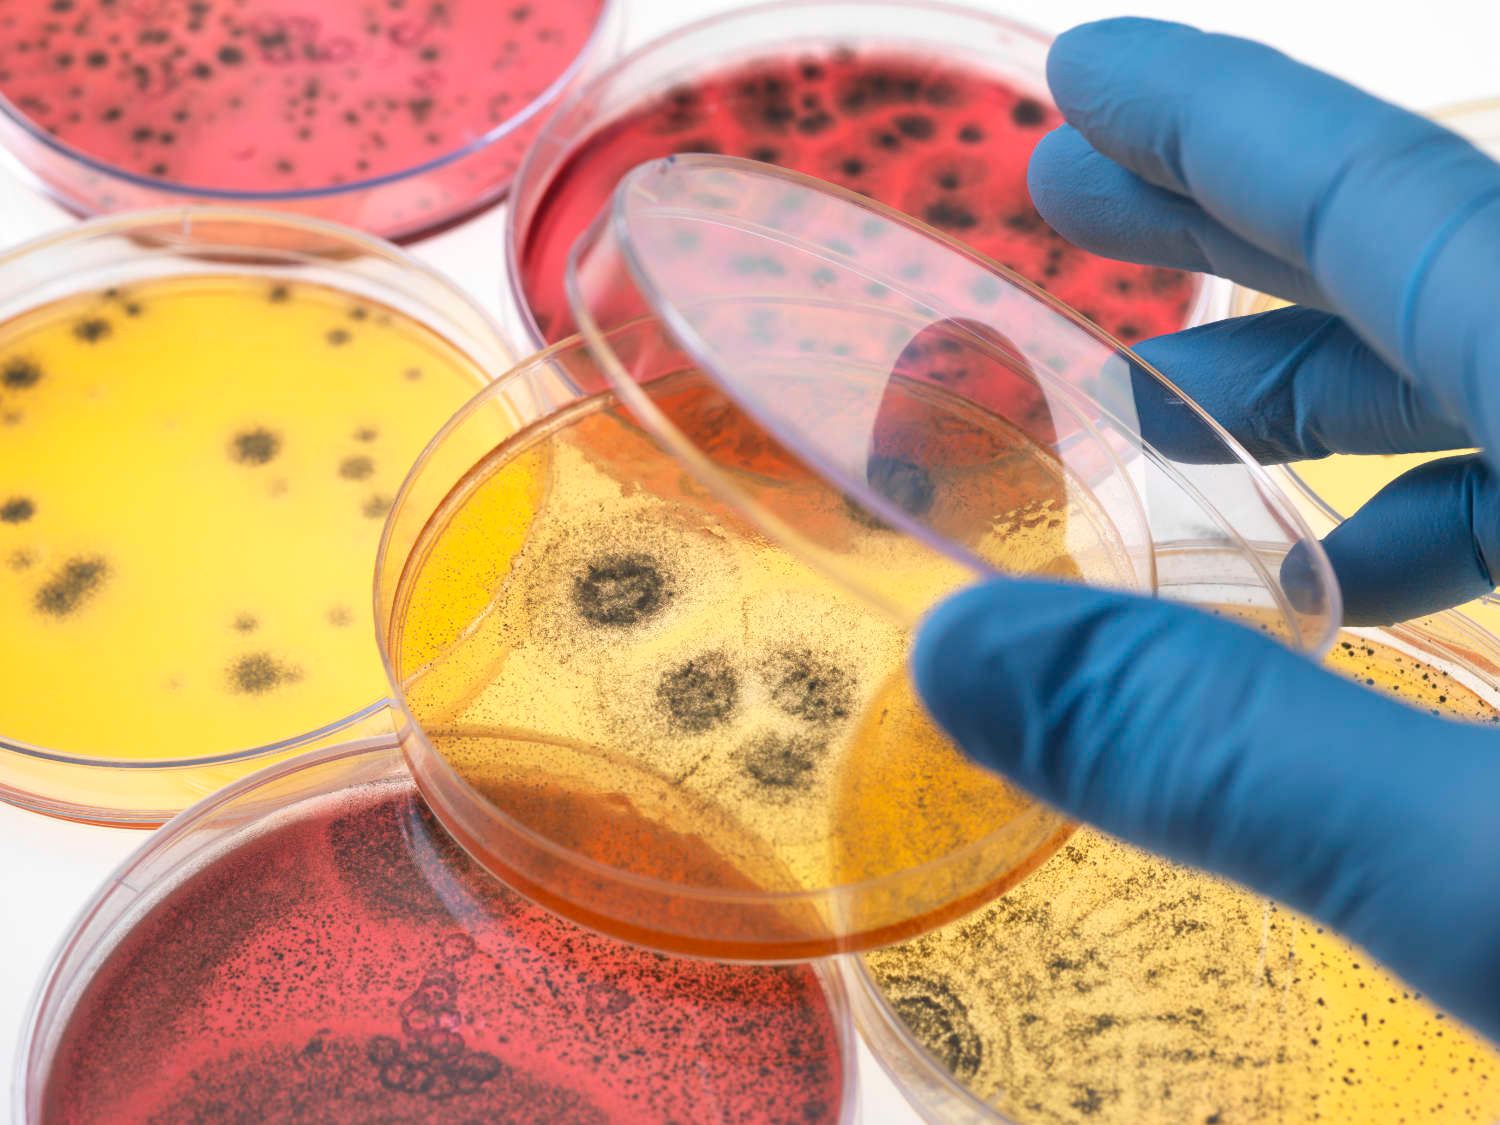

La naturaleza constituye una red compleja de vida, energía y materia en constante transformación. Desde los ecosistemas hasta la estructura molecular del ADN, las ciencias naturales intentan comprender la lógica profunda que organiza el mundo vivo.
Introducción a la segunda parte: la vida y el equilibrio de la naturaleza
En la primera parte de este recorrido, (Ver: Ciencias Naturales (I): El mundo físico: materia, energía y cosmos., por las ciencias naturales hemos tratado de comprender las bases fundamentales que sostienen el mundo físico. Allí aparecían las grandes disciplinas que estudian la estructura profunda de la realidad: la física, que investiga las leyes que rigen la materia y la energía, y la química, que explica la composición y las transformaciones de la materia. Gracias a estas ciencias sabemos que el universo no es un caos desordenado, sino un sistema gobernado por regularidades que pueden describirse, medirse y, hasta cierto punto, predecirse.
Sin embargo, dentro de ese universo regido por leyes físicas y químicas surge un fenómeno extraordinario que introduce un nuevo nivel de complejidad: la vida.
Los seres vivos están hechos de los mismos átomos que el resto del universo, obedecen las mismas leyes de la física y participan de las mismas reacciones químicas. Pero, al mismo tiempo, poseen propiedades que los distinguen profundamente del resto de la materia: pueden reproducirse, evolucionar, adaptarse a su entorno y mantener una organización interna extremadamente compleja.
Comprender ese fenómeno es la tarea de la biología, la ciencia que estudia los sistemas vivos en todas sus escalas, desde la célula microscópica hasta los grandes organismos que habitan la Tierra. La biología nos muestra que la vida no es una excepción aislada dentro de la naturaleza, sino una forma particular de organización de la materia que ha ido evolucionando durante miles de millones de años.
Pero los organismos vivos no existen de manera independiente. Cada ser vivo forma parte de un entramado mucho más amplio de relaciones con otros organismos y con el entorno físico que lo rodea. Los animales dependen de las plantas, las plantas dependen de la luz solar, los microorganismos reciclan la materia y todos ellos participan en ciclos de energía y nutrientes que sostienen el equilibrio de los ecosistemas.
Esta visión interconectada de la vida es el objeto de estudio de la ecología, una disciplina que nos revela hasta qué punto la naturaleza funciona como una red compleja en la que cada elemento cumple un papel dentro de un sistema mayor. En este contexto, la diversidad biológica aparece como una de las características más fascinantes del planeta: millones de especies distintas, cada una adaptada a su ambiente, interactúan formando sistemas vivos extraordinariamente delicados.
En esa red de relaciones aparece también el ser humano. Desde un punto de vista biológico, somos una especie más dentro del reino animal, resultado de un largo proceso evolutivo que comparte raíces con el resto de la vida en la Tierra. Sin embargo, nuestra capacidad de pensamiento simbólico, de organización social y de desarrollo tecnológico nos ha permitido modificar el entorno natural de una manera que ninguna otra especie ha logrado.
Esta situación plantea una cuestión fundamental: la relación entre conocimiento científico, sociedad y responsabilidad humana. La ciencia no solo describe la naturaleza; también proporciona herramientas que permiten transformarla. Gracias al conocimiento científico hemos desarrollado medicina, agricultura moderna, energía, transportes y sistemas de comunicación que han cambiado profundamente la vida humana. Pero ese mismo poder de transformación puede generar también problemas nuevos: degradación ambiental, pérdida de biodiversidad o alteraciones climáticas a escala global.
Por esta razón, el estudio de las ciencias naturales no puede limitarse únicamente a la descripción de fenómenos físicos o biológicos. También requiere una reflexión más amplia sobre el alcance y los límites del conocimiento científico, sobre su relación con otras formas de saber —como la filosofía o las humanidades— y sobre el papel que la ciencia desempeña dentro de la cultura contemporánea.
En esta segunda parte del artículo abordaremos precisamente esas cuestiones. Comenzaremos examinando el fenómeno de la vida desde la perspectiva de la biología, para comprender cómo funcionan los organismos y cómo se transmite la información genética entre generaciones. A continuación veremos cómo la ecología estudia las relaciones entre los seres vivos y su entorno, revelando la complejidad de los ecosistemas que sostienen la vida en nuestro planeta.
Finalmente, ampliaremos la mirada para reflexionar sobre el papel de la ciencia en la sociedad moderna, sus posibilidades, sus límites y la responsabilidad que implica el conocimiento. Porque conocer la naturaleza no es únicamente una actividad intelectual: también es una forma de comprender mejor el lugar que ocupamos dentro del mundo y de asumir la responsabilidad de conservar el equilibrio del sistema del que formamos parte.
Las ciencias naturales, en última instancia, no solo nos enseñan cómo funciona el universo. También nos recuerdan que la Tierra es un sistema extraordinariamente complejo y frágil, y que el conocimiento puede convertirse en una de las herramientas más poderosas para comprenderlo y preservarlo.
Parte II: La vida y la naturaleza
1. La biología: la ciencia de la vida.
2. La ecología: la naturaleza como sistema.
3. Botánica: el mundo vegetal como arquitectura viva.
4. Zoología: diversidad animal y estrategias de supervivencia.
5. Alcance y límites de las ciencias naturales.
6. Ciencias naturales, sociedad y cultura

Instrumentos científicos, libros y objetos de laboratorio simbolizan la búsqueda humana por comprender las leyes de la naturaleza, desde el mundo microscópico hasta la estructura del universo. (Imagen generada por ia, y editada por autor).
Las ciencias naturales nacen del deseo humano de comprender el funcionamiento del mundo. A lo largo de la historia, observadores, filósofos y científicos han utilizado instrumentos, experimentos y razonamientos para descifrar las leyes que gobiernan la materia, la energía y el cosmos. Desde el microscopio que revela lo invisible hasta los instrumentos astronómicos que permiten explorar el universo, la ciencia representa una de las mayores aventuras intelectuales de la humanidad: el intento de comprender la lógica profunda de la naturaleza.
1. La biología: la ciencia de la vida
1.1. Qué significa estar vivo: una definición difícil.
1.2. La célula como unidad fundamental.
1.3. Metabolismo: energía, alimento y transformación.
1.4. Herencia y genética: la transmisión de la información biológica.
1.5. Evolución: la gran explicación de la diversidad.
1.6. Ecosistemas: la vida como red de relaciones.
1.7. El ser humano como organismo natural.
1.8. La biología moderna: microbiología, biotecnología y biología molecular.
1. La biología: la ciencia de la vida
La biología es la ciencia que estudia la vida en todas sus formas, desde las bacterias microscópicas hasta los organismos más complejos, desde los ecosistemas que cubren la Tierra hasta los procesos invisibles que ocurren dentro de cada célula. Su objetivo fundamental es comprender qué es la vida, cómo funciona, cómo se organiza y cómo ha llegado a adquirir la extraordinaria diversidad que observamos hoy en el planeta. En este sentido, la biología no es simplemente una disciplina científica más, sino una de las grandes puertas de acceso al conocimiento de la naturaleza, porque a través de ella el ser humano intenta comprender el fenómeno más cercano y, al mismo tiempo, más misterioso de todos: la existencia de seres vivos.
A diferencia de otras ciencias naturales como la física o la química, que estudian las leyes generales de la materia y la energía, la biología se ocupa de sistemas extraordinariamente complejos. Los organismos vivos no son simples conjuntos de moléculas, sino estructuras organizadas capaces de crecer, transformarse, reproducirse y adaptarse a su entorno. La vida se caracteriza por una organización interna altamente ordenada, por una constante transformación de materia y energía y por la capacidad de transmitir información de una generación a otra. Estas propiedades hacen de los seres vivos sistemas dinámicos que mantienen su equilibrio interno mientras interactúan continuamente con el medio que los rodea.
El estudio de la vida ha fascinado a la humanidad desde la Antigüedad. Los primeros naturalistas observaron plantas y animales, describieron sus formas y trataron de clasificarlos. Con el paso del tiempo, la investigación biológica fue ampliando su campo de estudio y desarrollando métodos cada vez más rigurosos. A lo largo de los siglos, la biología ha incorporado herramientas procedentes de la física, la química y las matemáticas, transformándose en una ciencia moderna capaz de explorar desde los ecosistemas planetarios hasta el mundo microscópico de las moléculas que componen los organismos.
Uno de los grandes avances de la biología fue descubrir que todos los seres vivos comparten ciertos principios fundamentales. A pesar de la enorme diversidad de formas que existen en la naturaleza, desde un árbol hasta un insecto o un ser humano, todos los organismos están construidos a partir de células, utilizan un mismo lenguaje químico basado en el carbono y comparten mecanismos similares para almacenar y transmitir información genética. Este descubrimiento reveló una idea profunda: toda la vida terrestre está conectada por un origen común y forma parte de una misma historia evolutiva.
La biología moderna ha mostrado también que la vida no puede entenderse únicamente observando organismos aislados. Los seres vivos forman parte de redes complejas de relaciones en las que intervienen otros organismos y el entorno físico. Cada planta, cada animal y cada microorganismo participa en ciclos de materia y energía que mantienen el equilibrio de los ecosistemas. En este sentido, la vida es siempre una realidad colectiva y dinámica, una trama de interacciones que abarca desde los organismos individuales hasta la biosfera entera.
Comprender la vida implica, por tanto, estudiar diferentes niveles de organización. En el nivel más pequeño se encuentran las moléculas que participan en los procesos biológicos; después aparecen las células, que constituyen la unidad básica de los seres vivos; más arriba encontramos los organismos completos; y finalmente los ecosistemas y comunidades que forman el tejido vivo del planeta. Cada uno de estos niveles presenta propiedades propias, pero todos están conectados entre sí y se influyen mutuamente.
El desarrollo de la biología en los últimos dos siglos ha sido extraordinario. El descubrimiento de la célula, la formulación de la teoría de la evolución, el nacimiento de la genética y el desciframiento del ADN han permitido comprender aspectos fundamentales del funcionamiento de la vida. En tiempos más recientes, disciplinas como la biología molecular, la microbiología y la biotecnología han abierto nuevas posibilidades para estudiar y modificar los procesos biológicos con una precisión que hace apenas unas décadas parecía impensable.
Sin embargo, cuanto más se profundiza en el estudio de la vida, más evidente se vuelve su complejidad. Los seres vivos son sistemas delicadamente equilibrados en los que miles de procesos ocurren simultáneamente. La investigación biológica revela una realidad profundamente organizada y al mismo tiempo sorprendentemente dinámica, donde cada organismo es el resultado de una larga historia evolutiva y de una interacción constante con su entorno.
La biología no solo amplía nuestro conocimiento científico, sino que también transforma nuestra manera de entender el lugar que ocupamos en la naturaleza. Al estudiar la vida, el ser humano descubre que forma parte de la misma trama biológica que sostiene a todos los organismos del planeta. Nuestro cuerpo comparte mecanismos fundamentales con otros seres vivos, y nuestra existencia depende de los mismos procesos ecológicos que mantienen el equilibrio de la biosfera.
Por esta razón, la biología no es únicamente una ciencia descriptiva. También tiene una dimensión cultural y ética cada vez más importante. En un mundo marcado por la degradación ambiental, la pérdida de biodiversidad y los cambios climáticos, comprender cómo funciona la vida se convierte en una herramienta esencial para protegerla. El conocimiento biológico permite entender las consecuencias de nuestras acciones sobre los ecosistemas y plantea preguntas profundas sobre la responsabilidad humana hacia el planeta.
Estudiar biología es, en última instancia, estudiar el fenómeno más extraordinario de la naturaleza: la capacidad de la materia para organizarse, reproducirse y evolucionar hasta generar la inmensa diversidad de formas vivas que habitan la Tierra. En las páginas que siguen exploraremos algunos de los principios fundamentales que hacen posible este fenómeno, desde la definición misma de lo que significa estar vivo hasta las complejas relaciones ecológicas que conectan a todos los organismos en una misma red de vida.
Ver artículo principal: «Introducción a la Ciencia Biológica: Fundamentos, principios y disciplinas».
1.1. Qué significa estar vivo: una definición difícil
Definir qué significa estar vivo es una de las preguntas más antiguas y, al mismo tiempo, más complejas de la ciencia. A primera vista parece una cuestión sencilla: todos distinguimos intuitivamente entre un organismo vivo y un objeto inerte. Reconocemos que un árbol, un perro o una persona están vivos, mientras que una piedra o una montaña no lo están. Sin embargo, cuando se intenta formular una definición precisa y universal de la vida, las dificultades aparecen rápidamente. La vida no es una sustancia concreta ni una propiedad única que pueda señalarse con facilidad; es más bien un conjunto de características y procesos que, cuando se combinan, dan lugar a algo cualitativamente distinto de la materia inerte.
Desde el punto de vista científico, los seres vivos comparten una serie de rasgos fundamentales. Uno de los más evidentes es la organización. A diferencia de los objetos inanimados, los organismos poseen una estructura altamente ordenada en la que cada parte cumple una función dentro de un sistema complejo. Esta organización no es estática: las células, los tejidos y los órganos mantienen una actividad constante que permite al organismo conservar su integridad frente a los cambios del entorno. La vida, en este sentido, se caracteriza por un equilibrio dinámico que requiere una continua renovación de sus componentes.
Otro rasgo esencial es el metabolismo. Todos los seres vivos intercambian materia y energía con su entorno para mantenerse activos. Las plantas capturan energía solar y la transforman en materia orgánica mediante la fotosíntesis; los animales obtienen energía a partir de los alimentos; los microorganismos desarrollan estrategias químicas diversas para aprovechar los recursos disponibles en su ambiente. Este flujo constante de energía permite que los organismos crezcan, reparen sus estructuras y mantengan su funcionamiento interno. Sin metabolismo, la organización biológica se desintegraría rápidamente.
La capacidad de reproducirse es otra característica fundamental de la vida. Los organismos no solo mantienen su propia existencia, sino que también pueden generar nuevos individuos. A través de la reproducción, la vida se perpetúa a lo largo del tiempo y transmite información genética de una generación a otra. Este proceso es crucial porque permite que las poblaciones evolucionen y se adapten a las condiciones cambiantes del entorno. Sin reproducción, cada organismo sería un fenómeno aislado y la continuidad de la vida desaparecería.
La vida también implica la capacidad de responder al ambiente. Los seres vivos perciben estímulos —luz, temperatura, sustancias químicas, sonidos— y reaccionan de diferentes maneras. En los animales estas respuestas pueden adoptar formas complejas, como el comportamiento o el aprendizaje, mientras que en las plantas y microorganismos se manifiestan mediante ajustes fisiológicos o movimientos más sutiles. Esta sensibilidad al entorno permite a los organismos sobrevivir en condiciones cambiantes y aprovechar mejor los recursos disponibles.
Un aspecto especialmente importante es la capacidad de evolución. Las poblaciones de seres vivos cambian a lo largo de las generaciones debido a variaciones genéticas y a la acción de la selección natural. Este proceso explica la enorme diversidad de formas de vida que existen en la Tierra, desde bacterias microscópicas hasta los grandes vertebrados. La evolución revela que la vida no es una realidad fija, sino un proceso histórico que se transforma continuamente a lo largo del tiempo.
A pesar de estas características comunes, la definición de vida sigue siendo problemática porque existen casos que desafían las categorías tradicionales. Los virus, por ejemplo, presentan algunas propiedades de los seres vivos, como la capacidad de replicarse y evolucionar, pero carecen de metabolismo propio y solo pueden multiplicarse dentro de células hospedadoras. ¿Son entonces seres vivos o entidades biológicas intermedias entre lo vivo y lo inerte? La respuesta sigue siendo objeto de debate entre los científicos.
Además, los avances de la biología moderna han mostrado que la frontera entre vida y no vida no siempre es tan clara como se pensaba. Las moléculas orgánicas pueden organizarse en estructuras complejas, algunas capaces de copiar información o catalizar reacciones químicas. Estas observaciones han llevado a muchos investigadores a considerar la vida como un fenómeno emergente: un sistema altamente organizado de reacciones químicas que, bajo ciertas condiciones, adquiere propiedades nuevas como la autorregulación, la reproducción y la evolución.
Por esta razón, muchos biólogos prefieren no buscar una definición única y absoluta de la vida, sino describir un conjunto de propiedades que, en conjunto, caracterizan a los organismos vivos. Entre ellas destacan la organización celular, el metabolismo, la capacidad de reproducción, la transmisión de información genética, la respuesta al entorno y la evolución. Ninguna de estas características por sí sola basta para definir la vida, pero juntas permiten reconocerla y estudiarla de manera científica.
Comprender qué significa estar vivo no es solo un ejercicio teórico. Esta cuestión se encuentra en el corazón de algunos de los problemas más fascinantes de la ciencia contemporánea: el origen de la vida en la Tierra, la posibilidad de vida en otros planetas y el desarrollo de formas artificiales de organización biológica en el laboratorio. Cada uno de estos campos obliga a replantear continuamente los límites de nuestra definición.
En última instancia, la dificultad para definir la vida refleja su extraordinaria complejidad. Los seres vivos no son meras máquinas químicas, sino sistemas dinámicos capaces de mantener su organización, transformarse y adaptarse a lo largo del tiempo. La biología intenta comprender este fenómeno desde múltiples perspectivas, pero siempre queda una sensación de asombro ante la riqueza y diversidad de la vida.
Quizá por eso, más que una definición rígida, la vida puede entenderse como un proceso: una forma particular en que la materia se organiza para persistir, reproducirse y evolucionar. A partir de esta idea fundamental, la biología explora los mecanismos que hacen posible esa organización extraordinaria, comenzando por la unidad básica que sustenta a todos los organismos: la célula.
1.2. La célula como unidad fundamental
Uno de los descubrimientos más decisivos de la biología fue comprender que todos los seres vivos, desde los organismos más simples hasta los más complejos, están formados por células. La célula constituye la unidad fundamental de la vida, el nivel mínimo de organización capaz de realizar todas las funciones necesarias para mantener un organismo vivo. Esta idea, que hoy parece evidente, fue el resultado de siglos de observación, experimentación y avances tecnológicos que permitieron explorar el mundo microscópico con creciente precisión.
Antes del desarrollo del microscopio, la estructura íntima de los seres vivos permanecía completamente oculta. Las plantas, los animales y el propio cuerpo humano podían observarse a simple vista, pero su organización interna seguía siendo un misterio. Fue en el siglo XVII cuando los primeros microscopios permitieron a los científicos descubrir un universo invisible hasta entonces. El naturalista inglés Robert Hooke observó en una lámina de corcho una serie de pequeñas cavidades que le recordaban a las celdas de un monasterio, y por ello las llamó “células”. Aunque aquellas estructuras que observó eran células vegetales muertas, su descubrimiento abrió un camino completamente nuevo para la biología.
A lo largo del siglo XIX, diversos investigadores fueron comprendiendo progresivamente el significado de estas estructuras microscópicas. Los trabajos de Matthias Schleiden y Theodor Schwann condujeron a la formulación de la teoría celular, uno de los pilares fundamentales de la biología moderna. Según esta teoría, todos los seres vivos están compuestos por una o más células, y la célula es la unidad básica de estructura y funcionamiento de los organismos. Poco después, el médico Rudolf Virchow añadió un principio esencial: toda célula procede de otra célula preexistente. Con ello quedaba claro que la vida se perpetúa mediante la división celular y que existe una continuidad biológica entre todas las generaciones de organismos.
La célula puede imaginarse como una pequeña fábrica altamente organizada. En su interior se desarrollan miles de reacciones químicas coordinadas que permiten al organismo mantenerse vivo. Cada célula posee una membrana que delimita su interior y regula el intercambio de sustancias con el exterior. Esta membrana actúa como una frontera dinámica que permite la entrada de nutrientes, la salida de desechos y la comunicación con el entorno. Dentro de este espacio delimitado se encuentra el citoplasma, una matriz compleja en la que se distribuyen diversas estructuras especializadas encargadas de realizar funciones concretas.
En las células más complejas, como las de animales y plantas, existen compartimentos internos llamados orgánulos que desempeñan tareas específicas. Las mitocondrias, por ejemplo, transforman la energía química de los nutrientes en una forma utilizable por la célula; el retículo endoplasmático participa en la síntesis de proteínas y lípidos; el aparato de Golgi organiza y distribuye las moléculas producidas en la célula. En las células vegetales aparecen además estructuras particulares como los cloroplastos, responsables de la fotosíntesis, proceso mediante el cual las plantas capturan energía solar y la transforman en materia orgánica.
En el centro de muchas células se encuentra el núcleo, que alberga el material genético. Este material, organizado en forma de ADN, contiene las instrucciones necesarias para construir y mantener el organismo. El ADN puede considerarse una especie de archivo molecular en el que se encuentra codificada la información que guía el desarrollo, el funcionamiento y la reproducción de las células. Durante la división celular, esta información se copia y se transmite a las células hijas, garantizando la continuidad de la vida.
Comparación entre una célula eucariota y una célula procariota. Las células eucariotas poseen núcleo definido y orgánulos internos especializados, mientras que las procariotas presentan una estructura más simple y carecen de núcleo verdadero. Esquema adaptado de Wikipedia (Wikimedia Commons). Science Primer (National Center for Biotechnology Information). Vectorized by Mortadelo2005. Dominio Público.

Los seres vivos se organizan a partir de dos tipos fundamentales de células. Las células procariotas, propias de bacterias y arqueas, presentan una estructura simple: no poseen núcleo definido y su material genético se encuentra disperso en el interior celular. En cambio, las células eucariotas, que forman los organismos animales, vegetales, hongos y protistas, poseen un núcleo delimitado y numerosos orgánulos especializados, como las mitocondrias o el retículo endoplasmático. Esta diferencia estructural marca una de las grandes divisiones de la biología y refleja distintos niveles de complejidad en la organización de la vida.
No todos los seres vivos poseen células con el mismo grado de complejidad. Existen organismos formados por células relativamente simples, llamados procariotas, como las bacterias y las arqueas. Estas células carecen de núcleo definido y presentan una organización interna más sencilla. A pesar de ello, son extraordinariamente eficaces y han colonizado prácticamente todos los ambientes del planeta. Por otro lado, los organismos más complejos —animales, plantas, hongos y muchos protistas— están formados por células eucariotas, que poseen núcleo y múltiples orgánulos especializados. Estas células permiten una mayor diversificación de funciones y han hecho posible la evolución de organismos multicelulares altamente complejos.
En los organismos formados por muchas células, como los animales o las plantas, las células no actúan de manera aislada. Se organizan en tejidos, órganos y sistemas que cooperan entre sí para mantener la vida del conjunto. Cada tipo celular adquiere una especialización particular: algunas células se encargan del movimiento, otras del transporte de sustancias, otras de la protección o de la comunicación entre distintas partes del organismo. Esta división del trabajo celular es una de las claves que explica la complejidad de los seres vivos superiores.
La comprensión de la célula ha transformado profundamente la biología y la medicina. Muchas enfermedades pueden entenderse hoy como alteraciones en el funcionamiento celular, ya sea por defectos genéticos, infecciones, fallos metabólicos o procesos degenerativos. El estudio de las células ha permitido desarrollar técnicas como el cultivo celular, la ingeniería genética o la medicina regenerativa, que abren nuevas posibilidades para tratar enfermedades y comprender mejor los mecanismos fundamentales de la vida.
Sin embargo, más allá de su importancia médica o tecnológica, la célula representa una idea profunda sobre la organización de la vida. Cada organismo vivo, por complejo que parezca, está construido a partir de unidades microscópicas capaces de mantener su propia actividad vital. En cada célula se desarrolla una extraordinaria red de procesos químicos, energéticos e informativos que permiten a la vida persistir y adaptarse.
Comprender que la célula es la unidad fundamental de la vida significa reconocer que toda la diversidad biológica del planeta —bosques, animales, microorganismos e incluso el propio ser humano— se sustenta en el funcionamiento de estas pequeñas estructuras invisibles. En ellas se encuentran los mecanismos básicos que permiten a los organismos crecer, transformarse y reproducirse. A partir de esta base celular, la vida despliega una complejidad creciente que se manifiesta en la enorme diversidad de formas y estrategias que observamos en la naturaleza.
Célula eucariota animal con sus principales orgánulos. Adaptación en español realizada a partir de un esquema original de Wikipedia (Wikimedia Commons). Ilustración modificada y rotulada en su traducción al español mediante inteligencia artificial. Creative Commons Attribution 4.0. Unknown author – OpenStax. CC BY 4.0.

La célula es la unidad fundamental de todos los seres vivos. En su interior se organizan numerosos orgánulos especializados que permiten realizar las funciones esenciales de la vida: obtener energía, sintetizar proteínas, almacenar información genética y mantener el equilibrio interno del organismo. Este tipo de célula, característica de los organismos animales, muestra la compleja organización microscópica que hace posible el funcionamiento de los tejidos y, en última instancia, de todo el organismo.
1.3. Metabolismo: energía, alimento y transformación
Una de las características más fundamentales de los seres vivos es su capacidad para transformar materia y energía. Ningún organismo puede existir de forma aislada o autosuficiente: toda forma de vida depende de un intercambio constante con el entorno. Los organismos incorporan sustancias del medio, las transforman mediante complejos procesos químicos y liberan productos que vuelven a integrarse en los ciclos naturales. Este conjunto de transformaciones recibe el nombre de metabolismo, y constituye uno de los rasgos más esenciales que permiten distinguir a los seres vivos de la materia inerte.
El metabolismo puede entenderse como el sistema de reacciones químicas que mantienen vivo a un organismo. En cada célula tienen lugar miles de reacciones coordinadas que permiten obtener energía, construir estructuras biológicas, reparar daños y eliminar residuos. Estas reacciones no ocurren de forma caótica, sino que están organizadas en redes muy precisas que funcionan como auténticas rutas químicas. La célula dirige estos procesos mediante enzimas, moléculas especializadas que aceleran las reacciones y garantizan que se desarrollen de forma eficiente.
Desde un punto de vista general, el metabolismo suele dividirse en dos grandes tipos de procesos complementarios: el catabolismo y el anabolismo. El catabolismo comprende las reacciones mediante las cuales las moléculas complejas se descomponen en sustancias más simples, liberando energía en el proceso. Por ejemplo, cuando los animales digieren alimentos como los carbohidratos, las grasas o las proteínas, estas moléculas se fragmentan y liberan energía química que las células pueden utilizar. Esta energía es fundamental para mantener las funciones vitales, desde el movimiento muscular hasta la transmisión de impulsos nerviosos.
El anabolismo, por el contrario, agrupa las reacciones que construyen moléculas complejas a partir de componentes más simples. Gracias a estos procesos, las células pueden fabricar proteínas, membranas, ácidos nucleicos y muchas otras estructuras necesarias para el crecimiento y la renovación del organismo. A diferencia del catabolismo, el anabolismo requiere energía, que normalmente procede de las reacciones catabólicas. De esta manera, ambos procesos forman un sistema equilibrado: la energía liberada al descomponer moléculas permite construir nuevas estructuras biológicas.
Uno de los aspectos más fascinantes del metabolismo es la diversidad de estrategias que los seres vivos han desarrollado para obtener energía. Las plantas, las algas y ciertos microorganismos utilizan la fotosíntesis, un proceso mediante el cual capturan la energía de la luz solar y la convierten en energía química almacenada en moléculas orgánicas. Este proceso no solo sostiene la vida vegetal, sino que constituye la base energética de la mayor parte de los ecosistemas terrestres, ya que las plantas producen los compuestos que servirán de alimento para otros organismos.
Los animales, por su parte, no pueden captar directamente la energía solar. Dependen de la materia orgánica producida por otros organismos, principalmente plantas o algas. Al consumir alimentos, los animales incorporan moléculas energéticas que sus células transforman mediante procesos metabólicos como la respiración celular. En esta serie de reacciones químicas, la glucosa y otras moléculas se oxidan para liberar energía utilizable por la célula.
Existen también organismos capaces de obtener energía a partir de fuentes químicas inorgánicas. Muchos microorganismos que viven en ambientes extremos, como fuentes hidrotermales o sedimentos profundos, utilizan compuestos minerales para impulsar su metabolismo. Estos procesos muestran que la vida puede adaptarse a condiciones muy diversas y que la obtención de energía puede adoptar formas sorprendentemente variadas.
En el centro de todas estas transformaciones se encuentra una molécula clave: el ATP (adenosín trifosfato). Esta molécula actúa como una especie de “moneda energética” universal dentro de las células. Cuando el ATP libera uno de sus grupos fosfato, se produce una pequeña cantidad de energía que puede utilizarse para realizar trabajo biológico: mover estructuras celulares, transportar sustancias a través de membranas o sintetizar nuevas moléculas. Gracias a este sistema, las células pueden almacenar y distribuir energía de forma controlada.
El metabolismo no solo proporciona energía, sino que también conecta a los organismos con los grandes ciclos de la naturaleza. Las transformaciones metabólicas participan en el movimiento de elementos químicos fundamentales como el carbono, el nitrógeno o el fósforo. Las plantas capturan dióxido de carbono de la atmósfera, los animales lo liberan durante la respiración, y los microorganismos transforman compuestos orgánicos en formas reutilizables. De este modo, el metabolismo individual de cada organismo se integra en procesos ecológicos mucho más amplios que sostienen el equilibrio del planeta.
Comprender el metabolismo permite también entender cómo los organismos mantienen su estabilidad interna, un fenómeno conocido como homeostasis. Las células regulan cuidadosamente las reacciones metabólicas para mantener condiciones internas relativamente constantes, incluso cuando el entorno cambia. La temperatura corporal, el equilibrio de nutrientes o la concentración de ciertas sustancias químicas son regulados mediante complejos mecanismos metabólicos que permiten al organismo funcionar de manera estable.
La investigación científica ha mostrado que el metabolismo es extraordinariamente preciso y eficiente. Las rutas metabólicas están organizadas de tal forma que los productos de una reacción se convierten en los reactivos de la siguiente, formando cadenas de transformación altamente coordinadas. Este orden revela una profunda organización en el funcionamiento de la vida, donde cada reacción tiene un papel específico dentro del conjunto.
En definitiva, el metabolismo representa el flujo constante de energía y materia que sostiene la vida. Gracias a estas transformaciones químicas, los organismos pueden crecer, reproducirse, adaptarse y mantenerse activos frente a los cambios del entorno. Cada célula es un pequeño laboratorio en el que miles de reacciones ocurren de manera simultánea, manteniendo un equilibrio dinámico que permite a la vida persistir.
Comprender el metabolismo significa comprender cómo la vida se alimenta, cómo obtiene energía y cómo transforma el mundo material para mantenerse en funcionamiento. Este flujo permanente de transformación conecta a todos los organismos con la naturaleza que los rodea y revela que la vida no es un estado estático, sino un proceso continuo de intercambio y renovación. En este proceso, la información genética desempeña un papel decisivo, ya que dirige y regula muchas de las reacciones metabólicas que permiten a los organismos mantenerse vivos. Por ello, el siguiente paso para comprender la vida consiste en estudiar cómo se transmite y se organiza esa información biológica fundamental.
Estructura de una mitocondria. Este orgánulo celular, presente en la mayoría de las células eucariotas, es el principal responsable de la producción de energía química en forma de ATP mediante los procesos de respiración celular. En su interior destacan la membrana interna plegada formando crestas, la matriz mitocondrial y las partículas de ATP sintasa, donde se sintetiza la energía que alimenta el metabolismo celular. User: Mariana Ruiz Villarreal LadyofHats.

La mitocondria: el centro energético de la célula
Cuando se habla de metabolismo celular, es inevitable mencionar la mitocondria, uno de los orgánulos más importantes de la célula eucariota. Su función principal está relacionada con la obtención y transformación de la energía, un proceso esencial para que la vida pueda mantenerse. En términos sencillos, la mitocondria actúa como una especie de central energética celular, donde los nutrientes que la célula obtiene del exterior se transforman en una forma utilizable de energía química: el ATP (adenosín trifosfato).
Las células necesitan energía para realizar prácticamente todas sus funciones: sintetizar moléculas, transportar sustancias a través de las membranas, dividirse, reparar daños o responder a estímulos del entorno. Esta energía no puede utilizarse directamente a partir de los alimentos. Primero debe transformarse mediante una serie de procesos bioquímicos complejos que constituyen la respiración celular, y gran parte de estos procesos ocurre dentro de la mitocondria.
La estructura de la mitocondria está especialmente adaptada a esta función energética. Este orgánulo posee dos membranas diferenciadas. La membrana externa delimita el orgánulo y lo separa del resto del citoplasma. En cambio, la membrana interna se pliega formando numerosas invaginaciones llamadas crestas mitocondriales. Estos pliegues aumentan enormemente la superficie disponible para que se lleven a cabo las reacciones químicas implicadas en la producción de ATP.
Entre ambas membranas se encuentra el espacio intermembrana, mientras que el interior del orgánulo está ocupado por la matriz mitocondrial, un medio rico en enzimas, proteínas y moléculas necesarias para el metabolismo energético. En esta matriz también se encuentra ADN mitocondrial, lo que convierte a la mitocondria en un orgánulo peculiar: posee cierta autonomía genética y puede sintetizar algunas de sus propias proteínas. Este rasgo ha llevado a muchos científicos a pensar que las mitocondrias se originaron hace miles de millones de años a partir de bacterias que fueron incorporadas por células primitivas en un proceso de simbiosis.
El proceso metabólico que tiene lugar en la mitocondria forma parte de una cadena de transformaciones energéticas. Las moléculas orgánicas procedentes de los alimentos, como la glucosa o los ácidos grasos, son degradadas progresivamente. Durante estas reacciones se liberan electrones de alta energía que son transferidos a través de una serie de complejos proteicos situados en la membrana interna. Este conjunto de reacciones, conocido como cadena de transporte de electrones, genera un gradiente de protones a través de la membrana mitocondrial.
Ese gradiente energético es aprovechado por unas proteínas especializadas llamadas ATP sintasas, representadas en el esquema como pequeñas partículas incrustadas en la membrana interna. Estas proteínas funcionan como auténticas máquinas moleculares: utilizan la energía del flujo de protones para sintetizar moléculas de ATP a partir de ADP y fosfato. De este modo, la energía liberada durante la degradación de los nutrientes queda almacenada en forma de enlaces químicos ricos en energía.
El ATP producido en las mitocondrias puede difundirse posteriormente por el citoplasma y alimentar innumerables procesos celulares. Gracias a esta capacidad de conversión energética, la mitocondria se convierte en un elemento central del metabolismo celular. De hecho, las células con mayores demandas energéticas —como las células musculares, las neuronas o las células del hígado— suelen contener un gran número de mitocondrias.
Sin embargo, el papel de la mitocondria no se limita únicamente a la producción de energía. En este orgánulo también tienen lugar procesos metabólicos importantes relacionados con la síntesis de determinadas moléculas, la regulación del calcio celular o incluso la activación de mecanismos de muerte celular programada. Estas funciones muestran que la mitocondria participa de manera activa en el equilibrio general de la célula y en la regulación de su funcionamiento interno.
En conjunto, la mitocondria representa un ejemplo extraordinario de cómo la evolución biológica ha desarrollado estructuras especializadas capaces de transformar la energía química de los alimentos en energía utilizable para la vida. Sin estos pequeños orgánulos energéticos, las células complejas —y, por extensión, los organismos multicelulares— no podrían mantener el nivel de actividad metabólica que caracteriza a la vida eucariota.
1.4. Herencia y genética: la transmisión de la información biológica
Uno de los rasgos más sorprendentes de la vida es su capacidad para perpetuarse a lo largo del tiempo. Los organismos nacen, crecen y finalmente mueren, pero la vida no desaparece con cada individuo. En cambio, continúa en nuevas generaciones que conservan muchas de las características de sus antecesores. Este fenómeno, conocido como herencia biológica, constituye uno de los principios fundamentales de la vida y es el objeto de estudio de la genética.
La herencia explica por qué los hijos se parecen a sus padres, por qué ciertas características se repiten dentro de una familia y por qué las especies mantienen rasgos relativamente estables a lo largo del tiempo. Al mismo tiempo, la herencia no produce copias exactas: cada nueva generación presenta pequeñas variaciones que introducen diversidad dentro de las poblaciones. Esta combinación entre continuidad y variación es esencial para comprender cómo evoluciona la vida.
Durante siglos, los seres humanos observaron los efectos de la herencia sin comprender sus mecanismos. Agricultores y ganaderos sabían que era posible seleccionar ciertas características al cruzar plantas o animales, pero el proceso biológico que permitía transmitir esos rasgos seguía siendo un misterio. Fue en el siglo XIX cuando el monje y científico Gregor Mendel realizó una serie de experimentos con plantas de guisante que sentaron las bases de la genética moderna. Mendel descubrió que los rasgos hereditarios no se mezclan de forma indefinida, sino que se transmiten mediante unidades discretas que hoy llamamos genes.
Un gen puede entenderse como un fragmento de información biológica que contiene instrucciones para construir o regular algún aspecto del organismo. Estas instrucciones están codificadas en una molécula extraordinaria: el ADN, o ácido desoxirribonucleico. El ADN es una larga cadena molecular formada por cuatro tipos de componentes químicos que se organizan en una secuencia específica. Esta secuencia funciona como un lenguaje biológico que almacena la información necesaria para el desarrollo y funcionamiento de los seres vivos.
Cada célula de un organismo contiene una copia completa de esta información genética. En los organismos más complejos, el ADN se organiza en estructuras llamadas cromosomas, que se encuentran dentro del núcleo celular. Los cromosomas contienen miles de genes que controlan una amplia variedad de procesos, desde la formación de tejidos hasta la regulación del metabolismo o el funcionamiento del sistema nervioso.
La doble hélice del ADN. En esta molécula se almacena la información genética que determina las características de los seres vivos y que se transmite de generación en generación.
El proceso de transmisión genética ocurre durante la reproducción. Cuando un organismo produce descendencia, su material genético se copia y se transmite a la nueva generación. En los organismos que se reproducen sexualmente, como los animales y muchas plantas, la información genética procede de dos progenitores. Cada uno aporta la mitad del material genético, que se combina para formar una nueva configuración única. Esta mezcla genética explica por qué los individuos presentan rasgos heredados de ambos padres, pero al mismo tiempo poseen características propias.
La genética no solo explica la herencia de rasgos visibles, como el color de los ojos o la forma de las hojas en una planta. También permite comprender el funcionamiento profundo de los organismos. Los genes contienen las instrucciones para fabricar proteínas, moléculas fundamentales que participan en prácticamente todos los procesos biológicos. Las proteínas actúan como enzimas que catalizan reacciones químicas, como componentes estructurales de las células o como señales que coordinan la actividad de diferentes tejidos.
El flujo de información desde el ADN hasta las proteínas constituye uno de los principios centrales de la biología molecular. Primero, la información contenida en el ADN se copia en una molécula intermediaria llamada ARN. Después, esta información se utiliza para ensamblar proteínas mediante un complejo proceso celular. Este sistema de lectura y traducción del código genético permite a las células convertir la información heredada en estructuras y funciones concretas.
La genética también explica cómo surgen las variaciones que impulsan la evolución. Durante la copia del ADN pueden producirse cambios llamados mutaciones. Algunas mutaciones no tienen efectos apreciables, mientras que otras pueden alterar el funcionamiento de ciertos genes. Estas variaciones introducen diversidad genética dentro de las poblaciones, proporcionando el material sobre el cual actúa la selección natural. A lo largo de muchas generaciones, estos cambios pueden dar lugar a nuevas adaptaciones e incluso a nuevas especies.
El estudio de la genética ha experimentado un desarrollo extraordinario en las últimas décadas. El descubrimiento de la estructura del ADN a mediados del siglo XX permitió comprender con gran precisión cómo se almacena y se transmite la información genética. Posteriormente, el avance de la biología molecular ha hecho posible analizar genes individuales, secuenciar genomas completos e incluso modificar el material genético de ciertos organismos.
Estos avances han tenido profundas consecuencias en numerosos campos. En medicina, la genética permite identificar las bases moleculares de muchas enfermedades y desarrollar tratamientos más precisos. En agricultura, el conocimiento genético facilita la mejora de cultivos y la resistencia frente a plagas. En biología evolutiva, el análisis del ADN permite reconstruir la historia de las especies y comprender las relaciones entre diferentes formas de vida.
Sin embargo, el poder creciente de la genética también plantea importantes preguntas éticas y sociales. La capacidad de modificar genes, seleccionar características o manipular organismos vivos abre posibilidades extraordinarias, pero también exige una reflexión cuidadosa sobre sus límites y consecuencias. El conocimiento de la herencia biológica no solo amplía nuestra comprensión de la vida, sino que también nos obliga a pensar con responsabilidad sobre el uso que hacemos de ese conocimiento.
En última instancia, la genética revela que la vida posee una dimensión informativa profunda. Cada organismo es portador de una larga historia biológica codificada en su ADN, una historia que se remonta a los primeros seres vivos que aparecieron en la Tierra hace miles de millones de años. La transmisión de esta información genética permite que la vida conserve su continuidad a lo largo del tiempo, pero también que se transforme y diversifique.
Esta combinación de estabilidad y cambio constituye el motor de la evolución. Gracias a la herencia genética, los organismos transmiten sus rasgos a las nuevas generaciones; gracias a las variaciones genéticas, esas generaciones pueden adaptarse a nuevas condiciones. De este modo, la genética y la evolución se encuentran profundamente entrelazadas, formando dos aspectos inseparables de la historia de la vida en nuestro planeta.
Ver artículo: Herencia genética, genes y genómica: estudio avanzado.
1.5. Evolución: la gran explicación de la diversidad
Cuando observamos el mundo natural, una de las primeras cosas que llama la atención es la extraordinaria diversidad de la vida. En la Tierra existen millones de especies de organismos distintos: desde bacterias microscópicas hasta árboles gigantes, desde insectos diminutos hasta grandes mamíferos. Cada uno de estos seres posee formas, comportamientos y modos de vida diferentes. La pregunta de cómo ha surgido esta inmensa variedad de formas vivas ha ocupado durante siglos a naturalistas, filósofos y científicos. La respuesta más sólida que ha encontrado la biología moderna es la teoría de la evolución.
La evolución puede entenderse como el proceso mediante el cual las poblaciones de organismos cambian a lo largo de las generaciones. Estos cambios no ocurren de manera abrupta ni en un solo momento, sino a lo largo de largos periodos de tiempo. Con el paso de miles o millones de años, pequeñas variaciones acumuladas pueden transformar profundamente las características de una especie y dar lugar a nuevas formas de vida. De este modo, la diversidad biológica que hoy observamos es el resultado de una larga historia de transformaciones graduales.
La idea de que las especies cambian con el tiempo comenzó a tomar forma científica en el siglo XIX, especialmente gracias al trabajo de Charles Darwin. Tras años de observación y estudio de la naturaleza, Darwin propuso una explicación revolucionaria: las especies evolucionan mediante un proceso llamado selección natural. Según esta idea, los individuos de una población presentan variaciones heredables. Algunas de estas variaciones pueden proporcionar ventajas en determinadas condiciones ambientales, permitiendo a quienes las poseen sobrevivir y reproducirse con mayor éxito. Con el tiempo, esas características favorables se vuelven más comunes dentro de la población.
La selección natural no actúa con un propósito consciente ni dirige la evolución hacia un objetivo predeterminado. Es un proceso que surge de la interacción entre la variación biológica y las condiciones del entorno. Cuando el ambiente favorece ciertos rasgos —como una mayor velocidad, una mejor capacidad para obtener alimento o una mayor resistencia a enfermedades— los organismos que poseen esas características tienen más probabilidades de dejar descendencia. De esta manera, el conjunto de la población se va transformando gradualmente.
Un elemento esencial para que la evolución pueda producirse es la existencia de variación genética. Como vimos al hablar de genética, cada generación presenta pequeñas diferencias en su material hereditario. Estas variaciones pueden surgir por mutaciones en el ADN o por la recombinación genética que ocurre durante la reproducción sexual. Aunque muchas de estas variaciones no tienen efectos significativos, algunas pueden influir en la capacidad de los organismos para sobrevivir o reproducirse.
A lo largo de enormes escalas de tiempo, la acumulación de cambios evolutivos puede dar lugar a la formación de nuevas especies, un proceso conocido como especiación. Esto ocurre cuando poblaciones de una misma especie se separan y evolucionan de forma independiente durante largos periodos. Con el tiempo, las diferencias acumuladas pueden llegar a ser tan grandes que los individuos de ambas poblaciones ya no pueden reproducirse entre sí. En ese momento, se considera que han surgido especies distintas.
La evolución también explica por qué muchos organismos comparten rasgos comunes. Los vertebrados, por ejemplo, poseen una estructura corporal similar basada en una columna vertebral, un cráneo y un sistema nervioso central. Estas similitudes no se deben a coincidencias, sino a que todos estos animales descienden de antepasados comunes. El estudio comparado de la anatomía, el desarrollo embrionario y el ADN ha permitido reconstruir con bastante precisión las relaciones evolutivas entre diferentes grupos de organismos.
Otro aspecto importante de la evolución es la adaptación. A lo largo de generaciones, los organismos desarrollan características que les permiten ajustarse mejor a su entorno. Las alas de las aves facilitan el vuelo, el camuflaje de ciertos insectos los protege de los depredadores y las raíces profundas de algunas plantas les permiten acceder al agua en ambientes secos. Estas adaptaciones no aparecen de forma repentina ni por necesidad inmediata, sino que surgen gradualmente a partir de variaciones que resultan ventajosas en determinadas circunstancias.
Evolución del género Homo. A lo largo de los últimos dos millones de años han existido diversas especies humanas. Estas poblaciones surgieron, se diversificaron y, en muchos casos, desaparecieron, formando parte del proceso evolutivo que finalmente condujo al ser humano moderno (Homo sapiens).

La teoría de la evolución también ha transformado nuestra comprensión del lugar que ocupa el ser humano en la naturaleza. Durante mucho tiempo se pensó que nuestra especie era una entidad separada del resto de los seres vivos. Sin embargo, la biología evolutiva ha mostrado que los seres humanos comparten un ancestro común con otros primates y, en última instancia, con todas las formas de vida del planeta. Desde esta perspectiva, la humanidad forma parte de la misma historia biológica que ha producido la diversidad de la vida.
En las últimas décadas, el estudio de la evolución se ha enriquecido enormemente gracias al desarrollo de la genética y la biología molecular. El análisis del ADN ha permitido comparar el material genético de diferentes especies y reconstruir su historia evolutiva con gran detalle. Estos estudios han confirmado que todos los organismos de la Tierra comparten ciertos elementos genéticos fundamentales, lo que sugiere que toda la vida actual desciende de un ancestro común que vivió hace miles de millones de años.
La evolución no es un proceso del pasado que haya terminado. Continúa ocurriendo en la actualidad. Las poblaciones de microorganismos, por ejemplo, pueden evolucionar rápidamente cuando desarrollan resistencia a ciertos medicamentos. Las especies también pueden adaptarse a cambios ambientales, aunque en ocasiones estos cambios son tan rápidos que superan la capacidad de adaptación de los organismos.
Comprender la evolución permite contemplar la vida desde una perspectiva histórica profunda. Cada organismo que existe hoy es el resultado de una larga cadena de transformaciones que se remonta a los primeros seres vivos que habitaron la Tierra. Las formas, colores, comportamientos y estructuras que observamos en la naturaleza son el fruto de millones de años de interacción entre la vida y su entorno.
La teoría de la evolución ofrece así una de las explicaciones más poderosas de la biología. No solo describe cómo cambian las especies, sino que proporciona un marco que conecta la genética, la ecología, la anatomía y la historia de la vida. Gracias a esta idea, la diversidad biológica deja de parecer una colección de formas aisladas y se revela como el resultado de una historia común en la que todos los organismos están, de una u otra forma, relacionados.
Árbol filogenético de los tres dominios de la vida. Este diagrama muestra las relaciones evolutivas entre los principales grupos de organismos conocidos. A partir de un antepasado común ancestral, la vida se diversificó en tres grandes dominios —bacterias, arqueas y eucariotas— que posteriormente dieron lugar a la enorme variedad de seres vivos actuales. Fuente: Wikimedia Commons.

El diagrama representa un árbol filogenético, es decir, una reconstrucción científica de las relaciones evolutivas entre los organismos vivos. En lugar de mostrar una clasificación estática, como las antiguas jerarquías de la biología clásica, este tipo de representación intenta reconstruir la historia evolutiva de la vida en la Tierra, mostrando cómo los distintos grupos de organismos descienden de antepasados comunes y se han diversificado con el paso del tiempo.
En la base del árbol se encuentra el antepasado común universal, el organismo primitivo del que descienden todos los seres vivos conocidos. Aunque su naturaleza exacta sigue siendo objeto de investigación, los científicos consideran que debió existir hace más de 3.500 millones de años, en los primeros momentos de la historia de la vida en nuestro planeta.
A partir de este origen común, la evolución dio lugar a tres grandes ramas fundamentales que constituyen los tres dominios de la vida: bacterias, arqueas y eucariotas. Esta clasificación fue propuesta en la década de 1970 por el microbiólogo estadounidense Carl Woese, a partir del estudio comparado del ARN ribosomal, una molécula presente en todos los organismos.
El dominio Bacteria incluye a los microorganismos procariotas más conocidos. Son organismos unicelulares que carecen de núcleo celular y presentan una gran diversidad metabólica. Dentro de este grupo aparecen ramas como las proteobacterias, las cianobacterias o las espiroquetas, cada una de las cuales representa linajes evolutivos diferentes que se han adaptado a entornos muy variados. Las cianobacterias, por ejemplo, desempeñaron un papel fundamental en la historia del planeta, ya que fueron responsables de la oxigenación de la atmósfera primitiva mediante la fotosíntesis.
El segundo gran dominio es Archaea, formado por microorganismos procariotas que durante mucho tiempo se confundieron con bacterias, pero que en realidad poseen características genéticas y bioquímicas muy diferentes. Muchas arqueas viven en ambientes extremos, como fuentes hidrotermales, lagos hipersalinos o regiones con temperaturas muy elevadas. Entre los grupos representados en el árbol aparecen los metanógenos, capaces de producir metano como producto metabólico, o las haloarqueas, adaptadas a entornos con alta salinidad.
El tercer dominio es Eukarya, que incluye a todos los organismos eucariotas, es decir, aquellos cuyas células poseen un núcleo definido y orgánulos internos. Este dominio engloba tanto organismos unicelulares como los grandes organismos multicelulares que conocemos. Dentro de esta rama aparecen diversos grupos de protistas, como los ciliados o los flagelados, así como los grandes reinos de los animales, las plantas y los hongos.
La forma ramificada del árbol refleja uno de los principios fundamentales de la evolución: la descendencia con modificación. Las especies no aparecen de forma independiente, sino que surgen a partir de poblaciones ancestrales que, con el paso del tiempo, se diversifican y dan lugar a nuevos linajes. Cada bifurcación del árbol representa un momento en el que una población ancestral se separó en dos ramas evolutivas diferentes.
Además, este tipo de diagramas muestra que la diversidad de la vida no puede entenderse como una simple escala de complejidad. Los organismos actuales no forman una jerarquía lineal, sino una red de relaciones evolutivas en la que todos comparten un origen común. Incluso los seres humanos, situados dentro del grupo de los animales eucariotas, forman parte de una historia evolutiva mucho más amplia que conecta a todos los organismos del planeta.
En conjunto, el árbol filogenético constituye una de las representaciones más poderosas de la biología moderna, ya que sintetiza en una sola imagen la unidad y diversidad de la vida, mostrando cómo millones de especies diferentes forman parte de una misma historia evolutiva que se remonta a los orígenes de la vida en la Tierra.
1.6. Ecosistemas: la vida como red de relaciones
Hasta ahora hemos considerado la vida principalmente desde el punto de vista de los organismos individuales: la célula que mantiene su actividad, el metabolismo que transforma energía, la herencia que transmite información genética o la evolución que modifica las especies a lo largo del tiempo. Sin embargo, ningún ser vivo existe realmente de forma aislada. Cada organismo forma parte de un entramado de relaciones con otros seres vivos y con el medio físico que lo rodea. Comprender estas interacciones es el objetivo de la ecología, y uno de sus conceptos centrales es el de ecosistema.
Un ecosistema puede definirse como un sistema natural formado por organismos vivos y por el entorno físico en el que viven, unidos por una red de intercambios de energía y materia. En un bosque, por ejemplo, conviven árboles, plantas herbáceas, insectos, aves, mamíferos, hongos y microorganismos del suelo. Todos ellos interactúan entre sí y dependen también de factores como la luz solar, el agua, la temperatura o la composición del suelo. El ecosistema no es simplemente una colección de organismos, sino un sistema dinámico en el que todos estos elementos se encuentran conectados.
En el interior de un ecosistema, los organismos ocupan distintos papeles dentro del flujo de energía. Las plantas, algas y ciertos microorganismos constituyen la base de la mayoría de los ecosistemas porque son capaces de captar energía solar mediante la fotosíntesis. Estos organismos, llamados productores, transforman la energía luminosa en materia orgánica que servirá de alimento a otros seres vivos. Gracias a este proceso se genera la energía química que alimenta prácticamente toda la vida en la Tierra.
Los animales herbívoros se alimentan de los productores y constituyen el siguiente nivel dentro de la organización ecológica. A su vez, los animales carnívoros se alimentan de otros animales, estableciendo relaciones de depredación que conectan a múltiples especies. Estas relaciones forman lo que se conoce como cadenas alimentarias, que describen el camino que sigue la energía desde los productores hasta los diferentes niveles de consumidores. Sin embargo, en la naturaleza estas relaciones son mucho más complejas que una simple cadena lineal. En realidad, forman redes tróficas en las que numerosas especies se encuentran interconectadas a través de múltiples relaciones alimentarias.
Un componente fundamental de los ecosistemas lo constituyen los descomponedores, principalmente bacterias y hongos. Estos organismos se encargan de degradar los restos de plantas, animales y otros materiales orgánicos, liberando nutrientes que vuelven a integrarse en el suelo o en el agua. Gracias a su actividad, elementos químicos como el carbono, el nitrógeno o el fósforo pueden ser reutilizados por las plantas y volver a entrar en los ciclos biológicos. Sin este proceso de reciclaje, la vida en la Tierra sería imposible.
Los ecosistemas no solo implican relaciones alimentarias. También incluyen interacciones de cooperación, competencia y dependencia entre diferentes especies. Algunas plantas dependen de insectos para la polinización; ciertos animales viven asociados a microorganismos que les ayudan a digerir alimentos; muchos organismos compiten por recursos limitados como el agua, el espacio o la luz. Estas relaciones crean una red compleja de interdependencias que contribuye al equilibrio del sistema.
Este equilibrio no significa inmovilidad. Los ecosistemas son sistemas dinámicos que cambian con el tiempo. Las poblaciones de diferentes especies pueden aumentar o disminuir en función de múltiples factores, como la disponibilidad de alimento, las condiciones climáticas o la presencia de depredadores. A lo largo de los años o incluso de siglos, los ecosistemas pueden experimentar transformaciones profundas en un proceso conocido como sucesión ecológica. Un terreno recién formado por una erupción volcánica, por ejemplo, puede ser colonizado primero por microorganismos y plantas simples, para dar paso gradualmente a comunidades más complejas.
Cadena trófica simplificada de un ecosistema. La energía fluye desde los productores —las plantas que captan la energía del sol— hacia los consumidores herbívoros y, posteriormente, hacia los depredadores que se alimentan de ellos. Imagen generada por ia. (Chat GPT).

Uno de los conceptos más reveladores para comprender cómo funciona la naturaleza es el de cadena trófica, también llamada cadena alimentaria. En cualquier ecosistema los organismos no viven aislados ni existen de forma independiente, sino que están conectados por una red de relaciones basada, en gran medida, en la alimentación. La vida se organiza en una sucesión de niveles en los que unos seres vivos obtienen energía y materia a partir de otros. Esta transferencia de energía constituye uno de los mecanismos fundamentales que mantienen el funcionamiento de los ecosistemas.
La base de toda cadena trófica está formada por los productores, que son organismos capaces de fabricar su propio alimento. En los ecosistemas terrestres este papel corresponde principalmente a las plantas, que mediante la fotosíntesis captan la energía del Sol y la transforman en energía química almacenada en sus tejidos. En los ecosistemas acuáticos este papel lo desempeñan las algas y el fitoplancton. Gracias a ellos se incorpora energía nueva al sistema biológico. Sin los productores, la vida tal como la conocemos no podría existir, ya que constituyen el primer eslabón de la cadena alimentaria.
A partir de esta base aparecen los consumidores primarios, que son los animales herbívoros. Estos organismos se alimentan directamente de las plantas y, al hacerlo, incorporan la energía contenida en ellas. Conejos, insectos, roedores, muchos peces o grandes herbívoros como los ciervos son ejemplos de este nivel. En este punto la energía ya ha pasado del mundo vegetal al animal.
El siguiente nivel lo forman los consumidores secundarios, que son animales carnívoros o insectívoros que se alimentan de los herbívoros. Ranas que comen insectos, aves que capturan pequeños roedores o peces depredadores que se alimentan de otros peces constituyen ejemplos de este nivel. Más arriba todavía se encuentran los depredadores superiores, organismos que ocupan la parte alta de la cadena trófica. Águilas, lobos, tiburones o grandes felinos suelen ocupar estas posiciones, donde prácticamente no tienen enemigos naturales dentro del ecosistema.
Este sistema puede resultar, a primera vista, duro o incluso inquietante para el observador humano. La idea de que unos seres vivos sobrevivan alimentándose de otros puede parecer cruel, pero en realidad constituye uno de los mecanismos fundamentales de regulación de la naturaleza. La depredación cumple una función ecológica esencial: evita que las poblaciones de determinadas especies crezcan sin control y agoten los recursos disponibles. Cuando los herbívoros aumentan demasiado, los depredadores encuentran más alimento y su población también puede crecer. Cuando los herbívoros disminuyen, los depredadores también lo hacen. De esta manera se establece un equilibrio dinámico entre las distintas poblaciones.
Además, la cadena trófica no suele ser una simple línea recta. En la realidad los ecosistemas forman redes tróficas complejas, en las que una misma especie puede alimentarse de diferentes organismos y, a su vez, ser presa de varios depredadores. Estas redes alimentarias hacen que la energía circule por múltiples caminos dentro del ecosistema, lo que contribuye a su estabilidad y resiliencia frente a cambios ambientales.
Otro elemento fundamental del sistema ecológico lo constituyen los descomponedores, como bacterias y hongos. Estos organismos se encargan de descomponer los restos de plantas y animales muertos, liberando nutrientes que vuelven al suelo o al agua. Gracias a ellos los elementos químicos se reciclan y pueden volver a ser utilizados por los productores, cerrando así el ciclo de la materia.
La cadena trófica, por tanto, revela una verdad profunda sobre la naturaleza: la vida está formada por una red continua de transformaciones, donde la energía fluye de unos organismos a otros y la materia se recicla constantemente. Cada especie ocupa un lugar dentro de esta red y desempeña una función en el equilibrio general del ecosistema. Lejos de ser un sistema caótico, la naturaleza funciona como un conjunto de relaciones interdependientes que, a lo largo de millones de años de evolución, han dado lugar a la extraordinaria diversidad de la vida en la Tierra.
Los ecosistemas existen en una gran variedad de formas en el planeta. Los bosques tropicales, las sabanas, los desiertos, los océanos o los arrecifes de coral representan sistemas ecológicos distintos, cada uno con sus propias condiciones ambientales y su conjunto característico de especies. A pesar de estas diferencias, todos ellos comparten principios fundamentales relacionados con el flujo de energía, el reciclaje de nutrientes y las interacciones entre organismos.
En el nivel más amplio, todos los ecosistemas de la Tierra forman parte de un sistema mayor: la biosfera. La biosfera incluye el conjunto de todos los seres vivos y las regiones del planeta donde puede existir vida, desde las capas superiores del suelo hasta las profundidades oceánicas y la atmósfera baja. Dentro de este sistema global, la actividad de los organismos vivos influye profundamente en el funcionamiento del planeta. La producción de oxígeno por las plantas, la fijación de carbono o la regulación de ciertos ciclos químicos son ejemplos de cómo la vida modifica y mantiene las condiciones ambientales de la Tierra.
El estudio de los ecosistemas ha revelado también la gran fragilidad de muchos de estos equilibrios naturales. Alteraciones relativamente pequeñas en un elemento del sistema pueden provocar efectos en cadena que afectan a numerosas especies. La desaparición de un depredador, la introducción de una especie invasora o la contaminación de un hábitat pueden modificar profundamente la estructura de una comunidad biológica.
En el mundo actual, la actividad humana se ha convertido en uno de los factores más influyentes sobre los ecosistemas. La transformación de paisajes, la explotación de recursos naturales, la contaminación o el cambio climático están alterando numerosos sistemas ecológicos en todo el planeta. Comprender cómo funcionan los ecosistemas es por ello esencial para poder conservar la biodiversidad y mantener las condiciones que hacen posible la vida.
La idea de ecosistema revela una verdad fundamental sobre la naturaleza: la vida no se organiza en entidades aisladas, sino en redes complejas de relaciones. Cada organismo depende de muchos otros y participa en procesos que lo conectan con su entorno. Desde esta perspectiva, la vida aparece como una trama interdependiente en la que cada elemento desempeña un papel dentro de un sistema más amplio.
Entender esta red de relaciones permite contemplar la naturaleza con una mirada más profunda. Los seres vivos no solo existen individualmente, sino que forman parte de comunidades y sistemas que mantienen el equilibrio del planeta. Dentro de esta red de interdependencias se encuentra también el ser humano, cuya relación con la naturaleza constituye uno de los aspectos más importantes para comprender el lugar que ocupamos dentro del mundo vivo.
Ver artículos: Ecología. Introducción, los ecosistemas.
Paisaje natural de humedal y bosque de montaña — Imagen: © Pilat666 en Envato Elements.

La imagen muestra un paisaje natural que puede interpretarse como un pequeño ecosistema de agua dulce, probablemente una laguna o manantial rodeado de vegetación en un entorno montañoso. Este tipo de ambientes representa muy bien la idea de ecosistema en su sentido más completo: un espacio donde organismos vivos y elementos físicos del entorno interactúan de forma continua, formando un sistema dinámico y relativamente equilibrado.
Un ecosistema no es simplemente un paisaje bonito ni un conjunto de especies que conviven en un mismo lugar. En términos científicos, un ecosistema es una unidad funcional formada por los seres vivos —plantas, animales, microorganismos— y los componentes no vivos del medio, como el agua, el suelo, el aire, la luz solar o los minerales. Todos estos elementos están conectados por una compleja red de intercambios de energía y de materia que permite el mantenimiento de la vida.
En un entorno como el que muestra la imagen, las plantas y árboles constituyen la base biológica del sistema. Gracias a la fotosíntesis captan la energía del sol y la transforman en materia orgánica, produciendo oxígeno y generando el alimento que sostiene a muchos otros organismos. Esta vegetación forma lo que en ecología se denomina el nivel de productores, el primer eslabón de las cadenas tróficas.
A partir de esta base vegetal se desarrolla toda una comunidad biológica. Insectos, pequeños invertebrados, anfibios, peces, aves y mamíferos pueden encontrar en este tipo de ambientes refugio, alimento y condiciones adecuadas para su reproducción. Cada especie ocupa un lugar concreto dentro del ecosistema y desempeña una función determinada. Algunas se alimentan de plantas, otras de insectos o de pequeños animales, mientras que los depredadores controlan las poblaciones de sus presas.
El agua desempeña aquí un papel fundamental. Los humedales, lagunas o manantiales constituyen auténticos centros de biodiversidad porque concentran recursos esenciales para la vida. El agua regula la temperatura del entorno, permite el desarrollo de plantas acuáticas y ofrece un hábitat para numerosos organismos, desde microorganismos y algas hasta anfibios y peces. Al mismo tiempo, el suelo húmedo favorece el crecimiento de vegetación densa que proporciona alimento y refugio a muchas especies terrestres.
En estos sistemas naturales se establece lo que los ecólogos llaman equilibrio dinámico. No se trata de un equilibrio estático o inmutable, sino de una situación en la que las poblaciones de organismos fluctúan dentro de ciertos límites sin colapsar el sistema. La depredación, la competencia por los recursos, la disponibilidad de agua y nutrientes, o los cambios estacionales contribuyen a regular las poblaciones y a mantener la estabilidad general del ecosistema.
Otro componente esencial de este equilibrio lo constituyen los organismos descomponedores, como bacterias y hongos, que viven en el suelo o en el agua. Estos organismos degradan los restos de plantas y animales muertos, transformando la materia orgánica en nutrientes que vuelven a incorporarse al suelo y pueden ser reutilizados por las plantas. Gracias a este proceso, los ecosistemas reciclan continuamente la materia y mantienen activos los ciclos biogeoquímicos.
Un paisaje como el que vemos en la imagen es, por tanto, mucho más que un escenario natural: es el resultado de millones de años de evolución y de interacción entre organismos y ambiente. Cada planta, cada insecto, cada microorganismo forma parte de una red compleja de relaciones ecológicas. La estabilidad aparente de estos lugares es el resultado de innumerables procesos biológicos que se desarrollan de manera silenciosa pero constante.
Comprender los ecosistemas implica reconocer que la vida en la Tierra funciona como una gran red interconectada. Los organismos dependen unos de otros y también de las condiciones físicas del entorno. Cuando uno de estos elementos se altera profundamente —por ejemplo, a causa de la contaminación, la destrucción del hábitat o el cambio climático— todo el sistema puede verse afectado. Por esta razón, el estudio de los ecosistemas constituye uno de los pilares fundamentales de la ecología y de la comprensión científica de la naturaleza.
1.7. El ser humano como organismo natural
A lo largo de la historia, el ser humano ha tendido a considerarse a sí mismo como una realidad separada de la naturaleza. La capacidad de pensar, crear cultura, construir civilizaciones y transformar el entorno ha llevado con frecuencia a percibir a nuestra especie como algo radicalmente distinto del resto de los seres vivos. Sin embargo, desde el punto de vista biológico, el ser humano es ante todo un organismo natural. Nuestro cuerpo, nuestras funciones vitales y nuestra historia evolutiva forman parte del mismo proceso biológico que ha dado origen a todas las formas de vida en la Tierra.
El cuerpo humano está construido según los mismos principios que organizan a otros organismos. Está formado por células que realizan funciones especializadas y que se agrupan en tejidos, órganos y sistemas. El sistema circulatorio transporta nutrientes y oxígeno a todas las partes del organismo; el sistema respiratorio permite el intercambio de gases con el ambiente; el sistema digestivo transforma los alimentos en moléculas utilizables por las células; el sistema nervioso coordina la actividad del cuerpo y permite responder a los estímulos del entorno. Todos estos procesos se encuentran regulados por complejos mecanismos fisiológicos que mantienen el equilibrio interno necesario para la vida.
En este sentido, el ser humano comparte con otros animales las funciones biológicas fundamentales: alimentación, crecimiento, reproducción, regulación interna y adaptación al medio. Nuestro metabolismo transforma la energía contenida en los alimentos, nuestras células utilizan la información genética para fabricar proteínas y nuestras poblaciones evolucionan a lo largo del tiempo mediante variaciones heredables. Desde esta perspectiva, la biología muestra que la humanidad forma parte del mismo tejido de la vida que sostiene a todos los organismos.
La evidencia evolutiva refuerza esta idea de continuidad. El estudio comparado de la anatomía, el desarrollo embrionario y el ADN revela que los seres humanos están estrechamente relacionados con otros primates. Compartimos con ellos muchas características estructurales, como la organización del esqueleto, la disposición de los órganos o ciertos rasgos del sistema nervioso. El análisis genético muestra incluso que gran parte de nuestro material hereditario es similar al de otras especies cercanas. Estas similitudes indican que la especie humana surgió a partir de un largo proceso evolutivo que se remonta a antepasados comunes con otros primates.
Sin embargo, reconocer al ser humano como organismo natural no significa negar sus particularidades. A lo largo de su evolución, nuestra especie ha desarrollado capacidades cognitivas y culturales extraordinarias. El lenguaje articulado, la capacidad de pensamiento simbólico, la transmisión acumulativa de conocimientos y la creación de instituciones sociales han permitido a los seres humanos transformar profundamente su entorno. Estas características han dado lugar a una dimensión cultural que distingue a nuestra especie dentro del conjunto de la vida.
La cultura humana puede entenderse como una extensión de nuestras capacidades biológicas. El cerebro humano, resultado de millones de años de evolución, posee una gran capacidad para el aprendizaje, la memoria y la creatividad. Gracias a estas facultades, los seres humanos no solo se adaptan a su entorno mediante cambios biológicos, sino también mediante la transmisión de conocimientos, tecnologías y formas de organización social. De este modo, la evolución cultural ha adquirido un ritmo mucho más rápido que la evolución biológica.
Esta interacción entre biología y cultura ha permitido a la humanidad habitar prácticamente todos los ambientes del planeta, desde regiones polares hasta zonas desérticas. A diferencia de otras especies, cuya supervivencia depende principalmente de adaptaciones físicas específicas, los seres humanos pueden modificar su entorno mediante herramientas, agricultura, arquitectura o tecnología. Esta capacidad de transformación ha ampliado enormemente las posibilidades de supervivencia de nuestra especie.
No obstante, esta misma capacidad plantea también desafíos importantes. Al modificar los ecosistemas de forma intensa, la actividad humana puede alterar equilibrios naturales que han tardado miles o millones de años en formarse. La deforestación, la contaminación, la sobreexplotación de recursos o el cambio climático son ejemplos de cómo las acciones humanas pueden afectar a los sistemas ecológicos que sostienen la vida en el planeta.
Comprender al ser humano como parte de la naturaleza permite situar estos problemas en una perspectiva más amplia. Nuestra especie no existe al margen de los ecosistemas, sino dentro de ellos. Dependemos de la estabilidad de los ciclos naturales, de la fertilidad del suelo, de la disponibilidad de agua y de la diversidad biológica que sostiene las cadenas alimentarias. Aunque la tecnología haya ampliado nuestras capacidades, seguimos siendo organismos biológicos cuya existencia depende de las mismas condiciones ecológicas que sostienen a otras especies.
Desde el punto de vista biológico, el ser humano representa una de las muchas ramas del árbol evolutivo de la vida. Nuestra historia está conectada con la de otros organismos que compartieron antepasados comunes en el pasado remoto. Esta perspectiva evolutiva no disminuye la importancia de la humanidad, pero sí invita a comprenderla dentro de un contexto más amplio, donde todas las formas de vida forman parte de una historia compartida.
Al mismo tiempo, la conciencia y la capacidad reflexiva humanas introducen una dimensión singular en esta historia. Los seres humanos no solo participan en los procesos naturales, sino que también pueden comprenderlos. La ciencia, la filosofía y la cultura permiten reflexionar sobre la naturaleza, analizar sus mecanismos y plantear preguntas sobre el lugar que ocupa la humanidad dentro de ella.
En este sentido, el ser humano puede entenderse como un punto de encuentro entre la biología y la conciencia. Nuestro cuerpo pertenece plenamente al mundo natural, pero nuestra mente nos permite observar, interpretar y transformar ese mismo mundo. Esta doble condición —biológica y reflexiva— hace que la relación entre humanidad y naturaleza sea particularmente compleja.
Reconocer al ser humano como organismo natural constituye un paso importante para comprender nuestra verdadera posición dentro de la biosfera. No somos observadores externos del mundo vivo, sino una de sus expresiones. Nuestra especie forma parte de la red de relaciones que sostiene la vida en el planeta y comparte con otros organismos la misma dependencia de los sistemas ecológicos.
Desde esta perspectiva, el estudio biológico del ser humano no solo revela los mecanismos de nuestro funcionamiento corporal, sino también nuestra conexión profunda con el resto de la vida. Comprender esta conexión es fundamental para afrontar los desafíos ambientales y científicos del presente, así como para reflexionar sobre el papel que la humanidad desempeña dentro de la historia natural del planeta.
Comparación anatómica entre esqueletos de grandes primates y del ser humano. Estas similitudes estructurales muestran que nuestra especie forma parte del grupo de los primates y comparte con ellos un origen evolutivo común. Fuente: Museo de Zoología de la Universidad de Cambridge (Wikimedia Commons). User: DeFacto. Creative Commons Attribution-Share Alike 4.0. Original file (4,545 × 2,859 pixels, file size: 1.29 MB).
La comparación anatómica entre el ser humano y los grandes primates constituye una de las evidencias más claras de nuestro lugar dentro de la evolución biológica. Al observar los esqueletos de chimpancés, gorilas u orangutanes junto al de un ser humano, resulta evidente que todos ellos comparten un mismo plan estructural. La disposición de los huesos, la forma de las extremidades, la organización de la columna vertebral o la estructura de las manos responden a un mismo diseño evolutivo que ha sido modificado gradualmente a lo largo del tiempo. Estas similitudes reflejan un hecho fundamental: el ser humano no es una criatura aislada dentro de la naturaleza, sino una especie que forma parte del grupo de los primates y que comparte con ellos un origen evolutivo común.
Sin embargo, reconocer esta continuidad biológica no significa reducir al ser humano a la condición de un simple simio. La evolución no es un proceso uniforme ni produce organismos idénticos; al contrario, genera formas de vida cada vez más complejas y especializadas a partir de un mismo tronco común. En el caso humano, pequeñas transformaciones acumuladas durante millones de años dieron lugar a cambios profundos en nuestra anatomía y en nuestras capacidades cognitivas.
Uno de los rasgos más visibles es el bipedismo, la capacidad de caminar erguido sobre dos piernas. Esta adaptación modificó profundamente la estructura del esqueleto humano: la pelvis se ensanchó, la columna vertebral adquirió una curvatura característica y las extremidades inferiores se alargaron. Al liberar las manos de la función locomotora, la evolución permitió que estas se especializaran en la manipulación fina de objetos, en la fabricación de herramientas y en innumerables actividades técnicas.
Aún más decisiva fue la expansión del cerebro humano, especialmente de las áreas relacionadas con el lenguaje, el pensamiento abstracto y la planificación. El aumento del volumen cerebral no solo implicó una mayor capacidad cognitiva, sino también el desarrollo de formas complejas de comunicación, cooperación social y transmisión cultural. A diferencia de otras especies, los seres humanos no dependen únicamente de la herencia biológica para adaptarse al entorno; también transmiten conocimientos, técnicas y tradiciones de generación en generación.
Este proceso dio lugar a un fenómeno singular en la historia de la vida: la aparición de una especie capaz de reflexionar sobre sí misma y sobre el mundo que la rodea. La cultura, el lenguaje simbólico, la ciencia, el arte o la organización social compleja son manifestaciones de esta dimensión humana que se ha desarrollado sobre una base biológica compartida con otros primates.
Por tanto, la imagen de los esqueletos comparados nos recuerda una doble realidad. Por un lado, el ser humano pertenece plenamente al mundo natural y a la historia evolutiva de los organismos vivos. Por otro, la evolución ha producido en nuestra especie una combinación de características biológicas y cognitivas que han permitido el surgimiento de una forma de vida extraordinariamente compleja. Comprender esta continuidad y esta singularidad al mismo tiempo es una de las claves para situar correctamente al ser humano dentro de la naturaleza.
1.8. La biología moderna: microbiología, biotecnología y biología molecular
Durante gran parte de la historia, el estudio de la vida se centró en la observación directa de plantas, animales y otros organismos visibles. Los naturalistas describían especies, comparaban sus formas y trataban de comprender cómo se organizaban los seres vivos. Sin embargo, a partir del siglo XX la biología experimentó una transformación profunda. Los avances tecnológicos permitieron explorar el mundo microscópico y molecular que se encuentra en el interior de las células, revelando niveles de organización que antes eran completamente invisibles. Esta nueva etapa dio lugar a lo que hoy conocemos como biología moderna, un campo de investigación que integra disciplinas como la microbiología, la biología molecular y la biotecnología.
Uno de los grandes descubrimientos de la biología moderna fue comprender que gran parte de la vida en la Tierra es microscópica. Los microorganismos —bacterias, arqueas, ciertos hongos, protozoos y virus— constituyen una parte fundamental de la biosfera. Aunque invisibles a simple vista, estos organismos desempeñan funciones esenciales en los ecosistemas. Participan en la descomposición de la materia orgánica, en la fijación de nutrientes y en numerosos procesos químicos que sostienen el equilibrio de los ciclos naturales.
La microbiología, la ciencia que estudia estos organismos microscópicos, ha revelado la extraordinaria diversidad de formas de vida que existen más allá de lo que podemos ver. Muchos microorganismos habitan en el suelo, en el agua o en ambientes extremos donde otras formas de vida no podrían sobrevivir. Otros viven en estrecha asociación con plantas, animales o seres humanos. En el cuerpo humano, por ejemplo, existe una enorme comunidad de bacterias y otros microorganismos que forman lo que se conoce como microbiota. Estas comunidades microbianas desempeñan funciones importantes en procesos como la digestión, la protección frente a patógenos o la regulación del sistema inmunitario.
El estudio de los microorganismos también ha sido fundamental para comprender muchas enfermedades. A finales del siglo XIX se desarrolló la llamada teoría microbiana de la enfermedad, que demostró que numerosas infecciones eran causadas por bacterias u otros microorganismos. Este descubrimiento transformó la medicina, permitiendo el desarrollo de métodos de higiene, vacunas y antibióticos que han salvado millones de vidas.
Paralelamente al desarrollo de la microbiología, otra revolución científica se produjo al descifrar la base molecular de la vida. La biología molecular se centra en estudiar los procesos biológicos a nivel de moléculas, especialmente aquellas relacionadas con la información genética. El descubrimiento de la estructura del ADN en la década de 1950 permitió comprender cómo se almacena, se copia y se transmite la información genética dentro de las células.
Este hallazgo abrió la puerta a una comprensión mucho más profunda de los mecanismos que regulan la vida. Se descubrió que los genes no solo contienen información hereditaria, sino que también dirigen la producción de proteínas, moléculas esenciales para el funcionamiento de los organismos. A partir de entonces, la biología comenzó a estudiar con gran detalle cómo se activan o se silencian los genes, cómo interactúan las proteínas dentro de las células y cómo se organizan las complejas redes de regulación que mantienen el funcionamiento de los organismos.
La biología molecular ha permitido también comparar el material genético de distintas especies y reconstruir su historia evolutiva. Gracias al análisis del ADN, los científicos pueden estudiar las relaciones entre organismos con una precisión sin precedentes. Este tipo de investigaciones ha confirmado que todos los seres vivos comparten ciertos mecanismos moleculares fundamentales, lo que refuerza la idea de un origen común para toda la vida en la Tierra.
A partir de estos conocimientos surgió otro campo de gran importancia: la biotecnología. La biotecnología consiste en aplicar el conocimiento de los procesos biológicos para desarrollar tecnologías útiles en distintos ámbitos. Desde tiempos antiguos, los seres humanos han utilizado organismos vivos para producir alimentos como el pan, el queso o el vino. Sin embargo, la biotecnología moderna va mucho más allá, utilizando herramientas moleculares que permiten modificar y manipular organismos con gran precisión.
Hoy en día, la biotecnología tiene aplicaciones en campos muy diversos. En medicina, permite producir medicamentos como la insulina mediante bacterias modificadas genéticamente, desarrollar terapias basadas en el ADN o diseñar vacunas más eficaces. En agricultura, facilita la mejora de cultivos para aumentar su resistencia a plagas, sequías o enfermedades. En la industria y en la gestión ambiental, los microorganismos pueden utilizarse para producir sustancias útiles o para degradar contaminantes.
Estos avances han ampliado enormemente las posibilidades de la biología, pero también han generado importantes debates éticos y sociales. La capacidad de modificar el material genético de organismos plantea preguntas sobre los límites de la intervención humana en la naturaleza. Tecnologías recientes, como las herramientas de edición genética, permiten alterar genes con una precisión cada vez mayor, lo que abre nuevas perspectivas para tratar enfermedades hereditarias, pero también exige una reflexión cuidadosa sobre sus posibles consecuencias.
La biología moderna se caracteriza, por tanto, por una profunda integración entre diferentes niveles de estudio. Los investigadores analizan la vida desde la escala molecular hasta la escala de los ecosistemas, combinando conocimientos de genética, bioquímica, ecología y evolución. Esta visión integradora permite comprender la vida como un sistema complejo en el que procesos microscópicos pueden tener efectos visibles a gran escala.
Además, la biología contemporánea ha transformado nuestra forma de observar la naturaleza. Ya no vemos los organismos únicamente como estructuras visibles, sino como sistemas dinámicos en los que millones de interacciones moleculares sostienen la actividad vital. Cada célula contiene una red extraordinariamente compleja de procesos que permiten la síntesis de proteínas, la regulación genética, la producción de energía y la comunicación entre distintos componentes del organismo.
En última instancia, la biología moderna ha ampliado de manera espectacular nuestra comprensión de la vida. Gracias a la microbiología, sabemos que el mundo microscópico desempeña un papel esencial en el funcionamiento del planeta. Gracias a la biología molecular, comprendemos los mecanismos fundamentales que permiten almacenar y transmitir información genética. Y gracias a la biotecnología, hemos aprendido a utilizar estos conocimientos para desarrollar nuevas herramientas que influyen en la medicina, la agricultura y la industria.
Sin embargo, estos avances también recuerdan que el conocimiento científico implica una responsabilidad creciente. Cuanto más comprendemos los mecanismos de la vida, mayor es nuestra capacidad para intervenir en ellos. Por ello, el desarrollo de la biología moderna no solo plantea desafíos científicos, sino también cuestiones éticas sobre el modo en que utilizamos ese conocimiento y sobre el futuro de nuestra relación con el mundo vivo.
La imagen muestra un conjunto de placas de Petri utilizadas para el cultivo de microorganismos en un laboratorio. Este tipo de recipientes transparentes, que contienen un medio nutritivo sólido llamado agar, permiten a los científicos cultivar bacterias, hongos y otros microorganismos para observar su crecimiento y estudiar sus características. Las manchas o colonias visibles en la superficie del medio corresponden a poblaciones de microorganismos que se han multiplicado a partir de células individuales.
El desarrollo de técnicas de cultivo microbiológico fue uno de los avances fundamentales de la biología moderna. Gracias a ellas fue posible aislar microorganismos específicos, identificarlos y comprender su papel en numerosos procesos biológicos. A finales del siglo XIX, investigadores como Louis Pasteur o Robert Koch demostraron que muchos microorganismos son responsables de enfermedades infecciosas, dando origen a la llamada teoría microbiana de la enfermedad. Desde entonces, la microbiología se ha convertido en una disciplina central tanto para la medicina como para la biología.
El cultivo de microorganismos permite estudiar numerosos aspectos de su biología: su forma de crecimiento, su metabolismo, su capacidad para producir sustancias químicas o su respuesta frente a antibióticos. En los laboratorios modernos estas técnicas se combinan con herramientas de biología molecular que permiten analizar directamente el ADN de los microorganismos, identificar especies con gran precisión o estudiar los genes responsables de determinadas funciones biológicas.
Además de su importancia médica, la microbiología desempeña un papel fundamental en la biotecnología. Muchos microorganismos se utilizan para producir antibióticos, vitaminas, enzimas industriales o incluso combustibles biológicos. Las bacterias y levaduras han sido modificadas genéticamente para fabricar medicamentos, proteínas terapéuticas y vacunas. En este sentido, los pequeños organismos invisibles al ojo humano se han convertido en aliados esenciales para el desarrollo de la ciencia y de la tecnología moderna.
Las placas de Petri que aparecen en la imagen simbolizan, por tanto, uno de los instrumentos más representativos de la biología contemporánea. En ellas se observa cómo el estudio de la vida ha pasado, en gran medida, del simple examen de los organismos visibles en la naturaleza al análisis detallado de los procesos microscópicos que tienen lugar en células y microorganismos. La biología moderna explora así los mecanismos más íntimos de la vida, desde la estructura molecular del ADN hasta la actividad de los microorganismos que habitan en todos los rincones del planeta.
Ver artículo: La teoría microbiana de la enfermedad.
2.1. Ecosistemas: equilibrio, competencia y cooperación.
2.2. Cadenas tróficas: energía, depredación y ciclos.
2.3. Biodiversidad: riqueza biológica y fragilidad.
2.4. El impacto humano: la naturaleza modificada por la civilización.
2.5. Crisis climática y degradación ambiental.
2.6. La ecología como ciencia moral indirecta: responsabilidad y futuro.
2.7. Naturaleza y civilización: convivencia o destrucción.

La ecología estudia las complejas relaciones entre los seres vivos y su entorno. En la naturaleza, plantas, animales, microorganismos y factores físicos como el agua, la luz o el clima forman sistemas interdependientes que sostienen el equilibrio de los ecosistemas del planeta.
La vida en la Tierra no se organiza como una colección de organismos aislados, sino como una vasta red de relaciones en la que cada especie depende, de una u otra forma, de muchas otras. Los ecosistemas integran estas interacciones en sistemas dinámicos donde circulan la energía y los nutrientes, manteniendo el equilibrio de la biosfera. La ecología estudia precisamente estas conexiones profundas entre organismos, ambiente y ciclos naturales, ayudándonos a comprender tanto la extraordinaria complejidad de la naturaleza como la fragilidad de los equilibrios que la sostienen.
2. La ecología: la naturaleza como sistema
La vida en la Tierra no puede comprenderse plenamente si se estudia únicamente a través de organismos individuales. Cada planta, cada animal y cada microorganismo forma parte de un entramado mucho más amplio de relaciones que conectan a los seres vivos entre sí y con el entorno físico que los rodea. Estas relaciones constituyen el objeto de estudio de la ecología, una de las ramas más integradoras de la biología. La ecología analiza cómo interactúan los organismos con su ambiente, cómo se organizan las comunidades biológicas y cómo circulan la energía y los nutrientes a través de los sistemas naturales.
La palabra ecología procede del griego oikos, que significa “casa” o “hogar”, y logos, que significa “estudio”. En este sentido, la ecología puede entenderse como el estudio del hogar natural de los seres vivos. No se trata simplemente de describir especies o clasificar organismos, sino de comprender cómo se relacionan entre sí y cómo dependen de los elementos físicos del entorno, como el agua, el suelo, la luz solar o la temperatura. Desde esta perspectiva, la naturaleza aparece como un sistema complejo en el que numerosos componentes interactúan constantemente.
Una de las ideas centrales de la ecología es que los seres vivos están conectados por múltiples relaciones de dependencia. Las plantas capturan energía solar y producen materia orgánica mediante la fotosíntesis. Los animales herbívoros se alimentan de esas plantas, y a su vez son consumidos por depredadores. Los microorganismos descomponen los restos orgánicos y devuelven los nutrientes al suelo, permitiendo que el ciclo de la vida continúe. Este flujo continuo de materia y energía constituye uno de los procesos fundamentales que mantienen el funcionamiento de los ecosistemas.
A través de estos procesos, la naturaleza se organiza en sistemas relativamente estables llamados ecosistemas. Un ecosistema incluye tanto a los organismos vivos como a los factores físicos que influyen en ellos. Un bosque, un lago, una pradera o un arrecife de coral son ejemplos de ecosistemas donde miles de especies interactúan dentro de un entorno determinado. En cada uno de estos sistemas se establecen equilibrios dinámicos que permiten la coexistencia de numerosas formas de vida.
Estos equilibrios no significan que la naturaleza permanezca inmóvil. Los ecosistemas están en constante transformación. Las poblaciones de organismos cambian, las condiciones ambientales fluctúan y las comunidades biológicas se reorganizan con el tiempo. Sin embargo, dentro de ciertos límites, los ecosistemas poseen mecanismos de regulación que tienden a mantener la estabilidad del sistema. Esta capacidad de autorregulación ha permitido que la vida persista en la Tierra durante miles de millones de años a pesar de los cambios geológicos y climáticos.
El desarrollo de la ecología como ciencia moderna comenzó a consolidarse durante los siglos XIX y XX, cuando los científicos empezaron a estudiar las comunidades biológicas de forma sistemática. Los naturalistas observaron que las especies no se distribuyen al azar, sino que forman asociaciones características dependiendo de las condiciones ambientales. Con el tiempo, estas observaciones llevaron a comprender que la naturaleza funciona como una red de interacciones complejas en la que cada especie ocupa un papel dentro del sistema.
El avance de la investigación ecológica ha mostrado también que los procesos que ocurren en los ecosistemas locales están conectados con fenómenos a escala planetaria. La actividad de los organismos vivos influye en los grandes ciclos biogeoquímicos que regulan el funcionamiento de la Tierra. El ciclo del carbono, por ejemplo, conecta la fotosíntesis de las plantas con la respiración de los animales y la descomposición de los microorganismos. Del mismo modo, los ciclos del nitrógeno o del fósforo dependen en gran medida de la actividad biológica.
A escala global, todos los ecosistemas del planeta forman parte de un sistema mayor: la biosfera. La biosfera incluye el conjunto de todos los seres vivos y los ambientes donde puede existir vida. Dentro de este sistema global, los procesos ecológicos contribuyen a regular factores tan importantes como la composición de la atmósfera, la fertilidad del suelo o el equilibrio de los océanos. En este sentido, la vida no solo se adapta al planeta, sino que también participa activamente en la configuración de las condiciones que hacen posible su existencia.
En las últimas décadas, el estudio de la ecología ha adquirido una relevancia creciente debido al impacto de las actividades humanas sobre los sistemas naturales. La expansión de las ciudades, la transformación de paisajes, la explotación intensiva de recursos y la contaminación han alterado numerosos ecosistemas en todo el planeta. Estos cambios han puesto de manifiesto la fragilidad de muchos equilibrios ecológicos y la importancia de comprender mejor cómo funcionan los sistemas naturales.
La ecología no se limita por tanto a describir la naturaleza, sino que también proporciona herramientas para comprender las consecuencias de nuestras acciones sobre el medio ambiente. El conocimiento de las relaciones ecológicas permite evaluar cómo ciertas actividades humanas pueden afectar a la biodiversidad, a los ciclos naturales o a la estabilidad de los ecosistemas. De este modo, la ecología se ha convertido en una disciplina clave para afrontar algunos de los desafíos ambientales más importantes de nuestro tiempo.
Comprender la naturaleza como un sistema interconectado implica adoptar una mirada más amplia sobre el mundo vivo. Cada organismo forma parte de una red de relaciones que lo vincula con otros seres vivos y con el entorno físico. Ninguna especie existe completamente aislada, y los cambios que afectan a un elemento del sistema pueden repercutir en muchos otros.
Desde esta perspectiva, la ecología revela una imagen de la naturaleza profundamente interdependiente. La vida en la Tierra funciona como un vasto sistema en el que la energía fluye, la materia se recicla y las especies interactúan dentro de comunidades complejas. Estudiar estos sistemas permite comprender mejor la organización del mundo natural y, al mismo tiempo, invita a reflexionar sobre el lugar que ocupa la humanidad dentro de esa red de relaciones que sostiene la vida en el planeta.
2.1. Ecosistemas: equilibrio, competencia y cooperación
Los ecosistemas constituyen una de las unidades fundamentales para comprender cómo funciona la vida en la Tierra. Un ecosistema puede definirse como un sistema natural en el que interactúan organismos vivos —plantas, animales, hongos y microorganismos— junto con los elementos físicos del entorno, como el suelo, el agua, la luz y el clima. Dentro de estos sistemas, todos los componentes se encuentran conectados mediante flujos de energía, ciclos de nutrientes y una compleja red de relaciones biológicas.
Lejos de ser un conjunto caótico de organismos, los ecosistemas presentan una cierta organización interna. Cada especie ocupa un papel específico dentro del sistema, relacionado con la forma en que obtiene alimento, se reproduce o interactúa con otras especies. Estas funciones ecológicas contribuyen a la estabilidad general del sistema y permiten que múltiples organismos puedan coexistir dentro de un mismo ambiente.
Uno de los aspectos más interesantes de los ecosistemas es el equilibrio dinámico que tiende a establecerse entre sus diferentes componentes. Este equilibrio no implica que el sistema permanezca inmóvil o perfectamente estable. En realidad, las poblaciones de organismos cambian continuamente: algunas especies aumentan, otras disminuyen, y las condiciones ambientales pueden variar con las estaciones o con cambios climáticos más amplios. Sin embargo, dentro de ciertos límites, los ecosistemas poseen mecanismos de regulación que tienden a mantener su funcionamiento general.
Por ejemplo, cuando una población de herbívoros crece demasiado, puede consumir una mayor cantidad de vegetación. Esto puede provocar una reducción de los recursos disponibles, lo que a su vez limita el crecimiento de esa misma población. Al mismo tiempo, el aumento de herbívoros puede favorecer a los depredadores que se alimentan de ellos, contribuyendo también a regular su número. Este tipo de interacciones muestra cómo los ecosistemas funcionan como sistemas autorregulados donde distintas fuerzas biológicas se equilibran mutuamente.
Dentro de los ecosistemas, la competencia constituye una de las relaciones más comunes entre organismos. La competencia aparece cuando dos o más especies, o incluso individuos de la misma especie, necesitan los mismos recursos limitados, como alimento, agua, espacio o luz. En un bosque, por ejemplo, diferentes plantas pueden competir por la luz solar; en un ecosistema marino, numerosos animales pueden competir por las mismas presas.
La competencia desempeña un papel importante en la organización de las comunidades biológicas. A lo largo del tiempo, las especies que compiten por recursos similares pueden desarrollar estrategias distintas que les permitan coexistir. Algunas pueden especializarse en distintos tipos de alimento, otras pueden ocupar diferentes zonas del hábitat o aprovechar recursos en momentos distintos del día o del año. Este fenómeno, conocido como diferenciación ecológica, reduce la competencia directa y permite que múltiples especies compartan un mismo ecosistema.
Sin embargo, la vida en los ecosistemas no se basa únicamente en la competencia. Muchas relaciones entre organismos implican también formas de cooperación o interdependencia. Algunas especies desarrollan relaciones mutuamente beneficiosas que favorecen la supervivencia de ambas. Este tipo de interacción, conocido como mutualismo, es muy común en la naturaleza.
Un ejemplo clásico de cooperación ecológica es la relación entre plantas con flores e insectos polinizadores. Las plantas proporcionan néctar o polen como alimento, mientras que los insectos transportan el polen de una flor a otra, facilitando la reproducción de la planta. Ambos organismos se benefician de esta interacción, y con el tiempo muchas de estas relaciones han evolucionado hacia formas de cooperación muy especializadas.
Otro ejemplo notable se encuentra en los líquenes, asociaciones entre hongos y algas o cianobacterias. El hongo proporciona protección y estructura, mientras que el organismo fotosintético produce nutrientes mediante la fotosíntesis. Este tipo de asociación muestra hasta qué punto la cooperación puede integrarse profundamente en la organización de la vida.
En los ecosistemas también existen relaciones más complejas, como el parasitismo, en el que un organismo vive a expensas de otro, o el comensalismo, donde una especie se beneficia sin perjudicar significativamente a la otra. Todas estas interacciones contribuyen a formar la red ecológica que conecta a los organismos dentro de un mismo sistema.
La coexistencia de competencia y cooperación revela una característica fundamental de los ecosistemas: la vida se organiza a través de una diversidad de relaciones que pueden ser simultáneamente conflictivas y colaborativas. Las especies compiten por recursos, pero al mismo tiempo dependen unas de otras para procesos esenciales como la polinización, la dispersión de semillas o el reciclaje de nutrientes.
Esta complejidad de interacciones permite que los ecosistemas mantengan una gran diversidad de especies. Cuanto más variadas son las relaciones entre organismos, mayor suele ser la estabilidad del sistema. La diversidad biológica contribuye a que los ecosistemas sean más resistentes frente a perturbaciones, ya que la presencia de múltiples especies puede compensar la pérdida o disminución de alguna de ellas.
Comprender los ecosistemas implica reconocer que la vida se organiza en redes de interdependencia donde cada organismo desempeña un papel dentro del conjunto. Ninguna especie vive completamente aislada, y las relaciones entre organismos pueden influir profundamente en la estructura y funcionamiento del sistema.
Desde esta perspectiva, los ecosistemas pueden entenderse como sistemas vivos a gran escala, donde la energía fluye, los nutrientes circulan y las especies interactúan dentro de una red compleja de relaciones. Analizar estas conexiones permite comprender mejor cómo se mantiene el equilibrio de la naturaleza y cómo la diversidad de la vida se sostiene a través de un delicado balance entre competencia, cooperación e interdependencia.
Vista aérea de un gran sistema fluvial en la cuenca amazónica, donde el río serpentea formando meandros y zonas inundables rodeadas por selva tropical. Vista aérea de una llanura de inundación en selva amazónica cerca de Manaos. — Fuente: Wikipedia / Wikimedia Commons, licencia Creative Commons. User: CIAT – Amazon17. CC BY-SA 2.0. Original file (4,288 × 2,848 pixels, file size: 1.46 MB). Los grandes ríos tropicales, como los de la Amazonía, forman algunos de los ecosistemas más complejos del planeta. En ellos interactúan el agua, la vegetación, los suelos y miles de especies animales en un delicado equilibrio ecológico.
La fotografía muestra un paisaje característico de los grandes sistemas fluviales tropicales, donde el río serpentea lentamente a través de una inmensa extensión de selva. Este tipo de paisaje no es solo una forma geográfica: es un ejemplo extraordinario de ecosistema en funcionamiento. Un ecosistema es, en esencia, una red de relaciones entre organismos vivos y el medio físico que los rodea. El agua, el suelo, la vegetación, los microorganismos, los peces, los insectos, las aves y los mamíferos forman parte de una misma trama dinámica.
En los ríos amazónicos el agua marca el ritmo de la vida. Las crecidas estacionales inundan grandes extensiones de bosque, creando lo que se conoce como bosques inundables. Durante estos periodos, peces y otros animales penetran en la selva anegada para alimentarse de frutos, semillas y pequeños organismos. Cuando el agua retrocede, el suelo queda enriquecido con nutrientes transportados por el río. Así se establece un ciclo continuo de fertilidad que sostiene una biodiversidad extraordinaria.
En este entorno natural se observa con claridad uno de los principios fundamentales de los ecosistemas: el equilibrio dinámico. No se trata de un equilibrio estático, sino de una constante interacción entre fuerzas diferentes. Los organismos compiten por recursos como alimento, espacio o luz, pero al mismo tiempo cooperan indirectamente dentro del sistema. Las plantas, por ejemplo, capturan energía solar mediante la fotosíntesis y generan materia orgánica que sirve de base a toda la cadena de vida. Los herbívoros se alimentan de ellas, los depredadores de los herbívoros, y los descomponedores transforman los restos orgánicos en nutrientes que vuelven al suelo.
Los ríos, además, actúan como auténticas arterias ecológicas. Transportan sedimentos, nutrientes y organismos a lo largo de enormes distancias, conectando diferentes hábitats. Un mismo sistema fluvial puede incluir bosques tropicales, humedales, lagunas, islas fluviales y zonas pantanosas, cada una con comunidades biológicas distintas pero interdependientes.
Este tipo de ecosistema también pone de manifiesto la importancia de la diversidad biológica. Cuanto mayor es la variedad de especies, más estable suele ser el sistema. Cada organismo ocupa un papel específico dentro de la red ecológica: algunos dispersan semillas, otros controlan poblaciones de insectos, otros reciclan materia orgánica. La desaparición de una sola especie puede alterar estas relaciones y provocar cambios en cadena.
Por eso los grandes sistemas naturales como el de la Amazonía representan auténticos laboratorios vivos para comprender cómo funciona la naturaleza. En ellos se hace visible la complejidad de los procesos ecológicos y la profunda interdependencia que existe entre todos los elementos del medio natural. Más que simples paisajes, son sistemas vivos en los que cada componente, desde una bacteria del suelo hasta un gran depredador, participa en el delicado tejido que sostiene la vida.
Arrecife de coral tropical, uno de los ecosistemas marinos más diversos y complejos del planeta, formado por colonias de corales que construyen estructuras calcáreas donde habitan miles de especies de peces, invertebrados y algas. — Video: Envato Elements, autor: Kotangens.
Los arrecifes de coral representan uno de los ecosistemas más espectaculares y complejos del planeta. A primera vista pueden parecer simples formaciones rocosas bajo el agua, pero en realidad son estructuras vivas construidas durante miles de años por diminutos animales llamados pólipos coralinos. Estos organismos secretan esqueletos de carbonato cálcico que, generación tras generación, van formando auténticos paisajes submarinos compuestos por crestas, cavernas, plataformas y laberintos de coral.
Lo más sorprendente de estos ecosistemas es su extraordinaria biodiversidad. A pesar de ocupar menos del uno por ciento del fondo oceánico, los arrecifes albergan aproximadamente una cuarta parte de todas las especies marinas conocidas. En ellos viven miles de especies de peces, moluscos, crustáceos, esponjas, algas y otros organismos que encuentran refugio, alimento y lugares de reproducción entre las complejas estructuras coralinas.
Este fenómeno biológico recuerda, en cierto sentido, al funcionamiento de las grandes selvas tropicales terrestres. En ambos casos, la abundancia de nichos ecológicos permite la coexistencia de un número enorme de especies. Cada rincón del arrecife —una grieta del coral, una superficie iluminada por el sol, una zona de sombra o una pequeña cavidad— puede convertirse en el hogar de un organismo distinto. El resultado es una red de relaciones ecológicas extraordinariamente rica y delicada.
En el corazón de este sistema existe una relación simbiótica fundamental que sostiene la productividad del arrecife. Los corales mantienen una asociación con microalgas llamadas zooxantelas que viven en sus tejidos. Estas algas realizan la fotosíntesis y proporcionan al coral gran parte de la energía que necesita para crecer y construir su esqueleto calcáreo. A cambio, el coral les ofrece protección y acceso a compuestos químicos necesarios para la fotosíntesis. Este intercambio constituye uno de los ejemplos más elegantes de cooperación biológica en la naturaleza.
Gracias a esta cooperación microscópica se mantiene un ecosistema gigantesco. Sobre la base de los corales prosperan peces herbívoros que se alimentan de algas, depredadores que cazan a estos peces y numerosos organismos filtradores que limpian el agua. Así se forma una compleja red trófica en la que cada especie desempeña un papel específico. La estabilidad del arrecife depende precisamente de ese equilibrio entre competencia, cooperación y reciclaje continuo de nutrientes.
Los arrecifes también cumplen funciones ecológicas fundamentales para el planeta. Actúan como viveros naturales donde se desarrollan numerosas especies de peces que posteriormente se dispersan por el océano. Además, las barreras coralinas amortiguan el impacto de las olas y protegen muchas costas tropicales frente a tormentas y erosión marina. Millones de personas dependen indirectamente de estos ecosistemas para la pesca, el turismo y la protección de sus comunidades costeras.
Sin embargo, la delicada armonía de los arrecifes se encuentra hoy seriamente amenazada. El aumento de la temperatura del océano, la contaminación, la sobrepesca y la acidificación marina pueden alterar el frágil equilibrio que mantiene vivos estos sistemas. Cuando las condiciones ambientales se deterioran, los corales expulsan las algas simbióticas que les proporcionan energía, provocando el fenómeno conocido como blanqueamiento coralino. Si esta situación se prolonga, el coral muere y todo el ecosistema asociado puede colapsar.
Por esta razón, los arrecifes de coral se han convertido en uno de los símbolos más claros de la interdependencia entre la vida y el medio ambiente. Son ecosistemas extraordinariamente productivos, pero también extremadamente sensibles. Su estudio nos recuerda hasta qué punto la naturaleza funciona como un sistema complejo en el que innumerables organismos cooperan, compiten y se adaptan dentro de un equilibrio siempre dinámico.
2.2. Cadenas tróficas: energía, depredación y ciclos
Una de las formas más claras de comprender cómo funcionan los ecosistemas es observar el modo en que la energía circula entre los organismos. Ningún ser vivo puede existir sin una fuente de energía que sostenga sus funciones vitales. Desde el crecimiento de una planta hasta el movimiento de un animal o la actividad metabólica de una célula, todos los procesos biológicos dependen de un flujo continuo de energía. En los ecosistemas, esta energía se transmite de unos organismos a otros a través de relaciones alimentarias que forman lo que se conoce como cadenas tróficas.
Una cadena trófica describe el camino que sigue la energía dentro de un ecosistema desde su origen hasta los distintos organismos que la utilizan. En la mayoría de los casos, la fuente primaria de energía es el Sol. Las plantas, las algas y algunos microorganismos capturan la energía solar mediante la fotosíntesis y la transforman en materia orgánica. Estos organismos constituyen el primer nivel de la cadena trófica y reciben el nombre de productores, porque producen el alimento que sustenta a muchos otros seres vivos.
Los organismos que se alimentan de los productores forman el siguiente nivel trófico. Estos consumidores primarios suelen ser animales herbívoros, como insectos, roedores o grandes mamíferos que se alimentan de plantas. Al consumir materia vegetal, incorporan la energía química que las plantas han producido gracias a la fotosíntesis. Esta energía permite a los herbívoros crecer, moverse y reproducirse.
Por encima de los herbívoros aparecen los consumidores secundarios, que se alimentan de otros animales. Estos depredadores pueden ser pequeños carnívoros, aves rapaces, peces o grandes mamíferos que capturan presas para alimentarse. En algunos ecosistemas existen incluso consumidores terciarios o superdepredadores que ocupan la cima de la cadena alimentaria y tienen pocos o ningún enemigo natural.
Sin embargo, las cadenas tróficas no son simples secuencias lineales. En la naturaleza, los organismos suelen alimentarse de múltiples especies y formar redes alimentarias mucho más complejas. Un mismo animal puede consumir diferentes tipos de alimento y ser a su vez presa de varios depredadores. Por esta razón, los ecólogos suelen hablar de redes tróficas en lugar de cadenas simples, para describir mejor la compleja interconexión entre las especies.
Un aspecto fundamental del flujo de energía en los ecosistemas es que la energía no se recicla de la misma manera que la materia. En cada transferencia entre niveles tróficos, una parte considerable de la energía se pierde en forma de calor o se utiliza en procesos metabólicos. Por ello, la cantidad de energía disponible disminuye progresivamente a medida que se asciende en la cadena trófica. Esta limitación energética explica por qué los ecosistemas suelen tener muchos productores, menos herbívoros y todavía menos depredadores.
La depredación desempeña un papel importante en la regulación de las poblaciones dentro de los ecosistemas. Los depredadores controlan el número de sus presas, evitando que ciertas especies se multipliquen de manera excesiva. A su vez, las poblaciones de depredadores dependen de la disponibilidad de alimento, lo que crea una dinámica de equilibrio entre distintas especies. Estas interacciones contribuyen a mantener la estabilidad del ecosistema a lo largo del tiempo.
La energía fluye a través de las cadenas tróficas, pero la materia sigue un camino diferente. Los elementos químicos que forman los organismos —como el carbono, el nitrógeno o el fósforo— se reciclan continuamente en la naturaleza mediante procesos biológicos y geológicos. Cuando los organismos mueren o producen residuos, los descomponedores, como bacterias y hongos, degradan la materia orgánica y liberan nutrientes que vuelven a integrarse en el suelo o en el agua.
Gracias a este proceso de descomposición, los nutrientes quedan nuevamente disponibles para las plantas y otros organismos productores. De este modo, los elementos químicos circulan en ciclos naturales que conectan a todos los seres vivos dentro de un mismo sistema ecológico. Estos ciclos biogeoquímicos son esenciales para el mantenimiento de la vida en el planeta.
El estudio de las cadenas tróficas permite comprender cómo la energía y la materia conectan a los organismos dentro de un ecosistema. Cada especie participa en este flujo de recursos y contribuye al funcionamiento del sistema. Cuando una especie desaparece o se introduce una nueva especie en un ecosistema, las redes tróficas pueden alterarse, generando efectos que se propagan a lo largo de toda la comunidad biológica.
Por ejemplo, la desaparición de un gran depredador puede provocar un aumento excesivo de herbívoros, lo que a su vez puede afectar a la vegetación y modificar el equilibrio del ecosistema. Del mismo modo, la introducción de especies invasoras puede alterar las relaciones alimentarias y desplazar a especies nativas que ocupaban un papel importante dentro de la red trófica.
Comprender estas conexiones ayuda a percibir la naturaleza como un sistema profundamente interdependiente. La energía que impulsa la vida fluye desde el Sol hacia los organismos y se transmite a través de complejas redes alimentarias. Al mismo tiempo, los nutrientes se reciclan continuamente mediante procesos de descomposición y renovación.
Las cadenas tróficas revelan así uno de los principios fundamentales de la ecología: ningún organismo existe de manera completamente independiente. Cada especie forma parte de un sistema de relaciones que conecta a los productores, consumidores y descomponedores dentro de una misma red de vida. Esta interdependencia energética y material constituye uno de los pilares que sostienen la estabilidad y la continuidad de los ecosistemas del planeta.
Glaciares en retroceso en una región polar o de alta montaña. El aumento de la temperatura global está acelerando el deshielo de estas enormes reservas de agua dulce, uno de los signos más visibles del cambio climático contemporáneo. — Los glaciares funcionan como auténticos archivos climáticos de la Tierra. Su progresiva desaparición en muchas regiones del planeta refleja el impacto creciente de la actividad humana sobre el equilibrio del sistema climático global. Autor: Mvaligursky. (Envato).

La fotografía muestra un glaciar que desciende lentamente entre montañas, una masa gigantesca de hielo formada por la acumulación de nieve durante miles de años. Estas estructuras naturales son mucho más que simples paisajes espectaculares: constituyen uno de los elementos fundamentales del sistema climático de la Tierra. Los glaciares funcionan como enormes reservas de agua dulce, como reguladores de los ríos y como indicadores muy sensibles de los cambios ambientales.
Durante gran parte de la historia del planeta, los glaciares han experimentado ciclos naturales de avance y retroceso asociados a variaciones climáticas a gran escala. Sin embargo, en el último siglo se observa una aceleración notable en su desaparición. En numerosas regiones del mundo —desde los Alpes europeos hasta la Patagonia, desde Groenlandia hasta las grandes cordilleras asiáticas— las masas de hielo están reduciéndose a un ritmo que no tiene precedentes en la historia reciente.
La causa principal de este fenómeno está relacionada con el aumento de la temperatura media global. Desde el inicio de la industrialización moderna, la actividad humana ha liberado enormes cantidades de gases de efecto invernadero a la atmósfera. La combustión de carbón, petróleo y gas natural, junto con la deforestación y determinados procesos industriales, ha incrementado la concentración de dióxido de carbono, metano y otros gases capaces de retener el calor en la atmósfera.
Este aumento del efecto invernadero altera el delicado equilibrio energético del planeta. Una pequeña subida en la temperatura media global puede tener consecuencias enormes en sistemas sensibles como los glaciares. Cuando el hielo comienza a derretirse más rápido de lo que se acumula la nieve en invierno, el glaciar pierde masa y empieza a retroceder. Lo que antes era una lengua de hielo que descendía lentamente por el valle se convierte progresivamente en una masa fragmentada que se adelgaza y se retira hacia las zonas más altas.
Además, el retroceso del hielo produce un fenómeno que intensifica aún más el calentamiento. Las superficies heladas reflejan gran parte de la radiación solar hacia el espacio. Cuando desaparecen, dejan al descubierto rocas oscuras o suelos que absorben más calor. Este proceso, conocido como efecto de albedo, acelera el calentamiento local y favorece un deshielo todavía mayor.
La actividad humana también ha provocado otras alteraciones importantes en la atmósfera terrestre. Durante décadas, ciertas sustancias químicas utilizadas en la industria y en aerosoles contribuyeron al deterioro de la capa de ozono, una franja de la atmósfera que protege la vida en la Tierra al absorber gran parte de la radiación ultravioleta del Sol. Aunque las medidas internacionales han permitido frenar parcialmente este problema, su existencia demuestra hasta qué punto las actividades humanas pueden modificar procesos atmosféricos fundamentales.
El retroceso de los glaciares tiene consecuencias profundas para el equilibrio ecológico y para la vida humana. Estas masas de hielo almacenan una parte enorme del agua dulce del planeta. En muchas regiones montañosas actúan como reguladores naturales del agua, liberándola lentamente durante los meses cálidos y alimentando ríos de los que dependen ecosistemas enteros, sistemas agrícolas y millones de personas.
Su desaparición altera estos ciclos hidrológicos. En una primera fase el deshielo puede aumentar el caudal de los ríos, pero a largo plazo provoca escasez de agua cuando el glaciar deja de existir. Al mismo tiempo, el deshielo de grandes capas de hielo contribuye al aumento del nivel del mar, un fenómeno que amenaza a muchas ciudades costeras y regiones densamente pobladas del planeta.
La imagen de un glaciar que se derrite lentamente es, por tanto, algo más que un paisaje impresionante. Es también un símbolo de la profunda transformación que la civilización humana está provocando en el sistema natural de la Tierra. Los glaciares nos recuerdan que el clima, la atmósfera, los océanos y los ecosistemas forman parte de un mismo sistema interconectado, y que las acciones humanas tienen la capacidad de alterar ese equilibrio a escala global.
Comprender este proceso constituye uno de los grandes desafíos de la ecología contemporánea. No se trata únicamente de estudiar cómo funciona la naturaleza, sino también de reconocer la responsabilidad que la humanidad tiene en la conservación del delicado sistema que hace posible la vida en el planeta.
2.3. Biodiversidad: riqueza biológica y fragilidad
Uno de los rasgos más asombrosos de la vida en la Tierra es su extraordinaria diversidad. Desde los microorganismos invisibles hasta los grandes animales y las complejas comunidades vegetales, el planeta alberga una inmensa variedad de formas de vida. Esta diversidad biológica, conocida como biodiversidad, constituye uno de los pilares fundamentales del funcionamiento de los ecosistemas y uno de los aspectos más valiosos del patrimonio natural del planeta.
La biodiversidad puede entenderse en distintos niveles. En primer lugar, existe diversidad genética dentro de las propias especies. Los individuos de una misma especie no son idénticos entre sí: presentan variaciones en sus genes que pueden influir en su apariencia, su comportamiento o su capacidad para adaptarse al entorno. Esta variabilidad genética es esencial para la evolución, ya que permite que las poblaciones puedan responder a cambios ambientales a lo largo del tiempo.
En segundo lugar, la biodiversidad incluye la diversidad de especies. La Tierra alberga millones de especies distintas de plantas, animales, hongos y microorganismos, cada una con su propia forma de vida, su modo de alimentación y su papel dentro de los ecosistemas. Algunas especies son muy abundantes y ampliamente distribuidas, mientras que otras existen solo en regiones muy concretas del planeta.
Finalmente, la biodiversidad también se manifiesta en la diversidad de ecosistemas. Bosques tropicales, praderas, desiertos, humedales, arrecifes de coral o tundras representan ambientes muy distintos donde las condiciones climáticas, el suelo y la disponibilidad de agua permiten el desarrollo de comunidades biológicas específicas. Cada ecosistema alberga combinaciones particulares de especies adaptadas a esas condiciones.
Esta diversidad no es fruto del azar. Es el resultado de una larga historia evolutiva que se extiende durante miles de millones de años. A lo largo de este tiempo, las especies han surgido, se han transformado y en muchos casos se han extinguido. Las condiciones ambientales cambiantes, las migraciones de organismos y los procesos de selección natural han ido configurando el mosaico biológico que observamos en la actualidad.
La biodiversidad desempeña un papel fundamental en el funcionamiento de los ecosistemas. Cuanto mayor es la diversidad de especies, mayor suele ser la estabilidad del sistema. Diferentes organismos cumplen funciones ecológicas complementarias: algunos producen materia orgánica, otros la consumen, otros reciclan nutrientes o contribuyen a procesos como la polinización y la dispersión de semillas. Esta variedad de funciones permite que los ecosistemas mantengan su equilibrio incluso cuando cambian las condiciones ambientales.
La diversidad biológica también proporciona numerosos beneficios directos e indirectos para la humanidad. Los ecosistemas ricos en biodiversidad contribuyen a la fertilidad del suelo, a la regulación del clima, a la purificación del agua y al mantenimiento de los ciclos naturales de nutrientes. Muchas plantas y microorganismos han proporcionado sustancias que se utilizan en medicina, y numerosos cultivos agrícolas dependen de la polinización realizada por insectos y otros animales.
Además de su valor ecológico y utilitario, la biodiversidad posee también un valor cultural y estético. Los paisajes naturales, la variedad de formas vivas y la riqueza de los ecosistemas han inspirado a lo largo de la historia el arte, la literatura y la reflexión filosófica. La diversidad de la vida forma parte del patrimonio natural de la humanidad y constituye un elemento esencial para comprender la historia de la vida en el planeta.
Sin embargo, esta riqueza biológica es también extraordinariamente frágil. A lo largo de la historia de la Tierra han ocurrido episodios de extinción masiva en los que desaparecieron numerosas especies debido a cambios climáticos, erupciones volcánicas o impactos de meteoritos. En la actualidad, muchos científicos consideran que el planeta atraviesa una nueva fase de pérdida acelerada de biodiversidad, provocada principalmente por la actividad humana.
La transformación de los hábitats naturales es uno de los factores más importantes que amenazan la biodiversidad. La expansión de la agricultura, la urbanización y la explotación de recursos han reducido o fragmentado muchos ecosistemas, limitando el espacio disponible para numerosas especies. Cuando los hábitats se degradan o desaparecen, muchas especies no pueden adaptarse con suficiente rapidez y terminan extinguiéndose.
Otros factores también contribuyen a esta pérdida de biodiversidad. La introducción de especies invasoras puede alterar el equilibrio de los ecosistemas y desplazar a especies nativas. La contaminación de suelos, aguas y atmósfera afecta a numerosos organismos. El cambio climático modifica las condiciones ambientales y obliga a muchas especies a desplazarse o adaptarse a nuevas circunstancias.
La desaparición de especies no solo implica la pérdida de formas de vida individuales, sino también la alteración de las redes ecológicas que sostienen los ecosistemas. Cuando una especie desaparece, otras que dependían de ella pueden verse afectadas, generando efectos en cadena dentro del sistema. Por esta razón, la pérdida de biodiversidad puede tener consecuencias profundas para el funcionamiento de los ecosistemas.
Comprender la importancia de la biodiversidad implica reconocer que la vida en la Tierra forma un sistema complejo en el que cada especie desempeña un papel dentro del conjunto. La riqueza biológica del planeta no es simplemente una colección de organismos, sino una red de relaciones que mantiene el equilibrio de los ecosistemas.
La conservación de la biodiversidad se ha convertido por ello en uno de los grandes desafíos del mundo contemporáneo. Proteger los ecosistemas, preservar los hábitats naturales y gestionar de forma responsable los recursos del planeta son acciones fundamentales para mantener la diversidad de la vida. En última instancia, la protección de la biodiversidad no solo se refiere a la conservación de especies individuales, sino al mantenimiento de los sistemas ecológicos que hacen posible la vida en la Tierra.
La biodiversidad representa así una combinación de riqueza y fragilidad. Es el resultado de una larga historia evolutiva que ha producido una extraordinaria variedad de formas de vida, pero al mismo tiempo puede verse alterada con relativa rapidez si se modifican los equilibrios que sostienen los ecosistemas. Reconocer esta doble dimensión es esencial para comprender la importancia de preservar la diversidad biológica del planeta y asegurar la continuidad de la vida en sus múltiples manifestaciones.
Bosque húmedo de selva tropical con abundante vegetación y helechos arborescentes, un ejemplo representativo de los ecosistemas terrestres con mayor biodiversidad del planeta. — Las selvas tropicales concentran una parte extraordinaria de la biodiversidad mundial. En estos ecosistemas húmedos y cálidos conviven miles de especies de plantas, animales, hongos y microorganismos que forman redes ecológicas de enorme complejidad. Imagen: © Kjwells86 / Envato Elements.

Las selvas tropicales representan uno de los grandes centros de biodiversidad de la Tierra. Estos ecosistemas, caracterizados por un clima cálido y húmedo durante todo el año, ofrecen condiciones excepcionalmente favorables para el desarrollo de la vida. La abundancia de agua, la estabilidad climática y la intensa radiación solar permiten que la vegetación crezca de forma exuberante, creando una estructura vegetal compleja que sirve de soporte a innumerables especies.
En un bosque tropical, la diversidad biológica no se limita únicamente al número de especies presentes, sino también a la extraordinaria variedad de relaciones ecológicas que se establecen entre ellas. Árboles gigantes, lianas, musgos, helechos y plantas epífitas ocupan diferentes niveles del bosque, desde el suelo hasta el dosel superior. Cada uno de estos niveles constituye un microhábitat con condiciones particulares de luz, humedad y temperatura, lo que permite la coexistencia de organismos muy distintos en un mismo espacio.
La imagen de esta selva ilustra bien esa riqueza vegetal. Los helechos arborescentes, las densas capas de vegetación y la presencia de múltiples especies de árboles crean un entorno tridimensional en el que la vida se despliega en todas direcciones. En este ambiente habitan insectos, anfibios, reptiles, aves y mamíferos que dependen de la vegetación para alimentarse, refugiarse o reproducirse. Incluso el suelo del bosque, cubierto por hojas en descomposición, alberga una enorme comunidad de hongos, bacterias y pequeños invertebrados que participan en el reciclaje de la materia orgánica.
Este proceso de reciclaje es uno de los mecanismos fundamentales que sostienen la productividad de los ecosistemas tropicales. Aunque los suelos de muchas selvas no son especialmente ricos en nutrientes, la rápida descomposición de la materia orgánica permite que los nutrientes circulen continuamente entre las plantas, los animales y los microorganismos. Así se mantiene un ciclo biológico permanente que sustenta la extraordinaria densidad de vida característica de estos ecosistemas.
Las selvas tropicales también desempeñan un papel esencial en el equilibrio global del planeta. Funcionan como importantes reguladores climáticos, absorbiendo grandes cantidades de dióxido de carbono y liberando oxígeno a la atmósfera mediante la fotosíntesis. Además, influyen en los ciclos del agua, ya que la evapotranspiración de la vegetación contribuye a la formación de nubes y precipitaciones que alimentan ríos y sistemas hidrológicos a gran escala.
Sin embargo, esta riqueza biológica es también extremadamente vulnerable. La deforestación, la expansión agrícola, la explotación maderera y la construcción de infraestructuras están reduciendo la extensión de las selvas tropicales en muchas regiones del mundo. Cuando estos ecosistemas se fragmentan o desaparecen, no solo se pierden árboles, sino también innumerables especies que dependen de ellos para sobrevivir. Cada fragmento de bosque que desaparece puede significar la pérdida irreversible de formas de vida que aún ni siquiera han sido estudiadas por la ciencia.
Por esta razón, las selvas tropicales se consideran auténticos tesoros biológicos del planeta. En ellas se concentra una parte fundamental de la diversidad genética de la biosfera, una riqueza que sostiene el funcionamiento de los ecosistemas y que posee un valor incalculable para el futuro de la humanidad. Comprender la importancia de estos bosques y preservar su integridad se ha convertido en uno de los grandes retos de la ecología contemporánea, pues de su conservación depende en gran medida el equilibrio natural de la Tierra.
Mariposa Morpho azul (Morpho spp.) posada sobre una hoja en la selva tropical. Sus alas de intenso color azul metálico son uno de los ejemplos más llamativos de adaptación evolutiva y diversidad biológica en los ecosistemas tropicales. — Imagen: © Shaiith / Envato Elements.

Las mariposas del género Morpho, conocidas popularmente como mariposas Morpho azules, constituyen uno de los ejemplos más emblemáticos de la biodiversidad de las selvas tropicales americanas. Habitan principalmente en los bosques húmedos de América Central y del Sur, desde México hasta la Amazonía, donde forman parte de los complejos ecosistemas que caracterizan estas regiones de extraordinaria riqueza biológica.
Su rasgo más distintivo es el intenso color azul metálico de sus alas. Este color no se debe a pigmentos convencionales, sino a un fenómeno óptico conocido como coloración estructural. Las escamas microscópicas que cubren las alas poseen estructuras capaces de reflejar la luz de una forma muy particular, produciendo ese brillante tono azul que parece cambiar de intensidad según el ángulo desde el que se observe. Este mecanismo físico, resultado de millones de años de evolución, ilustra la sofisticación de las adaptaciones biológicas que pueden desarrollarse en ambientes con una intensa competencia ecológica.
En el entorno de la selva tropical, la diversidad de especies es extraordinaria. Miles de plantas, insectos, aves, reptiles y mamíferos conviven en un espacio relativamente reducido, creando una compleja red de relaciones ecológicas. En este contexto, cada organismo debe encontrar su propio nicho ecológico para sobrevivir. Las mariposas Morpho, por ejemplo, se alimentan principalmente de jugos de frutas fermentadas, savia de árboles y otras sustancias ricas en azúcares que encuentran en el suelo del bosque o en la vegetación.
Su vuelo lento y ondulante entre los claros del bosque constituye una de las imágenes más características de la selva tropical. Sin embargo, su brillante color azul cumple también funciones ecológicas importantes. Cuando la mariposa vuela, los destellos de luz azul aparecen y desaparecen rápidamente, lo que puede confundir a los depredadores. Curiosamente, la parte inferior de sus alas presenta tonos marrones con manchas que recuerdan a ojos, un patrón que actúa como camuflaje cuando el insecto se posa sobre la vegetación.
Este tipo de adaptaciones refleja uno de los aspectos fundamentales de la biodiversidad: la enorme variedad de soluciones evolutivas que la vida ha desarrollado para enfrentar los desafíos del entorno. En las selvas tropicales, donde la competencia por alimento, espacio y reproducción es particularmente intensa, la evolución ha favorecido una extraordinaria diversidad de formas, colores, comportamientos y estrategias de supervivencia.
Las mariposas Morpho son también un ejemplo de la interdependencia que caracteriza a los ecosistemas tropicales. Durante su fase larvaria, las orugas dependen de plantas específicas para alimentarse, mientras que los adultos participan indirectamente en procesos ecológicos como la dispersión de sustancias orgánicas y el reciclaje de nutrientes en el suelo del bosque. Así, incluso organismos aparentemente pequeños desempeñan un papel dentro del funcionamiento general del ecosistema.
La presencia de especies como la Morpho azul ilustra por qué las selvas tropicales se consideran auténticos centros de biodiversidad planetaria. Aunque ocupan una proporción relativamente pequeña de la superficie terrestre, albergan una parte muy significativa de las especies conocidas del planeta. Cada hectárea de selva puede contener cientos de especies de árboles y miles de especies de insectos, muchas de las cuales todavía no han sido descritas por la ciencia.
Sin embargo, esta riqueza biológica es también extremadamente frágil. La deforestación, la expansión agrícola y la transformación del territorio amenazan numerosos ecosistemas tropicales, poniendo en riesgo a innumerables especies que dependen de ellos para sobrevivir. La pérdida de estos hábitats no solo implica la desaparición de paisajes naturales, sino también la reducción de una diversidad biológica que constituye uno de los patrimonios más valiosos de la Tierra.
La Morpho azul, con sus alas brillantes que capturan la luz del bosque tropical, se ha convertido así en un símbolo de esa extraordinaria diversidad biológica. Representa la creatividad de la evolución y la complejidad de los ecosistemas tropicales, recordándonos que la naturaleza alberga una riqueza de formas de vida cuyo valor científico, ecológico y estético es difícil de exagerar.
Tucán de la selva tropical posado en la vegetación del bosque húmedo americano. Sus colores intensos y su gran pico curvado lo convierten en una de las aves más características de los ecosistemas tropicales. Los tucanes son aves emblemáticas de las selvas tropicales de América. Su presencia en el dosel del bosque refleja la extraordinaria diversidad de especies que habitan estos ecosistemas y el complejo equilibrio ecológico que sostiene la vida en ellos. — Vídeo: Hubzway. Envato Elements.
Los tucanes constituyen uno de los símbolos más reconocibles de la biodiversidad de las selvas tropicales americanas. Pertenecen a la familia Ramphastidae, un grupo de aves caracterizado por su gran pico curvado y por la intensidad de sus colores. En la actualidad se conocen más de cuarenta especies diferentes de tucanes, distribuidas en las regiones tropicales de América Central y del Sur, desde México hasta el norte de Argentina.
Su hábitat natural es el bosque tropical, donde viven principalmente en el dosel de la selva, es decir, en la capa superior formada por las copas de los árboles. Este espacio es uno de los entornos más dinámicos del ecosistema forestal, ya que en él se concentran gran parte de los frutos, flores e insectos que sirven de alimento a numerosas especies de aves, mamíferos y reptiles. Los tucanes se desplazan entre las ramas saltando y realizando vuelos cortos, buscando frutos maduros que constituyen la base de su alimentación.
El rasgo más llamativo de estas aves es sin duda su enorme pico. En algunas especies puede alcanzar casi un tercio de la longitud total del cuerpo, aunque su estructura interna es sorprendentemente ligera gracias a una compleja arquitectura ósea recubierta de queratina. Esta adaptación permite al tucán alcanzar frutos situados en ramas delgadas que no soportarían su peso, ampliando así su capacidad para aprovechar los recursos del bosque.
Más allá de su apariencia espectacular, los tucanes desempeñan un papel ecológico fundamental en el funcionamiento de la selva tropical. Se alimentan principalmente de frutas, que ingieren enteras y cuyos semillas dispersan posteriormente a través de sus excrementos, a menudo a grandes distancias del árbol original. Este proceso convierte a los tucanes en importantes agentes de regeneración del bosque, ya que contribuyen a la propagación de numerosas especies vegetales.
De este modo, los tucanes forman parte de una compleja red ecológica en la que animales y plantas dependen mutuamente para su supervivencia. Los árboles producen frutos que alimentan a las aves, mientras que estas transportan las semillas que permitirán que nuevos árboles crezcan en otras zonas del bosque. Este tipo de relaciones es característico de los ecosistemas tropicales, donde la biodiversidad no se limita al número de especies, sino también a la multiplicidad de interacciones entre ellas.
La presencia de numerosas especies de tucanes ilustra bien el fenómeno de diversificación evolutiva que se observa en las selvas tropicales. A lo largo de millones de años, diferentes especies han desarrollado variaciones en el tamaño del pico, en los colores del plumaje o en sus hábitos alimentarios, adaptándose a distintos nichos ecológicos dentro del mismo ecosistema. Así, cada especie ocupa un papel específico dentro del complejo entramado biológico del bosque.
Las selvas tropicales constituyen uno de los grandes centros de biodiversidad del planeta. Aunque ocupan una fracción relativamente pequeña de la superficie terrestre, albergan una enorme proporción de las especies conocidas de animales y plantas. En estos ambientes, la abundancia de alimento, el clima cálido y la estabilidad ambiental han favorecido procesos evolutivos que han generado una extraordinaria variedad de formas de vida.
El tucán, con su silueta inconfundible y su pico multicolor, representa de forma muy clara esa riqueza biológica. No es simplemente un ave llamativa, sino una pieza dentro del complejo engranaje ecológico que sostiene la vida en la selva tropical. Su existencia refleja la capacidad de la evolución para generar adaptaciones sorprendentes y demuestra cómo cada especie, por pequeña que sea, contribuye al equilibrio y continuidad de uno de los ecosistemas más diversos de la Tierra.
2.4. El impacto humano: la naturaleza modificada por la civilización
A lo largo de su historia, el ser humano ha transformado el entorno natural para adaptarlo a sus necesidades. Desde los primeros grupos humanos que modificaban el paisaje mediante el uso del fuego o la caza organizada, hasta las sociedades agrícolas y las grandes civilizaciones industriales, la actividad humana ha ejercido una influencia creciente sobre los ecosistemas del planeta. Hoy en día, esa influencia alcanza una escala global que no tiene precedentes en la historia de la Tierra.
La relación entre la humanidad y la naturaleza ha estado marcada por una tensión constante entre adaptación y transformación. Durante gran parte de la prehistoria, los seres humanos vivieron como cazadores y recolectores, dependiendo directamente de los recursos naturales disponibles en su entorno. Aunque incluso estas sociedades podían alterar ciertos ecosistemas mediante la caza intensiva o la utilización del fuego, el impacto global sobre el planeta era relativamente limitado debido a la baja densidad de población y a las tecnologías disponibles.
Un cambio profundo se produjo con la aparición de la agricultura, hace aproximadamente diez mil años. El desarrollo de la agricultura permitió a los seres humanos domesticar plantas y animales, establecer asentamientos permanentes y aumentar considerablemente la producción de alimentos. Sin embargo, este avance también implicó la transformación de grandes extensiones de territorio. Bosques fueron talados para crear campos de cultivo, los suelos fueron modificados mediante técnicas agrícolas y los cursos de agua comenzaron a ser gestionados mediante sistemas de riego.
Con el crecimiento de las civilizaciones y el desarrollo de ciudades, la intervención humana en los ecosistemas se intensificó. Las sociedades comenzaron a extraer recursos minerales, a construir infraestructuras y a modificar paisajes naturales a gran escala. A lo largo de los siglos, esta capacidad de transformación se vio amplificada por los avances tecnológicos y por el aumento continuo de la población humana.
La revolución industrial marcó un punto de inflexión especialmente significativo en esta relación entre humanidad y naturaleza. La utilización masiva de combustibles fósiles —como el carbón, el petróleo y el gas— permitió un enorme incremento de la producción industrial, del transporte y de la actividad económica. Este proceso impulsó un crecimiento sin precedentes de la capacidad humana para transformar el planeta, pero también introdujo nuevas formas de presión sobre los sistemas naturales.
En la actualidad, la influencia humana sobre la Tierra se manifiesta de múltiples maneras. La expansión de las ciudades, la agricultura intensiva, la explotación de recursos naturales y la construcción de infraestructuras han alterado profundamente numerosos paisajes. Muchos ecosistemas han sido fragmentados o reemplazados por entornos artificiales, lo que ha reducido el espacio disponible para muchas especies silvestres.
La contaminación constituye otro aspecto importante del impacto humano sobre la naturaleza. Las actividades industriales, el uso de productos químicos en la agricultura y la producción de residuos han introducido en el ambiente numerosas sustancias que pueden afectar a los organismos vivos. La contaminación del aire, del agua y del suelo puede alterar los ecosistemas y perjudicar la salud de muchas especies, incluida la humana.
Uno de los fenómenos más significativos asociados al desarrollo industrial es el cambio en la composición de la atmósfera. La emisión de gases procedentes de la combustión de combustibles fósiles ha aumentado la concentración de dióxido de carbono y otros gases que influyen en el clima del planeta. Estos cambios pueden alterar patrones climáticos, afectar a los ecosistemas y modificar las condiciones ambientales en numerosas regiones del mundo.
Además de estos efectos globales, la actividad humana ha introducido nuevas dinámicas en los ecosistemas. El transporte internacional de mercancías y personas ha facilitado la dispersión de especies fuera de sus áreas naturales, lo que en algunos casos ha provocado la aparición de especies invasoras capaces de alterar profundamente los ecosistemas locales. Del mismo modo, la sobreexplotación de ciertos recursos, como la pesca intensiva o la tala excesiva de bosques, puede provocar el colapso de poblaciones naturales.
A pesar de estos impactos, la relación entre civilización y naturaleza no es necesariamente una relación de destrucción inevitable. La misma capacidad tecnológica y científica que ha permitido transformar el planeta puede también contribuir a comprender mejor los sistemas naturales y a gestionar los recursos de forma más responsable. El desarrollo de energías renovables, la protección de espacios naturales o la restauración de ecosistemas degradados son ejemplos de cómo la actividad humana puede orientarse hacia modelos más sostenibles.
Comprender el impacto humano sobre la naturaleza exige reconocer que la civilización forma parte del sistema ecológico global. Los seres humanos no existen fuera de la biosfera, sino dentro de ella, y dependen de los mismos procesos ecológicos que sostienen a todas las formas de vida. La fertilidad del suelo, la disponibilidad de agua, la estabilidad del clima y la diversidad biológica son factores fundamentales para el bienestar de las sociedades humanas.
La historia de la civilización puede interpretarse en parte como la historia de nuestra relación con el entorno natural. A medida que nuestras capacidades tecnológicas han aumentado, también lo ha hecho nuestra capacidad para modificar los sistemas ecológicos del planeta. Esta situación plantea una cuestión central para el futuro de la humanidad: cómo utilizar el conocimiento científico y tecnológico de manera que permita el desarrollo de las sociedades humanas sin comprometer el equilibrio de los ecosistemas que sostienen la vida.
Reflexionar sobre el impacto humano en la naturaleza no significa rechazar el progreso o la civilización, sino comprender que toda intervención sobre el medio ambiente tiene consecuencias. La ecología moderna invita precisamente a considerar estas consecuencias dentro de un marco más amplio, donde la actividad humana se integra en el conjunto de procesos naturales que regulan el funcionamiento del planeta. En este contexto, el desafío consiste en encontrar formas de convivencia entre civilización y naturaleza que permitan mantener la riqueza biológica y la estabilidad ecológica de la Tierra.
Carretera que atraviesa un bosque tropical, ejemplo de cómo las infraestructuras humanas penetran en ecosistemas de gran valor ecológico. Las infraestructuras humanas, como carreteras o asentamientos, transforman profundamente los ecosistemas naturales. Aunque facilitan el desarrollo de las sociedades humanas, también pueden fragmentar hábitats y alterar el delicado equilibrio ecológico de regiones de gran biodiversidad. — © Kenstocker/ Envato Elements.

La imagen muestra una carretera de asfalto que se adentra en un entorno natural de gran riqueza ecológica. A primera vista puede parecer simplemente una vía de comunicación que atraviesa un paisaje exuberante, pero en realidad representa uno de los fenómenos más característicos de la relación entre la civilización humana y la naturaleza: la progresiva transformación de los ecosistemas por parte de la actividad humana.
Las carreteras constituyen uno de los elementos más visibles de la expansión de las sociedades modernas. Permiten el transporte de personas, bienes y recursos, conectan comunidades y facilitan el desarrollo económico. Sin embargo, su construcción en entornos naturales también tiene consecuencias ecológicas importantes. Cuando una vía atraviesa un bosque o una selva tropical, introduce una fractura física en el ecosistema que altera las dinámicas naturales que durante siglos o milenios habían permanecido relativamente estables.
Uno de los efectos más significativos de estas infraestructuras es la fragmentación del hábitat. Los grandes ecosistemas continuos se dividen en áreas más pequeñas separadas entre sí por carreteras, ciudades o explotaciones agrícolas. Muchas especies animales necesitan amplios territorios para alimentarse, reproducirse o desplazarse. Cuando el paisaje se fragmenta, sus poblaciones pueden quedar aisladas, lo que reduce la diversidad genética y aumenta la vulnerabilidad de las especies.
Las carreteras también facilitan la penetración humana en regiones que anteriormente eran de difícil acceso. A través de ellas se expanden actividades como la explotación forestal, la agricultura intensiva o la urbanización. En numerosos lugares del mundo, las primeras carreteras abiertas en regiones tropicales han sido el punto de partida de procesos de deforestación a gran escala que transforman radicalmente el paisaje natural.
En ecosistemas especialmente ricos en biodiversidad, como las selvas tropicales, estas transformaciones pueden tener consecuencias profundas. Estos bosques albergan una enorme variedad de especies animales y vegetales que dependen de un equilibrio ecológico muy complejo. Cada especie forma parte de una red de relaciones que incluye depredadores, presas, plantas, insectos polinizadores y microorganismos del suelo. Cuando el hábitat se altera o se reduce, muchas de estas relaciones se rompen.
Además de la fragmentación del territorio, las carreteras introducen otros factores de perturbación. El ruido, la contaminación, el aumento de la presencia humana o los atropellos de fauna afectan directamente a numerosas especies. Algunos animales evitan cruzar estas infraestructuras, mientras que otros mueren al intentar atravesarlas. Con el tiempo, estos efectos pueden modificar la composición biológica de un ecosistema.
Sin embargo, la imagen también invita a reflexionar sobre otro aspecto fundamental: la responsabilidad humana en la gestión del territorio. Las infraestructuras forman parte inevitable de la vida moderna, pero su diseño y planificación pueden realizarse de forma más respetuosa con el medio natural. En muchas regiones se están desarrollando soluciones como corredores ecológicos, pasos de fauna o sistemas de planificación territorial que buscan reducir el impacto de las carreteras sobre los ecosistemas.
La ecología contemporánea no se limita a estudiar la naturaleza en estado puro; también analiza cómo las actividades humanas interactúan con los sistemas naturales. Comprender estas relaciones es esencial para encontrar formas de desarrollo que permitan conciliar las necesidades de la civilización con la conservación de la biodiversidad.
La carretera que aparece en la imagen simboliza precisamente ese desafío. Representa la capacidad humana para transformar el paisaje, pero también recuerda la importancia de actuar con prudencia y responsabilidad. La preservación de los ecosistemas más valiosos del planeta depende en gran medida de las decisiones que las sociedades humanas adopten en relación con el uso del territorio y los recursos naturales.
2.5. Crisis climática y degradación ambiental
En las últimas décadas, el estudio de los sistemas naturales ha puesto de manifiesto una realidad cada vez más evidente: la actividad humana está alterando de forma profunda muchos de los equilibrios ecológicos del planeta. El crecimiento demográfico, la expansión industrial, el consumo masivo de recursos y la transformación del territorio han provocado cambios ambientales que afectan a los ecosistemas en múltiples niveles. Entre estos cambios, uno de los más significativos es la modificación del clima global, un fenómeno que se relaciona con procesos más amplios de degradación ambiental.
El clima de la Tierra nunca ha sido completamente estable. A lo largo de millones de años, el planeta ha experimentado periodos más cálidos y más fríos debido a factores naturales como las variaciones en la órbita terrestre, la actividad volcánica o cambios en la composición de la atmósfera. Sin embargo, las investigaciones científicas indican que el ritmo de cambio observado desde la revolución industrial es mucho más rápido que muchos de los cambios naturales registrados en el pasado reciente.
Uno de los factores más importantes que influyen en el clima es la composición de la atmósfera. La atmósfera terrestre contiene ciertos gases —como el dióxido de carbono, el metano o el vapor de agua— que tienen la capacidad de retener parte del calor procedente de la radiación solar. Este fenómeno, conocido como efecto invernadero, es esencial para mantener temperaturas adecuadas para la vida en el planeta. Sin él, la superficie terrestre sería mucho más fría y la vida tal como la conocemos difícilmente podría existir.
El problema surge cuando la concentración de estos gases aumenta de forma significativa. Desde el inicio de la era industrial, la quema de combustibles fósiles —como carbón, petróleo y gas natural— ha liberado grandes cantidades de dióxido de carbono a la atmósfera. A ello se suman otros procesos, como la deforestación o ciertas prácticas agrícolas, que también contribuyen a modificar la composición atmosférica. Como resultado, una mayor cantidad de calor queda retenida en el sistema climático.
El aumento de la temperatura media global puede tener múltiples consecuencias sobre los ecosistemas y sobre las sociedades humanas. Los patrones climáticos pueden alterarse, modificando la distribución de lluvias, la frecuencia de fenómenos extremos o la duración de las estaciones. Los glaciares y las capas de hielo en regiones polares muestran signos de retroceso, y el nivel del mar puede aumentar gradualmente debido a la expansión térmica del agua y al deshielo de grandes masas de hielo.
Estos cambios climáticos no actúan de forma aislada. Se combinan con otros procesos de degradación ambiental que afectan a numerosos ecosistemas del planeta. La deforestación, por ejemplo, no solo reduce la biodiversidad de los bosques, sino que también altera los ciclos del carbono y del agua. Los suelos degradados por la agricultura intensiva pueden perder fertilidad y volverse más vulnerables a la erosión. La contaminación de ríos y océanos afecta a comunidades biológicas enteras, alterando las cadenas alimentarias.
Los océanos, que desempeñan un papel fundamental en la regulación del clima global, también están experimentando cambios importantes. El aumento de la temperatura del agua y la absorción de dióxido de carbono pueden alterar la química marina, afectando a organismos sensibles como los corales o ciertos tipos de plancton. Dado que muchas especies marinas dependen de estos organismos, los efectos pueden extenderse a lo largo de toda la red ecológica.
La degradación ambiental también se manifiesta en la pérdida de hábitats naturales. A medida que los ecosistemas se fragmentan o desaparecen, muchas especies encuentran cada vez más difícil sobrevivir. Algunas pueden desplazarse hacia nuevas regiones en busca de condiciones más favorables, pero otras no logran adaptarse con suficiente rapidez a los cambios del entorno.
El estudio científico de estos fenómenos ha dado lugar a un amplio debate sobre el alcance y las consecuencias de la crisis climática y ambiental. Numerosos investigadores coinciden en que la actividad humana se ha convertido en una de las fuerzas más influyentes en la transformación del planeta. Esta situación ha llevado incluso a proponer que vivimos en una nueva etapa geológica caracterizada por el impacto humano sobre la Tierra.
Sin embargo, la comprensión de estos problemas también ha permitido desarrollar nuevas formas de abordarlos. La investigación científica ha impulsado el desarrollo de tecnologías energéticas más limpias, métodos de gestión sostenible de los recursos y estrategias de conservación de ecosistemas. Cada vez existe una mayor conciencia de que el bienestar humano está profundamente ligado a la estabilidad de los sistemas naturales.
La crisis climática y la degradación ambiental no son únicamente problemas científicos o tecnológicos; también implican decisiones sociales, económicas y culturales. El modo en que las sociedades producen energía, gestionan los recursos naturales o organizan su desarrollo influye directamente en el estado del planeta. Comprender estas interacciones es fundamental para diseñar estrategias que permitan reducir los impactos negativos sobre los ecosistemas.
Desde la perspectiva ecológica, el desafío consiste en encontrar formas de desarrollo que respeten los límites de los sistemas naturales. La Tierra funciona como un sistema complejo donde el equilibrio depende de múltiples procesos interconectados. Alterar profundamente alguno de estos procesos puede generar consecuencias difíciles de prever.
Por esta razón, el estudio de la crisis climática y de la degradación ambiental invita a reflexionar sobre la relación entre la humanidad y el planeta que habita. Comprender los mecanismos que regulan el clima y los ecosistemas no solo amplía nuestro conocimiento científico, sino que también nos recuerda que la estabilidad de la civilización humana depende en gran medida de la estabilidad del mundo natural que la sostiene.
2.6. La ecología como ciencia moral indirecta: responsabilidad y futuro
La ecología es, ante todo, una ciencia natural. Su objetivo principal consiste en comprender cómo funcionan los ecosistemas, cómo interactúan los organismos entre sí y de qué manera circulan la energía y la materia dentro de los sistemas naturales. Sin embargo, a medida que el conocimiento ecológico ha avanzado, se ha hecho cada vez más evidente que sus conclusiones tienen implicaciones que van más allá del ámbito puramente científico. Comprender cómo funciona la naturaleza conduce inevitablemente a reflexionar sobre el modo en que los seres humanos interactúan con ella. En este sentido, la ecología puede considerarse también una ciencia con una dimensión moral indirecta.
La ciencia, en sí misma, no dicta normas morales. Su función es describir y explicar fenómenos naturales mediante la observación, la experimentación y el análisis racional. Sin embargo, el conocimiento que proporciona puede influir profundamente en la forma en que las sociedades toman decisiones. La ecología revela que los sistemas naturales poseen equilibrios complejos y que muchas formas de vida dependen de relaciones delicadas entre organismos y entorno. Cuando estos equilibrios se alteran, las consecuencias pueden afectar a múltiples especies y a los propios sistemas que sostienen la vida.
Este conocimiento introduce inevitablemente una dimensión de responsabilidad. Si las actividades humanas tienen la capacidad de modificar los ecosistemas y de alterar procesos fundamentales de la biosfera, entonces las decisiones humanas adquieren una importancia que trasciende el interés inmediato de una generación o de una comunidad concreta. Las acciones humanas pueden influir en la estabilidad de los sistemas naturales que sostienen la vida en el planeta.
La ecología muestra, por ejemplo, que la destrucción de un hábitat natural no solo afecta a una especie concreta, sino a toda la red de relaciones que se desarrolla en ese ecosistema. La desaparición de una especie puede provocar cambios en las poblaciones de otras, alterar las cadenas alimentarias y modificar procesos ecológicos como la polinización o el reciclaje de nutrientes. De esta manera, las intervenciones humanas en la naturaleza pueden generar efectos en cascada que se extienden mucho más allá de lo que inicialmente se preveía.
Desde esta perspectiva, el conocimiento ecológico invita a considerar la relación entre humanidad y naturaleza dentro de un marco más amplio. La civilización humana depende de los mismos sistemas ecológicos que sostienen la vida de otras especies. La fertilidad de los suelos, la disponibilidad de agua dulce, la estabilidad del clima o la diversidad biológica son factores que influyen directamente en el bienestar de las sociedades humanas.
La ecología moderna ha contribuido a reforzar la idea de que los seres humanos forman parte de la biosfera y no pueden situarse completamente al margen de ella. Durante mucho tiempo, la cultura humana tendió a concebir la naturaleza principalmente como un conjunto de recursos disponibles para la explotación. Sin embargo, el estudio científico de los ecosistemas muestra que estos sistemas tienen límites y que su alteración puede afectar al equilibrio general del planeta.
Esto no significa que la relación entre humanidad y naturaleza deba interpretarse únicamente en términos de restricción o de conflicto. La historia de la civilización demuestra que los seres humanos poseen una extraordinaria capacidad para comprender los procesos naturales y para desarrollar tecnologías que mejoren sus condiciones de vida. La cuestión central no es si la humanidad debe intervenir en la naturaleza —algo inevitable desde el momento en que existen sociedades humanas—, sino cómo hacerlo de manera que se mantenga la estabilidad de los sistemas ecológicos.
En este contexto, la ecología puede entenderse como una fuente de orientación racional para la toma de decisiones colectivas. No impone valores por sí misma, pero proporciona información fundamental sobre las consecuencias de determinadas acciones. Conocer cómo funcionan los ecosistemas permite evaluar mejor los efectos de la deforestación, de la contaminación, de la explotación de recursos o de las políticas de conservación.
Este conocimiento adquiere una importancia particular cuando se considera el futuro a largo plazo. Muchas decisiones que afectan al medio ambiente tienen consecuencias que se manifiestan a lo largo de décadas o incluso de siglos. La degradación de un ecosistema puede ser difícil de revertir, y algunas pérdidas, como la extinción de especies, son irreversibles. Por ello, la reflexión ecológica invita a adoptar una perspectiva temporal más amplia que tenga en cuenta las generaciones futuras.
La idea de responsabilidad ambiental surge precisamente de esta comprensión del carácter interdependiente de los sistemas naturales. Las sociedades humanas tienen la capacidad de modificar profundamente su entorno, pero también poseen la capacidad de aprender de la ciencia y de ajustar sus comportamientos en función de ese conocimiento. La educación, la investigación científica y la cooperación internacional desempeñan un papel fundamental en este proceso.
En última instancia, la ecología pone de relieve una verdad sencilla pero profunda: la vida en la Tierra constituye una red de relaciones en la que cada organismo depende de muchos otros y del entorno que lo rodea. Los seres humanos no son una excepción dentro de esta red. Nuestro bienestar y nuestro desarrollo dependen de la estabilidad de los sistemas naturales que sostienen la biosfera.
Por ello, aunque la ecología sea una ciencia natural, sus conclusiones invitan a reflexionar sobre el modo en que la humanidad desea relacionarse con el mundo natural. Comprender la naturaleza no solo amplía nuestro conocimiento científico, sino que también abre la posibilidad de orientar nuestras acciones hacia un futuro en el que el desarrollo humano pueda coexistir con la conservación de los sistemas ecológicos que hacen posible la vida en el planeta.
2.7. Naturaleza y civilización: convivencia o destrucción
La relación entre la naturaleza y la civilización humana constituye uno de los grandes temas de la historia. Desde los primeros asentamientos agrícolas hasta las complejas sociedades tecnológicas actuales, los seres humanos han dependido siempre del mundo natural para obtener alimento, agua, energía y materias primas. Sin embargo, al mismo tiempo que dependemos de la naturaleza, también poseemos la capacidad de transformarla profundamente. Esta doble condición —dependencia y transformación— ha marcado la evolución de las sociedades humanas y plantea una cuestión fundamental: ¿es posible una convivencia equilibrada entre civilización y naturaleza, o la expansión de la actividad humana conduce inevitablemente a la degradación del medio natural?
A lo largo de la historia, la civilización ha surgido en estrecha relación con determinados entornos naturales. Las primeras grandes culturas agrícolas se desarrollaron en regiones fértiles donde la disponibilidad de agua y suelos productivos permitía cultivar alimentos de forma estable. Los valles de grandes ríos como el Nilo, el Tigris y el Éufrates, el Indo o el Huang He proporcionaron las condiciones necesarias para el nacimiento de algunas de las primeras civilizaciones conocidas. En estos contextos, la naturaleza no era simplemente un recurso, sino el fundamento mismo sobre el que se sostenía la vida social.
Con el tiempo, las sociedades humanas aprendieron a modificar su entorno de manera cada vez más intensa. La agricultura permitió transformar paisajes enteros en campos de cultivo; la construcción de ciudades reorganizó el territorio; las infraestructuras de transporte conectaron regiones distantes. A medida que aumentaba la capacidad tecnológica, también lo hacía la capacidad de intervenir en los sistemas naturales.
Durante siglos, estas transformaciones se mantuvieron dentro de límites relativamente regionales. Sin embargo, el desarrollo industrial y el crecimiento de la población humana ampliaron enormemente la escala de la intervención humana sobre la naturaleza. Hoy en día, la civilización moderna posee una capacidad de transformación planetaria: se modifican ecosistemas, se extraen recursos a gran escala y se alteran procesos naturales que afectan al conjunto del planeta.
Esta situación ha dado lugar a un debate profundo sobre el futuro de la relación entre humanidad y naturaleza. Por un lado, la civilización ha permitido avances extraordinarios en conocimiento, tecnología, salud y bienestar material. La capacidad humana para comprender los procesos naturales ha abierto posibilidades que antes eran inimaginables. La ciencia y la tecnología han permitido aumentar la producción de alimentos, desarrollar sistemas de comunicación globales y mejorar la calidad de vida de millones de personas.
Por otro lado, estos avances también han tenido efectos secundarios sobre los sistemas naturales. La expansión de la actividad humana ha reducido numerosos hábitats naturales, ha alterado los ciclos ecológicos y ha generado presiones sobre muchas especies y ecosistemas. En algunos casos, los cambios introducidos por la civilización superan la capacidad de recuperación de los sistemas naturales.
Frente a esta situación, algunos enfoques han planteado la relación entre humanidad y naturaleza como un conflicto inevitable, en el que el desarrollo humano implica necesariamente la degradación del entorno natural. Sin embargo, esta visión simplifica en exceso la complejidad del problema. La civilización humana no es necesariamente incompatible con la naturaleza, pero sí requiere una comprensión profunda de los límites ecológicos dentro de los cuales puede desarrollarse de forma sostenible.
La clave de esta relación reside en el conocimiento. La ciencia moderna ha permitido comprender con mayor claridad cómo funcionan los ecosistemas y cuáles son los procesos que sostienen la estabilidad de la biosfera. Este conocimiento ofrece la posibilidad de gestionar los recursos naturales de manera más responsable, evitando prácticas que provoquen daños irreversibles en los sistemas ecológicos.
El desarrollo de energías renovables, la protección de áreas naturales, la restauración de ecosistemas degradados o la gestión sostenible de recursos como el agua y los suelos son ejemplos de estrategias que buscan reconciliar el desarrollo humano con la conservación del entorno natural. Estas iniciativas reflejan un cambio gradual en la forma de entender la relación entre civilización y naturaleza.
Al mismo tiempo, esta relación plantea una dimensión cultural y ética más amplia. La forma en que las sociedades perciben la naturaleza influye en las decisiones que toman respecto a ella. Durante mucho tiempo, la naturaleza fue considerada principalmente como una fuente de recursos disponibles para el progreso humano. Hoy en día, cada vez más personas reconocen que los ecosistemas poseen un valor que va más allá de su utilidad inmediata.
La cuestión fundamental no es si la humanidad debe abandonar la civilización para preservar la naturaleza —algo imposible y contrario a la propia historia humana—, sino cómo orientar el desarrollo humano de forma que respete los procesos ecológicos fundamentales. Esto implica reconocer que el bienestar de las sociedades humanas depende en última instancia de la estabilidad de los sistemas naturales que sostienen la vida.
La civilización humana posee una capacidad singular: no solo puede transformar el mundo natural, sino también comprenderlo y reflexionar sobre las consecuencias de sus acciones. Esta capacidad abre la posibilidad de construir una relación más equilibrada con la naturaleza, basada en el conocimiento científico, la responsabilidad colectiva y una visión a largo plazo.
En última instancia, la relación entre naturaleza y civilización no está predeterminada. No existe una respuesta inevitable que conduzca necesariamente a la destrucción o a la armonía. El futuro dependerá en gran medida de las decisiones que las sociedades humanas adopten en relación con el uso de los recursos, la organización de sus sistemas productivos y la manera en que integren el conocimiento ecológico en su desarrollo.
Comprender la naturaleza como un sistema complejo y reconocer la posición del ser humano dentro de ese sistema constituye un paso esencial para orientar estas decisiones. La civilización puede convertirse en una fuerza de degradación si ignora los límites ecológicos, pero también puede ser una herramienta poderosa para proteger y restaurar los sistemas naturales si se guía por el conocimiento y la responsabilidad.
De este modo, la cuestión planteada por la relación entre naturaleza y civilización no es únicamente científica, sino también cultural y filosófica. Se trata, en última instancia, de decidir qué tipo de relación desea establecer la humanidad con el mundo vivo del que forma parte.
3. Botánica: el mundo vegetal como arquitectura viva.
3.1. Qué estudia la botánica y por qué es esencial.
3.2. Las plantas como base de la vida terrestre.
3.3. Fotosíntesis: capturar luz para crear materia.
3.4. Anatomía vegetal: raíces, tallos, hojas y flores.
3.5. Reproducción vegetal: semillas, polinización y ciclos.
3.6. Adaptaciones: cómo las plantas sobreviven en ambientes extremos.
3.7. Plantas y ecosistemas: bosques, praderas y selvas.
3.8. Agricultura y domesticación: plantas al servicio de la humanidad.
3.9. Plantas medicinales y química vegetal.
3.10. El futuro de la botánica: biodiversidad, deforestación y cambio climático.

Collage botánico: estructura vegetal, ecosistemas, investigación científica, polinización y germinación — cinco dimensiones del mundo vegetal que sostienen la vida en la Tierra.
El mundo vegetal constituye uno de los pilares fundamentales de la biosfera. Las plantas capturan la energía del Sol mediante la fotosíntesis, producen oxígeno, generan materia orgánica y sostienen la base de casi todas las cadenas alimentarias. Al mismo tiempo, forman los grandes paisajes de la Tierra —bosques, selvas, praderas o cultivos— y mantienen complejas relaciones con animales, microorganismos y seres humanos. La botánica estudia esta extraordinaria diversidad de formas y funciones, desde la estructura microscópica de las células vegetales hasta el papel de las plantas en los ecosistemas y en la vida de las sociedades humanas.
3. Botánica: el mundo vegetal como arquitectura viva.
Cuando pensamos en la vida sobre la Tierra, nuestra imaginación suele dirigirse con rapidez hacia los animales: criaturas que se mueven, cazan, sienten o interactúan de forma visible con su entorno. Sin embargo, la base silenciosa sobre la que se sostiene casi toda la biosfera es el mundo vegetal. Las plantas constituyen la gran infraestructura biológica del planeta, una inmensa arquitectura viva que organiza la energía solar, transforma la materia y construye los paisajes que hacen posible la vida tal como la conocemos.
La botánica es la rama de la biología que estudia este universo vegetal. Su campo abarca desde las microscópicas algas unicelulares hasta los gigantescos árboles de los bosques tropicales, desde los musgos que cubren las rocas húmedas hasta las complejas plantas con flores que dominan la mayoría de los ecosistemas terrestres. A primera vista, las plantas pueden parecer organismos simples o pasivos, pero una observación más atenta revela un mundo de extraordinaria sofisticación: tejidos especializados, sistemas de transporte de agua y nutrientes, mecanismos químicos de defensa, complejas estrategias reproductivas y una enorme diversidad de adaptaciones evolutivas.
La importancia de las plantas en el equilibrio del planeta es difícil de exagerar. Son los organismos que capturan la energía del Sol y la transforman en materia orgánica mediante el proceso de la fotosíntesis. En ese proceso se produce oxígeno, se fija carbono atmosférico y se genera la base energética que alimenta a casi todos los demás seres vivos. En términos ecológicos, las plantas actúan como productores primarios: el primer eslabón de la gran red de la vida. Sin su actividad constante, los ecosistemas terrestres y la mayoría de los acuáticos colapsarían rápidamente.
Pero el papel de las plantas no se limita a la producción de alimento y oxígeno. Las grandes formaciones vegetales —bosques, selvas, praderas, sabanas o manglares— crean los escenarios físicos donde se desarrolla la vida animal. Regulan el clima local y global, protegen los suelos frente a la erosión, influyen en los ciclos del agua y del carbono y proporcionan refugio y recursos a innumerables especies. En cierto sentido, las plantas no solo habitan los ecosistemas: los construyen.
Desde el punto de vista científico, la botánica también ha desempeñado un papel fundamental en la historia del conocimiento biológico. Muchos de los descubrimientos clave de la biología se realizaron estudiando organismos vegetales. El análisis de la estructura celular, la comprensión de los tejidos vivos, la investigación sobre la herencia genética o el estudio del crecimiento y el desarrollo encontraron en las plantas un campo de observación privilegiado. Las plantas, al ser organismos relativamente accesibles y manipulables en laboratorio, permitieron explorar con claridad los principios fundamentales de la vida.
Además, el mundo vegetal ha estado siempre estrechamente ligado a la historia de la civilización humana. Desde los primeros grupos agrícolas del Neolítico hasta las sociedades contemporáneas, las plantas han proporcionado alimento, fibras, combustibles, materiales de construcción y sustancias medicinales. La agricultura, una de las revoluciones más importantes de la historia humana, se basa precisamente en la domesticación y el manejo de especies vegetales. Gracias a ella surgieron las primeras ciudades, las grandes civilizaciones y los sistemas económicos complejos.
Incluso hoy, en una época dominada por la tecnología, la dependencia humana de las plantas sigue siendo absoluta. Nuestros alimentos proceden directa o indirectamente de ellas, gran parte de los medicamentos modernos tienen origen vegetal o se inspiran en compuestos presentes en las plantas, y muchos de los materiales industriales derivan de productos vegetales o de procesos biológicos relacionados con ellos. El mundo vegetal sigue siendo una fuente inagotable de recursos y de inspiración científica.
Sin embargo, el estudio de las plantas no se limita a su utilidad para los seres humanos. La botánica también revela una dimensión estética y estructural profundamente fascinante. Las plantas presentan una extraordinaria diversidad de formas, patrones y estrategias de crecimiento que recuerdan a auténticas obras de ingeniería natural. Las ramificaciones de los árboles, la geometría de las hojas, la simetría de las flores o la organización de las raíces en el suelo muestran cómo la vida vegetal ha desarrollado soluciones eficaces y elegantes a los desafíos del entorno.
Esta complejidad estructural es precisamente lo que permite hablar del mundo vegetal como una auténtica “arquitectura viva”. Cada planta es un sistema organizado que integra captación de luz, transporte de agua, intercambio de gases, crecimiento y reproducción en una estructura coherente. Los tejidos vegetales se organizan en redes que distribuyen nutrientes y señales químicas, mientras que la forma externa de la planta responde a las condiciones del ambiente: la luz disponible, el viento, la disponibilidad de agua o la presión de herbívoros.
La evolución ha producido a lo largo de cientos de millones de años una asombrosa variedad de soluciones biológicas. Algunas plantas se especializaron en ambientes húmedos y sombríos; otras desarrollaron adaptaciones para sobrevivir en desiertos abrasadores o en regiones polares. Algunas viven apenas unas semanas, mientras que otras pueden sobrevivir durante siglos o incluso milenios. Todas ellas, sin embargo, comparten la misma función fundamental: captar energía solar y transformarla en vida.
En la actualidad, el estudio de la botánica adquiere además una importancia creciente en el contexto de los grandes desafíos ambientales del siglo XXI. La deforestación, la pérdida de biodiversidad, el cambio climático y la degradación de los suelos amenazan muchos de los sistemas vegetales que sostienen el equilibrio del planeta. Comprender cómo funcionan las plantas, cómo se adaptan y cómo interactúan con su entorno se ha convertido en una tarea científica y social de primer orden.
Este capítulo explora el mundo vegetal desde diversas perspectivas: su papel fundamental en la biosfera, los procesos biológicos que permiten a las plantas transformar la energía del Sol en vida, su anatomía y sus estrategias reproductivas, sus sorprendentes adaptaciones a ambientes extremos y su relación profunda con los ecosistemas y con la historia humana. Al recorrer estos aspectos descubrimos que las plantas no son simplemente un fondo verde del paisaje, sino uno de los sistemas más complejos, antiguos y esenciales de la vida en la Tierra.
Comprender la botánica, en definitiva, significa comprender la base estructural de la biosfera. Significa reconocer que bajo nuestros pies, en cada bosque, en cada campo cultivado y en cada jardín urbano, se despliega una red silenciosa de organismos que sostiene el equilibrio del planeta y hace posible nuestra propia existencia.
Diversidad de plantas y órganos vegetales — tomates, zanahorias, frutos, flores y diferentes especies botánicas. Collage que muestra distintos ejemplos del mundo vegetal: frutos, raíces comestibles, flores, hojas y diversas especies de plantas. La botánica estudia esta enorme diversidad de organismos que constituyen la base de los ecosistemas terrestres y de la vida en el planeta. El mundo vegetal presenta una extraordinaria diversidad de formas, estructuras y estrategias de vida. Desde las diminutas algas microscópicas hasta los gigantescos árboles de los bosques tropicales, las plantas constituyen uno de los pilares fundamentales de la biosfera. La botánica, la ciencia que estudia las plantas, analiza su estructura, su funcionamiento y su evolución, así como el papel esencial que desempeñan en los ecosistemas. Sin las plantas, la vida terrestre tal como la conocemos no podría existir. — Fuente: Wikipedia / Wikimedia Commons. Usuario: Gecko. CC BY-SA 4.0.

El mundo vegetal constituye una de las manifestaciones más extraordinarias de la vida en la Tierra. Las plantas presentan una diversidad inmensa de formas, tamaños, colores y estrategias de supervivencia. Algunas viven flotando en el agua, otras se adaptan a los desiertos más áridos, mientras que muchas forman bosques densos que cubren vastas regiones del planeta. Esta diversidad no es únicamente estética: cada planta desempeña una función dentro de los ecosistemas y participa en complejas redes de interacción con otros organismos.
La botánica es la disciplina científica que estudia esta diversidad vegetal. Su campo de investigación abarca desde la anatomía de las plantas y sus procesos fisiológicos hasta su evolución, su clasificación y su relación con el medio ambiente. Los botánicos analizan cómo las plantas capturan la energía solar mediante la fotosíntesis, cómo transportan agua y nutrientes a través de sus tejidos y cómo se reproducen y se dispersan por el territorio.
Las plantas desempeñan además un papel fundamental en la historia de la vida. Son los principales productores de oxígeno en la atmósfera y constituyen la base de la mayoría de las cadenas alimentarias terrestres. A través de la fotosíntesis transforman la energía solar en materia orgánica, permitiendo que otros organismos —desde insectos hasta grandes mamíferos— puedan existir.
La diversidad vegetal también ha tenido una enorme importancia para las sociedades humanas. Desde los primeros tiempos de la agricultura, el ser humano ha dependido de las plantas para alimentarse, fabricar materiales, obtener medicinas y construir su entorno. Cereales, frutas, verduras, fibras textiles, maderas o plantas medicinales forman parte de la base material de la civilización.
En la actualidad, el estudio de la botánica adquiere una relevancia aún mayor. La pérdida de biodiversidad, la deforestación y el cambio climático amenazan numerosos ecosistemas vegetales. Comprender cómo funcionan las plantas y cómo interactúan con su entorno resulta esencial para conservar la riqueza biológica del planeta y garantizar un futuro sostenible.
3.1. Qué estudia la botánica y por qué es esencial
La botánica es la rama de la biología dedicada al estudio de las plantas, uno de los grandes grupos de organismos que componen la biosfera. Su campo abarca una enorme diversidad de formas de vida vegetal: desde las diminutas algas microscópicas que habitan en los océanos y lagos hasta los árboles gigantes que dominan los bosques tropicales, pasando por musgos, helechos, coníferas y plantas con flores. En términos científicos, la botánica investiga la estructura, el funcionamiento, la reproducción, la evolución y la distribución de los organismos vegetales, así como su relación con el entorno y con otros seres vivos.
A primera vista, las plantas pueden parecer organismos simples o incluso pasivos si se comparan con los animales. No se desplazan, no cazan y no muestran comportamientos visibles en el sentido habitual. Sin embargo, esta apariencia engaña. Las plantas constituyen sistemas biológicos extraordinariamente complejos, dotados de tejidos especializados, mecanismos de regulación interna y sofisticadas estrategias de adaptación al medio. Su forma de vida, aunque silenciosa y aparentemente inmóvil, está llena de procesos dinámicos que permiten captar energía, transformar sustancias químicas, crecer, reproducirse y responder a cambios ambientales.
La botánica, por tanto, no se limita a describir plantas o clasificarlas. Estudia cómo funcionan los organismos vegetales y cómo han llegado a ser lo que son a través de millones de años de evolución. Investiga cómo las raíces absorben agua y nutrientes del suelo, cómo los tallos transportan sustancias a lo largo de la planta, cómo las hojas capturan la luz solar para producir energía y cómo las flores desarrollan mecanismos complejos para atraer polinizadores y asegurar la reproducción de la especie.
Uno de los aspectos más fascinantes del mundo vegetal es su extraordinaria diversidad. Se estima que existen cientos de miles de especies de plantas en el planeta, cada una adaptada a condiciones ambientales concretas. Algunas prosperan en selvas húmedas y cálidas, donde la competencia por la luz es intensa; otras sobreviven en desiertos casi sin agua; algunas habitan en ambientes alpinos donde las temperaturas son extremas. Esta diversidad refleja una larga historia evolutiva en la que las plantas han desarrollado soluciones biológicas muy variadas para enfrentarse a los desafíos del entorno.
Pero más allá de su interés científico, el estudio de las plantas resulta esencial porque el mundo vegetal constituye el fundamento ecológico de la vida terrestre. Las plantas son los principales productores de materia orgánica en los ecosistemas. Mediante la fotosíntesis capturan la energía del Sol y la transforman en compuestos químicos que sirven de alimento para otros organismos. En ese proceso liberan oxígeno a la atmósfera, un gas indispensable para la respiración de la mayoría de los seres vivos.
En este sentido, las plantas ocupan el primer nivel de las cadenas alimentarias. Los animales herbívoros se alimentan directamente de ellas, mientras que los carnívoros dependen indirectamente de la energía que las plantas han capturado previamente. De este modo, el mundo vegetal sostiene la base energética de casi todos los ecosistemas del planeta.
Además, las plantas desempeñan un papel fundamental en el funcionamiento global de la Tierra. Regulan el ciclo del carbono al fijar dióxido de carbono de la atmósfera, influyen en el clima al controlar la evaporación de agua desde el suelo y la vegetación, protegen los suelos frente a la erosión y crean hábitats que permiten la existencia de innumerables especies animales y microbianas.
La importancia de las plantas también se refleja en la historia de la humanidad. Desde los primeros momentos de la civilización, los seres humanos han dependido de ellas para alimentarse, vestirse y construir refugios. La agricultura, basada en la domesticación de especies vegetales, permitió el surgimiento de las primeras sociedades sedentarias y el desarrollo de las grandes culturas históricas. Cereales, frutas, legumbres y numerosas plantas cultivadas continúan siendo la base de la alimentación humana en todo el mundo.
Más allá de la alimentación, muchas plantas poseen compuestos químicos con propiedades medicinales. A lo largo de la historia, diferentes culturas han utilizado extractos vegetales para tratar enfermedades y aliviar dolencias. Incluso en la medicina moderna, numerosos medicamentos derivan de sustancias originalmente descubiertas en plantas o inspiradas en sus compuestos naturales.
Por todo ello, la botánica no es una disciplina marginal dentro de las ciencias naturales. Es una ciencia central para comprender el funcionamiento de la biosfera y para abordar muchos de los grandes desafíos contemporáneos. La conservación de los bosques, la protección de la biodiversidad, la seguridad alimentaria o la búsqueda de nuevas fuentes de energía y materiales dependen en gran medida del conocimiento profundo del mundo vegetal.
En las últimas décadas, además, la botánica ha experimentado una profunda renovación gracias al desarrollo de nuevas herramientas científicas. La biología molecular, la genética y la ecología moderna han permitido estudiar las plantas con una precisión que antes era imposible. Hoy sabemos que las plantas utilizan complejas redes de señales químicas para coordinar su crecimiento, responder a ataques de herbívoros o adaptarse a cambios ambientales.
De este modo, el estudio de las plantas revela un universo biológico mucho más dinámico e inteligente de lo que durante mucho tiempo se creyó. Lejos de ser simples organismos estáticos, las plantas son sistemas vivos altamente organizados que interactúan constantemente con su entorno.
Comprender qué estudia la botánica y por qué es esencial significa, en última instancia, reconocer el papel fundamental que desempeñan las plantas en la historia de la vida y en el equilibrio de la Tierra. Son los grandes arquitectos verdes del planeta, los organismos que construyen y sostienen la base ecológica sobre la que descansa toda la biosfera.
Diversidad del mundo vegetal: organismos microscópicos, flores, frutos, plantas carnívoras y árboles muestran la extraordinaria variedad de formas que estudia la botánica. Ejemplos de la diversidad del mundo vegetal: desde organismos microscópicos y plantas especializadas como las carnívoras hasta flores, frutos y árboles completos. La botánica estudia esta enorme variedad de formas, estructuras y estrategias de vida que caracterizan a las plantas. El reino vegetal presenta una enorme diversidad de formas y estrategias de vida. Algunas plantas son microscópicas y viven en el agua; otras desarrollan flores complejas que atraen a los polinizadores; algunas producen frutos para dispersar sus semillas, mientras que otras se adaptan a ambientes extremos o incluso capturan insectos para complementar su nutrición. Esta diversidad refleja millones de años de evolución y adaptación al medio. — Fuente: Wikimedia Commons. Usuarios: Rkitko/Abraham – CC BY-SA 4.0.

El mundo vegetal se caracteriza por una extraordinaria diversidad de formas, tamaños y modos de vida. Algunas plantas son microscópicas y apenas visibles a simple vista, mientras que otras pueden alcanzar grandes dimensiones y formar bosques enteros que dominan el paisaje. Entre estos extremos se encuentran miles de especies con características muy diferentes: plantas con flores vistosas que atraen insectos, especies que producen frutos carnosos para dispersar sus semillas, plantas adaptadas a ambientes áridos o fríos, e incluso plantas carnívoras capaces de capturar pequeños organismos.
Esta diversidad es el resultado de un largo proceso evolutivo. A lo largo de millones de años, las plantas han desarrollado múltiples estrategias para sobrevivir, reproducirse y ocupar distintos nichos ecológicos. Algunas han perfeccionado mecanismos para aprovechar la luz solar con gran eficiencia; otras han desarrollado estructuras especializadas para almacenar agua o resistir condiciones climáticas extremas.
Las plantas también desempeñan un papel fundamental en los ecosistemas terrestres. Constituyen la base de la mayoría de las cadenas alimentarias y son responsables de la producción de oxígeno y de gran parte de la materia orgánica que sustenta la vida animal. Además, su diversidad contribuye a la estabilidad de los ecosistemas y a la resiliencia frente a los cambios ambientales.
Para el ser humano, esta riqueza vegetal ha sido siempre una fuente esencial de recursos. Las plantas proporcionan alimentos, medicinas, materiales de construcción y fibras textiles. Por esta razón, el estudio de la botánica no solo tiene un interés científico, sino también una gran importancia para comprender la relación entre la naturaleza y la civilización humana.
3.2. Las plantas como base de la vida terrestre
Cuando observamos un bosque, una pradera o incluso un simple jardín, solemos percibir el paisaje vegetal como un fondo natural sobre el que se desarrolla la vida animal. Sin embargo, desde el punto de vista biológico, la relación es justamente la inversa: las plantas constituyen el verdadero fundamento sobre el que se sostiene la vida terrestre. Son los organismos que capturan la energía del Sol, transforman sustancias simples en materia orgánica y crean las condiciones ecológicas que permiten la existencia de casi todos los demás seres vivos.
La vida en la Tierra depende, en última instancia, del flujo de energía solar. Esta energía llega al planeta en forma de radiación, pero la mayoría de los organismos no pueden utilizarla directamente. Las plantas —junto con algunos microorganismos fotosintéticos— poseen la extraordinaria capacidad de capturar esa energía y convertirla en energía química mediante el proceso de la fotosíntesis. Gracias a este mecanismo, utilizan dióxido de carbono, agua y luz solar para producir azúcares y otras moléculas orgánicas que constituyen la base de su crecimiento y funcionamiento.
Este proceso tiene consecuencias profundas para todo el sistema planetario. En primer lugar, permite la producción continua de materia orgánica, es decir, de sustancias ricas en energía que pueden ser utilizadas como alimento por otros organismos. Los animales herbívoros dependen directamente de las plantas para obtener energía, mientras que los carnívoros dependen indirectamente de ellas al alimentarse de los herbívoros. De este modo, toda la red alimentaria se apoya en la actividad fotosintética del mundo vegetal.
En segundo lugar, la fotosíntesis libera oxígeno como subproducto químico. Este gas, que hoy forma aproximadamente una quinta parte de la atmósfera terrestre, es indispensable para la respiración celular de la mayoría de los organismos complejos. En los primeros tiempos de la historia del planeta, la atmósfera carecía prácticamente de oxígeno. Fue la actividad fotosintética de organismos primitivos —antecesores de las plantas actuales— la que transformó gradualmente la composición atmosférica, permitiendo la evolución de formas de vida más complejas.
Las plantas no solo producen energía y oxígeno; también desempeñan un papel fundamental en la construcción de los ecosistemas terrestres. Los grandes paisajes naturales del planeta —selvas tropicales, bosques templados, sabanas, estepas o tundras— están definidos en gran medida por la vegetación que los domina. Cada tipo de vegetación crea condiciones específicas de humedad, temperatura y disponibilidad de recursos que influyen en la distribución de animales, microorganismos y otras plantas.
Por ejemplo, un bosque no es simplemente un conjunto de árboles. Es un sistema complejo donde las plantas generan sombra, retienen humedad en el suelo, protegen el terreno de la erosión y proporcionan alimento y refugio a innumerables especies. Bajo el dosel de los árboles prosperan arbustos, musgos, hongos e insectos, mientras que aves, mamíferos y otros animales encuentran allí su hábitat. Las plantas, por tanto, no solo participan en los ecosistemas: los construyen.
Otro aspecto esencial del papel de las plantas es su influencia sobre los ciclos biogeoquímicos del planeta. Estos ciclos regulan el movimiento de elementos químicos fundamentales —como el carbono, el nitrógeno o el agua— entre la atmósfera, el suelo, los océanos y los organismos vivos. Las plantas intervienen activamente en estos procesos al absorber dióxido de carbono del aire, fijar nutrientes en el suelo y liberar agua a la atmósfera a través de la transpiración.
En particular, el ciclo del carbono depende en gran medida de la actividad vegetal. Al capturar dióxido de carbono durante la fotosíntesis, las plantas contribuyen a regular la concentración de este gas en la atmósfera. Dado que el dióxido de carbono es uno de los principales gases de efecto invernadero, la vegetación desempeña un papel crucial en el equilibrio climático del planeta.
Las raíces de las plantas también tienen una función esencial en la estabilidad de los suelos. Al penetrar en la tierra, las raíces fijan el terreno y reducen el riesgo de erosión causado por el viento o el agua. Además, favorecen la formación de suelos fértiles al descomponer rocas y facilitar la acumulación de materia orgánica. Sin la presencia de vegetación, gran parte de los paisajes terrestres se degradaría rápidamente.
Desde la perspectiva humana, el papel de las plantas como base de la vida terrestre resulta igualmente evidente. Toda la agricultura se fundamenta en la capacidad de las plantas para transformar la energía solar en alimento. Cereales, frutas, legumbres y hortalizas constituyen la base de la dieta humana en la mayoría de las culturas. Incluso la producción de carne depende indirectamente de las plantas, ya que los animales domésticos se alimentan de ellas.
Además de alimento, las plantas proporcionan materias primas fundamentales para la vida cotidiana: madera para la construcción, fibras para tejidos, aceites, resinas, combustibles y numerosos compuestos utilizados en la industria y la medicina. A lo largo de la historia, las sociedades humanas han dependido profundamente del conocimiento de las plantas y de su cultivo.
Sin embargo, esta relación también implica una responsabilidad creciente. La expansión agrícola, la deforestación y la urbanización han transformado amplias regiones del planeta, alterando los ecosistemas vegetales y reduciendo la biodiversidad. La desaparición de bosques y otros sistemas vegetales no solo afecta a las especies que viven en ellos, sino también al equilibrio climático y ecológico global.
Comprender que las plantas constituyen la base de la vida terrestre significa reconocer su papel central en el funcionamiento del planeta. Son los organismos que capturan la energía que alimenta la biosfera, que construyen los paisajes donde se desarrolla la vida y que mantienen en equilibrio muchos de los procesos fundamentales de la Tierra.
En cierto sentido, toda la vida compleja del planeta descansa sobre esta inmensa red verde que cubre continentes y océanos. Las plantas, silenciosas y aparentemente inmóviles, son en realidad uno de los motores más poderosos de la biosfera: los organismos que sostienen, día tras día, el delicado equilibrio de la vida en la Tierra.
3.3. Fotosíntesis: capturar luz para crear materia
Entre todos los procesos que hacen posible la vida en la Tierra, pocos son tan fundamentales como la fotosíntesis. Gracias a este mecanismo biológico extraordinario, las plantas —junto con algas y ciertos microorganismos— son capaces de captar la energía del Sol y transformarla en materia orgánica. En otras palabras, convierten la luz en alimento. Este proceso constituye la base energética de casi todos los ecosistemas del planeta y explica por qué el mundo vegetal ocupa una posición central en la biosfera.
La fotosíntesis se desarrolla principalmente en las hojas de las plantas, dentro de estructuras microscópicas llamadas cloroplastos. Estos orgánulos contienen un pigmento verde conocido como clorofila, cuya función es absorber la energía luminosa procedente del Sol. Cuando la luz incide sobre las hojas, la clorofila captura esa energía y desencadena una serie de reacciones químicas complejas que permiten transformar sustancias simples en moléculas orgánicas ricas en energía.
Los ingredientes básicos de este proceso son sorprendentemente simples: agua, dióxido de carbono y luz solar. El agua es absorbida por las raíces desde el suelo y transportada a través del tallo hasta las hojas. El dióxido de carbono procede del aire y entra en la planta a través de pequeños poros presentes en la superficie de las hojas, llamados estomas. Con estos elementos, y gracias a la energía de la luz, la planta fabrica azúcares que servirán como fuente de energía y como material de construcción para sus tejidos.
Durante esta transformación química se produce también un subproducto fundamental: el oxígeno. Este gas es liberado a la atmósfera y constituye uno de los pilares de la vida aeróbica en el planeta. La respiración celular de animales, plantas y numerosos microorganismos depende precisamente de la presencia de oxígeno para obtener energía a partir de los nutrientes.
Desde una perspectiva ecológica, la fotosíntesis representa el punto de partida de las cadenas alimentarias. Las plantas producen compuestos orgánicos que almacenan energía química en sus enlaces moleculares. Cuando un animal herbívoro se alimenta de una planta, aprovecha esa energía previamente capturada del Sol. A su vez, los depredadores obtienen energía al alimentarse de otros animales. En última instancia, casi toda la energía que circula por los ecosistemas procede de la actividad fotosintética.
Por esta razón, los organismos capaces de realizar fotosíntesis reciben el nombre de productores primarios. Son los únicos seres vivos capaces de generar materia orgánica directamente a partir de sustancias inorgánicas utilizando la energía solar. Todos los demás organismos —incluidos los seres humanos— dependen directa o indirectamente de esta producción inicial.
La fotosíntesis también desempeña un papel esencial en el equilibrio químico de la atmósfera terrestre. Al absorber dióxido de carbono, las plantas contribuyen a regular la concentración de este gas en el aire. Dado que el dióxido de carbono es uno de los principales gases responsables del efecto invernadero, la actividad fotosintética influye en el clima del planeta y en el balance global del carbono.
Este proceso, que hoy nos parece natural y cotidiano, fue en realidad una innovación evolutiva extraordinaria en la historia de la vida. Hace miles de millones de años, los primeros organismos fotosintéticos comenzaron a liberar oxígeno en la atmósfera primitiva. Con el paso del tiempo, este gas se acumuló hasta transformar radicalmente la química del planeta, permitiendo la aparición de organismos capaces de utilizar el oxígeno para obtener energía de forma más eficiente.
La evolución de la fotosíntesis, por tanto, no solo permitió el desarrollo de las plantas modernas, sino que cambió profundamente la historia de la Tierra. Gracias a ella surgieron las condiciones necesarias para la aparición de ecosistemas complejos y para la evolución de organismos multicelulares, incluidos los animales y los seres humanos.
Desde el punto de vista de la estructura de la planta, la fotosíntesis está estrechamente ligada a la forma y función de las hojas. Las hojas suelen ser delgadas y amplias, una forma que maximiza la superficie expuesta a la luz solar. En su interior se encuentra una red de tejidos especializados que facilitan la captación de dióxido de carbono, la distribución del agua y la producción de compuestos orgánicos.
La energía obtenida mediante la fotosíntesis no se utiliza únicamente para el crecimiento de la planta. También permite producir sustancias estructurales como la celulosa, que forma las paredes celulares, y diversos compuestos químicos que intervienen en la defensa frente a herbívoros o en la interacción con otros organismos. De este modo, la fotosíntesis alimenta toda la maquinaria biológica de la planta.
Incluso los grandes paisajes del planeta reflejan la magnitud de este proceso. Los bosques tropicales, por ejemplo, representan enormes sistemas fotosintéticos capaces de fijar cantidades gigantescas de carbono. Las praderas, los cultivos agrícolas y las extensas masas de fitoplancton en los océanos desempeñan una función similar, capturando energía solar y sosteniendo complejas redes ecológicas.
En el contexto actual de cambio climático y creciente presión sobre los ecosistemas, comprender la fotosíntesis adquiere una relevancia especial. La capacidad de las plantas para capturar carbono y producir biomasa se ha convertido en un elemento clave en las estrategias destinadas a mitigar el aumento de gases de efecto invernadero y a mantener la estabilidad del sistema climático.
La fotosíntesis, en definitiva, es uno de los procesos más extraordinarios de la naturaleza. A través de él, la energía del Sol se transforma en la materia que alimenta la vida. Gracias a esta silenciosa alquimia vegetal, la luz que llega cada día a la superficie de la Tierra se convierte en hojas, frutos, semillas y bosques, sosteniendo la inmensa red de organismos que habitan nuestro planeta.
Proceso simplificado de la fotosíntesis. Las plantas utilizan la energía de la luz solar para transformar agua y dióxido de carbono en carbohidratos, liberando oxígeno a la atmósfera como subproducto. El esquema muestra de forma simplificada cómo las plantas capturan energía solar y la transforman en materia orgánica. A través de la fotosíntesis, el dióxido de carbono del aire y el agua absorbida por las raíces se convierten en azúcares que alimentan el crecimiento de la planta, mientras que el oxígeno se libera nuevamente al ambiente. Imagen creada con ia.

Aunque en los esquemas suele representarse de manera sencilla, la fotosíntesis es en realidad una compleja cadena de reacciones químicas que ocurre dentro de los cloroplastos de las células vegetales. En términos generales, el proceso puede dividirse en dos grandes fases. La primera, dependiente de la luz, transforma la energía luminosa en energía química utilizable por la célula. La segunda, conocida como ciclo de fijación del carbono, utiliza esa energía para incorporar el dióxido de carbono atmosférico y formar compuestos orgánicos más complejos.
Este proceso no solo produce azúcares que sirven como fuente de energía para la planta, sino que también genera los materiales básicos con los que se construyen sus tejidos. A partir de los carbohidratos iniciales, las plantas pueden sintetizar celulosa, almidones, lípidos y una gran variedad de moléculas orgánicas que forman parte de su estructura y metabolismo.
La fotosíntesis también conecta el mundo vegetal con el resto de la biosfera a través de los grandes ciclos biogeoquímicos del planeta. El carbono que capturan las plantas mediante este proceso puede permanecer almacenado durante largos periodos en la biomasa vegetal, en los suelos o incluso en sedimentos geológicos. De este modo, la actividad fotosintética participa activamente en la regulación del ciclo global del carbono.
En los océanos ocurre un fenómeno similar gracias al fitoplancton, organismos microscópicos capaces de realizar fotosíntesis que flotan en las capas superficiales del agua. Aunque son invisibles a simple vista, estos organismos producen una parte muy significativa del oxígeno atmosférico y constituyen la base de las cadenas alimentarias marinas.
La fotosíntesis, por tanto, no es solo un proceso fisiológico de las plantas. Es un mecanismo planetario que conecta la energía solar con la producción de materia viva, regula la composición de la atmósfera y sostiene el funcionamiento de los ecosistemas terrestres y marinos.
3.4. Anatomía vegetal: raíces, tallos, hojas y flores
Para comprender cómo funcionan las plantas es necesario observar su estructura. Aunque el mundo vegetal presenta una enorme diversidad de formas y tamaños, la mayoría de las plantas terrestres comparten una organización básica que se repite con distintas variaciones: raíces, tallos, hojas y, en muchos casos, flores. Estos órganos forman un sistema integrado que permite a la planta captar recursos del entorno, producir energía, crecer y reproducirse.
La anatomía vegetal es, por tanto, la disciplina que estudia la estructura interna y externa de las plantas, analizando cómo se organizan sus tejidos y órganos para cumplir funciones específicas. Cada parte de la planta desempeña un papel esencial dentro del conjunto, y el éxito evolutivo del mundo vegetal se debe en gran medida a la eficacia de esta organización.
Las raíces constituyen la base de la planta y se desarrollan generalmente bajo la superficie del suelo. Su función principal es absorber agua y minerales, elementos indispensables para el crecimiento y el metabolismo vegetal. A través de finos pelos absorbentes, las raíces captan las sustancias disueltas en el suelo y las incorporan al sistema interno de la planta.
Pero las raíces cumplen también otras funciones importantes. Actúan como sistema de anclaje, fijando la planta al terreno y permitiéndole resistir el viento y otras perturbaciones. Además, en muchas especies funcionan como órganos de almacenamiento, acumulando reservas de nutrientes que podrán utilizarse en momentos de crecimiento o en épocas desfavorables. En ciertos casos, como ocurre con zanahorias o remolachas, estas reservas alcanzan un desarrollo notable.
El tallo conecta las raíces con las hojas y constituye el eje central de la planta. Su función principal es transportar las sustancias que circulan por el organismo vegetal. A través de tejidos especializados —principalmente el xilema y el floema— el tallo distribuye agua y minerales desde las raíces hasta las hojas, y transporta los azúcares producidos en las hojas hacia el resto de la planta.
Además del transporte, el tallo cumple funciones estructurales. Sostiene las hojas para que puedan recibir la máxima cantidad de luz solar y posiciona las flores y frutos de manera que favorezcan la reproducción. En muchas plantas, especialmente en árboles y arbustos, el tallo se lignifica con el tiempo y forma troncos robustos capaces de soportar grandes alturas y pesos.
Las hojas son probablemente el órgano más característico del mundo vegetal. Su estructura está especialmente adaptada para realizar la fotosíntesis, el proceso mediante el cual las plantas capturan energía solar y producen materia orgánica. Las hojas suelen ser delgadas y amplias, lo que aumenta la superficie disponible para interceptar la luz.
En su interior se encuentran los cloroplastos, donde se desarrolla la fotosíntesis. Las hojas también participan en el intercambio gaseoso con la atmósfera a través de los estomas, pequeños poros que permiten la entrada de dióxido de carbono y la salida de oxígeno y vapor de agua. Este intercambio es esencial para el funcionamiento metabólico de la planta.
La diversidad de formas de las hojas refleja las adaptaciones de las plantas a diferentes ambientes. En climas secos, por ejemplo, muchas especies presentan hojas pequeñas o transformadas en espinas para reducir la pérdida de agua. En ambientes húmedos o sombreados, en cambio, las hojas suelen ser grandes y delgadas para captar mejor la luz disponible.
Finalmente, las flores constituyen los órganos reproductivos de muchas plantas, especialmente de las llamadas angiospermas o plantas con flores, que dominan la mayoría de los ecosistemas terrestres actuales. Las flores contienen las estructuras encargadas de producir gametos y facilitar la fecundación.
Una flor típica incluye varias partes especializadas: los estambres, que producen el polen (las células reproductoras masculinas), y el pistilo o carpelo, que contiene los óvulos (las células reproductoras femeninas). Cuando el polen llega al pistilo —a menudo transportado por insectos, aves, viento u otros agentes— puede producirse la fecundación, dando lugar a semillas.
Las flores han evolucionado con una extraordinaria variedad de formas, colores y aromas. Estas características no son meramente ornamentales: cumplen la función de atraer a los polinizadores, organismos que transportan el polen entre flores y facilitan la reproducción de las plantas. Esta relación entre plantas y animales constituye uno de los ejemplos más fascinantes de cooperación evolutiva en la naturaleza.
Tras la fecundación, muchas flores se transforman en frutos que protegen y ayudan a dispersar las semillas. Gracias a este mecanismo, las plantas pueden colonizar nuevos territorios y expandir su presencia en distintos ambientes.
En conjunto, raíces, tallos, hojas y flores forman un sistema biológico altamente integrado. Las raíces captan agua y nutrientes; el tallo transporta sustancias y sostiene la planta; las hojas producen energía mediante la fotosíntesis; y las flores permiten la reproducción. Cada órgano depende del funcionamiento de los demás, y el equilibrio entre estas partes permite que la planta crezca, sobreviva y se adapte a su entorno.
La anatomía vegetal revela así una organización sorprendentemente eficiente. A través de estructuras aparentemente simples, las plantas han desarrollado soluciones biológicas capaces de sostener su vida en una gran variedad de ambientes. Esta arquitectura viva, silenciosa pero extraordinariamente eficaz, constituye uno de los pilares sobre los que se apoya la vida terrestre.
Estructura básica de una planta terrestre. El sistema radicular se desarrolla bajo el suelo, mientras que el tallo sostiene las hojas y la flor, órganos responsables de la fotosíntesis y la reproducción. Este esquema muestra de forma simplificada los principales órganos que componen la estructura de una planta: raíces, tallo, hojas y flor. Cada uno de ellos desempeña funciones específicas, pero todos forman parte de un sistema integrado que permite a la planta absorber recursos, producir energía y reproducirse.

Aunque en muchos esquemas las plantas se representan como estructuras simples, en realidad cada uno de sus órganos está formado por una compleja red de tejidos especializados. Las raíces contienen zonas de crecimiento activo que permiten explorar continuamente el suelo en busca de agua y minerales. En su superficie se desarrollan microscópicos pelos absorbentes que multiplican enormemente la superficie de contacto con el terreno.
El tallo alberga los principales sistemas de conducción de la planta. En su interior se organizan los vasos del xilema y del floema, verdaderas “autopistas biológicas” que distribuyen agua, minerales y compuestos orgánicos por todo el organismo vegetal. En las plantas leñosas, estos tejidos se refuerzan con estructuras lignificadas que forman la madera.
Las hojas constituyen también una estructura altamente sofisticada. En su interior se dispone una red de nervaduras que transporta agua y nutrientes y distribuye los productos de la fotosíntesis. La superficie foliar, además, está recubierta por una fina capa protectora llamada cutícula que regula la pérdida de agua y protege frente a factores ambientales.
Las flores, por su parte, representan una de las innovaciones evolutivas más exitosas del reino vegetal. Su estructura está diseñada para favorecer el encuentro entre polen y óvulos, y en muchas especies ha evolucionado en estrecha relación con los animales polinizadores. Colores intensos, aromas complejos y formas especializadas son el resultado de millones de años de coevolución entre plantas e insectos, aves u otros organismos.
Observada en conjunto, la planta funciona como un sistema biológico perfectamente coordinado en el que cada órgano contribuye al equilibrio general. Esta organización permite a los organismos vegetales mantenerse firmemente enraizados en un lugar y, aun así, interactuar activamente con su entorno mediante complejos procesos de captación de energía, intercambio químico y reproducción.
Dionaea muscipula (Venus atrapamoscas), una de las plantas carnívoras más conocidas del mundo, capaz de capturar pequeños insectos mediante hojas modificadas que funcionan como trampas naturales. — La Venus atrapamoscas es un ejemplo fascinante de la diversidad del mundo vegetal. Esta planta carnívora ha desarrollado un mecanismo especializado para capturar insectos y obtener nutrientes en ambientes donde el suelo es pobre en minerales. Imagen: © sergeyskleznev / Envato Elements.

La Dionaea muscipula, conocida comúnmente como Venus atrapamoscas, es una de las plantas más extraordinarias del mundo vegetal. Su fama se debe a su sorprendente capacidad para capturar insectos mediante un mecanismo natural que recuerda, en cierto modo, al comportamiento de un depredador animal. Este rasgo la ha convertido en una de las especies vegetales más estudiadas y también en un símbolo de la sorprendente diversidad de estrategias que la evolución ha desarrollado en el reino de las plantas.
A diferencia de la mayoría de las plantas, que obtienen los nutrientes necesarios para su crecimiento a través del suelo mediante sus raíces, la Venus atrapamoscas vive en ambientes donde el suelo es extremadamente pobre en elementos esenciales, especialmente nitrógeno. Su hábitat natural se encuentra en regiones húmedas y pantanosas de la costa atlántica de Estados Unidos, principalmente en Carolina del Norte y Carolina del Sur. En estos suelos ácidos y arenosos, las plantas convencionales tienen dificultades para obtener nutrientes suficientes, lo que ha favorecido la aparición de estrategias adaptativas poco comunes.
Esta especie ha resuelto este problema mediante una forma singular de nutrición complementaria: la captura de pequeños insectos y artrópodos. Sus hojas se han transformado en estructuras especializadas que funcionan como trampas. Cada hoja presenta dos lóbulos articulados con pequeños filamentos sensoriales en su interior. Cuando un insecto toca estos filamentos, se desencadena un mecanismo rápido que hace que la hoja se cierre en fracciones de segundo, atrapando a la presa entre los bordes dentados de la planta.
Una vez capturado el insecto, la planta inicia un proceso digestivo. Las glándulas situadas en el interior de la hoja liberan enzimas que descomponen los tejidos de la presa, permitiendo que la planta absorba los nutrientes resultantes. Este proceso puede durar varios días, tras los cuales la trampa vuelve a abrirse y queda preparada para capturar una nueva presa.
Este mecanismo no solo es fascinante desde el punto de vista biológico, sino que también revela la extraordinaria creatividad de la evolución. A lo largo de millones de años, las plantas han desarrollado múltiples estrategias para sobrevivir en ambientes difíciles. En el caso de la Venus atrapamoscas, la evolución ha transformado una hoja común en un sofisticado sistema de captura capaz de responder a estímulos táctiles y desencadenar movimientos rápidos.
Las plantas carnívoras, como la Dionaea muscipula, forman parte de un grupo relativamente pequeño dentro del reino vegetal, pero ilustran muy bien la diversidad funcional que existe en la naturaleza. En distintos lugares del mundo se encuentran otros tipos de plantas carnívoras, como las droseras, las nepenthes o las utricularias, cada una con mecanismos diferentes para capturar presas.
La existencia de estas especies demuestra que el mundo vegetal es mucho más dinámico y complejo de lo que a menudo se imagina. Lejos de ser organismos pasivos, muchas plantas poseen sofisticados sistemas de adaptación que les permiten responder a su entorno de maneras sorprendentes. La Venus atrapamoscas, con su mecanismo de captura casi instantáneo, representa uno de los ejemplos más llamativos de esa capacidad adaptativa.
Además de su interés científico, esta planta también despierta una gran fascinación entre el público general. Su apariencia exótica y su comportamiento aparentemente “animal” la han convertido en una especie emblemática de la botánica. Sin embargo, su rareza natural también la hace vulnerable. La destrucción de hábitats húmedos y la recolección indiscriminada han reducido algunas poblaciones naturales, lo que ha llevado a establecer medidas de protección para garantizar su conservación.
En el contexto más amplio de la biodiversidad, la Venus atrapamoscas nos recuerda que la riqueza biológica del planeta no se limita a la variedad de animales visibles, sino que incluye también una enorme diversidad de plantas con estrategias evolutivas extraordinarias. Cada una de estas especies representa una solución diferente a los desafíos del medio natural, y juntas forman parte del complejo mosaico de vida que caracteriza a los ecosistemas terrestres.
3.5. Reproducción vegetal: semillas, polinización y ciclos
La continuidad de la vida vegetal depende de la capacidad de las plantas para reproducirse y generar nuevas generaciones. Aunque a menudo pasan desapercibidos, los procesos reproductivos de las plantas constituyen uno de los sistemas biológicos más ingeniosos y variados de la naturaleza. A través de semillas, flores, esporas y múltiples estrategias de dispersión, las plantas han desarrollado mecanismos eficaces para asegurar su propagación y adaptarse a entornos cambiantes.
En términos generales, la reproducción vegetal puede producirse de dos maneras: reproducción sexual y reproducción asexual. La reproducción sexual implica la combinación de células reproductoras masculinas y femeninas, lo que genera descendientes con nuevas combinaciones genéticas. Esta diversidad genética es fundamental para la evolución y para la capacidad de las especies de adaptarse a nuevas condiciones ambientales. La reproducción asexual, en cambio, permite a la planta producir nuevos individuos genéticamente idénticos a sí misma, a menudo mediante fragmentos de tallos, raíces o brotes.
En muchas plantas terrestres, especialmente en las plantas con flores, la reproducción sexual se organiza en torno a un elemento central: la semilla. Las semillas representan uno de los grandes avances evolutivos del mundo vegetal, ya que permiten proteger al embrión de la planta y facilitar su dispersión hacia nuevos lugares donde pueda crecer.
Una semilla contiene tres componentes principales: el embrión vegetal, que dará origen a la nueva planta; un tejido nutritivo que alimentará al embrión en sus primeras fases de desarrollo; y una cubierta protectora que lo resguarda frente a condiciones adversas. Gracias a esta estructura, muchas semillas pueden permanecer en estado de latencia durante largos periodos hasta que las condiciones ambientales son favorables para la germinación.
La formación de semillas depende de un proceso previo fundamental: la polinización. Este proceso consiste en el transporte del polen —que contiene las células reproductoras masculinas— desde los estambres de una flor hasta el órgano femenino, el pistilo o carpelo. Cuando el polen llega al estigma de una flor compatible, puede iniciarse la fecundación que dará lugar a la formación de la semilla.
La polinización puede producirse de diversas formas. En algunas especies, el viento transporta el polen de una planta a otra. Este mecanismo es común en muchas gramíneas y árboles como los pinos o los robles. En otras plantas, el transporte del polen depende de animales, especialmente insectos como abejas, mariposas y escarabajos. En estos casos, las flores suelen presentar colores vistosos, aromas intensos o néctar, que actúan como atractivos para los polinizadores.
La relación entre flores y polinizadores constituye uno de los ejemplos más fascinantes de coevolución en la naturaleza. A lo largo de millones de años, muchas especies de plantas y animales han desarrollado adaptaciones complementarias. Algunas flores poseen formas que facilitan el acceso de insectos específicos, mientras que ciertos polinizadores han evolucionado estructuras corporales que les permiten extraer néctar o transportar polen de manera más eficaz.
Una vez que se produce la fecundación, el óvulo se transforma en semilla y el ovario de la flor suele desarrollarse formando un fruto. Los frutos desempeñan un papel crucial en la dispersión de las semillas, permitiendo que las nuevas plantas se establezcan lejos de la planta madre. Esta dispersión puede ocurrir mediante el viento, el agua o la acción de animales que transportan o consumen los frutos.
Las estrategias de dispersión son extraordinariamente variadas. Algunas semillas poseen estructuras ligeras o alas que les permiten viajar con el viento, como ocurre con los diente de león o los arces. Otras se adhieren al pelaje de los animales mediante pequeños ganchos. En muchos casos, los frutos carnosos atraen a aves y mamíferos que se alimentan de ellos y posteriormente dispersan las semillas a través de sus desplazamientos.
Más allá de estos mecanismos visibles, la reproducción vegetal también se organiza en ciclos biológicos complejos. Muchas plantas alternan fases distintas en su ciclo de vida, combinando procesos de crecimiento, floración, formación de semillas y periodos de reposo. Estos ciclos suelen estar sincronizados con las estaciones del año y con factores ambientales como la temperatura, la disponibilidad de agua o la duración del día.
En las regiones templadas, por ejemplo, muchas plantas florecen en primavera, cuando las condiciones climáticas favorecen la actividad de los polinizadores y el crecimiento de las nuevas plantas. Durante el verano se desarrollan los frutos y semillas, mientras que en otoño estas se dispersan y el organismo vegetal entra en una fase de reposo o reducción de actividad durante el invierno.
Estos ritmos naturales muestran cómo las plantas están profundamente conectadas con los ciclos del planeta. La reproducción vegetal no es un proceso aislado, sino parte de una dinámica ecológica más amplia que implica interacciones con el clima, los suelos, los animales y otros organismos.
En conjunto, semillas, polinización y ciclos vitales forman un sistema extraordinariamente eficaz que ha permitido a las plantas colonizar prácticamente todos los ambientes terrestres. Desde los desiertos hasta las selvas tropicales, desde las regiones árticas hasta las montañas más altas, las plantas han desarrollado estrategias reproductivas capaces de asegurar la continuidad de la vida vegetal.
Este éxito evolutivo explica por qué las plantas constituyen hoy uno de los grupos de organismos más abundantes y diversos del planeta. Gracias a sus mecanismos de reproducción, la biosfera mantiene un flujo constante de renovación y expansión que sustenta el equilibrio de los ecosistemas y garantiza la persistencia de la vida en la Tierra.
Abejas recolectando polen y néctar en el interior de una flor durante el proceso de polinización, uno de los mecanismos fundamentales de reproducción en las plantas con flores. Las abejas son algunos de los polinizadores más eficaces del mundo vegetal. Al desplazarse entre flores en busca de néctar y polen, transportan inadvertidamente los granos de polen que permiten la fecundación y la formación de nuevas semillas. — Imagen: © Christening / Envato Elements.

La polinización es un proceso biológico esencial para la reproducción de la mayoría de las plantas con flores (angiospermas) y constituye uno de los mecanismos ecológicos más importantes para el mantenimiento de los ecosistemas terrestres. Este fenómeno consiste en la transferencia de los granos de polen desde las estructuras reproductoras masculinas de una flor —los estambres— hasta el estigma del órgano reproductor femenino, donde puede iniciarse el proceso de fecundación.
En las plantas que dependen de polinizadores animales, este transporte de polen se realiza mediante una interacción ecológica altamente especializada entre plantas y organismos visitantes, principalmente insectos. Las abejas, como las que aparecen en la imagen, se encuentran entre los polinizadores más eficientes debido a su comportamiento alimenticio y a su morfología corporal. Mientras buscan néctar —una sustancia rica en azúcares producida por la flor— o recolectan polen como fuente de proteínas, su cuerpo queda cubierto por microscópicos granos de polen que posteriormente pueden depositarse en otras flores.
Desde el punto de vista biológico, este proceso favorece la polinización cruzada, es decir, la transferencia de polen entre individuos distintos de una misma especie. Este mecanismo tiene una enorme importancia evolutiva, ya que permite la recombinación genética y aumenta la variabilidad de las poblaciones vegetales. Gracias a esta diversidad genética, las especies pueden adaptarse mejor a cambios ambientales, resistir enfermedades o colonizar nuevos hábitats.
Las flores han desarrollado a lo largo de la evolución múltiples adaptaciones para atraer a los polinizadores. Los colores intensos, los patrones visibles solo en el espectro ultravioleta, las fragancias aromáticas y la producción de néctar son estrategias que actúan como señales visuales y químicas para los insectos. A su vez, muchos polinizadores han evolucionado características anatómicas y comportamientos específicos que les permiten acceder a estos recursos de forma más eficiente.
En el caso de las abejas, su cuerpo está cubierto de finos pelos ramificados que facilitan la adhesión del polen. Además, poseen estructuras especializadas en las patas posteriores, conocidas como corbículas o cestas de polen, donde almacenan el polen que transportan hasta la colmena. Durante sus desplazamientos entre flores, estos insectos actúan como auténticos vectores biológicos de la reproducción vegetal.
La importancia ecológica de la polinización va mucho más allá del ciclo reproductivo de una planta individual. Este proceso sostiene gran parte de la productividad de los ecosistemas terrestres, ya que una proporción considerable de las plantas con flores depende de animales polinizadores para completar su ciclo vital. A través de este mecanismo se garantiza la producción de semillas, frutos y nuevos individuos vegetales que, a su vez, sirven de alimento a numerosas especies animales.
Desde una perspectiva más amplia, la polinización constituye uno de los pilares fundamentales de la biodiversidad terrestre. La estrecha relación evolutiva entre plantas y polinizadores ha generado una extraordinaria diversidad de formas, colores y comportamientos tanto en el mundo vegetal como en el animal. Este fenómeno de coevolución ha contribuido a la aparición de complejas redes ecológicas que mantienen el equilibrio y la estabilidad de los ecosistemas.
En definitiva, la escena aparentemente simple de unas abejas visitando una flor representa en realidad uno de los procesos más sofisticados y esenciales de la biología terrestre. A través de estos encuentros cotidianos entre insectos y flores se perpetúa el ciclo reproductivo de innumerables especies vegetales, garantizando la continuidad de la vida vegetal y, con ella, el funcionamiento de gran parte de los ecosistemas del planeta.
3.6. Adaptaciones: cómo las plantas sobreviven en ambientes extremos
Uno de los rasgos más sorprendentes del mundo vegetal es su capacidad para habitar prácticamente cualquier ambiente del planeta. Las plantas crecen en desiertos abrasadores, en montañas azotadas por el frío, en suelos salinos junto al mar e incluso en regiones donde el agua es escasa o las temperaturas alcanzan extremos severos. Esta extraordinaria capacidad de colonización se debe a la evolución de numerosas adaptaciones, es decir, características estructurales, fisiológicas o químicas que permiten a las plantas sobrevivir en condiciones difíciles.
A diferencia de los animales, las plantas no pueden desplazarse para escapar de un entorno hostil. Deben enfrentarse a las condiciones del lugar donde germinan y desarrollar estrategias que les permitan resistir la escasez de agua, el frío, el calor, la salinidad o la falta de nutrientes. Por esta razón, la evolución vegetal ha favorecido una enorme variedad de soluciones biológicas que permiten aprovechar al máximo los recursos disponibles.
Uno de los ambientes más desafiantes para la vida vegetal son los desiertos, donde la disponibilidad de agua es extremadamente limitada y las temperaturas pueden oscilar entre el calor intenso del día y el frío de la noche. Las plantas que habitan en estos ecosistemas han desarrollado adaptaciones especiales para conservar el agua. Muchas de ellas poseen hojas muy pequeñas o transformadas en espinas, lo que reduce la superficie de evaporación. Otras almacenan agua en tejidos engrosados, como ocurre en los cactus y otras plantas suculentas.
Además de estas características visibles, las plantas del desierto presentan mecanismos fisiológicos que les permiten utilizar el agua de manera extremadamente eficiente. Algunas especies abren sus estomas durante la noche en lugar de hacerlo durante el día, reduciendo así la pérdida de agua por evaporación mientras continúan realizando procesos metabólicos esenciales.
En el extremo opuesto se encuentran las plantas adaptadas a ambientes fríos o de alta montaña, donde las bajas temperaturas, los fuertes vientos y los suelos pobres representan grandes desafíos. En estas regiones muchas plantas crecen muy cerca del suelo, adoptando formas compactas que las protegen del viento y conservan mejor el calor. Otras desarrollan tejidos resistentes al congelamiento o ciclos de vida muy cortos que les permiten completar su crecimiento durante los breves periodos de verano.
Las plantas también pueden adaptarse a ambientes con exceso de agua, como pantanos o zonas inundables. En estos casos, el problema principal no es la escasez de agua, sino la falta de oxígeno en el suelo saturado. Algunas especies desarrollan raíces especiales que sobresalen del suelo o que contienen espacios de aire en su interior, permitiendo así el intercambio de gases necesario para la respiración celular.
Otro ambiente particularmente exigente es el de los suelos salinos, presentes en regiones costeras o en ciertos desiertos interiores. La alta concentración de sal puede resultar tóxica para muchas plantas, ya que altera el equilibrio químico de sus células. Sin embargo, algunas especies han desarrollado mecanismos que les permiten tolerar o incluso aprovechar estas condiciones. Estas plantas, conocidas como halófitas, pueden almacenar sal en tejidos especializados o expulsarla a través de estructuras específicas en sus hojas.
Las adaptaciones vegetales no se limitan a cambios estructurales. Muchas plantas producen compuestos químicos que les permiten resistir el ataque de herbívoros, microorganismos o condiciones ambientales adversas. Estas sustancias pueden actuar como defensas naturales frente a insectos y animales que intentan alimentarse de ellas, o como protección frente a la radiación solar intensa.
La interacción con otros organismos también puede formar parte de las estrategias de supervivencia vegetal. En muchos casos, las raíces de las plantas establecen relaciones simbióticas con hongos del suelo, formando asociaciones conocidas como micorrizas. Estas relaciones permiten mejorar la absorción de nutrientes y aumentar la resistencia de la planta frente a condiciones difíciles.
Incluso en ambientes aparentemente hostiles, como suelos volcánicos recientes o regiones áridas con muy pocos nutrientes, las plantas pueden ser las primeras colonizadoras. Algunas especies pioneras son capaces de crecer en terrenos casi estériles, iniciando procesos ecológicos que con el tiempo permiten el establecimiento de comunidades vegetales más complejas.
La diversidad de adaptaciones vegetales refleja una larga historia evolutiva marcada por la interacción constante entre los organismos y su entorno. A lo largo de millones de años, las plantas han respondido a cambios climáticos, transformaciones geológicas y presiones ecológicas desarrollando nuevas formas de sobrevivir y reproducirse.
Este proceso evolutivo explica por qué el mundo vegetal presenta una extraordinaria variedad de formas, tamaños y estrategias de vida. Desde los cactus del desierto hasta los musgos de las regiones polares, desde las plantas acuáticas hasta los árboles gigantes de las selvas tropicales, cada especie representa una solución particular a los desafíos del ambiente.
Comprender estas adaptaciones permite apreciar mejor la complejidad del mundo vegetal y su capacidad para sostener la vida en condiciones muy diversas. Las plantas no son organismos frágiles o pasivos; por el contrario, son sistemas biológicos altamente eficientes que han aprendido a prosperar en casi todos los rincones del planeta.
En última instancia, las adaptaciones vegetales revelan una de las grandes lecciones de la evolución: la vida encuentra caminos inesperados para persistir. Allí donde las condiciones parecen más difíciles, el mundo vegetal ha desarrollado soluciones ingeniosas que le permiten seguir creciendo, transformando el paisaje y sosteniendo el equilibrio de los ecosistemas terrestres.
3.7. Plantas y ecosistemas: bosques, praderas y selvas
Las plantas no viven aisladas. En la naturaleza forman comunidades complejas que interactúan entre sí y con numerosos organismos animales, microbianos y fúngicos. Estas comunidades vegetales constituyen la base estructural de los ecosistemas terrestres, es decir, sistemas dinámicos donde la vida se organiza en redes de relaciones que incluyen el suelo, el clima, el agua y la energía solar. Comprender el papel de las plantas en estos sistemas permite entender cómo se configuran los grandes paisajes naturales del planeta.
Las formaciones vegetales dominantes de una región dependen principalmente del clima —especialmente de la temperatura y la disponibilidad de agua— así como de las características del suelo y de la historia ecológica del lugar. Como resultado, la superficie terrestre se organiza en grandes tipos de ecosistemas donde determinadas formas de vegetación se vuelven predominantes. Entre los más importantes se encuentran los bosques, las praderas y las selvas.
Los bosques representan uno de los ecosistemas más complejos y extendidos de la Tierra. Se caracterizan por la presencia dominante de árboles que forman un dosel vegetal capaz de cubrir grandes superficies. Bajo este dosel se desarrolla una estructura ecológica en varios niveles: árboles altos, arbustos, plantas herbáceas, musgos y una rica comunidad de hongos y microorganismos en el suelo.
Los bosques desempeñan funciones ecológicas fundamentales. Actúan como grandes reguladores del clima, absorbiendo dióxido de carbono de la atmósfera y liberando oxígeno a través de la fotosíntesis. Además, contribuyen a mantener la humedad del suelo, regulan el ciclo del agua y protegen el terreno frente a la erosión. Al mismo tiempo, ofrecen refugio y alimento a una enorme diversidad de especies animales.
Existen diversos tipos de bosques en función del clima. En las regiones templadas predominan los bosques caducifolios, donde muchos árboles pierden sus hojas durante el otoño para reducir la pérdida de agua en invierno. En las zonas frías aparecen los bosques de coníferas o taigas, caracterizados por árboles resistentes al frío, como pinos y abetos. Cada uno de estos ecosistemas refleja una adaptación específica de las plantas a las condiciones ambientales.
Las praderas, por su parte, constituyen ecosistemas dominados por plantas herbáceas, principalmente gramíneas. Se desarrollan en regiones donde las precipitaciones no son suficientes para mantener grandes bosques, pero sí permiten el crecimiento de vegetación baja y extensa. Estas regiones incluyen las estepas euroasiáticas, las grandes praderas de América del Norte o las pampas de Sudamérica.
Aunque a primera vista las praderas pueden parecer ecosistemas simples, en realidad albergan una gran riqueza biológica. Sus suelos suelen ser muy fértiles debido a la acumulación de materia orgánica producida por las raíces de las plantas herbáceas. Estos ecosistemas sostienen grandes poblaciones de herbívoros, desde insectos hasta mamíferos de gran tamaño, y constituyen uno de los paisajes más importantes para la producción agrícola humana.
Las praderas también están estrechamente ligadas a fenómenos naturales como el fuego o el pastoreo. En muchos casos, los incendios periódicos o la actividad de herbívoros impiden el crecimiento de árboles y favorecen la permanencia de la vegetación herbácea. De este modo, el equilibrio ecológico de las praderas depende de una interacción constante entre plantas, animales y procesos naturales.
Las selvas tropicales representan uno de los ecosistemas más ricos y complejos del planeta. Se desarrollan en regiones cercanas al ecuador, donde las temperaturas son altas durante todo el año y las precipitaciones son abundantes. Estas condiciones permiten un crecimiento vegetal extraordinariamente intenso y una biodiversidad excepcional.
En las selvas tropicales, la vegetación se organiza en varios niveles superpuestos. Los árboles más altos forman un dosel cerrado que puede alcanzar decenas de metros de altura, mientras que debajo de él prosperan otras plantas adaptadas a condiciones de menor luminosidad. Lianas, epífitas y numerosas especies arbustivas se entrelazan en un sistema vegetal extraordinariamente denso.
La diversidad de especies en las selvas tropicales es tan grande que en una sola hectárea pueden encontrarse cientos de especies distintas de plantas. Este mosaico vegetal sustenta una enorme variedad de animales, desde insectos y anfibios hasta aves y mamíferos. La selva funciona como una compleja red ecológica donde cada organismo ocupa un lugar específico.
Más allá de sus diferencias, bosques, praderas y selvas comparten una característica fundamental: las plantas constituyen la base sobre la que se organiza todo el ecosistema. Son ellas las que capturan la energía solar, producen la biomasa que alimenta a otros organismos y crean las estructuras físicas que permiten la existencia de hábitats diversos.
Además, la vegetación influye profundamente en las condiciones ambientales de cada región. Los bosques regulan la humedad y la temperatura local, las praderas estabilizan los suelos y las selvas tropicales participan activamente en el ciclo global del carbono y del agua. De este modo, los ecosistemas vegetales no solo sostienen la vida local, sino que contribuyen al equilibrio del planeta en su conjunto.
Sin embargo, estos sistemas se encuentran hoy bajo una presión creciente debido a la actividad humana. La deforestación, la expansión agrícola, la urbanización y el cambio climático están alterando muchos de los ecosistemas vegetales del planeta. La pérdida de bosques tropicales, la degradación de praderas naturales o la fragmentación de hábitats representan desafíos ecológicos de gran magnitud.
Comprender el papel de las plantas en los ecosistemas permite valorar la importancia de conservar estos sistemas naturales. Bosques, praderas y selvas no son simplemente paisajes verdes: son complejas estructuras vivas que sostienen la biodiversidad, regulan procesos planetarios fundamentales y mantienen el equilibrio ecológico del que depende la vida humana.
Pradera natural dominada por vegetación herbácea y flores silvestres, un ecosistema abierto donde las gramíneas y plantas perennes forman comunidades vegetales de gran importancia ecológica. Las praderas son ecosistemas terrestres caracterizados por la dominancia de plantas herbáceas, especialmente gramíneas y flores silvestres. Aunque menos densas que los bosques o selvas, estas comunidades vegetales albergan una rica diversidad biológica y desempeñan un papel fundamental en el equilibrio de los paisajes naturales. — © AirImages / Envato Elements.

Las praderas constituyen uno de los grandes biomas terrestres dominados por vegetación herbácea. A diferencia de los bosques o selvas, donde la estructura ecológica está definida por árboles de gran porte, en las praderas la vegetación se organiza principalmente en torno a gramíneas, plantas perennes y flores silvestres que forman extensas comunidades vegetales adaptadas a condiciones ambientales específicas.
Desde una perspectiva ecológica, las praderas se desarrollan en regiones donde la disponibilidad de agua, la composición del suelo y las perturbaciones naturales —como el fuego, el viento o el pastoreo— limitan el establecimiento de árboles de gran tamaño. Estas condiciones favorecen la dominancia de plantas herbáceas que presentan adaptaciones particulares, como raíces profundas, ciclos de crecimiento rápidos y una gran capacidad de regeneración tras daños o perturbaciones.
Uno de los rasgos más notables de estos ecosistemas es que una parte considerable de su biomasa vegetal se encuentra bajo la superficie del suelo. Las raíces de las gramíneas y otras plantas herbáceas forman redes densas y profundas que permiten a las plantas acceder a nutrientes y agua incluso en condiciones climáticas variables. Este sistema radicular contribuye también a la estabilidad del suelo, favorece la acumulación de materia orgánica y participa activamente en los ciclos biogeoquímicos del carbono y del nitrógeno.
Las praderas albergan además una notable diversidad de organismos. Aunque el paisaje pueda parecer relativamente uniforme a simple vista, estas comunidades vegetales sostienen complejas redes ecológicas que incluyen insectos polinizadores, pequeños mamíferos, aves, reptiles y microorganismos del suelo. Muchas especies dependen de estas plantas herbáceas para alimentarse, reproducirse o encontrar refugio, lo que convierte a las praderas en sistemas ecológicos dinámicos y altamente productivos.
Desde el punto de vista evolutivo, las praderas han desempeñado un papel crucial en la historia de numerosos organismos. Grandes herbívoros como bisontes, antílopes o caballos han evolucionado en estrecha relación con estos ecosistemas abiertos, mientras que muchos insectos especializados han desarrollado ciclos de vida vinculados a determinadas especies de plantas herbáceas.
Además de su importancia ecológica, las praderas cumplen funciones ambientales fundamentales. Actúan como importantes reservorios de carbono en el suelo, ayudan a regular los ciclos hidrológicos y contribuyen a prevenir procesos de erosión. Estas características las convierten en ecosistemas clave para la estabilidad de amplias regiones del planeta.
La imagen de una pradera cubierta de flores silvestres ilustra así una forma particular de organización de la vida vegetal. Frente a la densidad estructural de bosques y selvas, las praderas representan un modelo ecológico distinto, donde la biodiversidad se expresa a través de comunidades herbáceas altamente adaptadas y a través de complejas interacciones entre plantas, animales y suelo. En conjunto, estos paisajes abiertos forman parte esencial del mosaico de ecosistemas que sostienen la diversidad biológica de la Tierra.
3.8. Agricultura y domesticación: plantas al servicio de la humanidad
La relación entre los seres humanos y las plantas ha sido una de las fuerzas más decisivas en la historia de la civilización. Durante la mayor parte de la existencia humana, nuestros antepasados dependieron de la recolección de frutos, raíces, semillas y otras partes de plantas silvestres para su alimentación. Sin embargo, hace unos diez mil años comenzó a producirse una transformación profunda: diversas sociedades humanas descubrieron que podían cultivar determinadas plantas y controlar su crecimiento, dando origen a la agricultura.
Este cambio marcó una de las grandes revoluciones de la historia humana. La domesticación de plantas permitió abandonar gradualmente el nomadismo de los grupos cazadores-recolectores y establecer comunidades sedentarias. A partir de ese momento, el cultivo sistemático de especies vegetales se convirtió en la base económica de las primeras civilizaciones.
La domesticación vegetal consiste en un proceso mediante el cual los seres humanos seleccionan y reproducen plantas con características que resultan útiles o beneficiosas. A lo largo de generaciones, las plantas cultivadas van desarrollando rasgos distintos de los de sus antepasados silvestres. Semillas más grandes, frutos más abundantes, menor presencia de sustancias tóxicas o ciclos de crecimiento más predecibles son algunos de los resultados de esta selección.
Este proceso no ocurrió en un único lugar ni en un único momento. La agricultura surgió de manera independiente en diferentes regiones del mundo. En el llamado Creciente Fértil, en el Próximo Oriente, se domesticaron especies como el trigo y la cebada. En Asia oriental se desarrolló el cultivo del arroz, mientras que en América se domesticaron plantas fundamentales como el maíz, la patata, el tomate y el cacao. Cada una de estas regiones creó sistemas agrícolas adaptados a sus condiciones climáticas y culturales.
Con el tiempo, estas plantas domesticadas se difundieron por todo el planeta, transformando profundamente la dieta humana y la organización social. Muchas de las especies que hoy consideramos alimentos básicos son el resultado de miles de años de selección agrícola. El maíz moderno, por ejemplo, es muy distinto de la planta silvestre original de la que procede, conocida como teosinte.
La agricultura no solo proporcionó una fuente más estable de alimento, sino que también permitió el desarrollo de sociedades complejas. La producción agrícola generó excedentes que podían almacenarse, lo que favoreció el crecimiento de las poblaciones, la aparición de ciudades y la especialización del trabajo. Artesanos, comerciantes, administradores y gobernantes surgieron en sociedades que ya no dependían exclusivamente de la caza y la recolección.
A lo largo de la historia, las plantas cultivadas han desempeñado un papel central en la economía y la cultura de las civilizaciones. Cereales como el trigo, el arroz o el maíz han sido la base alimentaria de millones de personas. Plantas como el algodón o el lino han permitido la producción de tejidos, mientras que otras especies han proporcionado aceites, bebidas, especias o materiales de construcción.
Sin embargo, la agricultura no se limita a producir alimentos. También implica una profunda transformación de los ecosistemas naturales. Para cultivar plantas es necesario modificar el terreno, preparar el suelo, controlar el agua y, en muchos casos, eliminar la vegetación original. A lo largo de milenios, estas actividades han transformado grandes regiones del planeta en paisajes agrícolas.
Durante los últimos siglos, el desarrollo tecnológico ha intensificado enormemente la producción agrícola. El uso de maquinaria, fertilizantes, sistemas de riego y nuevas variedades vegetales ha permitido aumentar de forma notable el rendimiento de los cultivos. Este proceso ha sido fundamental para alimentar a una población humana en constante crecimiento.
La mejora genética de las plantas cultivadas ha desempeñado un papel clave en este desarrollo. Mediante la selección artificial, los agricultores y científicos han obtenido variedades más resistentes a enfermedades, más productivas o mejor adaptadas a determinados climas. En tiempos recientes, la biotecnología ha permitido incluso modificar directamente el material genético de algunas plantas para introducir características específicas.
Sin embargo, estos avances también plantean desafíos importantes. La expansión de la agricultura intensiva puede provocar pérdida de biodiversidad, degradación del suelo y uso excesivo de recursos como el agua. Además, la sustitución de múltiples variedades tradicionales por unas pocas variedades comerciales puede reducir la diversidad genética de los cultivos.
Por esta razón, en la actualidad se busca cada vez más un equilibrio entre productividad y sostenibilidad. La agricultura moderna intenta combinar los conocimientos científicos con prácticas que respeten los ecosistemas y mantengan la fertilidad del suelo a largo plazo. Conceptos como agricultura sostenible, agroecología o conservación de variedades tradicionales reflejan esta preocupación creciente.
La domesticación de plantas ha permitido a la humanidad construir civilizaciones, alimentar poblaciones numerosas y desarrollar culturas complejas. Sin embargo, esta relación con el mundo vegetal también implica una responsabilidad. Las plantas no son simplemente recursos explotables; forman parte de sistemas ecológicos delicados que sostienen la vida en el planeta.
Comprender la historia de la agricultura y de la domesticación vegetal nos recuerda hasta qué punto la humanidad depende del mundo vegetal. Desde los primeros campos cultivados del Neolítico hasta los sistemas agrícolas contemporáneos, las plantas han estado siempre al servicio de la humanidad, pero también nos enseñan una lección fundamental: nuestra supervivencia está íntimamente ligada al equilibrio de la naturaleza que nos rodea.
Espigas de trigo madurando en un campo cultivado, uno de los cereales más importantes en la historia de la agricultura y en la alimentación de la humanidad. El trigo es uno de los cultivos fundamentales de la civilización humana. Desde los primeros asentamientos agrícolas del Neolítico, este cereal ha constituido una de las principales fuentes de alimento para numerosas culturas y sociedades.— © Maxbelchenko / Envato Elements.

El trigo (Triticum spp.) es uno de los cultivos agrícolas más antiguos y relevantes en la historia de la humanidad. Su domesticación se remonta aproximadamente a hace diez mil años, durante el periodo neolítico, en una región conocida como el Creciente Fértil, que abarca áreas del actual Oriente Próximo. En este contexto surgieron algunas de las primeras comunidades agrícolas sedentarias, que comenzaron a cultivar cereales silvestres como el trigo y la cebada para asegurar un suministro estable de alimentos.
Desde el punto de vista botánico, el trigo pertenece a la familia de las gramíneas (Poaceae), un grupo de plantas herbáceas que incluye numerosos cereales de gran importancia económica, como el arroz, el maíz, el centeno o la avena. Estas plantas presentan una morfología característica: tallos huecos, hojas estrechas y largas, y una inflorescencia denominada espiga, donde se desarrollan los granos que posteriormente se convierten en semillas comestibles.
El valor nutricional del trigo reside principalmente en su alto contenido en carbohidratos complejos, especialmente en forma de almidón, que proporciona una fuente importante de energía para el organismo humano. Además, contiene proteínas vegetales, vitaminas del grupo B y diversos minerales. La molienda de los granos permite obtener harina, base para la elaboración de numerosos alimentos fundamentales en muchas culturas, como el pan, la pasta o diversos productos de repostería.
Desde una perspectiva histórica, el cultivo del trigo desempeñó un papel decisivo en la transición de las sociedades humanas desde formas de vida basadas en la caza y la recolección hacia economías agrícolas más complejas. La posibilidad de almacenar granos durante largos periodos permitió garantizar reservas alimentarias, lo que favoreció el crecimiento demográfico, la aparición de asentamientos permanentes y el desarrollo de estructuras sociales más organizadas.
A lo largo de los siglos, el trigo ha sido objeto de intensos procesos de selección y mejora por parte de las sociedades humanas. Mediante técnicas de cultivo, hibridación y selección artificial, los agricultores han desarrollado variedades más productivas, resistentes a enfermedades o adaptadas a diferentes condiciones climáticas. Este proceso de domesticación continua constituye uno de los ejemplos más claros de cómo la humanidad ha transformado determinadas especies vegetales para satisfacer sus necesidades alimentarias.
En la actualidad, el trigo sigue siendo uno de los cultivos más extendidos del planeta. Millones de hectáreas de tierras agrícolas en todos los continentes se dedican a su producción, lo que lo convierte en un elemento central de la seguridad alimentaria global. Su cultivo representa también un ejemplo de la estrecha relación entre las plantas y las sociedades humanas, una interacción que ha modelado paisajes agrícolas y ha influido profundamente en la historia cultural, económica y biológica de nuestra especie.
Así, la imagen de un campo de trigo maduro no solo evoca un paisaje agrícola familiar, sino que también simboliza una de las grandes transformaciones de la historia humana: el momento en que ciertas plantas pasaron de formar parte del entorno natural a convertirse en recursos cultivados que sostienen la alimentación de miles de millones de personas.
3.9. Plantas medicinales y química vegetal
Desde los orígenes de la humanidad, las plantas han desempeñado un papel fundamental en el cuidado de la salud. Mucho antes de que existiera la medicina científica moderna, los seres humanos aprendieron a observar el mundo vegetal y a identificar especies que podían aliviar el dolor, curar heridas o tratar enfermedades. Este conocimiento, transmitido a lo largo de generaciones, constituye uno de los pilares más antiguos de la medicina.
Las plantas medicinales contienen una gran variedad de compuestos químicos producidos por su propio metabolismo. Estas sustancias, conocidas como metabolitos secundarios, no siempre participan directamente en las funciones básicas de crecimiento o reproducción de la planta, pero desempeñan un papel importante en su defensa frente a herbívoros, insectos o microorganismos. Muchas de estas moléculas poseen propiedades biológicas que también pueden influir en el organismo humano.
La relación entre plantas y medicina se basa precisamente en esta riqueza química. A lo largo de la evolución, las plantas han desarrollado complejas combinaciones de sustancias capaces de interactuar con procesos fisiológicos de otros organismos. Algunos compuestos actúan como analgésicos, otros como antiinflamatorios, antibacterianos o estimulantes del sistema nervioso.
Uno de los ejemplos más conocidos es el del ácido salicílico, una sustancia presente de forma natural en la corteza del sauce. Desde la antigüedad se utilizaban extractos de esta planta para aliviar el dolor y reducir la fiebre. A partir de este conocimiento tradicional, la química moderna desarrolló el ácido acetilsalicílico, más conocido como aspirina, uno de los medicamentos más utilizados en el mundo.
Otro ejemplo importante es la quinina, obtenida de la corteza del árbol de la quina, originario de América del Sur. Durante siglos, este compuesto fue uno de los tratamientos más eficaces contra la malaria, una enfermedad transmitida por mosquitos que ha afectado a millones de personas a lo largo de la historia.
El mundo vegetal ha proporcionado también sustancias utilizadas en el tratamiento de enfermedades graves. Algunos compuestos empleados en terapias contra el cáncer, por ejemplo, fueron descubiertos originalmente en plantas. Esto demuestra hasta qué punto la diversidad química del mundo vegetal puede convertirse en una fuente valiosa de conocimiento médico.
La química vegetal es extraordinariamente compleja. Las plantas producen miles de compuestos distintos, muchos de los cuales todavía no han sido completamente estudiados. Estas sustancias pueden incluir alcaloides, terpenos, flavonoides, aceites esenciales y otras moléculas con propiedades biológicas muy variadas.
En la naturaleza, estos compuestos cumplen funciones específicas. Algunas sustancias sirven como defensa frente a insectos o animales herbívoros, produciendo sabores amargos o efectos tóxicos. Otras participan en la comunicación química con otros organismos, como ocurre con los aromas de las flores que atraen a los polinizadores. Algunas incluso ayudan a proteger a la planta frente a radiación solar intensa o infecciones microbianas.
Para los seres humanos, esta diversidad química representa un verdadero laboratorio natural. Muchas culturas tradicionales han desarrollado sistemas de medicina basados en el uso de plantas, aprovechando sus propiedades terapéuticas. La fitoterapia, es decir, el uso de extractos vegetales con fines medicinales, forma parte de numerosas tradiciones médicas en distintas regiones del mundo.
Sin embargo, el conocimiento tradicional sobre plantas medicinales ha evolucionado con el desarrollo de la ciencia moderna. Hoy en día, los compuestos activos presentes en las plantas pueden aislarse, analizarse y estudiarse con precisión mediante técnicas químicas y farmacológicas. Esto permite comprender mejor su funcionamiento, determinar dosis adecuadas y evaluar posibles efectos secundarios.
La investigación científica continúa explorando el mundo vegetal en busca de nuevas sustancias con potencial terapéutico. Muchos ecosistemas, especialmente las selvas tropicales, albergan una enorme diversidad de especies vegetales que aún no han sido estudiadas en profundidad. Cada una de estas especies podría contener compuestos químicos con aplicaciones médicas futuras.
Este hecho plantea también una cuestión importante relacionada con la conservación de la biodiversidad. La desaparición de ecosistemas naturales implica la pérdida de especies vegetales que podrían contener moléculas valiosas para la medicina. En cierto sentido, la diversidad vegetal constituye una reserva biológica de conocimiento químico que todavía estamos lejos de comprender por completo.
Además del ámbito farmacéutico, la química vegetal influye en muchos otros aspectos de la vida humana. Los aromas de las especias, los sabores de frutas y bebidas, los pigmentos naturales de flores y frutos o los aceites esenciales utilizados en perfumes y cosméticos son ejemplos de cómo los compuestos vegetales forman parte de nuestra experiencia cotidiana.
En definitiva, el estudio de las plantas medicinales revela una dimensión fascinante del mundo vegetal. Las plantas no solo producen alimento y oxígeno, sino también una extraordinaria variedad de sustancias químicas que interactúan con otros organismos y que pueden resultar beneficiosas para la salud humana.
Comprender esta relación entre plantas y medicina nos recuerda que la naturaleza es una fuente inagotable de conocimiento. En las hojas, raíces y flores de innumerables especies vegetales se esconde una compleja farmacia natural que la humanidad ha comenzado a explorar, pero que aún guarda muchos secretos por descubrir.
Preparación tradicional de plantas medicinales en mortero, acompañadas de hierbas secas utilizadas en fitoterapia. Desde tiempos muy antiguos, las plantas han sido una de las principales fuentes de remedios para el ser humano. Muchas culturas desarrollaron conocimientos empíricos sobre las propiedades curativas de hojas, raíces, flores y cortezas, dando origen a tradiciones médicas basadas en la observación y la experiencia. La investigación científica moderna ha demostrado que muchas de estas propiedades se deben a compuestos químicos específicos producidos por las plantas.— Imagen: © Yanadjana (Envato Elements).

Las plantas constituyen verdaderos laboratorios químicos naturales. A lo largo de su evolución, han desarrollado una enorme variedad de moléculas orgánicas complejas que desempeñan funciones ecológicas esenciales: defensa frente a herbívoros, protección contra microorganismos, regulación del crecimiento o interacción con otros organismos del ecosistema. Muchas de estas sustancias, conocidas como metabolitos secundarios, poseen propiedades farmacológicas que han sido aprovechadas por la medicina humana.
Entre los principales grupos de compuestos bioactivos presentes en las plantas se encuentran los alcaloides, los terpenos, los flavonoides, los taninos y numerosos glucósidos. Estas moléculas pueden actuar como analgésicos, antiinflamatorios, antimicrobianos, sedantes o estimulantes del sistema nervioso. Ejemplos bien conocidos incluyen la morfina derivada del opio, la quinina procedente de la corteza de la quina, la aspirina originalmente inspirada en compuestos del sauce o los alcaloides presentes en numerosas especies tropicales.
La fitoterapia, es decir, el uso terapéutico de plantas medicinales, se apoya hoy tanto en la tradición etnobotánica como en la investigación bioquímica moderna. Los científicos analizan las sustancias presentes en las plantas, estudian su estructura molecular y evalúan su efecto sobre los procesos fisiológicos del organismo humano. Este trabajo ha permitido aislar principios activos, desarrollar medicamentos y comprender mejor la compleja interacción entre los compuestos vegetales y los sistemas biológicos.
Desde el punto de vista ecológico, la diversidad química de las plantas refleja millones de años de evolución en interacción con insectos, hongos, bacterias y otros organismos. Muchas moléculas que hoy se utilizan en farmacología surgieron originalmente como estrategias de defensa o comunicación biológica dentro de los ecosistemas. La investigación de la química vegetal continúa siendo un campo de enorme interés científico, ya que innumerables especies aún no estudiadas podrían contener compuestos con aplicaciones médicas futuras.
De este modo, el estudio de las plantas medicinales no solo conecta con antiguas tradiciones culturales, sino que también abre una ventana hacia uno de los aspectos más fascinantes de la biología: la extraordinaria capacidad de los organismos vegetales para generar una diversidad química capaz de influir profundamente en la salud y en la vida humana.
3.10. El futuro de la botánica: biodiversidad, deforestación y cambio climático
El estudio de las plantas no pertenece únicamente al pasado ni al ámbito académico de los laboratorios. En el mundo contemporáneo, la botánica adquiere una importancia creciente porque muchos de los grandes desafíos ambientales del siglo XXI están directamente relacionados con el mundo vegetal. La biodiversidad, la conservación de los bosques, el equilibrio climático y la seguridad alimentaria dependen en gran medida de la forma en que comprendamos y gestionemos los ecosistemas vegetales del planeta.
Uno de los conceptos centrales en este contexto es el de biodiversidad, que se refiere a la variedad de formas de vida existentes en la Tierra. Dentro de esta diversidad, las plantas constituyen un componente esencial. Se estima que existen cientos de miles de especies vegetales diferentes, cada una con características biológicas únicas y con un papel específico dentro de los ecosistemas.
La biodiversidad vegetal no es simplemente una colección de especies distintas. Representa una red compleja de relaciones ecológicas que sostienen el equilibrio de los sistemas naturales. Cada planta forma parte de un entramado que incluye animales, microorganismos, suelos y procesos climáticos. La desaparición de una especie vegetal puede desencadenar cambios en cadena que afectan a muchas otras formas de vida.
Sin embargo, en las últimas décadas el mundo vegetal se enfrenta a presiones crecientes. La deforestación, impulsada por la expansión agrícola, la explotación de madera y el crecimiento urbano, ha provocado la desaparición de grandes extensiones de bosques en distintas regiones del planeta. Las selvas tropicales, que albergan algunos de los ecosistemas más ricos en biodiversidad, han sufrido una pérdida significativa de superficie.
La desaparición de estos bosques no solo afecta a las plantas que los componen. También altera profundamente los ciclos ecológicos globales. Los bosques desempeñan un papel crucial en la regulación del clima, ya que absorben grandes cantidades de dióxido de carbono de la atmósfera. Cuando los bosques son destruidos, el carbono almacenado en la biomasa vegetal puede liberarse nuevamente al aire, contribuyendo al aumento de gases de efecto invernadero.
Este fenómeno está estrechamente vinculado con otro desafío fundamental: el cambio climático. El aumento de las temperaturas globales y las alteraciones en los patrones de precipitaciones están modificando las condiciones ambientales en muchas regiones del mundo. Estas transformaciones afectan directamente a las plantas, que dependen de factores climáticos relativamente estables para crecer y reproducirse.
Algunas especies vegetales pueden adaptarse a estos cambios o desplazarse hacia regiones más favorables, pero muchas otras tienen dificultades para hacerlo. Los cambios rápidos en el clima pueden superar la capacidad de adaptación de ciertos ecosistemas, provocando la desaparición de especies o la transformación profunda de paisajes naturales.
Además, el cambio climático puede alterar fenómenos ecológicos delicados como la sincronización entre la floración de las plantas y la actividad de sus polinizadores. Si las temperaturas modifican los ciclos estacionales, plantas e insectos pueden dejar de coincidir en el tiempo, lo que afectaría a los procesos de reproducción vegetal.
En este contexto, la botánica se convierte en una ciencia fundamental para comprender y afrontar estos problemas. Los investigadores estudian cómo responden las plantas a los cambios ambientales, cómo se distribuyen las especies en distintos ecosistemas y qué estrategias pueden contribuir a conservar la biodiversidad vegetal.
La conservación de los ecosistemas vegetales se ha convertido en una prioridad global. La creación de parques naturales, reservas biológicas y programas de restauración forestal busca proteger áreas donde la vegetación mantiene su funcionamiento ecológico natural. Asimismo, los bancos de semillas y jardines botánicos desempeñan un papel importante al preservar especies vegetales que podrían desaparecer en la naturaleza.
Por otra parte, la botánica moderna también explora nuevas posibilidades para el futuro. El estudio de la genética vegetal permite desarrollar cultivos más resistentes a sequías, enfermedades o temperaturas extremas, lo que puede resultar crucial para la agricultura en un clima cambiante. Del mismo modo, la investigación sobre plantas con alta capacidad de capturar carbono podría contribuir a estrategias destinadas a mitigar el calentamiento global.
A medida que aumenta nuestra comprensión del mundo vegetal, también se hace más evidente la profunda interdependencia entre la humanidad y las plantas. Los ecosistemas vegetales regulan el clima, producen oxígeno, mantienen la fertilidad del suelo y sostienen la base alimentaria de la población mundial. Sin ellos, la estabilidad ecológica del planeta sería imposible.
El futuro de la botánica, por tanto, no se limita al descubrimiento de nuevas especies o a la descripción de formas vegetales. Implica comprender cómo proteger y gestionar los sistemas naturales que sostienen la vida en la Tierra. En un mundo donde las presiones ambientales son cada vez mayores, el conocimiento botánico se convierte en una herramienta indispensable para construir una relación más equilibrada entre la civilización humana y la naturaleza.
En última instancia, estudiar el futuro de las plantas significa reflexionar sobre el futuro del propio planeta. La biodiversidad vegetal representa una herencia evolutiva acumulada durante cientos de millones de años. Preservarla no es solo una cuestión científica o ecológica, sino también una responsabilidad hacia las generaciones futuras que habitarán la Tierra después de nosotros.
4.1. Qué estudia la zoología: el reino animal como universo biológico.
4.2. El cuerpo animal: movimiento, sentidos y conducta.
4.3. Vertebrados e invertebrados: dos grandes mundos.
4.4. Evolución animal: adaptación, selección y formas de vida.
4.5. Conducta animal: instinto, aprendizaje e inteligencia.
4.6. Reproducción y cuidado de las crías.
4.7. Depredación, defensa y equilibrio ecológico.
4.8. Migraciones: la vida en movimiento.
4.9. Animales sociales: cooperación y jerarquía.
4.10. El ser humano como animal: continuidad y diferencia.
4.11. Amenazas actuales: extinción, pérdida de hábitats y conservación.

Collage sobre zoología: diversidad animal en distintos ecosistemas — vida marina, grandes mamíferos, anfibios, comportamiento social y trabajo científico de campo.
La zoología estudia la extraordinaria diversidad del reino animal, desde los organismos más pequeños hasta los grandes vertebrados que habitan océanos, bosques y praderas. Cada especie representa una solución evolutiva distinta a los desafíos de la supervivencia: alimentación, reproducción, defensa o adaptación al medio. Al mismo tiempo, el estudio científico de los animales permite comprender mejor los ecosistemas de la Tierra y las complejas relaciones que existen entre todas las formas de vida que comparten el planeta.
4. Zoología: diversidad animal y estrategias de supervivencia
La zoología es la rama de la biología dedicada al estudio científico de los animales, un vasto conjunto de organismos vivos que comparten ciertas características fundamentales, como la capacidad de movimiento, la nutrición heterótrofa y una compleja organización celular basada en tejidos y órganos especializados. Desde diminutos invertebrados microscópicos hasta los grandes mamíferos que recorren los continentes y océanos, el reino animal constituye una de las expresiones más extraordinarias de la diversidad de la vida en la Tierra.
Los animales surgieron en el contexto de la evolución biológica hace cientos de millones de años, como resultado de largos procesos de transformación que comenzaron con organismos unicelulares simples. Con el tiempo, la evolución favoreció la aparición de estructuras cada vez más complejas: sistemas nerviosos capaces de procesar información, órganos sensoriales que permiten percibir el entorno, sistemas musculares que hacen posible el movimiento y mecanismos de comportamiento que facilitan la supervivencia en ambientes cambiantes. Estos avances biológicos permitieron a los animales ocupar prácticamente todos los ecosistemas del planeta, desde las profundidades abisales de los océanos hasta las regiones polares y los desiertos más áridos.
Uno de los rasgos más característicos del mundo animal es su extraordinaria diversidad. Los científicos estiman que existen millones de especies animales distintas, aunque solo una parte de ellas ha sido descrita formalmente por la ciencia. Los animales se distribuyen en grandes grupos evolutivos —como los artrópodos, moluscos, equinodermos, peces, anfibios, reptiles, aves y mamíferos— que reflejan distintas soluciones biológicas al problema fundamental de vivir, crecer y reproducirse en la Tierra.
Cada uno de estos grupos ha desarrollado estrategias de supervivencia específicas, moldeadas por millones de años de evolución natural. Algunas especies han perfeccionado complejas técnicas de depredación, otras han desarrollado sofisticados mecanismos de defensa, como caparazones, venenos o camuflaje. Muchos animales han adquirido conductas sociales altamente organizadas que aumentan sus probabilidades de sobrevivir, como ocurre en colonias de insectos, manadas de mamíferos o bandadas de aves migratorias.
La alimentación constituye uno de los aspectos centrales de estas estrategias. Los animales participan en las cadenas tróficas como herbívoros, carnívoros u omnívoros, desempeñando un papel crucial en la regulación de los ecosistemas. Los depredadores controlan las poblaciones de otras especies, mientras que los herbívoros influyen en la estructura de la vegetación. Incluso los animales que se alimentan de materia orgánica en descomposición cumplen funciones ecológicas esenciales al reciclar nutrientes dentro de los sistemas naturales.
Otro aspecto fundamental de la zoología es el estudio del comportamiento animal, un campo conocido como etología. Las conductas de los animales —desde los rituales de cortejo hasta las migraciones estacionales o el cuidado de las crías— reflejan complejas adaptaciones evolutivas que aumentan las posibilidades de reproducción y supervivencia. A través del estudio del comportamiento, los científicos pueden comprender cómo los animales perciben su entorno, cómo toman decisiones y cómo interactúan con otros individuos de su especie.
La zoología también aborda cuestiones relacionadas con la anatomía y fisiología animal, es decir, la estructura interna de los organismos y el funcionamiento de sus sistemas biológicos. La diversidad de formas corporales que presentan los animales —desde cuerpos segmentados hasta esqueletos internos o externos— refleja adaptaciones a modos de vida muy distintos. Algunas especies están especializadas para el vuelo, otras para el buceo profundo o para la vida subterránea. Cada forma corporal representa una solución evolutiva a los desafíos del entorno.
En el mundo contemporáneo, el estudio de los animales adquiere además una dimensión ecológica y conservacionista cada vez más relevante. La expansión de las actividades humanas ha alterado profundamente muchos hábitats naturales, provocando la disminución de numerosas especies y la desaparición de otras. Comprender la biología y el comportamiento de los animales resulta esencial para diseñar estrategias de conservación que permitan preservar la biodiversidad y mantener el equilibrio de los ecosistemas.
La zoología moderna se apoya en múltiples disciplinas complementarias, como la genética, la ecología, la biogeografía o la paleontología. Gracias a estas herramientas, los científicos pueden reconstruir la historia evolutiva de las especies, estudiar sus relaciones de parentesco y comprender cómo han cambiado las comunidades animales a lo largo del tiempo geológico.
En conjunto, el estudio zoológico revela que el mundo animal no es un simple catálogo de especies aisladas, sino una red compleja de formas de vida interconectadas. Cada animal ocupa un lugar dentro de los ecosistemas y participa en procesos ecológicos que sostienen el funcionamiento de la biosfera.
Comprender esta diversidad y las estrategias que los animales han desarrollado para sobrevivir no solo amplía nuestro conocimiento sobre la naturaleza, sino que también nos ayuda a situar a la especie humana dentro del conjunto de la vida. La zoología nos recuerda que, aunque nuestra cultura y tecnología nos distingan, seguimos formando parte de la misma historia evolutiva que ha dado origen a todas las criaturas que habitan la Tierra.
4.1. Qué estudia la zoología: el reino animal como universo biológico
La zoología es la disciplina de la biología dedicada al estudio científico de los animales. Su objeto de estudio abarca la enorme diversidad de organismos que forman el reino animal, uno de los grandes grupos de seres vivos que habitan la Tierra. Desde organismos microscópicos que viven en el agua o en el suelo hasta los grandes vertebrados que dominan distintos ecosistemas, la zoología trata de comprender cómo son los animales, cómo funcionan, cómo se relacionan con su entorno y cómo han evolucionado a lo largo del tiempo.
A diferencia de otros grupos de seres vivos, los animales comparten ciertas características biológicas fundamentales. Son organismos heterótrofos, lo que significa que obtienen su energía alimentándose de otros seres vivos o de materia orgánica. Sus células carecen de pared celular rígida, lo que permite una mayor flexibilidad estructural y facilita el desarrollo de tejidos especializados. Además, la mayoría de los animales poseen sistemas nerviosos y musculares, que hacen posible el movimiento y la respuesta rápida a los estímulos del entorno.
Estas características han permitido que los animales desarrollen una enorme variedad de formas corporales, comportamientos y modos de vida. A lo largo de millones de años de evolución, las especies animales han colonizado prácticamente todos los ambientes del planeta: océanos, ríos, lagos, bosques, desiertos, montañas e incluso regiones polares. La zoología estudia cómo estas especies han logrado adaptarse a condiciones ambientales tan distintas.
Uno de los objetivos principales de esta ciencia es clasificar y describir la diversidad animal. Los zoologos analizan las características anatómicas, fisiológicas y genéticas de las distintas especies para comprender sus relaciones evolutivas. A partir de estos estudios se establecen grandes grupos dentro del reino animal, como los artrópodos, moluscos, equinodermos o cordados, cada uno de los cuales presenta estructuras corporales y estrategias biológicas particulares.
La zoología no se limita a describir las especies. También investiga el funcionamiento interno de los animales, estudiando sus órganos y sistemas biológicos: el sistema digestivo, el respiratorio, el circulatorio o el nervioso. Comprender cómo operan estos sistemas permite explicar cómo los animales obtienen energía, cómo se reproducen, cómo crecen y cómo mantienen el equilibrio interno necesario para la vida.
Otro campo fundamental de la zoología es el estudio del comportamiento animal. Los animales no solo poseen estructuras biológicas complejas, sino que también desarrollan conductas adaptativas que les permiten sobrevivir en su entorno. Estas conductas incluyen estrategias de caza, mecanismos de defensa, migraciones estacionales, sistemas de comunicación o formas de organización social. Analizar estos comportamientos permite comprender cómo los animales interactúan con otros individuos de su especie y con el ambiente que los rodea.
La zoología también estudia las relaciones ecológicas entre los animales y los ecosistemas en los que viven. Los animales forman parte de redes alimentarias complejas en las que cada especie desempeña un papel específico. Algunos son depredadores, otros herbívoros, otros carroñeros o descomponedores. Estas interacciones contribuyen al equilibrio de los ecosistemas y regulan las poblaciones de diferentes organismos.
En la actualidad, el estudio del reino animal tiene además una dimensión crucial desde el punto de vista de la conservación de la biodiversidad. La expansión de las actividades humanas ha provocado la pérdida de hábitats naturales y la disminución de numerosas especies animales. Comprender la biología de los animales y las condiciones necesarias para su supervivencia resulta fundamental para proteger los ecosistemas y preservar la diversidad de la vida.
En definitiva, la zoología explora el reino animal como un universo biológico extraordinariamente diverso y complejo. Cada especie representa el resultado de una larga historia evolutiva y una forma particular de resolver los desafíos de la existencia. Al estudiar esta diversidad, la zoología no solo amplía nuestro conocimiento sobre la vida en la Tierra, sino que también revela la profunda interconexión que existe entre todos los seres vivos que comparten el planeta.
Grandes felinos depredadores — jaguar, león, leopardo y guepardo — representativos de algunos de los principales carnívoros de los ecosistemas terrestres. Los grandes felinos se encuentran entre los depredadores más poderosos y especializados del reino animal. Su anatomía, sus sentidos y su comportamiento están adaptados para la caza, lo que les permite ocupar la posición de depredadores superiores en muchas cadenas tróficas. Estas especies desempeñan un papel fundamental en el equilibrio de los ecosistemas donde habitan. — © SteveAllenPhoto999 (Envato Elements).

Los grandes felinos pertenecen a la familia Felidae, un grupo de mamíferos carnívoros altamente especializados que incluye algunas de las especies depredadoras más eficientes de los ecosistemas terrestres. Entre ellos se encuentran animales emblemáticos como el león (Panthera leo), el leopardo (Panthera pardus), el jaguar (Panthera onca) o el guepardo (Acinonyx jubatus). Aunque presentan diferencias morfológicas y comportamentales, todos comparten adaptaciones evolutivas destinadas a la captura de presas.
Desde el punto de vista anatómico, los felinos poseen cuerpos musculosos y flexibles, garras retráctiles, mandíbulas potentes y dientes especializados para desgarrar carne. Sus sentidos, especialmente la visión nocturna y el oído, están altamente desarrollados, lo que les permite detectar y seguir a sus presas con gran eficacia. En el caso del guepardo, la evolución ha favorecido la velocidad extrema como estrategia de caza, mientras que especies como el leopardo o el jaguar destacan por su fuerza y capacidad de emboscada.
En los ecosistemas naturales, estos animales ocupan generalmente el nivel de depredadores ápice, es decir, el nivel superior de la cadena trófica. Esto significa que rara vez son cazados por otros animales y que su principal función ecológica consiste en regular las poblaciones de herbívoros y otros animales de menor tamaño. Al controlar el número de presas, contribuyen a evitar el sobrepastoreo y a mantener el equilibrio entre las distintas especies del ecosistema.
La presencia de grandes depredadores también influye en el comportamiento de otras especies animales. Muchos herbívoros modifican sus patrones de movimiento, sus horarios de actividad o sus áreas de alimentación para evitar a estos cazadores. Este fenómeno, conocido en ecología como efecto de cascada trófica, demuestra cómo una sola especie depredadora puede afectar indirectamente a la estructura completa de un ecosistema.
Los hábitats de los grandes felinos son muy variados. El león habita principalmente en sabanas africanas, donde caza en grupos organizados. El leopardo se caracteriza por su extraordinaria capacidad de adaptación y puede encontrarse en bosques, montañas o sabanas. El jaguar domina los ecosistemas de selva tropical de América, mientras que el guepardo está especializado en las llanuras abiertas donde puede aprovechar su gran velocidad.
A pesar de su importancia ecológica, muchas especies de grandes felinos se encuentran actualmente amenazadas por la pérdida de hábitat, la caza ilegal y los conflictos con las actividades humanas. La conservación de estos depredadores no solo implica proteger a estas especies emblemáticas, sino también preservar la integridad de los ecosistemas de los que forman parte.
El estudio de estos animales permite comprender mejor cómo funcionan las redes tróficas y cómo la presencia o ausencia de un depredador superior puede alterar profundamente el equilibrio natural de un territorio. Por ello, los grandes felinos no solo representan una de las expresiones más impresionantes de la evolución animal, sino también un elemento clave en la estabilidad ecológica de muchos paisajes naturales del planeta.
4.2. El cuerpo animal: movimiento, sentidos y conducta
Uno de los rasgos más distintivos del reino animal es la extraordinaria complejidad de su organización corporal. A diferencia de otros organismos vivos, los animales han desarrollado estructuras especializadas que les permiten moverse, percibir su entorno y reaccionar ante él. Estas capacidades no solo definen su forma de vida, sino que constituyen la base de muchas de sus estrategias de supervivencia.
El movimiento es una de las características más evidentes de los animales. Aunque existen excepciones —como algunos organismos marinos que permanecen fijos en un sustrato durante gran parte de su vida—, la mayoría de las especies animales poseen sistemas musculares y estructuras de soporte que les permiten desplazarse. Este desplazamiento puede adoptar múltiples formas: caminar, nadar, volar, reptar o saltar. Cada tipo de locomoción responde a adaptaciones específicas al medio en el que vive el animal.
La base biológica del movimiento se encuentra en la interacción entre músculos y estructuras esqueléticas. En muchos animales, como los vertebrados, existe un esqueleto interno que proporciona soporte y permite la inserción de los músculos. En otros grupos, como los artrópodos, el cuerpo está protegido por un exoesqueleto rígido que también actúa como punto de anclaje para los músculos. En ambos casos, el resultado es un sistema mecánico capaz de producir movimientos precisos y coordinados.
El movimiento animal no es simplemente desplazamiento. También está estrechamente relacionado con la búsqueda de alimento, la huida de depredadores, la reproducción o la exploración del entorno. La capacidad de moverse activamente ha permitido a los animales ocupar nichos ecológicos muy variados y desarrollar comportamientos complejos que aumentan sus probabilidades de supervivencia.
Para que el movimiento y la interacción con el entorno sean posibles, los animales han desarrollado órganos sensoriales altamente especializados. Estos órganos permiten detectar cambios en el ambiente y transmitir esa información al sistema nervioso. La vista, el oído, el olfato, el gusto y el tacto constituyen algunos de los sentidos más conocidos, pero el mundo animal presenta una diversidad sensorial mucho mayor.
Muchos animales poseen sentidos adaptados a condiciones ambientales específicas. Algunos peces detectan vibraciones del agua mediante sistemas sensoriales especializados; ciertos insectos perciben señales químicas extremadamente débiles en el aire; algunas aves migratorias parecen orientarse utilizando el campo magnético terrestre. Estas capacidades muestran hasta qué punto la evolución ha perfeccionado los mecanismos sensoriales para adaptarlos a distintos modos de vida.
Toda la información captada por los sentidos es procesada por el sistema nervioso, que coordina las respuestas del organismo. En los animales más simples, este sistema puede consistir en redes nerviosas relativamente básicas. En otros, como los vertebrados, el sistema nervioso alcanza un alto grado de complejidad, con estructuras cerebrales capaces de integrar información, tomar decisiones y regular conductas complejas.
La interacción entre movimiento, percepción sensorial y sistema nervioso da lugar al comportamiento animal. El comportamiento puede definirse como el conjunto de acciones mediante las cuales un animal responde a estímulos internos o externos. Estas conductas incluyen desde respuestas simples —como retirarse ante un estímulo doloroso— hasta comportamientos altamente elaborados, como la construcción de nidos, las migraciones o los rituales de cortejo.
Muchos comportamientos animales tienen un fuerte componente instintivo, es decir, están programados genéticamente y se transmiten de generación en generación. Sin embargo, en numerosas especies también existe una importante capacidad de aprendizaje. Algunos animales pueden modificar su conducta a partir de la experiencia, adaptándose mejor a las condiciones cambiantes de su entorno.
El estudio del comportamiento animal constituye un campo especializado dentro de la zoología conocido como etología. A través de la observación y el análisis de las conductas animales, los científicos pueden comprender cómo los animales se comunican, cómo establecen jerarquías sociales o cómo cooperan entre sí dentro de un grupo.
En conjunto, el cuerpo animal representa una extraordinaria integración de estructura, función y comportamiento. Los sistemas musculares permiten el movimiento, los órganos sensoriales captan información del entorno y el sistema nervioso coordina las respuestas del organismo. Esta compleja interacción ha permitido a los animales convertirse en uno de los grupos de seres vivos más dinámicos y adaptables de la biosfera.
Comprender cómo funcionan estos sistemas no solo nos ayuda a conocer mejor la diversidad animal, sino que también revela los principios biológicos que han guiado la evolución de organismos capaces de moverse, percibir y actuar en un mundo lleno de desafíos y oportunidades
4.2. El cuerpo animal: movimiento, sentidos y conducta
Uno de los rasgos más distintivos del reino animal es la extraordinaria complejidad de su organización corporal. A diferencia de otros organismos vivos, los animales han desarrollado estructuras especializadas que les permiten moverse, percibir su entorno y reaccionar ante él. Estas capacidades no solo definen su forma de vida, sino que constituyen la base de muchas de sus estrategias de supervivencia.
El movimiento es una de las características más evidentes de los animales. Aunque existen excepciones —como algunos organismos marinos que permanecen fijos en un sustrato durante gran parte de su vida—, la mayoría de las especies animales poseen sistemas musculares y estructuras de soporte que les permiten desplazarse. Este desplazamiento puede adoptar múltiples formas: caminar, nadar, volar, reptar o saltar. Cada tipo de locomoción responde a adaptaciones específicas al medio en el que vive el animal.
La base biológica del movimiento se encuentra en la interacción entre músculos y estructuras esqueléticas. En muchos animales, como los vertebrados, existe un esqueleto interno que proporciona soporte y permite la inserción de los músculos. En otros grupos, como los artrópodos, el cuerpo está protegido por un exoesqueleto rígido que también actúa como punto de anclaje para los músculos. En ambos casos, el resultado es un sistema mecánico capaz de producir movimientos precisos y coordinados.
El movimiento animal no es simplemente desplazamiento. También está estrechamente relacionado con la búsqueda de alimento, la huida de depredadores, la reproducción o la exploración del entorno. La capacidad de moverse activamente ha permitido a los animales ocupar nichos ecológicos muy variados y desarrollar comportamientos complejos que aumentan sus probabilidades de supervivencia.
Para que el movimiento y la interacción con el entorno sean posibles, los animales han desarrollado órganos sensoriales altamente especializados. Estos órganos permiten detectar cambios en el ambiente y transmitir esa información al sistema nervioso. La vista, el oído, el olfato, el gusto y el tacto constituyen algunos de los sentidos más conocidos, pero el mundo animal presenta una diversidad sensorial mucho mayor.
Muchos animales poseen sentidos adaptados a condiciones ambientales específicas. Algunos peces detectan vibraciones del agua mediante sistemas sensoriales especializados; ciertos insectos perciben señales químicas extremadamente débiles en el aire; algunas aves migratorias parecen orientarse utilizando el campo magnético terrestre. Estas capacidades muestran hasta qué punto la evolución ha perfeccionado los mecanismos sensoriales para adaptarlos a distintos modos de vida.
Toda la información captada por los sentidos es procesada por el sistema nervioso, que coordina las respuestas del organismo. En los animales más simples, este sistema puede consistir en redes nerviosas relativamente básicas. En otros, como los vertebrados, el sistema nervioso alcanza un alto grado de complejidad, con estructuras cerebrales capaces de integrar información, tomar decisiones y regular conductas complejas.
La interacción entre movimiento, percepción sensorial y sistema nervioso da lugar al comportamiento animal. El comportamiento puede definirse como el conjunto de acciones mediante las cuales un animal responde a estímulos internos o externos. Estas conductas incluyen desde respuestas simples —como retirarse ante un estímulo doloroso— hasta comportamientos altamente elaborados, como la construcción de nidos, las migraciones o los rituales de cortejo.
Muchos comportamientos animales tienen un fuerte componente instintivo, es decir, están programados genéticamente y se transmiten de generación en generación. Sin embargo, en numerosas especies también existe una importante capacidad de aprendizaje. Algunos animales pueden modificar su conducta a partir de la experiencia, adaptándose mejor a las condiciones cambiantes de su entorno.
El estudio del comportamiento animal constituye un campo especializado dentro de la zoología conocido como etología. A través de la observación y el análisis de las conductas animales, los científicos pueden comprender cómo los animales se comunican, cómo establecen jerarquías sociales o cómo cooperan entre sí dentro de un grupo.
En conjunto, el cuerpo animal representa una extraordinaria integración de estructura, función y comportamiento. Los sistemas musculares permiten el movimiento, los órganos sensoriales captan información del entorno y el sistema nervioso coordina las respuestas del organismo. Esta compleja interacción ha permitido a los animales convertirse en uno de los grupos de seres vivos más dinámicos y adaptables de la biosfera.
Comprender cómo funcionan estos sistemas no solo nos ayuda a conocer mejor la diversidad animal, sino que también revela los principios biológicos que han guiado la evolución de organismos capaces de moverse, percibir y actuar en un mundo lleno de desafíos y oportunidades.
4.3. Vertebrados e invertebrados: dos grandes mundos
La enorme diversidad del reino animal obliga a los científicos a organizarla en grandes grupos que permitan comprender sus relaciones evolutivas y sus características biológicas fundamentales. Una de las divisiones más conocidas dentro de la zoología distingue entre vertebrados e invertebrados, dos grandes conjuntos que representan formas muy distintas de organización corporal y estrategias de vida.
Esta clasificación se basa en la presencia o ausencia de una columna vertebral, una estructura ósea que forma parte del esqueleto interno de ciertos animales. Los vertebrados poseen esta estructura, que protege el sistema nervioso central y proporciona soporte al cuerpo. Los invertebrados, en cambio, carecen de columna vertebral, aunque muchos de ellos presentan otras estructuras de soporte igualmente eficaces.
A pesar de su enorme importancia cultural y científica, los vertebrados representan solo una pequeña fracción de la diversidad animal del planeta. La inmensa mayoría de las especies animales pertenecen al grupo de los invertebrados, lo que demuestra que la vida puede adoptar formas muy variadas sin necesidad de una columna vertebral.
Los vertebrados constituyen un grupo relativamente reducido pero muy conocido, ya que incluye a muchos de los animales más visibles para los seres humanos. Entre ellos se encuentran los peces, los anfibios, los reptiles, las aves y los mamíferos. Todos comparten ciertas características estructurales, como la presencia de un esqueleto interno formado por huesos o cartílagos, un sistema nervioso central bien desarrollado y un cuerpo organizado alrededor de una columna vertebral.
Este tipo de estructura corporal proporciona varias ventajas evolutivas. El esqueleto interno permite sostener cuerpos de mayor tamaño y facilita movimientos más complejos. Además, protege órganos vitales y sirve como punto de inserción para los músculos, lo que mejora la capacidad de locomoción. Gracias a estas características, los vertebrados han desarrollado una gran variedad de modos de vida, desde peces adaptados a los océanos hasta aves capaces de recorrer enormes distancias durante sus migraciones.
Los mamíferos, por ejemplo, presentan características muy avanzadas como la presencia de pelo, la producción de leche para alimentar a las crías y un sistema nervioso altamente desarrollado. Las aves han perfeccionado el vuelo mediante esqueletos ligeros y músculos especializados, mientras que los peces dominan los ecosistemas acuáticos con adaptaciones que les permiten nadar con gran eficiencia.
Por otro lado, el mundo de los invertebrados es extraordinariamente amplio y diverso. Incluye numerosos grupos animales que presentan estructuras corporales muy distintas entre sí. Entre los más importantes se encuentran los artrópodos, los moluscos, los equinodermos, los cnidarios y muchos otros.
Los artrópodos constituyen el grupo más numeroso del reino animal. Incluyen insectos, arañas, crustáceos y otros organismos caracterizados por tener un cuerpo segmentado y un exoesqueleto rígido que protege su estructura interna. Este exoesqueleto está formado por quitina y permite una gran variedad de movimientos articulados. La extraordinaria capacidad de adaptación de los artrópodos explica su enorme éxito evolutivo y su presencia en casi todos los ambientes del planeta.
Los moluscos, como caracoles, almejas o pulpos, presentan cuerpos blandos que en muchos casos están protegidos por conchas calcáreas. Algunos de ellos, como los cefalópodos, han desarrollado sistemas nerviosos complejos y comportamientos muy sofisticados.
Los equinodermos, entre los que se encuentran estrellas y erizos de mar, muestran una organización corporal diferente, con simetría radial y sistemas internos adaptados a la vida marina. Otros grupos, como los cnidarios, incluyen organismos como las medusas y los corales, que presentan formas corporales más simples pero desempeñan papeles ecológicos muy importantes en los ecosistemas marinos.
La diferencia entre vertebrados e invertebrados no implica una jerarquía de complejidad o importancia. Ambos grupos han desarrollado soluciones biológicas eficaces para sobrevivir y reproducirse. En muchos ecosistemas, los invertebrados desempeñan funciones esenciales como polinización, descomposición de materia orgánica o control de poblaciones de otros organismos.
Además, la evolución muestra que todos los animales comparten orígenes comunes en la historia de la vida. Vertebrados e invertebrados forman parte de un mismo árbol evolutivo que se ha ramificado a lo largo de cientos de millones de años. Las diferencias actuales reflejan distintos caminos evolutivos que han dado lugar a una extraordinaria variedad de formas de vida.
Comprender esta diversidad permite apreciar la riqueza del reino animal y su papel dentro de los ecosistemas. Desde los grandes vertebrados que dominan determinados hábitats hasta los innumerables invertebrados que sostienen procesos ecológicos fundamentales, ambos mundos forman parte de una red biológica compleja que mantiene el equilibrio de la biosfera.
En definitiva, la distinción entre vertebrados e invertebrados ayuda a ordenar la inmensa diversidad animal, pero también revela una verdad más profunda: la vida ha explorado múltiples formas de organización para adaptarse a la Tierra. Cada una de ellas representa una solución evolutiva a los desafíos de la existencia, contribuyendo al extraordinario mosaico biológico del planeta.
4.4. Evolución animal: adaptación, selección y formas de vida
La extraordinaria diversidad del mundo animal no es el resultado de un proceso aleatorio o caótico, sino de una larga historia evolutiva que se ha desarrollado durante cientos de millones de años. La evolución animal explica cómo, a partir de formas de vida relativamente simples, surgieron organismos cada vez más complejos capaces de ocupar casi todos los ambientes del planeta. Este proceso se basa en tres elementos fundamentales: la variación entre los individuos, la adaptación al entorno y la acción de la selección natural.
En cualquier población de animales existen pequeñas diferencias entre los individuos. Estas variaciones pueden afectar a rasgos físicos, fisiológicos o de comportamiento. Algunas de estas diferencias tienen un origen genético y pueden transmitirse a la descendencia. Cuando ciertas características resultan ventajosas para sobrevivir en un determinado entorno, los individuos que las poseen tienen mayores probabilidades de reproducirse y transmitir esos rasgos a las generaciones siguientes.
Este mecanismo, conocido como selección natural, fue descrito de manera sistemática en el siglo XIX por Charles Darwin y constituye uno de los principios fundamentales de la biología moderna. A lo largo de muchas generaciones, la selección natural puede favorecer ciertas características y eliminar otras, moldeando gradualmente la estructura y el comportamiento de las especies.
Las adaptaciones son precisamente el resultado de este proceso evolutivo. Una adaptación es cualquier característica que mejora la capacidad de un organismo para sobrevivir y reproducirse en su ambiente. Estas adaptaciones pueden adoptar muchas formas: cambios en la estructura del cuerpo, en los sistemas fisiológicos o en el comportamiento.
Por ejemplo, algunos animales han desarrollado cuerpos aerodinámicos y extremidades adaptadas al vuelo, como ocurre en las aves y los murciélagos. Otros poseen aletas que les permiten desplazarse con eficiencia en el agua, como los peces o los cetáceos. En los ambientes desérticos, ciertas especies han evolucionado mecanismos para conservar agua y soportar altas temperaturas, mientras que en regiones frías algunos animales han desarrollado pelajes densos o capas de grasa que les permiten resistir el frío.
La evolución también ha dado lugar a una enorme variedad de formas de vida y estrategias ecológicas. Algunos animales se especializan en la depredación activa, desarrollando sentidos agudos, velocidad y fuerza para capturar a sus presas. Otros adoptan estrategias más discretas, como el camuflaje o el mimetismo, que les permiten pasar desapercibidos ante los depredadores o acercarse a sus presas sin ser detectados.
En muchos casos, las adaptaciones no se limitan a rasgos físicos, sino que incluyen comportamientos complejos. Las migraciones estacionales de aves y peces, las elaboradas estrategias de cortejo de numerosas especies o la organización social de insectos como hormigas y abejas son ejemplos de comportamientos que han evolucionado porque aumentan las probabilidades de supervivencia y reproducción.
La evolución animal también está estrechamente relacionada con la interacción entre especies. En los ecosistemas, los animales no evolucionan de forma aislada, sino en constante relación con otros organismos. Depredadores y presas, parásitos y huéspedes, o animales y plantas que dependen unos de otros para la polinización o la dispersión de semillas influyen mutuamente en su evolución.
Este proceso de adaptación recíproca se conoce como coevolución. Un ejemplo clásico es la relación entre ciertas flores y los insectos que las polinizan. A medida que las plantas desarrollan estructuras que facilitan la polinización por determinados insectos, estos insectos pueden evolucionar características que les permiten aprovechar mejor los recursos de esas plantas. Con el tiempo, ambas especies pueden llegar a depender estrechamente una de la otra.
La evolución animal también se refleja en el registro fósil, que permite reconstruir la historia de la vida a lo largo del tiempo geológico. Los fósiles muestran cómo ciertas formas de vida aparecieron, se diversificaron y, en muchos casos, desaparecieron. Grandes episodios de cambio, como las extinciones masivas, han modificado profundamente la composición del mundo animal, abriendo oportunidades para la aparición de nuevas especies.
Uno de los ejemplos más impresionantes de diversificación evolutiva es la llamada explosión cámbrica, ocurrida hace más de quinientos millones de años. Durante este periodo aparecieron numerosos grupos animales con estructuras corporales complejas, lo que marcó el inicio de una gran expansión de la diversidad biológica.
A lo largo de la historia del planeta, la evolución ha producido una inmensa variedad de formas de vida animal, cada una adaptada a condiciones específicas. Desde organismos microscópicos hasta los grandes vertebrados, todas las especies representan soluciones evolutivas a los desafíos de la supervivencia.
Comprender la evolución animal permite interpretar la diversidad biológica no como un conjunto de especies aisladas, sino como el resultado de un proceso dinámico que continúa desarrollándose en el presente. Las especies actuales son el producto de millones de años de cambios acumulados y siguen evolucionando a medida que cambian las condiciones del planeta.
En este sentido, la evolución constituye el marco fundamental para entender la zoología. Explica por qué los animales presentan la diversidad de formas y comportamientos que observamos hoy y cómo cada especie ocupa un lugar específico dentro de los ecosistemas. A través de la evolución, la vida animal ha explorado innumerables caminos para adaptarse al mundo, generando uno de los espectáculos más extraordinarios de la naturaleza.
4.5. Conducta animal: instinto, aprendizaje e inteligencia
La vida animal no se limita a la estructura del cuerpo o al funcionamiento de los órganos. Una parte esencial de la biología animal es el comportamiento, es decir, el conjunto de acciones mediante las cuales los animales interactúan con su entorno, buscan alimento, evitan peligros, encuentran pareja o cuidan a sus crías. La conducta animal representa la expresión visible de complejos procesos biológicos que combinan la actividad del sistema nervioso, la influencia de los genes y la experiencia adquirida durante la vida.
El estudio científico del comportamiento animal se conoce como etología, una disciplina que analiza cómo y por qué los animales actúan de determinadas maneras. A través de la observación y el análisis comparativo de distintas especies, los etólogos han descubierto que muchas conductas tienen un origen evolutivo y cumplen funciones adaptativas relacionadas con la supervivencia y la reproducción.
Uno de los componentes fundamentales del comportamiento animal es el instinto. Las conductas instintivas son respuestas relativamente automáticas que están programadas en la información genética de la especie. No requieren aprendizaje previo y suelen aparecer de forma natural cuando el animal alcanza un determinado grado de desarrollo.
Ejemplos clásicos de comportamiento instintivo pueden observarse en numerosos animales. Las tortugas marinas recién nacidas se dirigen hacia el océano poco después de salir del huevo, las aves construyen nidos siguiendo patrones específicos de su especie y muchos insectos realizan complejos rituales de apareamiento sin haberlos aprendido previamente. Estas conductas reflejan programas biológicos heredados que han sido moldeados por la selección natural a lo largo de la evolución.
Sin embargo, el comportamiento animal no se reduce al instinto. Muchos animales poseen también una notable capacidad de aprendizaje, es decir, de modificar su conducta a partir de la experiencia. El aprendizaje permite adaptarse a situaciones cambiantes y aprovechar mejor las oportunidades que ofrece el entorno.
El aprendizaje puede adoptar diversas formas. Algunos animales aprenden mediante ensayo y error, ajustando su comportamiento en función de las consecuencias de sus acciones. Otros adquieren información observando a otros individuos, especialmente en especies sociales. Este tipo de aprendizaje social es frecuente en aves, mamíferos y algunos otros grupos animales.
El aprendizaje desempeña un papel particularmente importante en animales con sistemas nerviosos más desarrollados. En estos casos, la experiencia acumulada puede influir profundamente en la conducta futura del individuo, permitiéndole mejorar su eficiencia en tareas como la búsqueda de alimento, la navegación en el territorio o la interacción con otros miembros de su grupo.
A partir de estas capacidades surge una dimensión más compleja del comportamiento: la inteligencia animal. Aunque el concepto de inteligencia puede definirse de distintas maneras, en términos biológicos suele referirse a la capacidad de resolver problemas, adaptarse a nuevas situaciones o utilizar información de manera flexible.
Algunos animales muestran habilidades cognitivas sorprendentes. Ciertos primates utilizan herramientas para obtener alimento, algunos cuervos son capaces de resolver problemas complejos y los delfines demuestran una notable capacidad de aprendizaje y comunicación. Estas conductas sugieren que la inteligencia no es exclusiva del ser humano, sino que puede aparecer en diferentes grados en diversas especies animales.
La inteligencia animal no implica necesariamente pensamiento abstracto en el sentido humano, pero sí revela una gran plasticidad conductual. En muchos casos, estas habilidades permiten a los animales enfrentarse a entornos complejos donde la simple respuesta instintiva no sería suficiente.
La conducta animal también está profundamente influida por la vida social. En muchas especies, los individuos viven en grupos donde se establecen relaciones de cooperación, competencia o jerarquía. Estas estructuras sociales pueden facilitar la defensa frente a depredadores, mejorar la eficiencia en la búsqueda de alimento o aumentar las probabilidades de éxito reproductivo.
Los insectos sociales, como las hormigas o las abejas, presentan algunos de los ejemplos más impresionantes de organización colectiva. En estos casos, el comportamiento de cada individuo contribuye al funcionamiento de toda la colonia. En mamíferos sociales como lobos, elefantes o primates, las interacciones entre individuos pueden ser aún más complejas, incluyendo vínculos familiares, cooperación y aprendizaje social.
El estudio del comportamiento animal revela así que la vida animal está lejos de ser mecánica o simple. Las conductas observadas en la naturaleza son el resultado de una interacción continua entre herencia genética, experiencia individual y condiciones ambientales. Instinto, aprendizaje e inteligencia forman parte de un mismo sistema biológico que permite a los animales responder de manera eficaz a los desafíos del entorno.
Comprender esta dimensión conductual amplía nuestra visión del mundo animal. Los animales no son meros organismos que reaccionan de forma automática; muchos de ellos perciben, aprenden y toman decisiones en función de la información disponible. Esta complejidad comportamental constituye uno de los aspectos más fascinantes de la zoología y revela hasta qué punto la evolución ha producido formas de vida capaces de interactuar activamente con su entorno.
4.6. Reproducción y cuidado de las crías
La reproducción constituye uno de los procesos fundamentales de la vida animal. Gracias a ella, las especies pueden perpetuarse a lo largo del tiempo y transmitir su información genética a las generaciones futuras. Sin embargo, la reproducción en el reino animal no se limita al simple acto de producir descendencia. Implica una gran variedad de estrategias biológicas y comportamentales que han evolucionado para maximizar las probabilidades de supervivencia de las crías.
En términos generales, la reproducción animal puede producirse de dos formas principales: reproducción sexual y, en algunos casos, reproducción asexual. La reproducción sexual es la más común entre los animales y consiste en la unión de células reproductoras masculinas y femeninas, los gametos, que se combinan para formar un nuevo organismo. Este proceso genera descendientes con combinaciones genéticas únicas, lo que favorece la diversidad biológica y aumenta la capacidad de adaptación de las especies frente a cambios ambientales.
En muchas especies animales, la reproducción sexual está acompañada de complejos rituales de cortejo. Estos comportamientos permiten a los individuos reconocer a posibles parejas y evaluar su estado físico o su idoneidad genética. El canto de muchas aves, los coloridos despliegues de plumas, las danzas de ciertos insectos o los combates ritualizados entre machos son ejemplos de estrategias destinadas a atraer pareja y asegurar el éxito reproductivo.
Una vez que se produce la fecundación, el desarrollo de la descendencia puede seguir diferentes caminos. En algunos animales, los huevos se desarrollan fuera del cuerpo de la madre, como ocurre en muchos peces, anfibios, reptiles y aves. Este tipo de reproducción se denomina oviparidad. En otros casos, el embrión se desarrolla dentro del cuerpo materno, recibiendo protección y nutrientes hasta el momento del nacimiento; este proceso se conoce como viviparidad, característico de la mayoría de los mamíferos.
Entre estos dos extremos existen también formas intermedias, como la ovoviviparidad, en la que los huevos se desarrollan dentro del cuerpo de la madre pero el embrión se nutre principalmente de las reservas contenidas en el propio huevo. Estas variaciones muestran cómo la evolución ha generado múltiples soluciones para asegurar el desarrollo de las crías.
Sin embargo, producir descendencia no garantiza su supervivencia. En muchos casos, las crías deben enfrentarse desde el primer momento a un entorno lleno de peligros. Por esta razón, numerosas especies animales han desarrollado formas de cuidado parental, es decir, comportamientos destinados a proteger, alimentar o guiar a las crías durante sus primeras etapas de vida.
El cuidado parental puede adoptar formas muy distintas. Algunas especies, especialmente entre los invertebrados o los peces, producen un gran número de huevos y apenas muestran cuidado posterior. En estos casos, la estrategia consiste en generar muchas crías con la esperanza de que al menos algunas sobrevivan.
En otras especies, en cambio, el número de descendientes es menor pero la inversión parental es mucho mayor. Muchas aves construyen nidos, incuban cuidadosamente sus huevos y alimentan a sus polluelos durante semanas. Entre los mamíferos, el cuidado parental suele ser aún más intenso: las crías nacen relativamente indefensas y dependen de la protección y el alimento proporcionado por sus progenitores.
Los mamíferos presentan uno de los ejemplos más elaborados de cuidado parental. Las crías son alimentadas con leche producida por las glándulas mamarias de la madre, lo que les proporciona nutrientes esenciales durante las primeras etapas de desarrollo. Además, en muchas especies los padres protegen a las crías frente a depredadores, les enseñan habilidades básicas de supervivencia y mantienen vínculos sociales que pueden prolongarse durante largos periodos.
El cuidado de las crías no siempre recae únicamente en la madre. En numerosas especies, ambos progenitores participan en la protección y alimentación de la descendencia. Incluso existen animales donde el cuidado parental se reparte entre varios miembros del grupo, como ocurre en ciertas especies sociales.
Estas estrategias reflejan distintos equilibrios evolutivos entre el número de crías producidas y la inversión en su cuidado. En ambientes donde la mortalidad juvenil es muy alta, puede resultar más eficaz producir grandes cantidades de descendencia. En otros contextos, donde la supervivencia depende de un largo aprendizaje o de una fuerte protección parental, las especies tienden a producir menos crías pero invertir más recursos en cada una.
La reproducción y el cuidado de las crías constituyen, por tanto, una dimensión central de la vida animal. A través de estos procesos, las especies no solo aseguran su continuidad, sino que también transmiten comportamientos, adaptaciones y estrategias de supervivencia que han sido perfeccionadas a lo largo de millones de años de evolución.
Comprender estas dinámicas permite apreciar mejor la complejidad del mundo animal. Detrás de cada nacimiento en la naturaleza existe una larga historia evolutiva de estrategias reproductivas diseñadas para superar los desafíos del entorno. En ese proceso continuo de reproducción y cuidado se manifiesta una de las fuerzas más profundas de la vida: la persistencia de las especies a través del tiempo.
4.7. Depredación, defensa y equilibrio ecológico
En la naturaleza, la vida se desarrolla dentro de una red compleja de relaciones en la que los organismos dependen unos de otros para sobrevivir. Entre estas relaciones, una de las más importantes es la depredación, el proceso mediante el cual un animal captura y consume a otro organismo como fuente de alimento. Aunque a primera vista pueda parecer un fenómeno brutal, la depredación desempeña un papel fundamental en el funcionamiento de los ecosistemas y en el mantenimiento del equilibrio ecológico.
Los animales depredadores han desarrollado a lo largo de la evolución una gran variedad de estrategias para capturar a sus presas. Algunos poseen sentidos extraordinariamente agudos que les permiten detectar movimientos, sonidos o señales químicas a grandes distancias. Otros cuentan con estructuras físicas especializadas, como garras, dientes afilados o venenos, que facilitan la captura y la inmovilización de la presa.
Muchos depredadores utilizan también técnicas de acecho y camuflaje. Permanecen ocultos en el entorno hasta el momento oportuno para lanzar un ataque rápido y preciso. En otros casos, la estrategia consiste en perseguir a la presa durante largas distancias hasta que esta se agota. Cada una de estas tácticas refleja adaptaciones evolutivas específicas relacionadas con el tipo de presa y el ambiente en el que vive el depredador.
Sin embargo, en la naturaleza no solo evolucionan los depredadores. Las presas también desarrollan mecanismos de defensa que aumentan sus probabilidades de escapar. Este proceso de adaptación mutua entre depredadores y presas constituye un ejemplo clásico de coevolución, donde los cambios en una especie ejercen presión evolutiva sobre la otra.
Las estrategias defensivas adoptan muchas formas. Algunas especies utilizan el camuflaje, adoptando colores o formas que les permiten confundirse con el entorno. Insectos que imitan hojas o ramas, peces que se mezclan con los colores del fondo marino o animales con patrones de coloración que rompen la silueta del cuerpo son ejemplos de esta adaptación.
Otras especies recurren a defensas físicas, como caparazones, espinas o estructuras corporales resistentes que dificultan el ataque del depredador. Los erizos de mar, los armadillos o ciertas especies de peces espinosos muestran cómo la evolución ha desarrollado auténticos sistemas de protección.
También existen defensas químicas, en las que los animales producen sustancias tóxicas o desagradables para disuadir a posibles depredadores. Algunas ranas tropicales, ciertos insectos o incluso algunos peces contienen compuestos venenosos que los hacen peligrosos o poco apetecibles. En ocasiones, estas especies exhiben colores brillantes que advierten de su toxicidad, un fenómeno conocido como coloración de advertencia.
Además de estas adaptaciones físicas y químicas, muchos animales utilizan estrategias de comportamiento para evitar ser capturados. Algunas especies viven en grupos, lo que reduce la probabilidad de que un individuo sea atacado. Otras desarrollan sistemas de vigilancia colectiva en los que algunos miembros del grupo alertan a los demás cuando detectan peligro.
La relación entre depredadores y presas no solo afecta a las especies implicadas directamente. Tiene también consecuencias importantes para la estructura de los ecosistemas. Los depredadores suelen regular las poblaciones de herbívoros, evitando que estas crezcan de forma excesiva y agoten los recursos vegetales. De este modo, contribuyen indirectamente a mantener el equilibrio entre plantas y animales dentro de un ecosistema.
Cuando desaparecen los grandes depredadores de un sistema natural, pueden producirse desequilibrios ecológicos significativos. Las poblaciones de herbívoros pueden aumentar sin control, lo que provoca una sobreexplotación de la vegetación y altera profundamente el paisaje y la biodiversidad. Por esta razón, los depredadores desempeñan un papel esencial como reguladores naturales de los ecosistemas.
La depredación también impulsa la evolución de nuevas adaptaciones. A lo largo del tiempo, la presión ejercida por los depredadores ha favorecido la aparición de mecanismos defensivos cada vez más eficaces, mientras que los depredadores han desarrollado estrategias más sofisticadas para superar esas defensas. Este proceso continuo ha contribuido a la extraordinaria diversidad de formas y comportamientos que observamos en el reino animal.
Desde una perspectiva ecológica, la depredación no debe interpretarse únicamente como un conflicto entre especies, sino como parte de un sistema dinámico que mantiene la estabilidad de los ecosistemas. La vida en la naturaleza está basada en la transferencia de energía entre organismos, y la depredación constituye uno de los mecanismos fundamentales mediante los cuales esa energía circula dentro de las redes alimentarias.
Comprender estas relaciones permite apreciar que la naturaleza funciona como un sistema interconectado donde cada especie desempeña un papel. Depredadores y presas forman parte de un equilibrio complejo que ha sido moldeado por millones de años de evolución. En ese equilibrio, incluso los procesos aparentemente más duros cumplen una función esencial en la continuidad y diversidad de la vida.
4.8. Migraciones: la vida en movimiento
Uno de los fenómenos más impresionantes del mundo animal es la migración. Cada año, millones de animales recorren grandes distancias a través de continentes, océanos y cielos siguiendo rutas que, en muchos casos, han sido utilizadas durante generaciones. Estas migraciones representan una de las estrategias más complejas que la evolución ha desarrollado para afrontar los cambios estacionales del entorno y asegurar la supervivencia de las especies.
La migración animal puede definirse como un desplazamiento periódico y generalmente predecible que realizan ciertos animales entre diferentes regiones geográficas. Estos movimientos suelen estar relacionados con la búsqueda de alimento, la reproducción o la necesidad de evitar condiciones ambientales adversas como el frío, la sequía o la escasez de recursos.
Las migraciones no son simples desplazamientos aleatorios. Se trata de movimientos organizados que siguen rutas específicas y que, en muchas especies, están sincronizados con cambios estacionales del clima o de la disponibilidad de alimentos. Gracias a estas migraciones, los animales pueden aprovechar recursos que solo están disponibles durante determinados momentos del año.
Uno de los ejemplos más conocidos es el de las aves migratorias. Muchas especies de aves que habitan en regiones templadas o frías durante el verano se desplazan hacia zonas más cálidas cuando llega el invierno. En estos viajes pueden recorrer miles de kilómetros, atravesando mares, desiertos o cordilleras. Algunas aves, como ciertas especies de golondrinas o charranes, realizan migraciones intercontinentales que se encuentran entre los viajes más largos del reino animal.
Las aves migratorias poseen adaptaciones extraordinarias que les permiten realizar estos trayectos. Sus cuerpos están diseñados para el vuelo eficiente, y muchas especies almacenan grandes reservas de grasa antes de iniciar el viaje. Además, poseen notables capacidades de orientación que les permiten seguir rutas precisas incluso cuando atraviesan regiones desconocidas.
Pero las migraciones no son exclusivas de las aves. Numerosas especies de peces también realizan desplazamientos de gran escala. Algunos peces migran entre aguas dulces y saladas para reproducirse. Un ejemplo clásico es el del salmón, que nace en ríos de agua dulce, pasa gran parte de su vida en el océano y regresa posteriormente al río donde nació para reproducirse.
En los océanos, grandes mamíferos marinos como las ballenas también realizan migraciones estacionales. Muchas especies se desplazan desde zonas frías ricas en alimento hacia aguas más cálidas donde se reproducen y dan a luz a sus crías. Estos viajes pueden cubrir miles de kilómetros y siguen rutas que parecen estar profundamente arraigadas en la biología de la especie.
Las migraciones también son comunes entre algunos mamíferos terrestres. En ciertas regiones de África, por ejemplo, grandes manadas de herbívoros como ñus y cebras recorren extensas llanuras en busca de pastos frescos y agua. Estos movimientos colectivos transforman temporalmente los ecosistemas y atraen a numerosos depredadores que dependen de estas migraciones para obtener alimento.
Uno de los aspectos más fascinantes de la migración animal es la capacidad de orientación que muestran muchas especies. Los científicos han descubierto que algunos animales utilizan diversas señales para navegar durante sus viajes. Estas pueden incluir la posición del Sol, las estrellas, el campo magnético de la Tierra o incluso referencias geográficas como ríos y montañas.
En muchos casos, la migración combina instinto y aprendizaje. Los animales jóvenes pueden iniciar el viaje guiados por programas biológicos heredados, mientras que la experiencia acumulada en migraciones anteriores mejora su capacidad para orientarse y elegir rutas más eficientes.
Desde el punto de vista ecológico, las migraciones desempeñan un papel importante en el funcionamiento de los ecosistemas. Al desplazarse entre distintas regiones, los animales contribuyen a transferir energía y nutrientes de un lugar a otro. Además, pueden influir en la dispersión de semillas, en la dinámica de las poblaciones y en las interacciones entre especies.
Sin embargo, las migraciones también se encuentran hoy amenazadas por diversos factores asociados a la actividad humana. La fragmentación de hábitats, la construcción de infraestructuras, la contaminación y el cambio climático pueden alterar las rutas migratorias tradicionales o dificultar el acceso a las áreas necesarias para completar el ciclo vital de muchas especies.
Comprender el fenómeno de las migraciones permite apreciar hasta qué punto la vida animal está conectada con los ritmos del planeta. Las migraciones reflejan la capacidad de los organismos para responder a los cambios del entorno mediante movimientos coordinados que pueden abarcar enormes distancias.
En cierto sentido, la migración representa una de las expresiones más dinámicas de la vida en la Tierra. Millones de animales se desplazan cada año siguiendo rutas invisibles que conectan distintos ecosistemas. Estos viajes muestran cómo la vida, lejos de permanecer estática, se encuentra en constante movimiento, adaptándose a los ciclos naturales del planeta.
Bandada de gansos o ánsares (Anser sp.) volando en formación durante una migración estacional. Estas aves recorren miles de kilómetros cada año entre sus áreas de reproducción y sus zonas de invernada. Muchas especies de aves realizan migraciones estacionales que pueden abarcar miles de kilómetros. Estos desplazamientos permiten aprovechar los cambios climáticos del planeta, buscando regiones donde haya más alimento, temperaturas más favorables y mejores condiciones para la reproducción. — © GreensandBlues (Envato Elements).

La migración es uno de los fenómenos más extraordinarios del comportamiento animal. Cada año, millones de aves recorren enormes distancias entre sus áreas de reproducción y sus zonas de invernada, siguiendo rutas que en muchos casos se han mantenido durante miles de años. Estas migraciones permiten a las aves aprovechar los recursos estacionales del planeta, desplazándose hacia regiones donde el clima y la disponibilidad de alimento resultan más favorables.
En el caso de los gansos y otras aves acuáticas migratorias, estos desplazamientos pueden alcanzar varios miles de kilómetros. Muchas poblaciones que se reproducen en las regiones septentrionales de Europa y Asia migran hacia latitudes más templadas durante el invierno, donde encuentran agua abierta, vegetación abundante y condiciones menos extremas. Cuando llega la primavera, emprenden el viaje de regreso hacia el norte para reproducirse en zonas donde los días más largos y la abundancia de alimento favorecen el desarrollo de las crías.
Uno de los aspectos más fascinantes de la migración es la capacidad de orientación de las aves. Diversos estudios han demostrado que las aves utilizan múltiples mecanismos para orientarse durante sus viajes. Entre ellos se encuentran la posición del sol, el patrón de las estrellas, referencias geográficas del paisaje y, de manera especialmente notable, la percepción del campo magnético terrestre. Algunas especies poseen células sensoriales especializadas que les permiten detectar este campo magnético, actuando como una especie de brújula biológica.
La formación en “V”, característica de muchas bandadas de gansos, también tiene una función importante desde el punto de vista energético. Al volar en esta disposición, cada ave aprovecha las corrientes de aire generadas por las alas de la que va delante, lo que reduce la resistencia del aire y disminuye el esfuerzo necesario para mantener el vuelo. Además, las aves suelen turnarse en la posición de liderazgo, permitiendo que los individuos se alternen en la tarea más exigente del desplazamiento.
Este comportamiento migratorio implica una notable coordinación fisiológica y conductual. Antes de iniciar el viaje, muchas aves acumulan grandes reservas de grasa que servirán como combustible durante el trayecto. Durante la migración realizan escalas en determinadas zonas húmedas o áreas de alimentación donde recuperan energía antes de continuar el viaje.
Las migraciones de aves constituyen así un ejemplo extraordinario de adaptación evolutiva al ritmo cambiante del planeta. Estos desplazamientos conectan ecosistemas muy distantes entre sí y desempeñan un papel importante en la dinámica ecológica global, transportando nutrientes, dispersando semillas y formando parte de complejas redes tróficas que atraviesan continentes enteros.
El estudio de las migraciones sigue siendo un campo activo de investigación científica. A pesar de los avances en seguimiento por satélite y en biología del comportamiento, muchos aspectos de este fenómeno continúan despertando fascinación y preguntas. La capacidad de estos animales para orientarse y recorrer enormes distancias con precisión sigue siendo una de las manifestaciones más sorprendentes de la inteligencia y adaptación del mundo animal.
4.9. Animales sociales: cooperación y jerarquía
Aunque muchos animales viven de manera solitaria, numerosas especies han desarrollado formas de vida basadas en la organización social. En estos casos, los individuos no actúan de manera aislada, sino que forman grupos estables dentro de los cuales se establecen relaciones de cooperación, competencia y jerarquía. Estas estructuras sociales representan una de las estrategias evolutivas más importantes para aumentar las probabilidades de supervivencia y reproducción.
La vida en grupo puede ofrecer diversas ventajas. Los animales sociales pueden defenderse mejor frente a depredadores, localizar alimento con mayor eficacia o cuidar colectivamente de las crías. Además, la interacción entre individuos facilita el aprendizaje social, permitiendo que los miembros jóvenes del grupo adquieran comportamientos esenciales para sobrevivir en su entorno.
Uno de los ejemplos más conocidos de organización social se encuentra en los insectos sociales, como hormigas, abejas y termitas. En estas especies, las colonias pueden llegar a contener miles o incluso millones de individuos que cooperan estrechamente entre sí. Cada miembro de la colonia desempeña funciones específicas: algunas se encargan de la reproducción, otras de la búsqueda de alimento, otras de la defensa o del cuidado de las larvas.
Esta división del trabajo convierte a la colonia en una especie de superorganismo, donde el éxito del grupo depende de la cooperación de todos sus miembros. La coordinación de las actividades se logra mediante complejos sistemas de comunicación química y conductual, que permiten transmitir información sobre la localización de alimentos o sobre posibles amenazas.
En el caso de muchos mamíferos sociales, la organización del grupo suele basarse en relaciones de parentesco y en la formación de jerarquías. Animales como lobos, leones, elefantes o primates viven en grupos donde algunos individuos ocupan posiciones dominantes y otros adoptan roles subordinados. Estas jerarquías ayudan a reducir los conflictos dentro del grupo y a organizar el acceso a recursos como alimento o parejas reproductivas.
Las manadas de lobos, por ejemplo, muestran una estructura social bien definida. En ellas suele existir una pareja reproductora dominante, mientras que otros miembros del grupo colaboran en la caza y en el cuidado de las crías. Esta cooperación aumenta las posibilidades de éxito en la captura de presas grandes y contribuye a la supervivencia del grupo.
Entre los primates, las relaciones sociales pueden ser aún más complejas. Muchas especies establecen vínculos duraderos entre individuos, utilizan sistemas de comunicación variados y desarrollan comportamientos cooperativos como el cuidado mutuo o la defensa colectiva del territorio. En estos grupos, la posición jerárquica puede influir en el acceso a recursos y en las oportunidades reproductivas.
La vida social también implica mecanismos de comunicación que permiten coordinar las actividades del grupo. Los animales utilizan una amplia gama de señales para transmitir información: sonidos, gestos, posturas corporales, colores o sustancias químicas. Estas señales pueden advertir de la presencia de depredadores, indicar la disponibilidad de alimento o reforzar los vínculos entre miembros del grupo.
La cooperación entre animales no siempre implica igualdad entre los individuos. En muchos grupos sociales se establecen jerarquías de dominancia, donde algunos animales tienen prioridad sobre otros en determinadas situaciones. Estas jerarquías pueden basarse en la fuerza física, en la edad, en la experiencia o en la habilidad para formar alianzas dentro del grupo.
Aunque las jerarquías pueden generar conflictos, también cumplen una función importante al reducir la violencia abierta dentro del grupo. Una vez establecida la posición de cada individuo, las interacciones suelen seguir reglas relativamente estables que evitan enfrentamientos constantes.
Desde una perspectiva evolutiva, la vida social ha surgido porque en determinadas condiciones la cooperación puede resultar más ventajosa que la competencia individual. Al actuar juntos, los animales pueden realizar tareas que serían imposibles o mucho más difíciles para un individuo aislado. Este principio explica por qué muchas especies han desarrollado sistemas sociales complejos a lo largo de la evolución.
El estudio de los animales sociales permite comprender mejor cómo surgen las estructuras de cooperación y cómo se organizan las relaciones dentro de los grupos. Estas investigaciones también ofrecen pistas valiosas sobre el origen evolutivo de algunos comportamientos humanos, ya que nuestra propia especie forma parte de una larga historia de evolución social.
En definitiva, la vida social muestra que el mundo animal no está compuesto únicamente por individuos aislados que compiten entre sí. En muchos casos, la supervivencia depende de la capacidad de colaborar, comunicarse y organizarse colectivamente. A través de la cooperación y la jerarquía, numerosos animales han construido sistemas sociales complejos que reflejan una de las dimensiones más fascinantes de la evolución biológica.
4.10. El ser humano como animal: continuidad y diferencia
Desde el punto de vista de la biología, el ser humano pertenece plenamente al reino animal. Nuestra especie, Homo sapiens, forma parte del grupo de los mamíferos y comparte con otros primates un origen evolutivo común. Anatomía, fisiología y genética muestran con claridad esta continuidad: poseemos un cuerpo organizado según los mismos principios biológicos que otros vertebrados, respiramos, nos alimentamos, nos reproducimos y estamos sujetos a las mismas leyes de la vida que el resto de los animales.
Sin embargo, al mismo tiempo que formamos parte del mundo animal, el ser humano presenta características que lo distinguen profundamente de las demás especies. Comprender esta doble dimensión —la continuidad biológica y la singularidad cultural— es esencial para situar correctamente a nuestra especie dentro de la historia de la vida.
Desde el punto de vista anatómico, los humanos compartimos numerosas características con otros mamíferos y, en particular, con los primates. Poseemos un esqueleto interno, un sistema nervioso altamente desarrollado, manos con pulgar oponible y una estructura corporal que refleja nuestra historia evolutiva. Estudios genéticos muestran que compartimos una gran parte de nuestro material genético con otros primates, especialmente con chimpancés y gorilas, lo que confirma nuestro parentesco evolutivo.
La evolución humana se desarrolló a lo largo de millones de años a partir de antepasados primates que habitaban en África. Durante este proceso aparecieron cambios importantes en la anatomía y el comportamiento. Uno de los más significativos fue la bipedestación, es decir, la capacidad de caminar de forma habitual sobre dos extremidades. Este cambio liberó las manos para manipular objetos y favoreció el desarrollo de habilidades técnicas.
Otro rasgo fundamental fue el aumento del tamaño y la complejidad del cerebro. El cerebro humano es especialmente grande en relación con el tamaño del cuerpo, y ciertas regiones relacionadas con el lenguaje, la memoria y el pensamiento abstracto alcanzan un desarrollo notable. Este crecimiento cerebral permitió la aparición de capacidades cognitivas que ampliaron enormemente las posibilidades de interacción con el entorno.
Estas capacidades cognitivas dieron lugar a una característica central de nuestra especie: la cultura. A diferencia de otros animales, los seres humanos no dependen exclusivamente de comportamientos instintivos o de aprendizajes individuales. Nuestra especie ha desarrollado sistemas complejos de transmisión cultural mediante el lenguaje, la enseñanza y la acumulación de conocimientos a lo largo de generaciones.
Gracias a la cultura, los seres humanos han podido crear herramientas cada vez más sofisticadas, desarrollar sistemas sociales complejos y transformar profundamente el entorno natural. La tecnología, el arte, la ciencia y las instituciones sociales forman parte de esta dimensión cultural que distingue a nuestra especie dentro del mundo animal.
El lenguaje articulado desempeña un papel clave en esta singularidad humana. Aunque muchos animales poseen formas de comunicación, el lenguaje humano permite expresar ideas abstractas, transmitir conocimientos complejos y construir sistemas simbólicos elaborados. Esta capacidad ha facilitado la cooperación a gran escala y la organización de sociedades complejas.
Otro rasgo distintivo del ser humano es su capacidad de reflexión consciente. Los seres humanos no solo perciben el mundo que los rodea, sino que también pueden pensar sobre sí mismos, sobre su historia y sobre su lugar en el universo. Esta autoconciencia ha dado origen a la filosofía, la religión, la ciencia y numerosas formas de expresión cultural.
Sin embargo, reconocer estas diferencias no implica negar nuestra pertenencia al mundo natural. Los seres humanos siguen dependiendo de los mismos procesos biológicos que sostienen la vida en todos los organismos. Necesitamos alimento, agua y oxígeno, y nuestra supervivencia está ligada al equilibrio de los ecosistemas de los que formamos parte.
De hecho, la capacidad humana para transformar el entorno ha generado desafíos ecológicos que afectan a todo el planeta. La expansión de la actividad humana ha modificado ecosistemas, alterado ciclos naturales y provocado la desaparición de numerosas especies. Esta situación subraya la responsabilidad particular que nuestra especie tiene como parte del sistema natural.
Desde una perspectiva científica, el ser humano puede entenderse como una especie animal dotada de capacidades culturales excepcionales. Nuestra biología nos vincula al resto de los seres vivos, mientras que nuestra cultura nos permite actuar de maneras que trascienden las limitaciones de otros animales.
Esta doble condición —animal y cultural— constituye una de las claves para comprender la naturaleza humana. Somos el resultado de una larga historia evolutiva que compartimos con todas las formas de vida del planeta, pero también somos la única especie capaz de reflexionar conscientemente sobre esa historia.
Comprender al ser humano como parte del reino animal no disminuye su singularidad; al contrario, la sitúa dentro del marco más amplio de la evolución biológica. Reconocer esta continuidad nos recuerda que nuestra existencia está profundamente ligada a la vida que nos rodea y que nuestra historia forma parte de la gran historia de la naturaleza.
4.11. Amenazas actuales: extinción, pérdida de hábitats y conservación
La diversidad animal que hoy observamos en la Tierra es el resultado de cientos de millones de años de evolución. A lo largo de este vasto periodo, innumerables especies han surgido, se han transformado y, en muchos casos, han desaparecido. La extinción forma parte del proceso natural de la evolución. Sin embargo, en el presente se observa un fenómeno preocupante: la velocidad a la que están desapareciendo muchas especies es muy superior a la que cabría esperar en condiciones naturales.
Numerosos científicos consideran que el planeta atraviesa actualmente una crisis de biodiversidad que podría compararse con algunas de las grandes extinciones masivas del pasado geológico. La diferencia fundamental es que, en esta ocasión, el principal agente de cambio no es una catástrofe natural, sino la propia actividad humana.
Uno de los factores más importantes en esta crisis es la pérdida de hábitats naturales. A medida que las sociedades humanas se expanden y transforman el territorio, grandes extensiones de ecosistemas naturales se convierten en zonas agrícolas, áreas urbanas o infraestructuras de transporte. Bosques, humedales, praderas y selvas desaparecen o se fragmentan, lo que dificulta la supervivencia de muchas especies que dependen de estos entornos para alimentarse, reproducirse y refugiarse.
La deforestación de las regiones tropicales constituye uno de los ejemplos más visibles de este proceso. Las selvas tropicales albergan una enorme diversidad de especies animales y vegetales, muchas de las cuales aún no han sido completamente estudiadas. Cuando estos ecosistemas son destruidos o degradados, numerosas especies pierden el entorno que necesitan para vivir.
Otro factor que amenaza la biodiversidad es la sobreexplotación de los recursos naturales. La caza excesiva, la pesca intensiva y el comercio ilegal de especies silvestres han reducido gravemente las poblaciones de muchos animales. Algunas especies han sido llevadas al borde de la extinción debido a la presión directa ejercida por las actividades humanas.
La contaminación ambiental también afecta de manera significativa a numerosas especies. Sustancias químicas, plásticos y otros residuos alteran los ecosistemas terrestres y marinos, afectando a la salud de los organismos y perturbando las cadenas tróficas. En los océanos, por ejemplo, la acumulación de plásticos y contaminantes químicos representa una amenaza creciente para muchas especies marinas.
El cambio climático añade una presión adicional sobre los ecosistemas. El aumento de las temperaturas, las alteraciones en los patrones de lluvia y el deshielo de regiones polares están modificando los hábitats de numerosas especies. Algunos animales pueden adaptarse o desplazarse hacia nuevas áreas, pero otros no tienen la capacidad de hacerlo con suficiente rapidez.
Frente a estas amenazas, la ciencia y la sociedad han desarrollado diversas estrategias de conservación de la biodiversidad. Una de las más importantes consiste en la creación de áreas protegidas, como parques nacionales y reservas naturales, donde los ecosistemas pueden mantenerse relativamente intactos y las especies pueden desarrollarse sin la presión directa de la actividad humana.
Además de proteger espacios naturales, la conservación también implica gestionar de forma responsable los recursos biológicos. Esto incluye regular la pesca, controlar la caza, limitar el comercio ilegal de especies y promover prácticas agrícolas y forestales sostenibles.
La investigación científica desempeña un papel fundamental en estos esfuerzos. Los biólogos y ecólogos estudian las poblaciones animales, analizan los cambios en los ecosistemas y desarrollan estrategias para proteger especies en peligro. Programas de reproducción en cautividad, restauración de hábitats y reintroducción de especies son algunas de las herramientas utilizadas para recuperar poblaciones amenazadas.
Sin embargo, la conservación no depende únicamente de la ciencia. También requiere decisiones sociales, políticas y económicas que reconozcan el valor de la biodiversidad. Los ecosistemas naturales no solo albergan especies animales y vegetales; también proporcionan servicios esenciales para la humanidad, como la regulación del clima, la fertilidad del suelo, la purificación del agua o la polinización de cultivos.
La desaparición de especies no representa únicamente una pérdida biológica, sino también una pérdida cultural y científica. Cada especie encierra una historia evolutiva única y constituye una pieza dentro del complejo sistema de la vida en la Tierra.
Comprender las amenazas que enfrentan los animales hoy en día es un paso esencial para valorar la importancia de la conservación. La diversidad biológica no es simplemente un patrimonio del pasado, sino una condición necesaria para el equilibrio de los ecosistemas y para el futuro de la propia humanidad.
En última instancia, la conservación de la vida animal plantea una cuestión que va más allá de la biología: cómo debe relacionarse la civilización humana con el resto de la naturaleza. Reconocer nuestra responsabilidad dentro de este sistema puede convertirse en uno de los desafíos más importantes del siglo XXI.
5. Alcance y límites de las ciencias naturales.
5.1. Qué pueden explicar: el “cómo” de la naturaleza.
5.2. Qué no pueden explicar: valores, sentido y finalidad.
5.3. El peligro del cientificismo: cuando la ciencia se convierte en ideología.
5.4. Ciencia y filosofía: dos miradas necesarias.
5.5. Ciencia y religión: conflicto, diálogo y malentendidos.
5.6. Por qué las humanidades siguen siendo imprescindibles.
5.7. El ser humano como puente: naturaleza y conciencia.

Los límites del conocimiento científico: entre la investigación empírica de la naturaleza y las grandes preguntas que trascienden el método experimental.
Las ciencias naturales permiten comprender con gran precisión numerosos aspectos del mundo físico y biológico mediante la observación, la experimentación y el análisis racional. Sin embargo, el propio método científico establece también sus límites: la ciencia explica cómo funcionan los fenómenos naturales, pero no siempre puede responder a preguntas sobre el sentido último de la realidad, el origen absoluto del universo o el significado de la existencia humana. Reconocer tanto el alcance como los límites de la ciencia forma parte de una comprensión madura del conocimiento.
5. Alcance y límites de las ciencias naturales.
Las ciencias naturales constituyen uno de los logros intelectuales más importantes de la humanidad. A través de la observación, la experimentación y el análisis racional, han permitido descubrir las leyes que gobiernan el mundo físico y biológico. Gracias a este método de investigación, el ser humano ha logrado comprender fenómenos que durante siglos permanecieron envueltos en el misterio: la estructura de la materia, el movimiento de los planetas, la evolución de los seres vivos o el funcionamiento del cuerpo humano.
El método científico ha demostrado una enorme capacidad para explicar los procesos naturales. Al estudiar los fenómenos mediante hipótesis verificables, experimentos y modelos teóricos, la ciencia puede describir con gran precisión cómo funciona la naturaleza. Este enfoque ha permitido construir teorías sólidas que explican desde el comportamiento de las partículas subatómicas hasta la dinámica de los ecosistemas y la historia evolutiva de la vida.
Sin embargo, la propia fuerza del método científico reside también en sus límites. Las ciencias naturales están diseñadas para estudiar fenómenos observables y medibles dentro del mundo físico. Su campo de acción se centra en aquello que puede analizarse mediante datos, experimentos y modelos matemáticos. Esta delimitación metodológica permite alcanzar un alto grado de precisión, pero también implica que ciertas preguntas quedan fuera de su alcance.
Existen cuestiones que pertenecen a otros ámbitos del pensamiento humano. Preguntas relacionadas con el sentido de la existencia, los valores morales, la finalidad de la vida o la naturaleza de la conciencia no pueden resolverse únicamente mediante experimentos o ecuaciones. Estas cuestiones han sido tradicionalmente abordadas por la filosofía, la ética, la religión o las humanidades en general.
Reconocer esta distinción no disminuye la importancia de la ciencia; al contrario, permite comprender mejor su naturaleza. La ciencia no pretende ofrecer respuestas a todas las preguntas posibles, sino explicar con rigor aquellos aspectos de la realidad que pueden investigarse mediante su método. Confundir este ámbito específico con una explicación total de la realidad conduce a una interpretación excesiva del papel de la ciencia.
En algunos momentos de la historia moderna ha surgido la tendencia a considerar que solo el conocimiento científico es válido, una postura conocida como cientificismo. Esta visión transforma la ciencia, que es un método de investigación, en una especie de ideología que pretende explicar todos los aspectos de la realidad exclusivamente desde el punto de vista científico. Sin embargo, muchos pensadores han señalado que esta posición ignora dimensiones fundamentales de la experiencia humana que no pueden reducirse únicamente a datos empíricos.
La comprensión completa de la realidad requiere, por tanto, una pluralidad de perspectivas. La ciencia proporciona conocimientos objetivos sobre la naturaleza, pero la filosofía reflexiona sobre el significado de esos conocimientos, la ética examina sus implicaciones morales y las humanidades exploran las dimensiones culturales y simbólicas de la experiencia humana.
A lo largo de la historia, la relación entre ciencia, filosofía y religión ha sido compleja. En ocasiones ha existido conflicto, especialmente cuando determinadas interpretaciones religiosas chocaban con descubrimientos científicos. En otros momentos ha habido diálogo y colaboración, ya que muchas de las preguntas fundamentales sobre el origen del universo, la naturaleza de la vida o el lugar del ser humano en el cosmos han interesado tanto a científicos como a filósofos y teólogos.
En este contexto, las humanidades siguen desempeñando un papel esencial. La historia, la filosofía, la literatura o el arte ayudan a interpretar el conocimiento científico dentro de un marco cultural más amplio. Estas disciplinas permiten reflexionar sobre el significado de los descubrimientos científicos, sus implicaciones éticas y su impacto en la sociedad.
El propio ser humano se encuentra en una posición singular dentro de esta relación entre ciencia y cultura. Como organismo biológico, formamos parte de la naturaleza y podemos ser estudiados por las ciencias naturales. Pero al mismo tiempo poseemos conciencia, lenguaje, pensamiento simbólico y capacidad de reflexión, lo que nos sitúa también dentro del ámbito de la filosofía y las humanidades.
De este modo, el estudio del alcance y los límites de las ciencias naturales no busca disminuir el valor del conocimiento científico, sino situarlo dentro de un marco intelectual más amplio. Comprender qué puede explicar la ciencia y qué preguntas pertenecen a otros ámbitos del pensamiento permite evitar confusiones y enriquecer nuestra comprensión del mundo.
Las ciencias naturales constituyen una herramienta poderosa para explorar la realidad física y biológica. Pero la comprensión completa de la existencia humana requiere integrar este conocimiento con otras formas de reflexión. En esa convergencia entre ciencia, filosofía y cultura se encuentra una de las claves para entender no solo el mundo que habitamos, sino también el lugar que ocupamos dentro de él.
5.1. Qué pueden explicar: el “cómo” de la naturaleza
Las ciencias naturales nacen del deseo profundamente humano de comprender el mundo que nos rodea. Desde los primeros observadores del cielo nocturno hasta los científicos modernos que estudian las partículas más diminutas o las galaxias más lejanas, el impulso fundamental ha sido siempre el mismo: descubrir cómo funciona la naturaleza. La ciencia no se conforma con contemplar el mundo; intenta desentrañar los mecanismos que lo hacen posible.
Cuando hablamos de lo que la ciencia puede explicar, hablamos ante todo del “cómo” de los fenómenos naturales. La ciencia busca identificar causas, relaciones y procesos. Observa, compara, formula hipótesis y construye teorías que permitan comprender por qué ocurren ciertas cosas y de qué manera se desarrollan. No se trata de una curiosidad superficial, sino de un esfuerzo sistemático por descubrir las regularidades que rigen el comportamiento del universo.
Por ejemplo, la física intenta explicar cómo se mueven los cuerpos, cómo actúan las fuerzas o cómo se transmite la energía. Gracias a ella sabemos por qué los planetas orbitan alrededor del Sol, cómo cae un objeto cuando lo soltamos o cómo se comporta la luz al atravesar distintos materiales. Estas explicaciones no se limitan a describir lo que ocurre; buscan identificar las leyes que gobiernan esos fenómenos.
La biología, por su parte, se ocupa del funcionamiento de los seres vivos. Trata de comprender cómo se organizan las células, cómo se transmite la información genética de una generación a otra, cómo los organismos obtienen energía o cómo las especies cambian a lo largo del tiempo. En este ámbito, la ciencia ha logrado explicar procesos extraordinariamente complejos, como la replicación del ADN o los mecanismos de la evolución.
Algo similar ocurre con la química, que estudia cómo se combinan los elementos para formar sustancias nuevas y cómo se transforman unas en otras. Las reacciones químicas que tienen lugar en un laboratorio no son distintas, en esencia, de las que ocurren en nuestro propio cuerpo o en la atmósfera terrestre. Comprender esos procesos permite explicar desde la combustión de un combustible hasta la digestión de los alimentos.
En todos estos casos, el objetivo es siempre el mismo: descubrir los mecanismos internos de los fenómenos naturales. La ciencia no se contenta con afirmar que algo ocurre; intenta comprender qué fuerzas, qué estructuras y qué procesos lo hacen posible. De ahí que la observación rigurosa, la experimentación y el análisis sean herramientas fundamentales en el trabajo científico.
Una de las grandes virtudes de este enfoque es que permite construir explicaciones verificables. Cuando una teoría científica describe cómo ocurre un fenómeno, esa explicación debe poder contrastarse con la experiencia. Los científicos formulan predicciones, realizan experimentos y comprueban si los resultados coinciden con lo esperado. Si las observaciones confirman la teoría, esta se refuerza; si no, debe ser revisada o incluso abandonada.
Este carácter crítico y autocorrectivo es uno de los rasgos más poderosos de la ciencia. A lo largo de la historia, muchas teorías han sido modificadas o sustituidas por otras más completas. Lo que ayer parecía una explicación definitiva puede hoy considerarse incompleto o incluso erróneo. Sin embargo, este proceso de revisión constante no debilita el conocimiento científico; al contrario, lo hace más sólido y más preciso con el tiempo.
Otro aspecto importante es que las explicaciones científicas suelen revelar patrones de orden en la naturaleza. El universo, lejos de ser un caos absoluto, parece regirse por regularidades que pueden describirse mediante leyes y modelos. Estas regularidades permiten comprender fenómenos muy distintos mediante principios comunes. La gravedad, por ejemplo, explica tanto la caída de una manzana como el movimiento de los planetas.
Este descubrimiento de patrones ha permitido además algo extraordinario: la capacidad de prever ciertos acontecimientos naturales. Sabemos calcular eclipses con siglos de antelación, predecir el comportamiento de muchos sistemas físicos o comprender el desarrollo de enfermedades. Aunque la naturaleza siempre conserva un grado de complejidad e incertidumbre, el conocimiento científico permite reducir considerablemente el margen de desconocimiento.
En la vida cotidiana, muchas de las cosas que damos por sentadas son fruto de este esfuerzo por comprender el “cómo” del mundo. La electricidad que ilumina nuestras casas, los medicamentos que combaten infecciones o los satélites que orbitan la Tierra son aplicaciones directas del conocimiento científico acumulado durante siglos.
Sin embargo, el objetivo fundamental de la ciencia no es solo producir tecnología. Antes que nada, es una forma de conocimiento. Su ambición es comprender los procesos que estructuran la realidad natural: desde el nacimiento de las estrellas hasta el funcionamiento del cerebro humano. Cada descubrimiento abre nuevas preguntas y nuevos caminos de investigación.
Comprender el “cómo” de la naturaleza significa, en última instancia, revelar la arquitectura interna del mundo físico. Significa descubrir que detrás de la aparente diversidad de fenómenos existe una trama de relaciones, leyes y procesos que se repiten con sorprendente coherencia.
Las ciencias naturales han logrado avances extraordinarios en esta tarea. Han permitido explicar la estructura de la materia, la evolución de la vida, la dinámica del clima o la historia del universo. Pero incluso con todo ese conocimiento acumulado, la naturaleza sigue siendo inmensamente compleja y en gran medida misteriosa.
Y quizá ahí reside parte de su fascinación. Cada respuesta científica abre nuevas preguntas, cada explicación revela capas más profundas de realidad. El “cómo” de la naturaleza nunca se agota del todo, porque el universo es un sistema extraordinariamente rico y complejo.
La ciencia, en ese sentido, no es solo un conjunto de conocimientos, sino una aventura intelectual permanente. Una búsqueda continua por comprender los mecanismos que hacen posible el mundo en el que vivimos.
5.2. Qué no pueden explicar: valores, sentido y finalidad
Las ciencias naturales han demostrado una capacidad extraordinaria para explicar cómo funciona el mundo físico. Han logrado describir con gran precisión los procesos que gobiernan la materia, la energía y la vida. Sin embargo, ese poder explicativo tiene también sus límites. Hay cuestiones fundamentales de la experiencia humana que no pertenecen al ámbito propio de la ciencia. Entre ellas se encuentran los valores, el sentido de la existencia y la idea de finalidad.
La razón de este límite no es un defecto de la ciencia, sino una consecuencia directa de su método. Las ciencias naturales trabajan con fenómenos observables, medibles y repetibles. Su lenguaje es el de las causas físicas, los procesos naturales y las regularidades del universo. Todo aquello que puede someterse a observación sistemática, experimentación o verificación empírica entra dentro de su campo de estudio.
Pero no todo lo que forma parte de la vida humana puede reducirse a ese tipo de análisis. Existen preguntas que no se refieren a cómo funciona algo, sino a qué significa, qué valor tiene o para qué existe. Son preguntas que pertenecen a otro nivel de reflexión.
Por ejemplo, la biología puede explicar con gran detalle cómo se desarrolla un organismo humano desde la fecundación hasta la edad adulta. Puede describir los mecanismos genéticos que intervienen en ese proceso, las reacciones químicas que sostienen la vida o las estructuras celulares que permiten el funcionamiento del cuerpo. Pero la biología no puede responder a preguntas como qué valor tiene una vida humana, qué sentido puede tener la existencia o cuál debería ser el modo correcto de vivir.
Del mismo modo, la neurociencia puede estudiar cómo funcionan las redes neuronales del cerebro, cómo se generan las emociones o cómo se procesan las percepciones. Puede identificar regiones cerebrales asociadas a determinados estados mentales e incluso explicar algunos de los mecanismos biológicos que intervienen en la toma de decisiones. Sin embargo, ninguna investigación científica puede determinar si una decisión es moralmente buena o mala, justa o injusta.
Los valores pertenecen al ámbito de la ética, de la filosofía moral y de la reflexión cultural. Son construcciones humanas que se relacionan con nuestra manera de convivir, con nuestras tradiciones, con nuestras creencias y con nuestras aspiraciones como sociedad. La ciencia puede estudiar el comportamiento humano desde un punto de vista biológico o psicológico, pero no puede establecer por sí sola qué es lo correcto o lo incorrecto.
Algo parecido ocurre con la cuestión del sentido de la existencia. Desde el punto de vista científico, el ser humano puede describirse como una especie biológica surgida a lo largo de un largo proceso evolutivo. Podemos estudiar nuestra anatomía, nuestro genoma o nuestra historia evolutiva. Pero ninguna de esas explicaciones responde a la pregunta de por qué vivimos o qué significado tiene nuestra vida.
Esa pregunta pertenece a la esfera de la filosofía, de la espiritualidad, de la religión o de la reflexión personal. Cada cultura, cada tradición y cada individuo intenta responderla a su manera. La ciencia puede aportar conocimientos sobre el mundo, pero no puede ofrecer una respuesta definitiva a la cuestión del sentido.
También la idea de finalidad se sitúa fuera del campo propio de las ciencias naturales. Durante siglos, muchos pensadores interpretaron la naturaleza como un sistema orientado hacia fines concretos. Sin embargo, la ciencia moderna describe los fenómenos naturales en términos de causas y procesos, no de propósitos. Cuando un biólogo explica el funcionamiento de un órgano o la adaptación de una especie, lo hace en términos de evolución, selección natural y procesos históricos, no de intenciones o metas preestablecidas.
Esto no significa que las preguntas sobre finalidad carezcan de importancia. Para muchos seres humanos, reflexionar sobre el propósito de la vida o sobre el significado del universo es una parte esencial de la experiencia humana. Simplemente significa que esas cuestiones pertenecen a otro tipo de reflexión distinta de la científica.
Comprender estos límites es fundamental para evitar malentendidos. A veces se espera de la ciencia respuestas que no puede ofrecer, y cuando esas respuestas no llegan se genera frustración o confusión. Pero la ciencia nunca se propuso resolver todas las preguntas posibles. Su objetivo es comprender los mecanismos de la naturaleza, no determinar el valor último de la existencia.
Reconocer este límite no reduce la importancia de la ciencia. Al contrario, permite situarla en su lugar adecuado dentro del conjunto del conocimiento humano. La ciencia nos ayuda a comprender el mundo físico con una precisión extraordinaria, pero la experiencia humana es más amplia que ese campo.
La reflexión sobre los valores, el sentido y la finalidad forma parte de otras tradiciones intelectuales que han acompañado a la humanidad durante milenios: la filosofía, la religión, el pensamiento ético, la literatura o el arte. Todas ellas intentan explorar dimensiones de la existencia que no pueden medirse con instrumentos ni verificarse mediante experimentos.
De algún modo, esta diversidad de perspectivas refleja la complejidad del propio ser humano. Somos seres biológicos, pero también seres conscientes, capaces de preguntarnos por el significado de nuestra vida y por el valor de nuestras acciones. Las ciencias naturales iluminan una parte fundamental de esa realidad, pero no la agotan.
Comprender el mundo exige, por tanto, varias formas de conocimiento. La ciencia nos permite descifrar los procesos de la naturaleza; la filosofía, la ética o la reflexión espiritual nos ayudan a pensar sobre el sentido y el valor de nuestra existencia.
Cuando estas perspectivas se reconocen mutuamente y dialogan entre sí, el conocimiento humano se vuelve más amplio y más profundo. Cada una aporta una pieza distinta para comprender la complejidad del mundo y de la vida humana.
5.3. El peligro del cientificismo: cuando la ciencia se convierte en ideología
El enorme prestigio que han alcanzado las ciencias naturales en los últimos siglos es plenamente comprensible. Gracias a ellas la humanidad ha logrado comprender muchos de los mecanismos fundamentales de la naturaleza y ha desarrollado tecnologías que han transformado profundamente la vida cotidiana. La medicina moderna, la electricidad, los transportes, las telecomunicaciones o la exploración del espacio son ejemplos visibles de hasta qué punto el conocimiento científico ha ampliado nuestras posibilidades.
Sin embargo, ese éxito extraordinario ha dado lugar también a una tentación intelectual: pensar que la ciencia puede explicar absolutamente todo. Cuando se adopta esta idea, la ciencia deja de ser un método de conocimiento y pasa a convertirse en una especie de visión total del mundo. A esta postura se la suele llamar cientificismo.
El cientificismo no es lo mismo que la ciencia. Mientras que la ciencia es una forma de investigar la realidad basada en la observación, el razonamiento y la experimentación, el cientificismo es una creencia filosófica que sostiene que solo el conocimiento científico es válido y que todas las demás formas de conocimiento carecen de valor real. Según esta postura, cualquier pregunta significativa debería poder resolverse mediante métodos científicos.
A primera vista, esta idea puede parecer razonable. Si la ciencia ha tenido tanto éxito explicando el funcionamiento del universo físico, ¿por qué no confiar en ella también para resolver cualquier otra cuestión? Sin embargo, cuando se examina con más atención, esta postura plantea varios problemas.
El primero es que el cientificismo confunde el alcance de la ciencia con el alcance de la realidad. Las ciencias naturales estudian ciertos aspectos del mundo: los fenómenos físicos, químicos y biológicos. Pero el hecho de que un método sea eficaz para estudiar esos fenómenos no significa que sea adecuado para analizar todas las dimensiones de la experiencia humana.
Hay aspectos fundamentales de nuestra vida que no pueden reducirse a datos medibles o a procesos físicos. La belleza de una obra de arte, el significado de una experiencia personal, la justicia de una decisión política o el valor moral de una acción pertenecen a ámbitos distintos del conocimiento científico. Pretender que estas cuestiones puedan resolverse únicamente mediante el método científico significa ignorar la complejidad de la realidad humana.
Otro problema del cientificismo es que tiende a simplificar en exceso la naturaleza del conocimiento. A lo largo de la historia, la humanidad ha desarrollado múltiples formas de comprender el mundo: la filosofía, la literatura, la reflexión ética, la religión, las tradiciones culturales o el arte. Cada una de estas formas de conocimiento aborda aspectos diferentes de la experiencia humana.
Cuando se afirma que solo la ciencia produce conocimiento verdadero, se corre el riesgo de despreciar todas esas otras tradiciones intelectuales que también han contribuido a comprender la condición humana. La cultura humana es demasiado rica y compleja como para reducirla a un único método de explicación.
Existe además una paradoja interesante en el cientificismo. La afirmación “solo el conocimiento científico es válido” no es en sí misma una afirmación científica, sino filosófica. No puede demostrarse mediante experimentos ni mediante observaciones empíricas. En cierto sentido, el cientificismo se basa en una creencia que queda fuera del propio método científico que pretende defender.
Por esta razón, muchos filósofos de la ciencia han insistido en la necesidad de distinguir claramente entre la ciencia como disciplina y las interpretaciones ideológicas que a veces se construyen en torno a ella. La ciencia es una herramienta extraordinaria para comprender el mundo natural, pero no constituye por sí sola una filosofía completa de la realidad.
Cuando el cientificismo se convierte en una visión dominante, pueden aparecer también ciertas consecuencias culturales problemáticas. Una de ellas es la tendencia a considerar que todo aquello que no puede medirse o cuantificarse carece de importancia. Bajo esta perspectiva, aspectos esenciales de la vida humana —como la ética, la creatividad, la espiritualidad o la experiencia estética— pueden quedar relegados a un segundo plano.
Otra consecuencia es la ilusión de que la ciencia puede proporcionar respuestas definitivas a todas las preguntas humanas. Sin embargo, la propia historia de la ciencia muestra que el conocimiento científico está siempre abierto a revisión. Las teorías cambian, se perfeccionan o se sustituyen a medida que aparecen nuevos datos y nuevas ideas. La ciencia avanza precisamente porque reconoce sus propios límites.
Comprender esto permite adoptar una actitud más equilibrada. La ciencia es una de las mayores conquistas intelectuales de la humanidad, pero no es la única forma de comprender el mundo. Su grandeza reside en su capacidad para explicar los procesos de la naturaleza con rigor y precisión, no en ofrecer una respuesta total a todas las preguntas posibles.
Reconocer los límites del conocimiento científico no significa debilitarlo. Al contrario, significa respetar su verdadera naturaleza. Cuando la ciencia se mantiene dentro de su ámbito propio, su poder explicativo es inmenso. Pero cuando se intenta convertirla en una ideología que pretende sustituir a todas las demás formas de reflexión, se corre el riesgo de deformar tanto la ciencia como el propio conocimiento humano.
La verdadera riqueza del pensamiento humano surge precisamente del diálogo entre distintas formas de saber. La ciencia ilumina los mecanismos de la naturaleza; la filosofía reflexiona sobre los fundamentos del conocimiento y del sentido; las humanidades exploran la experiencia humana en toda su complejidad. Cada una aporta una perspectiva distinta, y juntas permiten una comprensión más amplia del mundo.
En ese equilibrio entre saberes reside quizá una de las lecciones más importantes de la historia intelectual: la ciencia es una herramienta poderosa para conocer la realidad, pero no necesita convertirse en una ideología para demostrar su valor.
5.4. Ciencia y filosofía: dos miradas necesarias
A lo largo de la historia del pensamiento, la ciencia y la filosofía han estado mucho más unidas de lo que a veces imaginamos hoy. En sus orígenes, la distinción entre ambas disciplinas era apenas perceptible. Los primeros pensadores que intentaron comprender la naturaleza —los filósofos de la antigua Grecia— eran al mismo tiempo lo que hoy llamaríamos científicos. Observaban el cielo, reflexionaban sobre la materia, intentaban explicar el origen del mundo y formulaban teorías sobre la vida y el cosmos. En ese momento inicial, filosofía y ciencia formaban parte de una misma búsqueda: comprender racionalmente la realidad.
Con el paso de los siglos, el conocimiento humano fue creciendo y especializándose. A partir de la revolución científica de los siglos XVI y XVII, las ciencias naturales comenzaron a desarrollar métodos propios basados en la observación sistemática, la experimentación y el análisis matemático. Este proceso dio lugar a disciplinas cada vez más especializadas: física, química, biología, astronomía, geología y muchas otras. La ciencia moderna adquirió una enorme capacidad para describir y explicar los fenómenos naturales.
Sin embargo, a pesar de esta especialización creciente, la filosofía nunca desapareció del horizonte del conocimiento. Al contrario, siguió desempeñando un papel fundamental. La razón es sencilla: la ciencia responde a muchas preguntas sobre cómo funciona el mundo, pero las preguntas sobre qué significa ese conocimiento, cuáles son sus límites o cómo debemos interpretarlo pertenecen al ámbito de la reflexión filosófica.
La filosofía, en cierto modo, se sitúa en un nivel más amplio de reflexión. No se limita a estudiar fenómenos concretos, sino que intenta analizar los fundamentos del conocimiento, el significado de las teorías, la naturaleza de la verdad o el lugar que ocupa el ser humano en el universo. Estas cuestiones no pueden resolverse mediante experimentos de laboratorio, pero son esenciales para comprender el alcance del saber científico.
Por ejemplo, cuando un científico formula una teoría sobre el origen del universo o sobre la evolución de la vida, surgen inmediatamente preguntas más amplias. ¿Qué significa realmente explicar algo? ¿Qué grado de certeza tienen nuestras teorías? ¿Hasta qué punto el conocimiento científico describe la realidad o simplemente construye modelos útiles para comprenderla? Estas preguntas pertenecen al ámbito de lo que se conoce como filosofía de la ciencia.
La filosofía de la ciencia analiza precisamente cómo funciona el conocimiento científico: cuáles son sus métodos, qué tipo de razonamientos utiliza, cómo se construyen las teorías y cómo cambian a lo largo del tiempo. Gracias a este tipo de reflexión se comprende mejor que la ciencia no es un conjunto de verdades absolutas e inmutables, sino un proceso dinámico de investigación que evoluciona con el tiempo.
Además, la filosofía también ayuda a plantear preguntas que a menudo preceden a los grandes avances científicos. Muchas ideas que hoy forman parte del conocimiento científico surgieron originalmente como reflexiones filosóficas. La idea de que la naturaleza está regida por leyes racionales, por ejemplo, fue en su origen una intuición filosófica que más tarde se convirtió en uno de los pilares de la ciencia moderna.
La relación entre ciencia y filosofía también aparece cuando se reflexiona sobre las consecuencias del conocimiento científico. Los descubrimientos científicos no existen en un vacío cultural; influyen en la manera en que los seres humanos comprenden el mundo y se comprenden a sí mismos. La teoría de la evolución, por ejemplo, no solo transformó la biología, sino también la forma en que la humanidad se piensa dentro de la historia de la vida.
En estos casos, la filosofía desempeña un papel importante al ayudar a interpretar el significado más amplio de esos descubrimientos. Permite reflexionar sobre sus implicaciones para nuestra visión del ser humano, para la ética, para la cultura o para nuestra comprensión del lugar que ocupamos en el universo.
También es la filosofía la que invita a examinar críticamente los propios supuestos del pensamiento científico. Ningún conocimiento se desarrolla completamente al margen de ciertos marcos conceptuales. Las preguntas sobre qué es la realidad, qué significa explicar un fenómeno o qué entendemos por causalidad tienen un componente filosófico inevitable.
Lejos de ser disciplinas enfrentadas, ciencia y filosofía pueden entenderse como dos perspectivas complementarias sobre la realidad. La ciencia se centra en el análisis detallado de los fenómenos naturales; la filosofía reflexiona sobre el significado más amplio de ese conocimiento y sobre las preguntas que quedan abiertas.
Cuando ambas perspectivas dialogan, el conocimiento humano se vuelve más rico y más profundo. La ciencia aporta datos, teorías y modelos que permiten comprender los procesos del universo; la filosofía ayuda a interpretar ese conocimiento, a situarlo dentro de una visión más amplia del mundo y a examinar sus límites.
De hecho, muchos de los grandes científicos de la historia mantuvieron siempre una fuerte dimensión filosófica en su pensamiento. Newton, Einstein o Darwin no se limitaron a formular teorías técnicas; también reflexionaron sobre las implicaciones de sus descubrimientos y sobre las preguntas fundamentales que estos abrían.
En cierto sentido, la ciencia y la filosofía responden a dos necesidades distintas pero igualmente humanas. Una busca comprender el funcionamiento del mundo, la otra intenta reflexionar sobre el significado de ese conocimiento. Separarlas completamente empobrecería nuestra comprensión de la realidad.
Por eso puede decirse que ambas disciplinas representan dos miradas necesarias. La ciencia ilumina los mecanismos de la naturaleza con una precisión cada vez mayor. La filosofía, por su parte, nos recuerda que el conocimiento humano no consiste solo en acumular datos, sino también en pensar sobre lo que esos datos significan.
Juntas forman parte de una misma aventura intelectual: la búsqueda de una comprensión cada vez más profunda del mundo y de nuestro lugar dentro de él.
5.5. Ciencia y religión: conflicto, diálogo y malentendidos
La relación entre ciencia y religión ha sido, durante siglos, uno de los temas más debatidos de la historia del pensamiento. A menudo se presenta como una confrontación inevitable entre dos formas opuestas de entender el mundo: por un lado, la ciencia basada en la observación y el razonamiento; por otro, la religión apoyada en la fe y la tradición. Sin embargo, esta imagen simplificada no refleja del todo la complejidad histórica ni intelectual de esta relación.
En realidad, ciencia y religión han coexistido durante largos periodos sin enfrentamientos directos. Durante gran parte de la historia, muchos de los grandes investigadores de la naturaleza eran personas profundamente religiosas. Para ellos, estudiar el mundo natural no era una actividad contraria a la fe, sino una forma de comprender mejor la obra de la creación. La idea de que el universo posee un orden racional, susceptible de ser comprendido mediante la razón humana, fue en muchos casos compatible con una visión religiosa del mundo.
En el nacimiento de la ciencia moderna, numerosos científicos entendían su trabajo como una exploración del orden de la naturaleza. El universo era concebido como un sistema regido por leyes, y descubrir esas leyes era una forma de desvelar la estructura profunda de la realidad. Esta visión favoreció el desarrollo de la investigación científica, ya que suponía que el mundo no era caótico ni arbitrario, sino inteligible.
Sin embargo, a medida que el conocimiento científico fue avanzando, surgieron también tensiones. Algunas interpretaciones tradicionales de los textos religiosos entraron en conflicto con los nuevos descubrimientos científicos. Uno de los ejemplos más conocidos es la controversia en torno a la estructura del sistema solar en los comienzos de la astronomía moderna. Cuando ciertos descubrimientos parecieron contradecir interpretaciones literales de antiguos textos, se generaron enfrentamientos que marcaron profundamente la percepción pública de la relación entre ciencia y religión.
Con el tiempo, muchos de estos conflictos se fueron reinterpretando. En muchos casos, el problema no residía tanto en la ciencia o en la religión en sí mismas, sino en la manera en que se interpretaban sus respectivos ámbitos. Cuando una tradición religiosa intentaba ofrecer explicaciones detalladas sobre fenómenos naturales, podía entrar en terreno que hoy pertenece claramente al conocimiento científico. Del mismo modo, cuando algunos defensores de la ciencia pretendían utilizarla para responder a preguntas sobre el sentido último de la existencia, se movían hacia un terreno filosófico o espiritual que excede el método científico.
Por esta razón, numerosos pensadores han señalado que ciencia y religión se ocupan, en gran medida, de preguntas diferentes. Las ciencias naturales estudian los procesos del universo, investigan cómo funcionan los fenómenos físicos y biológicos y construyen teorías que permiten comprender el desarrollo del mundo natural. La religión, en cambio, suele centrarse en cuestiones relacionadas con el significado de la existencia, el origen último del universo, la relación entre el ser humano y lo trascendente o las orientaciones morales de la vida.
Cuando se respetan estos ámbitos distintos, el conflicto se reduce considerablemente. La ciencia no necesita pronunciarse sobre la dimensión espiritual o religiosa de la experiencia humana, del mismo modo que la religión no puede sustituir a la investigación científica en la explicación de los procesos naturales.
A pesar de ello, los malentendidos siguen siendo frecuentes. A veces se plantea la relación entre ciencia y religión como una lucha entre razón y fe, como si ambas fueran necesariamente incompatibles. Pero esta oposición simplificada ignora que la realidad intelectual es mucho más matizada. La razón humana ha sido utilizada tanto en la investigación científica como en la reflexión teológica o filosófica. Ambas tradiciones han desarrollado sistemas complejos de pensamiento a lo largo de los siglos.
También existen situaciones en las que el diálogo entre ciencia y religión puede resultar fructífero. El desarrollo del conocimiento científico plantea preguntas profundas sobre el origen del universo, la naturaleza de la vida o el lugar del ser humano en el cosmos. Estas cuestiones no siempre pueden resolverse exclusivamente mediante métodos científicos, y a menudo invitan a reflexiones filosóficas o espirituales más amplias.
Por ejemplo, el descubrimiento de la inmensidad del universo o la complejidad de la vida ha suscitado en muchas personas una sensación de asombro que trasciende el ámbito puramente científico. Este tipo de experiencias no son incompatibles con la investigación racional; al contrario, forman parte del mismo impulso humano de comprender la realidad en toda su profundidad.
En las sociedades contemporáneas, la relación entre ciencia y religión sigue evolucionando. En algunos contextos, se mantienen posturas de confrontación. En otros, se buscan formas de diálogo que permitan reconocer la legitimidad de distintos niveles de reflexión sobre la realidad.
Quizá una de las claves para comprender esta relación consiste en reconocer que el conocimiento humano tiene diversas dimensiones. La ciencia aporta una comprensión rigurosa de los procesos naturales y permite describir con precisión el funcionamiento del universo. La religión, por su parte, se sitúa en un plano distinto, relacionado con el significado, la trascendencia y la orientación moral de la vida.
Cuando ambas esferas se confunden o intentan ocupar el lugar de la otra, surgen conflictos y malentendidos. Pero cuando se reconocen sus ámbitos propios y se mantienen abiertas al diálogo, pueden coexistir como formas distintas de aproximarse a una realidad que siempre supera nuestra comprensión completa.
La historia muestra que el ser humano no solo busca explicar el mundo, sino también comprender su significado. En ese doble impulso —explicar y comprender— se encuentran, de diferentes maneras, tanto la ciencia como la religión.
5.6. Por qué las humanidades siguen siendo imprescindibles
En una época profundamente marcada por el desarrollo científico y tecnológico, puede surgir la impresión de que las disciplinas humanísticas han perdido parte de su importancia. Vivimos rodeados de avances técnicos, sistemas digitales, inteligencia artificial, biotecnología o exploración espacial. En este contexto, las ciencias parecen ocupar el centro del progreso humano. Sin embargo, esta percepción puede ser engañosa. Precisamente en un mundo cada vez más dominado por la tecnología, las humanidades resultan más necesarias que nunca.
Las humanidades —la historia, la filosofía, la literatura, el arte, la filología o la reflexión ética— se ocupan de una dimensión fundamental de la realidad: la experiencia humana. Mientras que las ciencias naturales investigan los procesos de la naturaleza, las humanidades intentan comprender cómo viven, piensan y sienten los seres humanos, cómo organizan sus sociedades, cómo interpretan el mundo y qué significado dan a su propia existencia.
Esta diferencia no implica que unas disciplinas sean superiores a otras. Más bien señala que se ocupan de ámbitos distintos pero complementarios del conocimiento. Las ciencias pueden explicar cómo funciona el cerebro humano, pero no pueden describir la riqueza de la experiencia interior que encontramos en la literatura o en la poesía. Pueden analizar la acústica de una sinfonía, pero no pueden expresar el impacto emocional que la música produce en quienes la escuchan.
Las humanidades nos permiten comprender el mundo desde la perspectiva de la cultura, de la historia y de la conciencia humana. Gracias a ellas podemos conocer cómo pensaban las civilizaciones del pasado, qué valores guiaban sus decisiones y cómo interpretaron los grandes acontecimientos de su tiempo. Sin ese conocimiento histórico, nuestra comprensión del presente quedaría profundamente empobrecida.
La historia, por ejemplo, no es solo una acumulación de fechas o acontecimientos. Es una reflexión sobre la experiencia colectiva de la humanidad. A través de ella descubrimos cómo se han formado las sociedades, cómo se han construido las instituciones y cómo han surgido las ideas que todavía influyen en nuestro mundo. Estudiar historia significa observar la trayectoria del ser humano a lo largo del tiempo, con sus logros, sus errores y sus transformaciones.
Algo similar ocurre con la filosofía. Desde la antigüedad, los filósofos han intentado reflexionar sobre las preguntas más profundas de la existencia: qué es la verdad, qué significa vivir bien, qué es la justicia o qué lugar ocupa el ser humano en el universo. Estas preguntas siguen siendo esenciales incluso en una sociedad tecnológicamente avanzada. Ningún progreso técnico puede sustituir la reflexión sobre los valores que orientan nuestras decisiones.
La literatura y el arte, por su parte, ofrecen otra forma de conocimiento que no se basa en la demostración científica, sino en la exploración de la experiencia humana. A través de los relatos, los poemas, las pinturas o la música, las humanidades nos permiten entrar en contacto con emociones, conflictos y perspectivas que forman parte de la vida humana. Estas obras no solo entretienen o emocionan; también nos ayudan a comprender mejor a los demás y a nosotros mismos.
En este sentido, las humanidades desempeñan un papel esencial en la formación de una mirada crítica y reflexiva sobre el mundo. Nos enseñan a interpretar textos, a analizar ideas, a comprender contextos históricos y a reconocer la diversidad de perspectivas que existen en las sociedades humanas. Estas capacidades son fundamentales para una ciudadanía consciente y para una cultura democrática madura.
Además, las humanidades nos recuerdan que el progreso humano no puede medirse únicamente en términos de innovación técnica o crecimiento económico. Una sociedad puede alcanzar grandes avances tecnológicos y, al mismo tiempo, enfrentarse a profundas crisis morales o culturales. La historia ofrece numerosos ejemplos de civilizaciones que alcanzaron un gran desarrollo material sin resolver ciertos problemas fundamentales de convivencia o justicia.
Por esta razón, el desarrollo científico necesita ir acompañado de una reflexión ética y cultural. Los avances en genética, inteligencia artificial o ingeniería tecnológica plantean preguntas importantes sobre el uso responsable del conocimiento. ¿Qué límites deben establecerse? ¿Qué consecuencias pueden tener ciertas decisiones para las generaciones futuras? Estas cuestiones no pueden resolverse solo mediante cálculos técnicos; requieren también reflexión moral y filosófica.
Las humanidades aportan precisamente ese espacio de reflexión. Ayudan a situar el conocimiento científico dentro de una visión más amplia de la cultura y de la condición humana. Permiten pensar no solo en lo que podemos hacer, sino también en lo que debemos hacer.
Por otro lado, las humanidades también alimentan la imaginación y la sensibilidad. El contacto con la literatura, el arte o la música amplía nuestra percepción del mundo y nos permite experimentar formas de belleza, emoción y significado que no pueden reducirse a datos o fórmulas. Esta dimensión estética forma parte esencial de la vida humana.
A lo largo de la historia, las grandes culturas han surgido precisamente de la interacción entre conocimiento técnico, pensamiento filosófico y expresión artística. Cuando alguna de estas dimensiones se debilita, el equilibrio cultural se resiente.
En el mundo contemporáneo, donde la información circula con enorme rapidez y las transformaciones tecnológicas se suceden a gran velocidad, las humanidades ofrecen algo especialmente valioso: tiempo para pensar. Invitan a la reflexión, al análisis crítico y a la comprensión profunda de los procesos históricos y culturales.
Por eso siguen siendo imprescindibles. No solo porque preservan la memoria cultural de la humanidad, sino porque ayudan a orientar el conocimiento científico dentro de una visión más amplia del ser humano. Las ciencias nos enseñan cómo funciona el mundo; las humanidades nos ayudan a comprender qué significa vivir en él.
5.7. El ser humano como puente: naturaleza y conciencia
En el conjunto del universo conocido, el ser humano ocupa una posición singular. Desde el punto de vista biológico, somos una especie más dentro de la vasta diversidad de la vida. Nuestro cuerpo está formado por los mismos elementos químicos que componen la materia del universo; nuestras células funcionan según los mismos principios biológicos que rigen a todos los organismos vivos. En ese sentido, pertenecemos plenamente al mundo natural. Somos naturaleza.
Sin embargo, la experiencia humana revela también otra dimensión. A diferencia de otros seres vivos, los seres humanos poseemos una conciencia reflexiva que nos permite pensar sobre nosotros mismos, sobre el mundo y sobre el significado de nuestra existencia. No solo vivimos en la naturaleza, sino que somos capaces de observarla, estudiarla e intentar comprenderla. Esta capacidad de reflexión sitúa al ser humano en una posición peculiar dentro del conjunto de la realidad.
Podría decirse que el ser humano actúa como un puente entre dos dimensiones: por un lado, la naturaleza física de la que formamos parte; por otro, la conciencia que nos permite comprenderla. Nuestro cuerpo pertenece al mundo material, pero nuestra mente es capaz de construir ideas, teorías, culturas y sistemas de pensamiento que trascienden la simple supervivencia biológica.
Las ciencias naturales han mostrado con claridad la profundidad de nuestra pertenencia al mundo natural. La biología ha demostrado que los seres humanos compartimos un origen evolutivo común con otras especies. Nuestro organismo es el resultado de millones de años de evolución, y muchas de nuestras características físicas y conductuales tienen raíces profundas en la historia de la vida.
La neurociencia, por su parte, ha revelado la complejidad extraordinaria del cerebro humano. En ese órgano, compuesto por miles de millones de neuronas interconectadas, se originan procesos tan complejos como la memoria, el lenguaje, la imaginación o la capacidad de razonar. La mente humana, con toda su riqueza, surge de una base biológica profundamente integrada en la naturaleza.
Pero al mismo tiempo, la conciencia humana introduce una dimensión nueva en el universo conocido. Los seres humanos no solo reaccionamos a los estímulos del entorno; también somos capaces de interpretar la realidad, de formular preguntas sobre el origen del mundo, de construir explicaciones científicas y de crear sistemas culturales complejos.
Gracias a esta capacidad, la naturaleza ha llegado a contemplarse a sí misma a través de la mente humana. El universo, que durante miles de millones de años evolucionó sin observadores conscientes, ha producido finalmente seres capaces de preguntarse por su origen y su estructura. De algún modo, el ser humano se convierte así en un punto de encuentro entre la materia y la conciencia.
Esta posición intermedia explica también muchas de las tensiones que atraviesan la experiencia humana. Por un lado, estamos profundamente vinculados a nuestra condición biológica. Necesitamos alimento, descanso, protección y relaciones sociales para sobrevivir. Nuestros cuerpos responden a los mismos procesos fisiológicos que rigen la vida en la Tierra.
Pero al mismo tiempo, nuestra conciencia nos impulsa a ir más allá de las necesidades inmediatas. Los seres humanos buscamos conocimiento, significado, belleza, justicia o trascendencia. Construimos culturas, desarrollamos lenguajes, creamos arte y elaboramos sistemas de pensamiento que intentan comprender el mundo y orientar la vida humana.
Esta doble dimensión ha sido objeto de reflexión en muchas tradiciones filosóficas. Algunas han insistido en la continuidad entre el ser humano y el resto de la naturaleza; otras han destacado la singularidad de la conciencia humana. En realidad, ambas perspectivas captan aspectos verdaderos de nuestra condición.
Somos parte del mundo natural y, al mismo tiempo, somos capaces de reflexionar sobre él. Esta posición nos otorga una responsabilidad particular. El conocimiento científico nos permite comprender cada vez mejor los procesos de la naturaleza, pero también nos recuerda que nuestras acciones pueden influir profundamente en el equilibrio del planeta.
El desarrollo tecnológico ha ampliado enormemente nuestra capacidad de intervenir en el entorno natural. Podemos modificar ecosistemas, transformar paisajes y alterar procesos biológicos que durante millones de años siguieron su curso de manera independiente. Esta capacidad exige una reflexión ética sobre el uso del conocimiento científico y sobre nuestra relación con el mundo natural.
En este sentido, comprender al ser humano como puente entre naturaleza y conciencia implica también reconocer nuestra responsabilidad dentro de la historia del planeta. Somos la única especie conocida capaz de reflexionar conscientemente sobre el impacto de sus acciones y de intentar orientar su comportamiento en función de ese conocimiento.
La ciencia nos permite comprender cada vez mejor los mecanismos de la naturaleza. La filosofía y las humanidades nos ayudan a reflexionar sobre el significado de ese conocimiento y sobre el modo en que debemos utilizarlo. En el encuentro entre ambas dimensiones se sitúa la condición humana.
Ser humano significa, en última instancia, habitar simultáneamente estos dos mundos: el de la naturaleza que nos ha producido y el de la conciencia que nos permite comprenderla. En esa frontera entre materia y pensamiento se desarrolla la aventura intelectual y cultural de nuestra especie.
Así, el ser humano no solo forma parte de la naturaleza, sino que también se convierte en uno de los lugares donde la naturaleza llega a conocerse a sí misma.
6.1. Ciencia y tecnología: conocimiento aplicado.
6.2. Progreso material: medicina, energía, transporte y comunicaciones.
6.3. La ciencia como poder: quién controla el conocimiento.
6.4. Riesgos modernos: contaminación, armas, manipulación biológica.
6.5. Responsabilidad humana: ética científica y límites morales.
6.6. Educación científica: por qué una sociedad ignorante es vulnerable.
6.7. La ciencia como parte de la cultura, no como enemigo de la cultura.

La ciencia como motor de transformación del mundo contemporáneo: investigación científica, tecnología, energía, medicina y exploración del universo como expresiones del conocimiento aplicado.
La ciencia no es solo un conjunto de conocimientos sobre la naturaleza; es también una fuerza capaz de transformar profundamente la sociedad. A partir de la investigación científica surgen tecnologías que modifican nuestra forma de vivir, desde los avances médicos que prolongan la vida hasta los sistemas de energía, transporte y comunicación que conectan el planeta. En el mundo moderno, ciencia, tecnología y cultura forman un entramado inseparable: el conocimiento genera poder, plantea nuevos riesgos y exige una reflexión ética constante sobre el uso responsable de los descubrimientos humanos.
6. Ciencias naturales, sociedad y cultura
Las ciencias naturales no existen en un vacío aislado. Aunque su objeto principal de estudio es la naturaleza —la materia, la energía, la vida y los procesos que estructuran el universo— sus descubrimientos y aplicaciones influyen profundamente en la forma en que los seres humanos viven, se organizan y comprenden el mundo. Desde los comienzos de la ciencia moderna, el conocimiento científico ha ido transformando de manera progresiva la vida cotidiana, la economía, la política y la cultura.
A lo largo de los últimos siglos, esta influencia se ha vuelto cada vez más visible. Los avances científicos han dado lugar a tecnologías que han cambiado radicalmente la experiencia humana. La medicina ha permitido combatir enfermedades que durante siglos fueron mortales; los sistemas de energía han multiplicado la capacidad productiva de las sociedades; los transportes han reducido distancias que antes parecían insalvables; y las comunicaciones han conectado continentes en cuestión de segundos. En pocas generaciones, la humanidad ha pasado de vivir en un mundo relativamente aislado y limitado a habitar una civilización global profundamente interconectada.
Este proceso muestra hasta qué punto la ciencia no es solo una actividad intelectual, sino también una fuerza social de primer orden. El conocimiento científico se convierte rápidamente en tecnología, y la tecnología modifica las estructuras económicas, las formas de trabajo y las relaciones entre las sociedades. La historia moderna puede entenderse, en gran medida, como la historia de una interacción constante entre descubrimientos científicos y transformaciones sociales.
Sin embargo, este poder transformador no está exento de ambigüedades. El mismo conocimiento que permite curar enfermedades puede utilizarse también para desarrollar armas cada vez más destructivas. Las tecnologías que facilitan la producción industrial pueden mejorar la calidad de vida de millones de personas, pero también generar graves problemas ambientales si se utilizan sin control. De este modo, la ciencia aparece no solo como una fuente de progreso, sino también como una herramienta cuyo uso depende de decisiones humanas.
Por esta razón, la relación entre ciencia y sociedad plantea preguntas que van más allá del laboratorio. ¿Quién controla el conocimiento científico? ¿Cómo se decide qué investigaciones se financian y cuáles no? ¿Quién se beneficia de los avances tecnológicos? Estas cuestiones muestran que la ciencia no es una actividad completamente neutral, sino que se desarrolla dentro de contextos sociales, políticos y económicos concretos.
En las sociedades contemporáneas, el conocimiento científico se ha convertido en una forma de poder. Los países que dominan las tecnologías más avanzadas suelen tener una gran influencia en la economía global, en la política internacional y en el desarrollo industrial. El control de la energía, de la informática, de la biotecnología o de la inteligencia artificial puede determinar el equilibrio de poder entre las naciones.
Al mismo tiempo, el progreso científico plantea nuevos desafíos éticos. Los avances en genética, en inteligencia artificial o en manipulación biológica abren posibilidades que hace apenas unas décadas pertenecían al ámbito de la ciencia ficción. La capacidad de intervenir en los procesos de la vida o de desarrollar sistemas tecnológicos autónomos obliga a reflexionar sobre los límites del conocimiento y sobre las responsabilidades que acompañan a estos descubrimientos.
En este contexto, la ciencia deja de ser solo un instrumento técnico y se convierte también en una cuestión cultural y moral. El conocimiento científico debe integrarse dentro de una reflexión más amplia sobre el tipo de sociedad que queremos construir. No se trata únicamente de preguntarse qué podemos hacer gracias a la ciencia, sino también qué debemos hacer y cuáles son las consecuencias de nuestras decisiones.
Otro aspecto fundamental de esta relación entre ciencia y sociedad es la educación. En un mundo profundamente influido por la tecnología, comprender los principios básicos del conocimiento científico se vuelve esencial para la ciudadanía. Una sociedad que ignora los fundamentos de la ciencia corre el riesgo de ser vulnerable a la manipulación, a la desinformación o a decisiones colectivas basadas en el miedo o en la ignorancia.
La alfabetización científica no significa que todos los ciudadanos deban convertirse en especialistas, pero sí que dispongan de herramientas intelectuales suficientes para comprender los grandes debates que afectan al mundo contemporáneo: el cambio climático, la energía, la salud pública, el uso de los recursos naturales o el desarrollo tecnológico.
Por último, es importante recordar que la ciencia forma parte de la cultura humana en el sentido más amplio. A veces se presenta el conocimiento científico como algo separado de las humanidades o incluso como un rival de la cultura tradicional. Sin embargo, esta oposición es artificial. La ciencia es una expresión más de la creatividad intelectual humana, del mismo modo que lo son la filosofía, la literatura o el arte.
A lo largo de la historia, las grandes civilizaciones han desarrollado simultáneamente conocimientos científicos, reflexiones filosóficas y expresiones artísticas. Todas ellas forman parte de la misma aventura cultural: el intento de comprender el mundo y de dar sentido a la experiencia humana.
En este último bloque del estudio sobre las ciencias naturales se examinará precisamente esta relación entre conocimiento científico, sociedad y cultura. Se analizará cómo la ciencia se convierte en tecnología aplicada, cómo ha transformado las condiciones materiales de la vida humana, qué riesgos y responsabilidades acompañan a su desarrollo y por qué el conocimiento científico debe integrarse dentro de una visión cultural más amplia.
Comprender esta relación es esencial para entender el mundo contemporáneo. La ciencia ha ampliado enormemente nuestro poder sobre la naturaleza, pero también nos obliga a pensar con mayor profundidad sobre el uso de ese poder y sobre el futuro de la civilización humana.
6.1. Ciencia y tecnología: conocimiento aplicado
Cuando se habla de ciencia, muchas personas piensan inmediatamente en laboratorios, telescopios, ecuaciones o investigaciones muy especializadas que parecen alejadas de la vida cotidiana. Sin embargo, una de las características más notables del conocimiento científico es su capacidad para transformarse en tecnología. La ciencia busca comprender cómo funciona la naturaleza; la tecnología utiliza ese conocimiento para crear herramientas, sistemas y soluciones prácticas que modifican la vida humana. En este sentido, la tecnología puede entenderse como la aplicación concreta del conocimiento científico.
A lo largo de la historia, esta relación entre ciencia y tecnología ha sido una de las fuerzas más poderosas de transformación social. Desde los primeros avances en metalurgia, navegación o agricultura hasta las tecnologías digitales contemporáneas, el conocimiento sobre los procesos naturales ha permitido ampliar enormemente las capacidades humanas. Lo que comienza como una investigación teórica en un campo científico puede terminar, años o incluso décadas después, convirtiéndose en una innovación que afecta a millones de personas.
Un ejemplo claro de esta relación puede encontrarse en la electricidad. Durante mucho tiempo, el estudio de los fenómenos eléctricos fue una cuestión puramente científica. Los investigadores trataban de comprender cómo se comportaban ciertas cargas, cómo se transmitía la energía o qué propiedades tenían determinados materiales. Sin embargo, con el tiempo ese conocimiento permitió desarrollar sistemas eléctricos que transformaron completamente la vida cotidiana: iluminación, motores, telecomunicaciones y una larga lista de aplicaciones tecnológicas que hoy consideramos normales.
Algo parecido ocurrió con el estudio de la estructura de la materia. La investigación en física y química permitió comprender cómo están formados los átomos y cómo interactúan entre sí. A partir de estos descubrimientos surgieron nuevos materiales, procesos industriales más eficientes, medicamentos, plásticos, semiconductores y numerosos avances que hoy forman parte de la base tecnológica de la sociedad moderna.
En el campo de la biología, el impacto ha sido igualmente profundo. El conocimiento sobre el funcionamiento de las células, la genética o los microorganismos ha dado lugar a tecnologías médicas capaces de prevenir enfermedades, producir vacunas o desarrollar tratamientos que hace solo unas décadas habrían parecido imposibles. La investigación sobre el ADN, por ejemplo, no solo ha ampliado nuestra comprensión de la vida, sino que ha abierto el camino a nuevas formas de diagnóstico y terapia médica.
Este proceso revela una característica fundamental del conocimiento científico: su capacidad para generar aplicaciones prácticas incluso cuando en un principio no se buscaban. Muchas investigaciones científicas comienzan como intentos de comprender fenómenos naturales sin un objetivo tecnológico inmediato. Sin embargo, el conocimiento acumulado puede dar lugar más adelante a aplicaciones inesperadas que cambian profundamente la sociedad.
La relación entre ciencia y tecnología también funciona en sentido inverso. Los avances tecnológicos permiten desarrollar nuevos instrumentos que amplían la capacidad de investigación científica. Los telescopios más potentes, los microscopios avanzados, los aceleradores de partículas o los sistemas de computación de alto rendimiento son herramientas tecnológicas que han hecho posible explorar aspectos de la naturaleza que antes resultaban inaccesibles.
De esta manera, ciencia y tecnología forman un ciclo continuo de retroalimentación. La investigación científica produce conocimiento que puede convertirse en tecnología, y esa tecnología proporciona a su vez nuevas herramientas para seguir investigando. Este proceso ha acelerado enormemente el ritmo del progreso en los últimos siglos.
Sin embargo, la aplicación tecnológica del conocimiento científico también plantea preguntas importantes. La tecnología no es simplemente un conjunto neutral de herramientas; su desarrollo y su uso tienen consecuencias sociales, económicas y ambientales. Cada innovación tecnológica introduce cambios en la forma en que las sociedades trabajan, producen, se comunican o se relacionan con la naturaleza.
Por ejemplo, la revolución industrial transformó profundamente la organización del trabajo y el desarrollo de las ciudades. Más recientemente, las tecnologías digitales han cambiado la manera en que accedemos a la información, nos comunicamos y participamos en la vida social. Estos cambios muestran que la tecnología no solo modifica los objetos que utilizamos, sino también las estructuras de la sociedad.
Además, la aplicación del conocimiento científico puede tener efectos tanto positivos como problemáticos. Las mismas técnicas que permiten producir energía o mejorar la medicina pueden utilizarse también para desarrollar armamento sofisticado o sistemas que alteran profundamente el equilibrio del medio ambiente. Por esta razón, el desarrollo tecnológico siempre va acompañado de decisiones humanas sobre cómo utilizar ese conocimiento.
Comprender la relación entre ciencia y tecnología implica reconocer que el conocimiento científico no permanece encerrado en los laboratorios. Tarde o temprano, ese conocimiento tiende a traducirse en herramientas capaces de modificar el mundo material y las condiciones de la vida humana.
En el mundo contemporáneo, esta relación se ha vuelto especialmente intensa. La investigación científica y el desarrollo tecnológico forman hoy un sistema estrechamente conectado que impulsa gran parte de la innovación económica y del progreso material. Universidades, centros de investigación, empresas tecnológicas y gobiernos participan en una red compleja dedicada a transformar el conocimiento en aplicaciones prácticas.
De este modo, la ciencia no solo amplía nuestra comprensión de la naturaleza, sino que también se convierte en una de las principales fuentes de transformación del mundo. La tecnología representa el momento en que el conocimiento deja de ser únicamente teoría y se convierte en acción sobre la realidad.
6.2. Progreso material: medicina, energía, transporte y comunicaciones
Uno de los efectos más visibles del desarrollo científico ha sido el enorme progreso material que ha experimentado la humanidad en los últimos siglos. El conocimiento de la naturaleza no solo ha permitido comprender mejor el mundo, sino también mejorar las condiciones de vida de millones de personas. En muchos aspectos fundamentales de la existencia cotidiana —la salud, la energía, el transporte o las comunicaciones— los avances científicos han transformado profundamente la experiencia humana.
La medicina constituye quizá uno de los ejemplos más claros de esta transformación. Durante la mayor parte de la historia, la vida humana estuvo marcada por enfermedades que hoy resultan prevenibles o tratables. Epidemias, infecciones y dolencias que durante siglos causaron enormes sufrimientos podían propagarse sin control en sociedades que apenas comprendían su origen. El desarrollo de la microbiología, de la farmacología y de la investigación médica permitió descubrir los microorganismos responsables de muchas enfermedades, desarrollar vacunas y crear medicamentos capaces de combatir infecciones que antes eran mortales.
Estos avances han cambiado radicalmente la esperanza de vida de las poblaciones. En muchas regiones del mundo, la longevidad humana se ha duplicado en comparación con siglos anteriores. La medicina moderna no solo trata enfermedades, sino que también permite prevenirlas, diagnosticar con precisión y mejorar la calidad de vida de las personas. La cirugía, los antibióticos, la vacunación o las técnicas de diagnóstico por imagen son ejemplos de cómo el conocimiento científico se traduce en beneficios concretos para la salud humana.
Otro ámbito decisivo ha sido el de la energía. Toda civilización depende de su capacidad para obtener y utilizar energía. Durante gran parte de la historia, las sociedades humanas se apoyaron en fuentes relativamente limitadas: la fuerza muscular, el viento, el agua o la combustión de madera. Con el desarrollo de la ciencia y la tecnología, la humanidad aprendió a aprovechar nuevas fuentes energéticas mucho más potentes y eficientes.
La revolución industrial estuvo estrechamente ligada al uso del carbón y posteriormente del petróleo y del gas natural. Estas fuentes de energía permitieron impulsar máquinas, desarrollar industrias y multiplicar la producción material. Más tarde, el conocimiento científico hizo posible la generación de electricidad a gran escala, lo que transformó por completo la vida urbana, la iluminación, la producción industrial y la comunicación.
En las últimas décadas, la investigación científica ha impulsado además el desarrollo de nuevas formas de energía, como la energía solar, la eólica o otras tecnologías destinadas a reducir el impacto ambiental de la producción energética. Estas innovaciones muestran cómo la ciencia continúa buscando soluciones para equilibrar el progreso material con la sostenibilidad del planeta.
El transporte ha sido otro campo profundamente transformado por la aplicación del conocimiento científico. Durante milenios, el desplazamiento humano estuvo limitado por la velocidad de los animales o por la navegación a vela. La introducción de la máquina de vapor, posteriormente del motor de combustión interna y finalmente de los sistemas de propulsión modernos cambió radicalmente la escala de movilidad humana.
Los trenes, los automóviles, los aviones y los barcos modernos han reducido de forma extraordinaria las distancias entre regiones del planeta. Lo que en otro tiempo requería semanas o meses de viaje hoy puede realizarse en pocas horas. Este cambio ha tenido consecuencias profundas en el comercio, en la economía global y en el intercambio cultural entre sociedades.
Igualmente revolucionario ha sido el desarrollo de las comunicaciones. Durante siglos, la transmisión de información dependía del transporte físico de mensajes, lo que imponía límites muy estrictos a la rapidez de la comunicación. Con el descubrimiento de los principios eléctricos y electromagnéticos surgieron tecnologías que transformaron completamente esta situación.
El telégrafo, el teléfono, la radio y posteriormente la televisión permitieron transmitir información a grandes distancias en tiempos cada vez más breves. Más recientemente, el desarrollo de la informática y de las redes digitales ha dado lugar a un sistema global de comunicación instantánea. Internet ha conectado prácticamente todos los rincones del planeta, permitiendo el intercambio inmediato de información, conocimientos y experiencias.
Este sistema de comunicaciones ha transformado profundamente la cultura, la economía y la organización social. La información circula hoy a una velocidad sin precedentes, y el acceso al conocimiento se ha ampliado enormemente. Las sociedades contemporáneas funcionan en gran medida gracias a esta infraestructura tecnológica que permite coordinar actividades a escala global.
En conjunto, estos avances muestran cómo el conocimiento científico ha contribuido a crear un mundo materialmente muy distinto del que conocieron las generaciones anteriores. La medicina prolonga la vida, la energía impulsa la actividad económica, el transporte conecta territorios y las comunicaciones permiten el intercambio inmediato de información.
Sin embargo, este progreso material también plantea nuevos desafíos. El uso intensivo de recursos naturales, el impacto ambiental de ciertas tecnologías o las desigualdades en el acceso a estos avances recuerdan que el progreso científico no es automáticamente sinónimo de bienestar universal. Las sociedades deben aprender a gestionar estos avances de forma responsable y equilibrada.
Aun así, resulta difícil negar que el conocimiento científico ha ampliado enormemente las posibilidades de la vida humana. La historia de la ciencia es, en gran medida, también la historia de una expansión continua de las capacidades materiales de la humanidad. Gracias a la ciencia, los seres humanos han aprendido a comprender la naturaleza y, al mismo tiempo, a transformar su entorno de maneras que generaciones anteriores apenas podían imaginar.
6.3. La ciencia como poder: quién controla el conocimiento
El conocimiento científico suele presentarse como una búsqueda desinteresada de la verdad, una actividad dedicada a comprender los procesos de la naturaleza y ampliar el horizonte del saber humano. En gran medida, esta visión es correcta: la investigación científica nace de la curiosidad intelectual y del deseo de comprender el mundo. Sin embargo, cuando ese conocimiento se traduce en tecnología y en capacidad de transformar la realidad, adquiere también una dimensión política, económica y estratégica. En ese momento, la ciencia deja de ser solo conocimiento y se convierte también en una forma de poder.
A lo largo de la historia moderna, los avances científicos han estado estrechamente vinculados al desarrollo de los Estados, de las economías y de las instituciones. Los grandes descubrimientos no surgen únicamente del esfuerzo individual de investigadores aislados; suelen desarrollarse dentro de sistemas complejos de financiación, universidades, centros de investigación, empresas tecnológicas y programas gubernamentales. Esto significa que la producción del conocimiento científico está, en gran medida, integrada en estructuras sociales y políticas.
El desarrollo de la ciencia moderna estuvo profundamente ligado al crecimiento de los Estados modernos y de las economías industriales. A medida que las sociedades comprendieron el valor estratégico del conocimiento científico, comenzaron a invertir recursos en investigación. Universidades, academias científicas y laboratorios se convirtieron en instituciones clave para el desarrollo del conocimiento y para la formación de especialistas capaces de impulsar la innovación.
En el mundo contemporáneo, esta relación entre ciencia y poder se ha intensificado. Los países que dominan determinadas tecnologías suelen ocupar posiciones de liderazgo en la economía global y en la política internacional. El control del conocimiento científico y tecnológico puede traducirse en ventajas económicas, militares o industriales que influyen en el equilibrio de poder entre las naciones.
El desarrollo de la energía nuclear en el siglo XX constituye un ejemplo especialmente claro de esta relación. El conocimiento físico que permitió comprender la estructura del átomo abrió la puerta tanto a la producción de energía nuclear como a la fabricación de armamento de enorme poder destructivo. Desde entonces, la investigación en este campo ha estado estrechamente ligada a decisiones políticas, estratégicas y militares.
Algo similar ocurre hoy con áreas como la inteligencia artificial, la biotecnología, la informática avanzada o la exploración espacial. Estas disciplinas no solo representan avances científicos, sino también campos de competencia entre Estados, empresas y centros de investigación que buscan dominar tecnologías con un enorme potencial económico y estratégico.
La financiación de la investigación científica refleja también esta dimensión del conocimiento como poder. Gran parte de los proyectos científicos dependen de recursos proporcionados por gobiernos, instituciones públicas o empresas privadas. Estas entidades deciden qué investigaciones se apoyan y cuáles quedan en segundo plano. En consecuencia, las prioridades científicas pueden verse influidas por intereses económicos, políticos o industriales.
Esto no significa necesariamente que la ciencia pierda su carácter intelectual o su vocación de búsqueda de la verdad. Pero sí implica que la investigación científica se desarrolla dentro de un entramado de decisiones sociales que determinan qué áreas reciben más atención, qué tecnologías se desarrollan con mayor rapidez y qué aplicaciones se consideran prioritarias.
Otro aspecto importante es la relación entre conocimiento y acceso. En principio, la ciencia se basa en la idea de que el conocimiento debe compartirse y difundirse para que otros investigadores puedan revisarlo, ampliarlo o cuestionarlo. Esta circulación abierta de ideas ha sido una de las claves del progreso científico. Sin embargo, en algunos campos tecnológicos el conocimiento puede convertirse en un recurso estratégico protegido por patentes, secretos industriales o restricciones de seguridad.
De este modo, el conocimiento científico se sitúa en una tensión constante entre dos principios: por un lado, la idea de que el saber debe ser compartido para impulsar el progreso colectivo; por otro, el interés de ciertos actores por controlar ese conocimiento para obtener ventajas económicas o estratégicas.
Esta situación plantea preguntas importantes sobre la gobernanza del conocimiento científico. ¿Debe el saber científico considerarse un bien común de la humanidad? ¿Hasta qué punto es legítimo que ciertas tecnologías queden en manos de unos pocos actores? ¿Cómo puede garantizarse que los avances científicos beneficien al conjunto de la sociedad y no solo a determinados intereses?
Estas cuestiones no tienen respuestas simples. La investigación científica requiere recursos, organización y planificación, lo que inevitablemente implica decisiones institucionales y políticas. Pero al mismo tiempo, la historia de la ciencia muestra que el progreso del conocimiento suele beneficiarse de entornos abiertos, donde las ideas pueden circular y ser discutidas libremente.
Comprender la ciencia como una forma de poder no significa desconfiar de ella, sino reconocer que el conocimiento tiene consecuencias reales en la organización de las sociedades. Las decisiones sobre investigación, tecnología e innovación influyen en la economía, en la política internacional y en el futuro de las civilizaciones.
Por esta razón, el debate sobre la ciencia no puede limitarse únicamente a cuestiones técnicas. También debe incluir reflexiones sobre quién decide las prioridades de investigación, quién controla las aplicaciones tecnológicas y cómo se distribuyen los beneficios del progreso científico.
En el mundo contemporáneo, donde el conocimiento se ha convertido en uno de los recursos más valiosos, estas preguntas adquieren una importancia creciente. La ciencia sigue siendo una herramienta fundamental para comprender la naturaleza, pero también es una fuente de poder que exige responsabilidad, transparencia y reflexión colectiva sobre su uso.
6.4. Riesgos modernos: contaminación, armas, manipulación biológica
El desarrollo científico y tecnológico ha ampliado enormemente las capacidades humanas. Gracias a la ciencia, las sociedades modernas han logrado avances extraordinarios en medicina, producción de energía, transporte, agricultura o comunicación. Sin embargo, ese mismo poder para transformar la naturaleza y manipular los procesos físicos o biológicos ha generado también nuevos riesgos. La ciencia no solo ha multiplicado nuestras posibilidades; también ha ampliado nuestra capacidad de alterar profundamente el equilibrio natural del planeta.
Uno de los riesgos más visibles es la contaminación ambiental. El desarrollo industrial de los últimos siglos, impulsado por el conocimiento científico y tecnológico, ha permitido producir bienes a gran escala y mejorar el nivel material de vida de muchas sociedades. Pero este progreso ha tenido también consecuencias inesperadas para los ecosistemas. La emisión de contaminantes en el aire, el vertido de residuos en ríos y mares o la acumulación de sustancias tóxicas en el suelo han alterado en muchos lugares el equilibrio natural de la biosfera.
La ciencia ha permitido identificar estos problemas y comprender sus causas. Los estudios sobre la atmósfera, los océanos o los ciclos biogeoquímicos han mostrado cómo ciertas actividades humanas pueden afectar al clima, a la biodiversidad o a la calidad del agua y del aire. Paradójicamente, el mismo conocimiento científico que hizo posible el desarrollo industrial es ahora esencial para comprender sus consecuencias y buscar soluciones sostenibles.
Otro ámbito donde el conocimiento científico ha generado riesgos potenciales es el de la tecnología militar. Desde la antigüedad, las sociedades han utilizado el conocimiento técnico para desarrollar armas cada vez más eficaces. Sin embargo, en la era moderna la combinación entre ciencia avanzada y tecnología militar ha alcanzado niveles de poder sin precedentes.
El desarrollo de armamento basado en principios físicos complejos —como las armas nucleares o ciertas tecnologías avanzadas de defensa— ha cambiado profundamente la naturaleza de los conflictos entre Estados. Estas armas poseen una capacidad destructiva que puede afectar no solo a ejércitos, sino a poblaciones enteras y a grandes regiones del planeta. Desde mediados del siglo XX, la posibilidad de destrucción a gran escala se ha convertido en uno de los principales desafíos de la política internacional.
La ciencia, en este contexto, aparece como una herramienta ambivalente. Los mismos conocimientos sobre física, química o ingeniería que permiten desarrollar tecnologías civiles útiles pueden también utilizarse con fines militares. Por esta razón, muchos científicos han reflexionado sobre la responsabilidad ética asociada a su trabajo y sobre el uso que puede hacerse de los descubrimientos científicos.
Un tercer campo de preocupación en el mundo contemporáneo es la manipulación biológica. El desarrollo de la genética y de la biología molecular ha abierto posibilidades extraordinarias para comprender los mecanismos de la vida. Hoy es posible analizar el genoma de los organismos, estudiar con gran precisión los procesos celulares e incluso modificar ciertos aspectos de la información genética.
Estos avances ofrecen oportunidades prometedoras en medicina, agricultura y biotecnología. Permiten desarrollar tratamientos para enfermedades, mejorar cultivos o comprender mejor el funcionamiento de los organismos vivos. Sin embargo, también plantean preguntas importantes sobre los límites de la intervención humana en los procesos biológicos.
La posibilidad de modificar organismos, manipular microorganismos o intervenir en el patrimonio genético de los seres vivos exige una reflexión cuidadosa. No se trata solo de una cuestión técnica, sino también ética y social. Las decisiones sobre el uso de estas tecnologías deben considerar tanto sus beneficios potenciales como los riesgos que podrían generar.
Estos tres ejemplos —contaminación ambiental, armamento avanzado y manipulación biológica— muestran que el progreso científico no es un proceso simple ni lineal. Cada avance abre nuevas posibilidades, pero también plantea nuevas responsabilidades. El conocimiento amplía nuestra capacidad de actuar sobre el mundo, pero esa capacidad debe ir acompañada de una reflexión sobre sus consecuencias.
En este sentido, los riesgos asociados al desarrollo científico no provienen de la ciencia en sí misma, sino del uso que los seres humanos hacen de ese conocimiento. La ciencia proporciona herramientas para comprender la naturaleza y transformarla; la manera en que esas herramientas se utilizan depende de decisiones humanas, sociales y políticas.
Por esta razón, el progreso científico debe ir acompañado de instituciones capaces de regular el uso de ciertas tecnologías, de acuerdos internacionales que limiten los riesgos y de una cultura ética que reconozca la responsabilidad asociada al conocimiento. La historia reciente muestra que la cooperación internacional y la reflexión ética pueden desempeñar un papel importante para evitar usos peligrosos del conocimiento científico.
El desafío del mundo contemporáneo consiste en encontrar un equilibrio entre el avance del conocimiento y la gestión responsable de sus consecuencias. La ciencia ha ampliado enormemente el poder humano sobre la naturaleza, pero ese poder debe ejercerse con prudencia y con una visión de largo plazo.
Comprender los riesgos asociados al progreso científico no significa rechazar la ciencia, sino reconocer que el conocimiento exige responsabilidad. El mismo saber que permite mejorar la vida humana puede también alterar profundamente el equilibrio del planeta si se utiliza sin reflexión ni control.
6.5. Responsabilidad humana: ética científica y límites morales
A medida que el conocimiento científico ha ampliado la capacidad humana para intervenir en la naturaleza, también ha crecido la necesidad de reflexionar sobre las responsabilidades asociadas a ese poder. La ciencia permite comprender los procesos del mundo físico y biológico, pero la decisión sobre cómo utilizar ese conocimiento pertenece al ámbito de la ética y de la reflexión moral. En otras palabras, el progreso científico plantea inevitablemente la pregunta sobre los límites del poder humano.
Durante gran parte de la historia, la capacidad de transformar el entorno natural era relativamente limitada. Las sociedades humanas podían modificar su entorno inmediato, pero el impacto global de esas acciones era reducido. En el mundo contemporáneo, la situación es muy distinta. La combinación entre ciencia avanzada y tecnología ha otorgado a la humanidad una capacidad de intervención sobre la naturaleza que no tiene precedentes en la historia.
Hoy es posible alterar ecosistemas completos, modificar organismos vivos, manipular el patrimonio genético o desarrollar tecnologías capaces de influir en el funcionamiento del planeta a gran escala. Este poder abre oportunidades extraordinarias para mejorar la vida humana, pero también plantea riesgos si se ejerce sin reflexión o sin control.
Por esta razón, el desarrollo científico ha ido acompañado progresivamente de un debate ético sobre los límites del conocimiento aplicado. La ética científica intenta responder a una pregunta fundamental: no solo qué podemos hacer gracias al conocimiento, sino qué debemos hacer y qué acciones deberían considerarse moralmente inaceptables.
Uno de los primeros ámbitos en los que surgió esta reflexión fue la medicina. A lo largo del siglo XX, el desarrollo de nuevas técnicas médicas planteó cuestiones delicadas relacionadas con la experimentación, el consentimiento de los pacientes o el uso de ciertos tratamientos. Estos debates llevaron a establecer principios éticos destinados a proteger la dignidad y los derechos de las personas en la investigación médica.
Con el tiempo, este tipo de reflexiones se extendió a otros campos de la ciencia. La investigación genética, por ejemplo, ha abierto la posibilidad de intervenir directamente en la información hereditaria de los seres vivos. Estas tecnologías ofrecen perspectivas prometedoras para el tratamiento de enfermedades, pero también plantean interrogantes sobre hasta qué punto es legítimo modificar ciertos aspectos de la vida.
De manera similar, el desarrollo de nuevas tecnologías energéticas, industriales o informáticas obliga a considerar sus consecuencias sociales y ambientales. La ciencia puede ofrecer soluciones técnicas, pero la evaluación de sus efectos a largo plazo requiere una reflexión más amplia sobre el bienestar humano y sobre el equilibrio del planeta.
En este contexto, la ética científica no pretende frenar el progreso del conocimiento, sino orientarlo de forma responsable. El objetivo no es limitar la investigación por miedo al descubrimiento, sino asegurar que el uso del conocimiento respete ciertos principios fundamentales: la protección de la vida, la dignidad de las personas, la preservación del entorno natural y el bienestar de las generaciones futuras.
Un aspecto importante de esta reflexión es reconocer que la ciencia, por sí sola, no puede determinar los valores que deben guiar su aplicación. Las ciencias naturales describen hechos y procesos; la ética reflexiona sobre lo que es justo, correcto o deseable. Por esta razón, el diálogo entre científicos, filósofos, juristas y representantes de la sociedad resulta esencial para establecer normas que orienten el desarrollo tecnológico.
La historia reciente muestra que este diálogo puede dar lugar a acuerdos y regulaciones importantes. Existen tratados internacionales que limitan el uso de determinadas armas, normas que regulan la investigación biomédica o políticas destinadas a proteger el medio ambiente. Estos mecanismos reflejan el reconocimiento de que el conocimiento científico debe integrarse dentro de un marco de responsabilidad colectiva.
Otro elemento fundamental es la conciencia individual de los propios científicos. Muchos investigadores han reflexionado sobre el impacto potencial de su trabajo y han defendido la necesidad de mantener una actitud ética en la práctica científica. La responsabilidad no recae únicamente en las instituciones o en los gobiernos; también forma parte de la cultura profesional de la comunidad científica.
En última instancia, la cuestión de los límites morales del conocimiento científico está ligada a una reflexión más amplia sobre el lugar del ser humano en el mundo. La ciencia ha permitido comprender la naturaleza con una profundidad extraordinaria, pero ese conocimiento también nos recuerda que formamos parte de un sistema natural complejo y delicado.
La capacidad de intervenir en ese sistema exige prudencia y sentido de responsabilidad. El progreso científico solo puede considerarse verdaderamente beneficioso cuando se acompaña de una reflexión ética que tenga en cuenta no solo las posibilidades técnicas, sino también las consecuencias humanas y ambientales de nuestras decisiones.
En el mundo contemporáneo, la ciencia ha ampliado el poder humano sobre la naturaleza de manera espectacular. Pero cuanto mayor es ese poder, mayor es también la responsabilidad que lo acompaña. El desafío de nuestro tiempo consiste en aprender a utilizar el conocimiento científico con sabiduría, integrándolo dentro de una visión ética que reconozca los límites y las responsabilidades de la acción humana.
6.7. La ciencia como parte de la cultura, no como enemigo de la cultura
En muchas ocasiones se ha presentado la ciencia y la cultura humanística como si pertenecieran a mundos distintos o incluso enfrentados. Según esta visión simplificada, la ciencia estaría asociada al cálculo, a la técnica y al conocimiento objetivo, mientras que la cultura —entendida como arte, filosofía, literatura o pensamiento humanístico— representaría el ámbito de la sensibilidad, la creatividad o la reflexión sobre el sentido de la existencia. Esta oposición, sin embargo, es en gran medida artificial. La ciencia no es un elemento ajeno a la cultura humana, sino una de sus expresiones más profundas.
La cultura, en su sentido más amplio, incluye todas las formas mediante las cuales los seres humanos intentan comprender el mundo y dar sentido a su experiencia. Dentro de esa búsqueda se encuentran las tradiciones filosóficas, las religiones, las obras artísticas, la literatura, las instituciones sociales y también el conocimiento científico. Todas ellas forman parte del mismo impulso humano por explorar la realidad y por situarse dentro de ella.
Desde esta perspectiva, la ciencia puede entenderse como una forma particular de cultura, caracterizada por un método específico de investigación. Su rasgo distintivo no es el tema que estudia —la naturaleza— sino la manera en que aborda ese estudio: mediante la observación rigurosa, la experimentación y la construcción de teorías que puedan contrastarse con la experiencia. Este método ha permitido alcanzar un conocimiento muy preciso de numerosos procesos naturales, pero sigue siendo una actividad profundamente humana, nacida de la curiosidad intelectual y del deseo de comprender.
A lo largo de la historia, las grandes culturas han integrado conocimiento científico y pensamiento humanístico sin percibirlos como ámbitos separados. En la Grecia antigua, los filósofos reflexionaban al mismo tiempo sobre la naturaleza, la política, la ética o el arte. Durante el Renacimiento, artistas, ingenieros y pensadores participaban en un mismo ambiente intelectual donde la observación del mundo natural inspiraba tanto descubrimientos científicos como obras artísticas.
Incluso en la época moderna, muchos científicos han mostrado una profunda sensibilidad cultural. Algunos de los grandes investigadores de la historia no se limitaron a desarrollar teorías técnicas; también reflexionaron sobre el significado de sus descubrimientos, sobre la belleza de las leyes naturales o sobre el lugar del ser humano en el universo. Para muchos de ellos, el estudio de la naturaleza despertaba un sentimiento de asombro que se acerca tanto a la experiencia estética como a la investigación racional.
El conocimiento científico puede ampliar de manera extraordinaria nuestra percepción del mundo. Saber que las estrellas son sistemas solares lejanos, comprender la historia evolutiva de la vida o conocer la estructura del átomo no reduce la belleza del universo; al contrario, la profundiza. La ciencia revela dimensiones de la realidad que antes permanecían ocultas, y esa revelación puede despertar una admiración intelectual comparable a la que produce una gran obra de arte.
Por esta razón, algunos pensadores han insistido en que el conocimiento científico no empobrece la experiencia humana, sino que la enriquece. Comprender cómo funciona la naturaleza no elimina el misterio del mundo; más bien lo transforma en un misterio más profundo, donde cada descubrimiento abre nuevas preguntas sobre la complejidad del universo.
El problema surge cuando se intenta separar artificialmente la ciencia del resto de la cultura o cuando se la presenta como una amenaza para las humanidades. Esta oposición puede aparecer tanto desde quienes desconfían del conocimiento científico como desde quienes consideran que la ciencia debería sustituir a todas las demás formas de pensamiento. En ambos casos se pierde de vista que la cultura humana es un sistema complejo en el que diferentes formas de conocimiento se complementan.
La ciencia proporciona una comprensión rigurosa de los procesos naturales. Las humanidades, por su parte, exploran el significado de la experiencia humana, las tradiciones culturales, los valores éticos y las expresiones artísticas. Ninguna de estas dimensiones puede sustituir completamente a las otras. El conocimiento humano se vuelve más rico precisamente cuando estas perspectivas dialogan entre sí.
En el mundo contemporáneo, donde la tecnología influye cada vez más en la vida cotidiana, resulta especialmente importante mantener ese equilibrio cultural. Una sociedad que valore únicamente el progreso técnico corre el riesgo de olvidar las preguntas sobre el sentido, la justicia o la belleza. Pero una sociedad que rechace el conocimiento científico se vuelve incapaz de comprender los procesos que determinan el funcionamiento del mundo natural.
Por ello, la ciencia debe entenderse como una parte esencial de la cultura moderna. No es un saber frío o aislado, sino una de las formas más poderosas mediante las cuales la humanidad ha aprendido a explorar la realidad. Integrada con la filosofía, el arte, la historia y las demás disciplinas humanísticas, contribuye a construir una visión más amplia y profunda de la experiencia humana.
En última instancia, ciencia y cultura forman parte de la misma aventura intelectual: el esfuerzo continuo por comprender el mundo y por situar al ser humano dentro de la inmensa complejidad del universo.
7.1. La naturaleza como hogar y como misterio.
7.2. La ciencia como conquista intelectual de la humanidad.
7.3. La visión unificada: física, química, vida y cosmos.
7.4. Conocer para cuidar: saber y responsabilidad.
7.5. Una idea final: el mundo es más comprensible de lo que parece.

La naturaleza como un sistema único donde se entrelazan el cosmos, la vida y el conocimiento humano: del átomo a las galaxias, la ciencia revela la profunda unidad del universo.
La exploración científica ha permitido al ser humano descubrir que la realidad, pese a su inmensa diversidad, forma parte de un mismo sistema natural. La materia que compone las estrellas es la misma que forma los átomos de nuestro cuerpo; los procesos físicos que rigen el cosmos se conectan con la química de la vida y con la evolución de los seres vivos en la Tierra. A través de la ciencia, la humanidad ha aprendido a contemplar la naturaleza como una red de relaciones que une el universo, la vida y la conciencia humana. Este conocimiento no solo amplía nuestra comprensión del mundo, sino que también invita a una reflexión más profunda sobre nuestra responsabilidad dentro de ese mismo sistema natural del que formamos parte.
7. Conclusión
Al llegar al final de este recorrido por las ciencias naturales, resulta inevitable detenerse un momento y contemplar el conjunto del camino recorrido. A lo largo de este estudio hemos observado cómo el ser humano ha intentado comprender la naturaleza desde múltiples perspectivas: explorando la materia, estudiando la vida, investigando los procesos del universo y reflexionando sobre el lugar que ocupa nuestra especie dentro de esa inmensa realidad.
La naturaleza aparece, en este contexto, como un escenario extraordinariamente complejo. Desde las partículas elementales que componen la materia hasta las galaxias que pueblan el cosmos, el universo está formado por una red de procesos interconectados que se desarrollan a lo largo de escalas de tiempo y de espacio difíciles de imaginar. Durante miles de millones de años, estos procesos se han desplegado silenciosamente, dando lugar a la formación de estrellas, planetas, océanos, ecosistemas y finalmente a la aparición de la vida.
Dentro de esta vasta historia natural, el ser humano representa un episodio relativamente reciente. Sin embargo, posee una característica singular: la capacidad de preguntarse por el mundo que lo rodea. A diferencia de otros organismos, nuestra especie no se limita a vivir en la naturaleza; también intenta comprenderla. La curiosidad, la observación y la reflexión han llevado a los seres humanos a desarrollar conocimientos cada vez más precisos sobre el funcionamiento del universo.
Este esfuerzo intelectual ha dado lugar a una de las grandes aventuras de la historia humana: el nacimiento y el desarrollo de la ciencia. Gracias a ella hemos aprendido a interpretar los movimientos de los astros, a comprender la estructura de la materia, a estudiar los procesos químicos que sostienen la vida y a reconstruir la historia evolutiva de los seres vivos. Poco a poco, el conocimiento científico ha ido revelando que el universo no es un conjunto caótico de fenómenos aislados, sino un sistema regido por leyes y procesos que pueden investigarse y comprenderse.
Uno de los descubrimientos más fascinantes que ha aportado la ciencia es la profunda unidad de la naturaleza. La física, la química y la biología, que durante mucho tiempo se desarrollaron como disciplinas separadas, han mostrado progresivamente que forman parte de un mismo entramado de procesos naturales. Los átomos estudiados por la física y la química constituyen la base de las moléculas que permiten la existencia de la vida. Los organismos vivos, a su vez, evolucionan dentro de un planeta que forma parte de un sistema cósmico mucho más amplio.
Esta visión unificada del mundo natural ha transformado profundamente nuestra comprensión del universo. Hoy sabemos que la materia de nuestro cuerpo procede de elementos formados en el interior de antiguas estrellas, que la vida en la Tierra surgió a partir de procesos químicos complejos y que nuestra especie es el resultado de una larga historia evolutiva que conecta a todos los seres vivos.
Sin embargo, este conocimiento no solo amplía nuestra comprensión intelectual; también plantea nuevas responsabilidades. A medida que la ciencia ha aumentado nuestra capacidad de intervenir en la naturaleza, ha quedado claro que las acciones humanas pueden tener consecuencias profundas para el equilibrio del planeta. El desarrollo tecnológico ha permitido mejorar enormemente las condiciones de vida, pero también ha puesto de manifiesto la fragilidad de los ecosistemas y la necesidad de gestionar los recursos naturales con prudencia.
Comprender la naturaleza implica también reconocer que formamos parte de ella. El ser humano no es un observador externo del mundo natural, sino uno de sus elementos. Nuestra supervivencia depende de la estabilidad de los sistemas ecológicos que sostienen la vida en la Tierra. Por esta razón, el conocimiento científico puede convertirse en una herramienta fundamental no solo para comprender el mundo, sino también para protegerlo.
En última instancia, el estudio de las ciencias naturales nos invita a adoptar una mirada más amplia sobre la realidad. El universo aparece ante nosotros como un sistema extraordinariamente complejo, pero también sorprendentemente comprensible. A través del esfuerzo acumulado de generaciones de investigadores, la humanidad ha logrado descifrar muchos de los procesos que estructuran la naturaleza.
Aun así, el conocimiento humano sigue siendo parcial y provisional. Cada descubrimiento abre nuevas preguntas y revela dimensiones de la realidad que aún permanecen inexploradas. La ciencia no ofrece respuestas definitivas a todos los misterios del universo, pero sí proporciona un método poderoso para acercarnos progresivamente a su comprensión.
En este sentido, el estudio de la naturaleza no es solo una acumulación de datos o teorías, sino también una experiencia intelectual que despierta una profunda sensación de asombro. Cuanto más aprendemos sobre el universo, más evidente se vuelve su extraordinaria complejidad y belleza.
La naturaleza es, al mismo tiempo, nuestro hogar y un vasto misterio que seguimos intentando comprender. Y quizá uno de los rasgos más admirables de la humanidad sea precisamente ese impulso constante por observar, preguntar y aprender.
En las páginas que siguen, este epílogo abordará algunas ideas finales que sintetizan el significado de este recorrido: la naturaleza como hogar y como misterio, la ciencia como una de las grandes conquistas intelectuales de la humanidad, la visión unificada de los procesos naturales y la responsabilidad que acompaña al conocimiento. En conjunto, estas reflexiones invitan a contemplar el mundo con una mirada más consciente, donde comprender la naturaleza se convierte también en una forma de cuidar el lugar que habitamos.
7.1. La naturaleza como hogar y como misterio
Para el ser humano, la naturaleza ha sido siempre algo doble: nuestro hogar y, al mismo tiempo, un profundo misterio. Desde los primeros grupos humanos que habitaron bosques, montañas y llanuras, hasta las sociedades tecnológicas actuales, la vida humana ha dependido por completo de los sistemas naturales que sostienen la existencia en la Tierra. El aire que respiramos, el agua que bebemos, los alimentos que nos nutren y la energía que permite el funcionamiento del planeta forman parte de una red de procesos naturales de los que dependemos de manera absoluta.
Durante la mayor parte de la historia, esa dependencia se percibía de forma inmediata. Las estaciones, el clima, los ciclos de los ríos o el comportamiento de los animales condicionaban directamente la vida de las comunidades humanas. La naturaleza era un entorno cercano, poderoso y a menudo imprevisible. De ella procedían tanto los recursos que permitían vivir como los peligros que podían amenazar la supervivencia.
Con el desarrollo de la civilización, especialmente a partir de la revolución industrial, muchas sociedades comenzaron a experimentar una cierta sensación de distancia respecto al mundo natural. Las ciudades, la tecnología y los sistemas industriales crearon entornos cada vez más artificiales donde los procesos naturales parecían quedar ocultos tras la infraestructura humana. Sin embargo, esta impresión es en gran medida ilusoria. Incluso en las sociedades más tecnológicas, la vida humana sigue dependiendo completamente de los sistemas naturales que hacen posible la existencia en el planeta.
La ciencia moderna ha contribuido a revelar con mayor claridad esta dependencia. El estudio de la ecología ha mostrado que la vida en la Tierra se sostiene gracias a una compleja red de relaciones entre organismos, ecosistemas y procesos físicos. La atmósfera regula la temperatura del planeta, los océanos influyen en el clima global, las plantas producen el oxígeno que respiramos y los ciclos naturales permiten la renovación constante de los recursos biológicos.
Comprender estos procesos ha cambiado profundamente nuestra percepción del planeta. La Tierra ya no aparece solo como el escenario donde se desarrolla la vida humana, sino como un sistema dinámico en el que todos los elementos están interconectados. La biosfera, la hidrosfera, la atmósfera y la geosfera forman un conjunto de procesos que se influyen mutuamente y que hacen posible la existencia de la vida.
En este sentido, la naturaleza puede entenderse verdaderamente como nuestro hogar. No se trata simplemente de un entorno externo al ser humano, sino del sistema del que formamos parte y del que depende nuestra propia existencia. Cada ser humano, cada organismo vivo y cada ecosistema participa en esa compleja red de relaciones que sostienen la vida en el planeta.
Pero al mismo tiempo, la naturaleza sigue siendo también un misterio. A pesar de los enormes avances del conocimiento científico, el universo conserva una profundidad que continúa desafiando nuestra comprensión. Sabemos mucho más que las generaciones anteriores sobre la estructura de la materia, la evolución de la vida o la historia del cosmos, pero cada descubrimiento abre nuevas preguntas.
La ciencia ha mostrado, por ejemplo, que el universo es mucho más vasto de lo que las culturas antiguas pudieron imaginar. Miles de millones de galaxias pueblan el cosmos, cada una de ellas formada por miles de millones de estrellas. En ese escenario inmenso, nuestro planeta aparece como un pequeño punto azul donde, de manera extraordinaria, ha surgido la vida y la conciencia.
Del mismo modo, el estudio de la vida ha revelado niveles de complejidad biológica que todavía estamos lejos de comprender por completo. Desde el funcionamiento de las células hasta la organización de los ecosistemas, la naturaleza muestra una riqueza de procesos que continúa sorprendiendo a los investigadores.
Este doble carácter —hogar y misterio— es una de las razones por las que el estudio de la naturaleza ha fascinado a la humanidad durante milenios. Vivimos dentro de un sistema natural que sostiene nuestra existencia, pero cuya complejidad supera continuamente nuestra comprensión completa.
Lejos de reducir el misterio del mundo, el conocimiento científico a menudo lo profundiza. Cuanto más aprendemos sobre la naturaleza, más evidente se vuelve su extraordinaria riqueza. Cada nivel de explicación revela nuevas capas de procesos que invitan a seguir investigando.
Por esta razón, contemplar la naturaleza como hogar y como misterio puede inspirar una actitud particular hacia el mundo natural. Por un lado, invita al respeto hacia los sistemas que sostienen la vida. Por otro, despierta una curiosidad intelectual que impulsa a seguir explorando y comprendiendo la realidad que nos rodea.
El ser humano habita un planeta extraordinario dentro de un universo inmenso. Comprender la naturaleza significa reconocer al mismo tiempo nuestra pertenencia a ese sistema y la profundidad del misterio que todavía encierra.
7.2. La ciencia como conquista intelectual de la humanidad
Entre las muchas realizaciones de la civilización humana, pocas pueden compararse con el desarrollo del conocimiento científico. A lo largo de los siglos, la ciencia ha representado una de las más notables conquistas intelectuales de la humanidad: un esfuerzo colectivo por comprender el mundo natural mediante la observación, el razonamiento y la investigación sistemática. No se trata simplemente de un conjunto de datos o de teorías acumuladas, sino de una forma de conocimiento que ha transformado profundamente la manera en que los seres humanos interpretan la realidad.
Durante la mayor parte de la historia, el mundo natural aparecía ante los seres humanos como un escenario lleno de fenómenos difíciles de explicar. El movimiento de los astros, las tormentas, las enfermedades o los cambios de las estaciones podían interpretarse mediante relatos míticos, tradiciones culturales o explicaciones simbólicas que intentaban dar sentido a esos acontecimientos. Estas formas de interpretación formaron parte de las primeras maneras humanas de comprender la naturaleza.
Sin embargo, con el tiempo surgió una nueva forma de aproximarse al mundo: la idea de que los fenómenos naturales podían investigarse mediante la observación cuidadosa y el razonamiento crítico. Esta actitud intelectual comenzó a desarrollarse en algunas civilizaciones antiguas y adquirió una forma especialmente influyente en el pensamiento griego, donde filósofos y observadores de la naturaleza intentaron buscar explicaciones racionales para los procesos del mundo.
El desarrollo de la ciencia moderna, especialmente a partir de los siglos XVI y XVII, representó un paso decisivo en esta dirección. La combinación entre observación sistemática, experimentación y formulación de leyes naturales permitió comprender fenómenos que durante siglos habían permanecido envueltos en el misterio. La astronomía reveló la estructura del sistema solar; la física comenzó a explicar el movimiento de los cuerpos; la química investigó la composición de la materia; y más tarde la biología exploró la complejidad de los organismos vivos.
Este proceso de investigación no fue obra de una sola persona ni de una sola generación. La ciencia es una empresa profundamente colectiva, construida a lo largo del tiempo por miles de investigadores que han contribuido con observaciones, teorías, experimentos y debates intelectuales. Cada descubrimiento se apoya en el trabajo anterior y abre nuevas posibilidades para futuras investigaciones.
Uno de los aspectos más admirables de la ciencia es su carácter acumulativo. A diferencia de otras formas de conocimiento que pueden permanecer relativamente estables durante largos periodos, la ciencia avanza mediante un proceso continuo de revisión y mejora. Las teorías se someten a pruebas, se contrastan con la experiencia y se modifican cuando aparecen nuevos datos. Este proceso de crítica y corrección constante ha permitido construir un conocimiento cada vez más preciso sobre la naturaleza.
Gracias a este esfuerzo intelectual sostenido, la humanidad ha logrado comprender aspectos fundamentales del universo que antes resultaban inaccesibles. Sabemos que la Tierra forma parte de un sistema planetario que gira alrededor del Sol, que la materia está compuesta por átomos y partículas elementales, que la vida ha evolucionado a lo largo de millones de años y que el universo mismo tiene una historia que se remonta a miles de millones de años.
Estos descubrimientos no solo han ampliado el conocimiento humano; también han cambiado profundamente nuestra visión del mundo y de nosotros mismos. La ciencia ha mostrado que la humanidad forma parte de un universo vasto y dinámico, donde los procesos naturales siguen leyes que pueden investigarse y comprenderse.
Además, el conocimiento científico ha permitido desarrollar tecnologías que han transformado radicalmente la vida humana. La medicina moderna, los sistemas de comunicación, la producción de energía o los medios de transporte son ejemplos de cómo la investigación científica puede traducirse en mejoras concretas para la sociedad.
Pero más allá de sus aplicaciones prácticas, la ciencia representa también un logro cultural de gran importancia. Constituye una forma de pensamiento basada en la curiosidad, en la búsqueda de evidencias y en la disposición a revisar nuestras propias ideas cuando aparecen nuevos datos. Este modo de pensar ha contribuido a fomentar una actitud crítica y abierta hacia el conocimiento.
Por todo ello, puede decirse que la ciencia es una de las grandes conquistas intelectuales de la humanidad. No solo porque ha permitido comprender mejor la naturaleza, sino también porque ha creado un método para explorar la realidad de manera sistemática y compartida.
La aventura científica continúa en el presente. Cada generación de investigadores se enfrenta a nuevos desafíos y a nuevas preguntas sobre el universo, la vida y la materia. El conocimiento humano sigue creciendo, y con él se amplía también nuestra capacidad para comprender el mundo.
En este sentido, la ciencia no es una obra terminada, sino un proceso en permanente desarrollo. Representa el esfuerzo continuo de la humanidad por descifrar los secretos de la naturaleza y por ampliar los límites de su comprensión del universo.
7.3. La visión unificada: física, química, vida y cosmos
Uno de los logros más profundos del conocimiento científico ha sido revelar que los distintos aspectos de la naturaleza no constituyen mundos separados, sino partes de una misma realidad interconectada. Durante mucho tiempo, las ciencias naturales se desarrollaron como disciplinas relativamente independientes: la física estudiaba las leyes fundamentales de la materia y la energía, la química analizaba las transformaciones de las sustancias, y la biología se ocupaba de los organismos vivos. Cada una de estas áreas parecía describir un nivel distinto de la naturaleza.
Sin embargo, a medida que el conocimiento científico fue avanzando, comenzó a aparecer una visión más amplia: los procesos que estudian estas disciplinas forman parte de una misma cadena de fenómenos naturales que se extiende desde el origen del universo hasta la aparición de la vida en la Tierra. Lo que en un primer momento parecía una fragmentación del conocimiento terminó revelando una profunda unidad en la estructura del mundo natural.
La física se ocupa de las leyes más fundamentales del universo. Estudia las propiedades de la materia, el comportamiento de la energía, las fuerzas que gobiernan el movimiento de los cuerpos y los procesos que estructuran el cosmos. Gracias a la física sabemos que las estrellas nacen, evolucionan y mueren a lo largo de enormes escalas de tiempo, y que en el interior de estas estrellas se forman muchos de los elementos químicos que componen el universo.
La química aparece, en cierto sentido, como una prolongación de estos procesos físicos. Cuando las partículas elementales se combinan para formar átomos y los átomos se unen en moléculas, surgen nuevas propiedades y nuevas formas de organización de la materia. La química estudia precisamente estas combinaciones y transformaciones que permiten la formación de sustancias cada vez más complejas.
A partir de esa complejidad molecular surge otro nivel de organización: la vida. Los organismos vivos están formados por estructuras químicas extremadamente sofisticadas que interactúan entre sí de maneras altamente organizadas. Las células, las proteínas, el ADN y los sistemas metabólicos que sostienen la vida se basan en principios químicos y físicos que operan dentro de los organismos.
La biología estudia estos sistemas vivos, su funcionamiento interno y su evolución a lo largo del tiempo. Sin embargo, incluso en este nivel de la naturaleza siguen presentes los principios fundamentales que rigen la materia y la energía. Los procesos biológicos no están separados del resto de la naturaleza; forman parte de una continuidad que conecta la física, la química y la vida.
Esta continuidad se hace especialmente evidente cuando se observa la historia del universo en su conjunto. El cosmos comenzó con condiciones físicas muy simples, pero con el paso del tiempo surgieron estructuras cada vez más complejas. Primero se formaron las estrellas y las galaxias; más tarde aparecieron sistemas planetarios; y en algunos de esos planetas se desarrollaron las condiciones necesarias para el surgimiento de la vida.
En este contexto, la vida puede entenderse como una forma particularmente compleja de organización de la materia, surgida a partir de los mismos procesos físicos y químicos que operan en todo el universo. El carbono, el oxígeno, el nitrógeno y muchos otros elementos que forman los organismos vivos se originaron en procesos cósmicos que tuvieron lugar mucho antes de la formación de la Tierra.
Esta perspectiva ha llevado a muchos científicos a hablar de una visión unificada de la naturaleza, donde los distintos niveles de la realidad —desde las partículas elementales hasta los ecosistemas— se comprenden como etapas de una misma historia natural. La física describe las leyes fundamentales del universo, la química explica cómo se combinan los elementos y la biología estudia las formas de vida que surgen a partir de esas combinaciones.
La cosmología, por su parte, amplía esta visión hacia las escalas más grandes del universo, permitiendo reconstruir la evolución del cosmos desde sus primeros momentos hasta la formación de las estructuras actuales. De este modo, el conocimiento científico conecta procesos que van desde lo infinitamente pequeño hasta lo inmensamente grande.
Esta visión integrada de la naturaleza representa uno de los grandes logros intelectuales de la ciencia moderna. Gracias a ella, el universo aparece no como un conjunto fragmentado de fenómenos aislados, sino como un sistema coherente en el que los distintos niveles de organización se relacionan entre sí.
Para el ser humano, esta comprensión tiene también un significado profundo. Significa reconocer que la vida en la Tierra forma parte de una historia mucho más amplia que comenzó en el propio universo. Los mismos procesos físicos que dieron origen a las estrellas están conectados, a través de una larga cadena de transformaciones, con la aparición de la vida y con la conciencia humana.
En este sentido, la visión unificada de la naturaleza nos invita a contemplar el mundo con una perspectiva más amplia. Física, química, vida y cosmos no son dominios separados, sino capítulos distintos de una misma historia natural que continúa desarrollándose.
7.4. Conocer para cuidar: saber y responsabilidad
El conocimiento de la naturaleza no es únicamente una empresa intelectual destinada a satisfacer la curiosidad humana. Comprender cómo funciona el mundo natural tiene también una dimensión práctica y moral. A medida que la ciencia ha ampliado nuestra comprensión de los procesos físicos, biológicos y ecológicos, también ha revelado con mayor claridad la profunda dependencia que la humanidad mantiene con el equilibrio de la naturaleza. Conocer la naturaleza implica, en cierto sentido, asumir la responsabilidad de cuidarla.
Durante gran parte de la historia, los seres humanos actuaron sobre su entorno sin comprender plenamente las consecuencias de sus acciones. Las sociedades modificaban paisajes, explotaban recursos o transformaban ecosistemas sin disponer de un conocimiento detallado de los complejos procesos que sostienen la vida en el planeta. En muchos casos, los efectos de estas acciones eran limitados debido a la escala relativamente pequeña de las actividades humanas.
Sin embargo, el desarrollo científico y tecnológico de los últimos siglos ha cambiado radicalmente esta situación. Hoy la humanidad posee una capacidad de intervención sobre la naturaleza que no tiene precedentes. La agricultura intensiva, la explotación de recursos energéticos, la industrialización y el crecimiento urbano han transformado profundamente amplias regiones del planeta. Estas transformaciones han mejorado las condiciones de vida de muchas sociedades, pero también han generado impactos ambientales que ahora comprendemos con mayor claridad.
La ciencia ha desempeñado un papel fundamental en la identificación de estos procesos. Gracias a la investigación científica sabemos que los ecosistemas funcionan como redes complejas de relaciones entre organismos, suelos, agua, clima y energía. Alterar uno de estos elementos puede tener consecuencias que se extienden a todo el sistema. Los estudios ecológicos han mostrado que la estabilidad de la biosfera depende del equilibrio entre múltiples procesos naturales que se desarrollan a lo largo del tiempo.
Este conocimiento nos permite comprender que la Tierra no es simplemente un conjunto de recursos disponibles para la explotación humana, sino un sistema delicado del que depende nuestra propia supervivencia. El aire que respiramos, el agua que bebemos, los suelos que producen alimentos y los océanos que regulan el clima forman parte de un entramado natural que sostiene la vida en el planeta.
En este contexto, el conocimiento científico se convierte en una herramienta esencial para orientar nuestras decisiones. Comprender cómo funcionan los ecosistemas, cómo se regeneran los recursos naturales o cómo afectan ciertas actividades humanas al equilibrio ambiental permite diseñar formas de desarrollo más sostenibles. El saber científico ofrece información valiosa para gestionar los recursos del planeta con mayor prudencia.
Pero el conocimiento, por sí solo, no garantiza que las decisiones humanas sean responsables. Saber cómo funcionan los sistemas naturales es una condición necesaria, pero no suficiente. También se requiere una reflexión ética sobre el uso de ese conocimiento. Las sociedades deben decidir cómo equilibrar las necesidades económicas, el bienestar humano y la conservación de los sistemas naturales que hacen posible la vida.
En este sentido, el conocimiento científico puede contribuir a despertar una nueva conciencia sobre la relación entre la humanidad y la naturaleza. Comprender la complejidad del planeta y la interdependencia de los procesos naturales invita a adoptar una actitud de mayor respeto hacia el entorno natural.
La idea de que conocer la naturaleza implica también cuidarla se basa en una intuición profunda: cuando entendemos mejor algo, somos más conscientes de su valor y de su fragilidad. La ciencia no solo revela la estructura del mundo natural; también muestra la extraordinaria complejidad de los sistemas que sostienen la vida.
Esta comprensión puede inspirar una relación más equilibrada entre la humanidad y su entorno. En lugar de considerar la naturaleza únicamente como un recurso a explotar, el conocimiento científico invita a verla como un sistema del que formamos parte y cuya estabilidad es esencial para nuestro futuro.
El desafío del mundo contemporáneo consiste precisamente en integrar el progreso científico y tecnológico con una gestión responsable del planeta. La ciencia ha ampliado enormemente nuestras capacidades, pero también ha revelado los límites ecológicos dentro de los cuales se desarrolla la vida en la Tierra.
Por ello, conocer la naturaleza no debe entenderse solo como una conquista intelectual, sino también como una llamada a la responsabilidad. El saber científico puede convertirse en una guía para orientar nuestras acciones hacia un equilibrio más sostenible entre desarrollo humano y preservación del mundo natural.
En última instancia, el conocimiento de la naturaleza nos recuerda que el planeta no es simplemente el escenario de la actividad humana. Es el sistema vivo que hace posible nuestra existencia. Comprenderlo mejor puede ayudarnos a protegerlo con mayor sabiduría y a reconocer que cuidar la naturaleza es, en última instancia, cuidar también nuestro propio futuro.
7.5. Una idea final: el mundo es más comprensible de lo que parece
Al contemplar la naturaleza en toda su magnitud —desde la inmensidad del cosmos hasta la complejidad de la vida— es fácil sentir que el universo es demasiado vasto y demasiado complejo para ser comprendido por la mente humana. Durante milenios, muchas culturas percibieron el mundo natural como un escenario lleno de fuerzas misteriosas e imprevisibles, donde los fenómenos parecían escapar a cualquier explicación racional. Tormentas, eclipses, enfermedades o terremotos se interpretaban a menudo como manifestaciones de poderes desconocidos que escapaban completamente al entendimiento humano.
Sin embargo, una de las lecciones más sorprendentes que ha aportado la ciencia es que, pese a su enorme complejidad, el universo posee una estructura que puede investigarse y comprenderse. El mundo natural no es un caos absoluto, sino un sistema regido por procesos y regularidades que pueden ser observados, descritos y explicados mediante el conocimiento científico.
A lo largo de los últimos siglos, la humanidad ha descubierto que muchos fenómenos que en otro tiempo parecían inexplicables responden a leyes naturales relativamente simples. El movimiento de los planetas, el comportamiento de la luz, la composición de la materia o el desarrollo de los organismos vivos pueden estudiarse mediante modelos que permiten comprender sus causas y prever sus consecuencias.
Este descubrimiento ha transformado profundamente nuestra relación con el universo. En lugar de un mundo dominado por fuerzas incomprensibles, la ciencia ha revelado una realidad donde el orden y la regularidad desempeñan un papel fundamental. Las mismas leyes físicas que gobiernan el movimiento de una piedra también explican la dinámica de los planetas; los mismos principios químicos que operan en un laboratorio se encuentran en los procesos que sostienen la vida.
Esta capacidad de comprender la naturaleza es, en sí misma, uno de los aspectos más fascinantes de la condición humana. Nuestro cerebro, fruto de la evolución biológica, ha desarrollado la capacidad de construir modelos conceptuales que permiten interpretar fenómenos extremadamente complejos. A través del lenguaje, de las matemáticas y de la observación sistemática, los seres humanos han aprendido a descifrar muchos de los mecanismos que estructuran el universo.
Pero esta comprensión nunca es completa ni definitiva. Cada generación de científicos descubre nuevos aspectos de la realidad que obligan a revisar o ampliar las teorías existentes. El conocimiento científico avanza mediante un proceso continuo de preguntas, hipótesis y descubrimientos. Lo que hoy parece bien entendido puede revelarse mañana como parte de un fenómeno aún más profundo.
Por ello, afirmar que el mundo es más comprensible de lo que parece no significa que todos sus misterios estén resueltos. Al contrario, significa reconocer que el universo posee una estructura que puede investigarse y que la mente humana tiene la capacidad de explorarla progresivamente. La ciencia no elimina el misterio del mundo; lo transforma en un campo de investigación permanente.
Esta idea contiene también un mensaje de confianza en la capacidad intelectual de la humanidad. A pesar de las dificultades y de los errores inevitables en cualquier proceso de investigación, la historia de la ciencia demuestra que los seres humanos pueden ampliar continuamente su comprensión del mundo natural.
Desde el descubrimiento de las leyes del movimiento hasta la exploración de las galaxias más lejanas, desde el estudio de las células hasta la investigación del origen del universo, el conocimiento científico ha permitido iluminar muchos aspectos de la realidad que antes permanecían ocultos.
Esta capacidad de comprender la naturaleza no solo tiene valor práctico; también posee una dimensión profundamente cultural. Conocer el universo en el que vivimos amplía nuestra perspectiva sobre la existencia humana. Nos permite situar nuestra vida dentro de una historia natural que se extiende a lo largo de miles de millones de años y que conecta nuestra experiencia cotidiana con procesos cósmicos de enorme escala.
Al mismo tiempo, este conocimiento invita a contemplar el mundo con una mezcla de racionalidad y asombro. La ciencia muestra que la naturaleza posee una coherencia que puede investigarse, pero también revela niveles de complejidad que continúan desafiando nuestra imaginación.
Quizá esa sea una de las ideas más inspiradoras que se desprenden del estudio de las ciencias naturales: el universo es vasto y complejo, pero no completamente inaccesible a la comprensión humana. Con paciencia, curiosidad y espíritu crítico, la humanidad ha logrado descifrar muchos de sus secretos.
El mundo es más comprensible de lo que parece. Y precisamente por eso sigue siendo una fuente inagotable de preguntas, descubrimientos y maravillas.
Bibliografía recomendada
Sagan, Carl — Cosmos.
Hawking, Stephen — Breve historia del tiempo.
Bryson, Bill — Una breve historia de casi todo.
Darwin, Charles — El origen de las especies.
Kuhn, Thomas — La estructura de las revoluciones científicas.
Wilson, Edward O. — La diversidad de la vida.
Wagensberg, Jorge — Ideas sobre la complejidad del mundo.
Referencias principales
- Campbell, Neil A. et al., Biología.
- Margalef, Ramón, Ecología.
- Odum, Eugene P. y Barrett, Gary W., Fundamentos de ecología.
- Wilson, Edward O., La diversidad de la vida.
- Carson, Rachel, Primavera silenciosa.
- Encyclopaedia Britannica, Biology.
- Encyclopaedia Britannica, Ecosystem.



